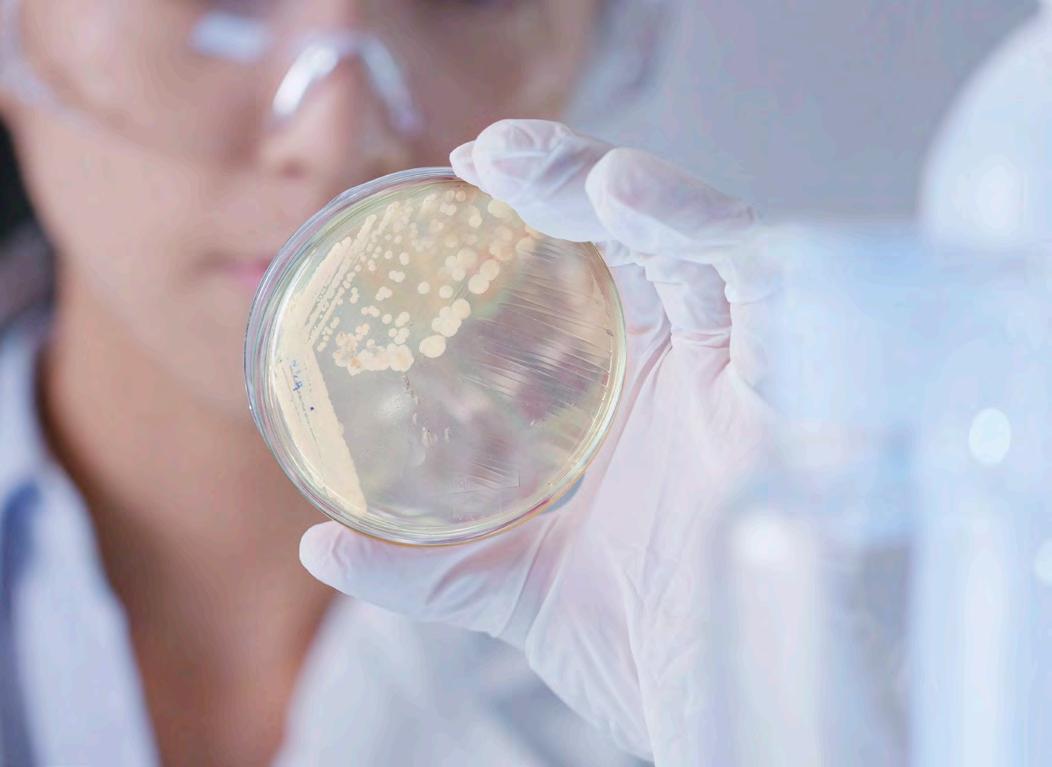

SCIENCE LABSCHÜLERVERSUCHE-SYSTEM

![]()


Bremen, Hamburg, Niedersachsen Nord-Ost, Schleswig-Holstein
Eike Damm
Tel. (0172) 294 98 22
E-Mail edamm@ld-didactic.de
Niedersachsen West, Nordrhein-Westfalen West
Peter Förster
Mobil (0172) 294 98 03
E-Mail pfoerster@ld-didactic.de
Hessen & Niedersachsen Süd
Mark Metzbaur
Mobil (0172) 294 98 06
E-Mail mmetzbaur@ld-didactic.de



Bremen, Niedersachsen Nord-Ost, Schleswig-Holstein
Jörg Grube
Mobil (0172) 294 98 28
E-Mail jgrube@ld-didactic.de
Nordrhein-Westfalen Ost
Carsten Kayser
Mobil (0172) 294 98 32
E-Mail ckayser@ld-didactic.de


Saarland & Luxemburg
Dr. Tobias Budenz
Mobil (0172) 257 16 79
E-Mail tbudenz@ld-didactic.de
Nord, Thüringen

Berlin, Brandenburg, MecklenburgVorpommern, Sachsen-Anhalt, Sachsen
Uwe Biesel
Mobil (0172) 294 98 26
E-Mail ubiesel@ld-didactic.de

Nordrhein-Westfalen (Sekundarstufe 1)
Sandra Flores
Mobil (0172) 294 98 16
E-Mail sflores@ld-didactic.de
Baden-Württemberg West
Wolfgang Reith
Mobil (0172) 294 98 14
E-Mail wreith@ld-didactic.de


Baden-Württemberg Ost, Bayern Süd Dr. Thomas Grünsfelder
Pierre Schuy
Mobil (0172) 294 98 19
E-Mail pschuy@ld-didactic.de

Mobil (0172) 294 98 35
E-Mail tgruensfelder@ld-didactic.de

Stechert
E-Mail ustechert@ld-didactic.de

angebote@ld-didactic.de
E-Mail hprinz@ld-didactic.de

Sophie Willnow
E-Mail swillnow@ld-didactic.de



BIOLOGIE


Ein ideales SchülerversucheSystem sollte dabei unterstützen, möglichst viele Experimente im Unterricht durchführen zu können.
Das fängt bei einer zeitsparenden Vorbereitung an, reicht über eine übersichtliche Aufbewahrung und ein unkompliziertes Handling der Geräte, umfasst einfache und sichere Experimente und beinhaltet Unterstützung bei der Nachbereitung und Korrektur.
Deshalb besteht Science Lab aus drei zentralen Elementen, die aufeinander abgestimmt entwickelt wurden: unser Aufbewahrungssystem unsere Versuchsliteratur unsere Messtechnik
1
2
3
Jedes Element bietet in sich viele Vorteile und Innovationen. Potenziert durch das perfekte Zusammenwirken der drei Elemente stellt Science Lab ein einzigartiges Schülerversuche-System dar.
Da Science Lab sowohl in der Physik, Chemie und Biologie und von der Sekundarstufe I bis hin zur Sekundarstufe II genutzt wird, brauchen sich Schülerinnen und Schüler und Lehrerinnen und Lehrer nur mit einem System vertraut machen. Viele Geräte, deren Bedienung und die Nutzung der Arbeitsblätter sind bereits schnell für alle Fächer bekannt. Zudem offeriert Science Lab die Flexibilität sich an jedes Unterrichtskonzept hin anzupassen.

1

DIGITALE & EXPERIMENTELLE KOMPETENZEN ERWERBEN
3

2 UNSER AUFBEWAHRUNGSSYSTEM & GERÄTE UNSERE VERSUCHSLITERATUR UNSERE MESSTECHNIK



n langlebig durch robustes & stabiles Design
n unkomplizierte Aufbewahrung und schnelle Handhabung durch innovative Detaillösungen
n einfaches und sicheres Experimentieren
n konform mit Lehrplänen und Prüfungsinhalten der Bundesländer
n ideal mit dem universellen Schülermessgerät Mobile-CASSY 2 WLAN für alle Themen und den speziell für Schülerversuche entwickelten Sensoren
n mit neuesten didaktischen Erkenntnissen erstellte Experimente
n digitales Experimentieren einfach möglich
n Experimentiereinheiten, die auf Schulstunden zugeschnitten sind
n reduzierte Vorbereitungszeit für Lehrerinnen und Lehrer
n editierbare, interaktive Versuchsanleitungen mit vorbereiteten Lehrer- und Schülerteilen
n gerätegeformte Aufbewahrung für eine schnelle Vollständigkeitskontrolle
n satz- und blockweise Aufbewahrung angepasst an das Unterrichtskonzept
n Grundlagen- und Vertiefungsversuche
n qualitativ hochwertige und innovative Geräte
n entwickelt für das Experimentieren in Schülergruppen

n für alle üblichen Schrankmaße
n mit und ohne Deckel symmetrisch stapelbar
n immer stapelbar, da kein Gerät hinausragt
n vorder- und rückseitige Griffmulden für einfache Schrankentnahme und Transport
n systematische Anordnung der Geräte
n Beschriftung auf Schubvorderund rückseite



n von Weitem erkennbare, eindeutige und klare Kennzeichnung
n Einräumplan
n flexibel durch auswechselbare Einleger in Schutzhülle

n flexible Beschriftung
n auswechselbares Etikett in Schutzhülle
n wasserbeständig
n je ein Etikett für Vorder- und Rückseite des Schubes


n zeitsparendes Entnehmen und Einräumen der Geräte
n schnelle Vollständigkeitskontrolle vor und nach dem Experimentieren
n online abrufbar über QR-Code (Einräumplan in A4 zum Selbstdruck verfügbar)



n übersichtliche Strukturierung der Schülerversuche-Sammlung durch eindeutige Farbcodierung
n des Unterrichtsfachs
n des Fachbereichs
n der Themengebiete
n schnelles und einfaches Auffinden durch Kombination der Farbgebung mit den Kürzeln der einzelnen Schübe
n QR-Code: online direkt zu allen Produktinformationen und detailliertem Einräumplan
n direkte Zuordnung zu Schülergruppen über frei beschriftbares Feld auf dem Etikett

LANGLEBIGE UND BEWÄHRTE GERÄTE
ALLTAGSERPROBT UND
FEHLERTOLERANT
n im Schulalltag erprobte Geräte n stabil und einfach für Schülerhände entwickelt
BESTÄNDIG UND WIEDERBESCHAFFBAR
n Geräte einzeln erwerbbar
n Ersatzteile sind über viele Jahre lieferbar


VERTRAUTE GERÄTE FÄCHER- UND JAHRGANGSÜBERGREIFEND
n ein System für Physik, Chemie & Biologie sowie die S I und S II
n Geräte und deren Bedienung sind über Fächer und Stufen hinweg bekannt
n viele Geräte werden in mehreren Versuchen genutzt
n geringer Zeitbedarf beim Erlernen neuer Versuchsthemen

& HOCHWERTIG
n alle Materialien vom Schub bis zum Fachteiler
n unempfindlich gegen Schläge und Stöße
n abwaschbar, leichte Reinigung
n keine Verfärbungen durch UV-Strahlung

n Deckel passt auf und unter den Schub
n optional zum Schutz vor Staub und Schmutz
n zusätzliche Sicherheit für Geräte im Schub und beim Transport

Mit den LEYBOLD-Netzgeräten bieten wir höchste Qualität und Geräte, die deutschen und internationalen Sicherheitsstandards entsprechen, um ein sicheres Experimentieren im Unterricht zu garantieren. Durch die moderne Technik sind die LEYBOLD-Netzgeräte nicht nur zuverlässig im Einsatz, sie stehen auch für Langlebigkeit.
n moderne Sicherheitsstandards und Erfüllung der RiSU
n abgestimmt auf die Science Lab Schülerversuche
n einfache und intuitive Bedienung
n klare und übersichtlich angeordnete Bedienelemente
n leistungsfähig und universell in der Funktionalität
n berührungsungefährliche Spannung bei Schülernetzgeräten
n Sicherheitstransformator nach DIN EN 61588-2-6 bei Netzgeräten für Schülerversuche
n alle Ausgänge sind galvanisch vom Netz getrennt und erdfrei
n alle Ausgänge sind kurzschlussfest
n robuster Aufbau im Stahlblechgehäuse
n einfache Handhabung und Transport durch beidseitige Griffmulden
n flexibler Einsatz bei Schülerversuchen in der S I und S II, aber auch in der Demonstration sowie Praktikumsversuchen an Hochschulen






Schüler bekommen alle Geräte für ein Thema in einem Schub ausgegeben
n in den Schüben befinden sich alle für den Versuch benötigten Geräte für eine Schülergruppe n gerätegeformte Aufbewahrung - jedes Gerät hat seinen definierten Platz
n zeitsparendes Aus- und Einräumen der Geräte n eindeutige Zuordnung der einzelnen Schübe zu Schülergruppen über beschriftbares Feld auf den Etiketten
n schnelle Vollständigkeitskontrolle vor und nach dem Experimentieren durch abgebildeten Einräumplan auf der Rückseite

1. WIE GROß IST DIE KLASSE?




Beispiel: 15 Schüler











WIE GROß IST EINE SCHÜLERGRUPPE?







Unsere Empfehlung: 2 bis 3 Schüler in einer Gruppe

5a) SATZWEISE 5b) BLOCKWEISE




Schüler bekommen nur die Geräte für das aktuelle Experiment ausgegeben

GERÄTEGEFORMTE AUFBEWAHRUNG
n in den Schüben befinden sich gleiche Geräte für mehrere Schülergruppen
n Konzentration auf aktuelles Experiment, da weitere Geräte nicht ausgeteilt werden
n geringerer Platzbedarf in Schränken durch Zusammensortieren gleicher Geräte
n Verwendung von variablen Fachteilern (2 - 10 Fächer möglich) sowie teilweise gerätegeformten Einlegeschäumen
n einfacheres Zurückräumen von zu reinigenden und trocknenden Geräten
n für 4 bis 16 Arbeitsgruppen bestellbar
Bei Fragen kontaktieren Sie gerne unsere Fachberater.















Schüler / 3 = 5 Gruppen

WO FINDE ICH DIE ARTIKELNUMMER? 6a) Direkt beim Schub: Übersicht Inhalt & Zubehör
6b) Extra-Seite am Ende von jedem Fach „Blockweise Aufbewahrung“




PB erforderlich.
DURCHFÜHRBAR
n die meisten Versuche sind in einer Schulstunde durchführbar
n Schülerinnen und Schüler können die meisten Versuche selbstständig durchführen
n Experimentieren in Schülergruppen (2-er oder 3-er Gruppen) wird unterstützt
PLATZSPAREND UND EFFIZIENT
n geringer Platzbedarf auf dem Tisch, da satzweise maximal zwei stapelbare Schübe pro Experimentiergruppe
n Zeitersparnis durch intuitiven Umgang der Schülerinnen und Schüler mit den Schüben
KOMPLETT UND VERTRAUT
n Science Lab deckt die Unterrichtsfächer Physik, Chemie & Biologie und die S I und S II ab
n Schülerinnen und Schüler machen sich mit dem Material schnell vertraut: geringer Zeitbedarf beim Erlernen neuer Versuchsthemen
VERSTÄNDLICH UND ANPASSBAR
n leicht verständliche Versuchsanleitungen in einfacher Sprache leiten die Schülerinnen und Schüler sicher durch die Versuche
n Verwendung von wiederkehrenden Operatoren in den Versuchsanleitungen
n Editieren der Versuchsanleitung ist einfach möglich, z. B. um diese an den eigenen Unterricht anzupassen
n Versuchsanleitungen sind bereits durch Zusatzaufgaben erweitert, um Schülerinnen und Schüler individuell fördern zu können
n die Vorlesefunktion und die Zoomfunktion berücksichtigen zusätzliche Anforderungen im Zuge der Inklusion



Die Naturwissenschaften sind experimentelle Schulfächer. Dieses wird auch bei einem Studium der Lehrpläne deutlich, denn in jedem Bundesland sind in der Physik, Chemie und Biologie Schülerversuche vorgesehen.
Diese sollen einerseits den Wissenserwerb fördern, andererseits u. a. experimentelle Kompetenzen lehren. Dadurch ermöglicht der Einsatz von Experimenten im Unterricht einen handlungsorientierten Zugang zu den Naturwissenschaften.
n Versuchsauswahl auf Basis der unterschiedlichen Lehrpläne der Bundesländer
n Sekundarstufe I und II: für Schülerversuche ab Klasse 5 bis hin zum Abitur
n große Versuchsauswahl, um beispielsweise auch Wahlthemen und MINT-AGs abzudecken
n ausgelegt auf die Förderung von Basiskompetenzen in den Kompetenzbereichen n Erkenntnisgewinnung
n Fachwissen
n Kommunikation
n Bewertung
n Förderung von digitalen Kompetenzen




Die Versuchsanleitungen wurden in Zusammenarbeit mit Didaktik-Instituten der Universität zu Köln erstellt.
VERSUCHSANLEITUNGEN FÜR UNSERE SCHÜLERVERSUCHE
n auf Basis neuester didaktischer Erkenntnisse erstellt und unter Mitwirkung von Lehrkräften entwickelt n zugeschnitten auf die Bedürfnisse von Schülern und Lehrern
n informativer und umfassender Lehrerteil für eine zeitsparende Vorbereitung n leicht verständlicher und interessanter Schülerteil n einfach und unkompliziert editierbar (Texte, Tabellen, Diagramme, Bilder) - plus: auch eigene Experimente erstellbar n lehrplankonform, ausgerichtet auf das Erlernen von Fähigkeiten und Kompetenzen




n Herunterladen als PDF-Datei zum Ausdruck

n Aufruf der digitalen Version auf jedem Schülergerät
n jederzeit und von überall Zugriff auf die digitalen, interaktiven Versuchsanleitungen
n können einfach und schnell von Lehrer und Schülern auf eigenem Tablet/Smartphone/PC aufgerufen, bearbeitet, gespeichert oder geteilt werden
n intuitive Nutzung der digitalen Anleitungen
n Auswertung und Protokollierung in der Schule oder zu Hause
n einfache Korrektur durch schnelle digitale Prüfung sowie Musterantworten

EINFACH &

n herstellerunabhängig n plattformunabhängig n Lösungen für jede IT-Infrastruktur n ermöglicht auch BYOD
NUTZBAR AUF JEDEM TABLET, SMARTPHONE & PC


n einfach verteilbar an alle Schülertablets und Smartphones über QR-Code
INTERAKTIVE NUTZUNG
n Aufgaben beantworten

n Auswertung
n digitales Protokoll
n Speichern
n Teilen an den Lehrer
EXPERIMENTIEREN
n Aufruf des Lab Docs n Aufbau des Versuchs DIGITALES

INTERAKTIV MIT DEM MOBILE-CASSY 2 WLAN
n Versuch & Messung durchführen
n Live-Messwerte in Tabellen und Diagrammen


n kurze und verständliche Versuchsbeschreibungen mit direkter Ansprache
n auf sinnvolle Unterrichtseinheiten ausgelegt
n zugeschnitten auf die jeweilige Altersgruppe
n ausreichend Platz für die Antworten der Schülerinnen und Schüler
n modularer Aufbau ermöglicht unterschiedliche Vertiefungsmöglichkeiten und Arbeitsgeschwindigkeiten
n besteht aus Anleitung und auszufüllendem Arbeitsblatt
n sukzessive Darstellung des Versuchsaufbaus und der Durchführung

n Empfehlungen zum Unterrichtseinsatz der Versuche mit Versuchszielen und der Einordnung in den fachlichen Kontext
n ausführliche Begleitinformationen zur Vorbereitung, Nennung möglicher Fehlerquellen und Sicherheitsmaßnahmen
n didaktische Überlegungen für den Experimentiereinsatz im geöffneten und geschlossenen Unterricht
n das Arbeitsblatt enthält Musterantworten und Beispielmessungen sowie Beispielauswertungen zur Unterrichtsplanung
n Einordnung der Versuche nach Stufe, Schwierigkeitsgrad, Vorbereitungszeit und Dauer





































n Versuchstitel und Unterrichtsfach n Stufe
n Schwierigkeitsgrad n Vorbereitungszeit für den Lehrerinnen und Lehrer n Dauer der Durchführung
n Kurzbeschreibung n Didaktische Überlegungen n Hinweise zum Experiment
ZUSATZINFORMATIONEN IN ROT n Einleitung n Arbeitsauftrag n Material n Sicherheitshinweise n Aufbau n Durchführung

n Beobachtung n Abbau n Auswertung n Schlussfolgerung n Zusatzaufgaben
LAB
n Anleitung und Aufgabenstellungen n Messwerte (Tabelle, Diagramm)
n Auswertungen
n speicherbar als digitales Protokoll
Die Anleitungen Lab Docs können in unterschiedlichen Literaturpaketen erworben werden. Spezifisch auf die Bedürfnisse im Unterricht ausgerichtet, stehen Pakete für das jeweilige Unterrichtsfach oder zu einzelnen Fachgebieten zur Auswahl. Die verfügbaren Literaturpakete sind bei jedem Schub aufgeführt.


n alle Versuchsanleitungen mit Schüler- und Lehrerteil
n Einmalkauf als Schullizenz
n gleichzeitige Nutzung und Verwaltung der Literatur mit Internet und ohne Internet
n einfache und schnelle Aktivierung über Produktschlüssel
n kostenlose Updates des gesamten Paketes
n komfortable Suchfunktion zum schnellen Finden des gewünschten Versuchs n Upgrades bei neuen Funktionalitäten
n enthält alle Versuchsanleitungen in HTML5 zur digitalen Nutzung
n auch herunterladbar als PDF-Datei zum Ausdrucken
MANAGEMENT UND VERWALTUNG DER DIGITALEN BIBLIOTHEKEN
Document Center
OHNE INTERNET
NUTZUNG DER LITERATUR IM DOCUMENT CENTER
n vollständig auf lokalem PC/Laptop installiert
n Verteilung der Lab Docs an die Klasse ist ohne Internetzugang möglich
kostenlose Document Center Software

MIT INTERNET
NUTZUNG DER LITERATUR IN LEYLAB B
n Online-Zugriff von allen Endgeräten mit Internetzugang n Verteilung der Literatur auch außerhalb des Unterrichts möglich
kostenlose Version von LeyLab (Free-Version)
Dafür gibt es die ausgedruckte Version im Ordner für jedes Thema.
n erhältlich für jedes Thema (in der Chemie & Biologie für jedes Fachgebiet)
n Schüler- und Lehrerteil
n enthält Versionen mit und ohne Unterstützung des Mobile-CASSY 2 WLAN
SCHNELL UND EINFACH VERSUCHSANLEITUNGEN BEARBEITEN UND ERSTELLEN
GEKAUFTE LAB DOCS
ANLEITUNGEN AUS DEN LITERATURPAKETEN ANPASSEN

VORHANDENE ANLEITUNGEN
FÜR DEN DIGITALEN
UNTERRICHT FIT MACHEN
GANZ NEUE, EIGENE ANLEITUNGEN ERSTELLEN
n einfach zu bedienendes Tool, HTML-Kenntnisse sind nicht notwendig
n Versuchsanleitungen methodisch und didaktisch nach eigenen Bedürfnissen gestalten n responsives Layout - passt sich an jede Bildschirmgröße an n einheitliche, standardisierte Gestaltung der Anleitungen ermöglicht eine intuitive Nutzung durch Schülerinnen und Schüler sowie Kolleginnen und Kollegen n zentrale Verfügbarkeit n Messwerttabellen und Diagramme mit und ohne Einbindung eines Mobile-CASSYs
n Bearbeiten & Löschen von Aufgaben
n Änderung von Anleitungen
n Hinzufügen von Text
n Einbinden und Anpassen von interaktiven Diagrammen & Tabellen
n Einfügen von Bildern, Vektorgrafiken, Hyperlinks, etc.
n Anfertigen und Erzeugen von Materiallisten
n Erstellen von Formeln


n Änderungen sofort im Web-Browser sichtbar
n komfortable Ansicht des Schülerund Lehrerteils
n Export als PDF möglich
n Export nach LeyLab für zentrales Management
n Verteilung der Lab Docs über QR-Code

n für alle Messaufgaben & -themen in Physik, Chemie und Biologie
n sowohl Messen als auch Auswerten
n mit WLAN (Verbindung mit einem Schul-WLAN-Router oder Aufbau eines eigenen Access Points)
n große, grafikfähige Messwertanzeige für kontrastreiche Diagramme

n Messung von Spannung, Stromstärke, Leistung, Energie und Temperatur ist direkt ohne weiteres Zubehör möglich
n kompatibel mit allen CASSY-Sensoren S und M
n automatische Sensorerkennung
n schnelle Messwertaufnahme - bis 500.000 Werte pro Sekunde

EINFACH DIREKT MESSEN
1. EINSCHALTEN |
2. SENSOR AUFSTECKEN |
3. AUTOMATISCHE SENSORERKENNUNG |
4. START DER MESSUNG |

5. SPEICHERN DER WERTE IM MOBILE-CASSY |
6. PROTOKOLLIEREN
MESSEN MIT LAB DOCS
1. EINSCHALTEN |
2. SENSOR AUFSTECKEN |
3. MESSEINSTELLUNG VON LAB DOC |
4. START DER MESSUNG |
5. MESSERGEBNISSE LIVE IN LAB DOC |
6. AUSWERTUNG IM LAB DOC |
7. DIGITALES PROTOKOLL SPEICHERN


MESSEN MIT CASSY.APP WEB
1. EINSCHALTEN |
2. SENSOR AUFSTECKEN |
3. MESSEINSTELLUNG IN WEB-APP |
4. START DER MESSUNG |
5. MESSERGEBNISSE SPEICHERN |

6. VIELFÄLTIGE AUSWERTUNGSMÖGLICHKEITEN (WEB-APP, EXCEL, ETC.)
OUTDOOR-MESSEN (DATALOGGER)
1. EINSCHALTEN |
2. SENSOR AUFSTECKEN |
3. AUTOMATISCHE SENSORERKENNUNG |
4. START DER MESSUNG |
5. SPEICHERN DER WERTE IM MOBILE-CASSY |
6. PROTOKOLLIEREN

(Noch) keine Tablet-Klasse?
Digitale Schülerversuche können auch ausschließlich mit dem Mobile-CASSY 2 WLAN durchgeführt werden.
Das Schülermessgerät kann einen sogenannten Access Point aufbauen. Dieses eigene WLAN ermöglicht das Zusammenspiel mit Tablets oder Smartphones.

MIKROFON M (524 442)


PH-ADAPTER S (524 0672)

LEITFÄHIGKEITSADAPTER S (524 0671)
Die CASSY-Sensoren M sind die ideale Ergänzung für LEYBOLD-Schülerversuche mit dem Mobile-CASSY 2 WLAN.
n preisgünstige Sensorfamilie, speziell entwickelt für Schülerversuche n Sensoren mit mehreren Messgrößen und/oder Messbereichen
n automatische Einstellung der Messgrößen n sofortiges Messen ohne mühsames Einstellen n kontinuierlicher Ausbau der Familie mit weiteren Sensoren
n zusätzlich über 50 CASSY-Sensoren S n unterstützt von den Lab Docs und der CASSY App

SPANNUNGSSENSOR M, ±30 V (524 438)

MAGNETFELDSENSOR M, ±100 mT (524 436)


ELEKTROCHEMIE-BOX M (524 450)

GM-ADAPTER M (524 440)

LUX-SENSOR M (524 444)

LICHTSCHRANKE M (524 431)
KRAFTSENSOR M, ±50 N (524 434)
Bis zu vier Geräte (Tablet/Smartphone/Laptop) können sich mit einem Mobile-CASSY 2 WLAN verbinden (= 1 Schülergruppe)

Nach Verbindung mit Mobile-CASSY 2 WLAN werden Einstellungen für den Versuch übergeben (Messgrößen, Messbereiche etc.). Lab Doc Mobile-CASSY 2 WLAN drahtlose Verbindung

Messwerte werden direkt in Tabellen und Diagramme des Lab Docs übernommen.



Jeder Schüler beantwortet im individuellen Lab Doc am eigenen Tablet, Smartphone oder Laptop die Fragen und wertet die Messergebnisse aus. Danach kann das digitale, persönliche Protokoll gespeichert und geteilt werden.
MANUELLE EINGABE
INTERAKTIVE MESSINSTRUMENTE

Live-Messwerte aus dem Mobile-CASSY 2 WLAN werden in Messinstrumente, Tabellen und Diagramme übertragen

DIGITALES PROTOKOLL



Abspeichern und Teilen des Protokolls Abgespeicherte Daten sind jederzeit wieder ladbar (z. B. für eine weitere Bearbeitung zu Hause)

ONLINE-PORTAL ZUR ORGANISATION
UND VERWALTUNG VON EXPERIMENTEN

EXPERIMENTESAMMLUNG
n jederzeit Zugriff auf den gesamten
LD-Experimentekatalog mit allen relevanten Informationen zu jedem Experiment
n schnell und sicher das gewünschte Experiment finden
n Aufbau einer eigenen Experimentesammlung
n einfache Erweiterung der LD-Experimente
n leichte Erstellung von eigenen, neuen Experimenten
n gemeinsames Arbeiten mit Kolleginnen & Kollegen intelligente Verknüpfung mit Geräten


n das komplette Inventar auf einen Blick n direkter Überblick über alle vorhandenen Geräte inklusive Anzahl und Lagerort n zeitsparende Suche von Geräten n ausführliche Informationen zu jedem Gerät n einfache Inventarisierung der kompletten Sammlung n LD-Geräte und Geräte anderer Hersteller n mit Barcode-Funktionalität
n klare Bestandsverwaltung mit Ausleih- und Rückgabefunktion
Um vom Science Lab voll zu profitieren und die damit verbundenen Möglichkeiten zu nutzen, den Unterricht digital zu gestalten, bieten wir Seminare und Workshops bei uns im Hause oder vor Ort an Ihrer Schule an.
Die Seminare vor Ort können wir individuell gestalten und unterschiedliche Schwerpunkte setzen. So kann ein bestimmtes Unterrichtsfach, das Messsystem CASSY oder digitale Medien in den Fokus gerückt werden. Generell führen wir durch relevante, vorausgewählte Schülerversuche, werten diese gemeinsam aus und bearbeiten konkrete Fragestellungen. Dabei nutzen wir selbstverständlich digitale Medien und das Mobile-CASSY 2 WLAN und zeigen die einfache Nutzung der Lab Docs.

Auch die Vorbereitung von Unterricht und das Verwalten und Organisieren von Experimenten und Geräten sind Teil der Fortbildung. Für Termine bei uns im Hause schauen Sie auf unsere Homepage. Für ein Seminar an Ihrer Schule schreiben Sie uns dazu einfach eine E-Mail an: marketing@ld-didactic.de.

n individuell ausgewählte und abgesprochene Schwerpunkte werden gezielt geschult und bearbeitet n konkrete Einsatzmöglichkeiten und didaktisch sinnvolle Nutzung von digitalen Medien werden vermittelt n Einbringen unseres Know-Hows, sowie Wissen und Erfahrungen von verschiedensten Bildungsinstituten weltweit, von Trendveranstaltungen etc.
Teilnehmer: max. 10 Teilnehmer pro Seminar
Dauer: 4-5 Stunden
Preis: nach Angebot
Nachweis/Zertifikat:
Ort: vor Ort, gerne auch gemeinsam mit weiteren Schulen
Professionelle Serviceleistungen in allen Projektphasen


Individuelle und kompetent Beratunglehrplankonform und innovativ für den digitalen Unterricht.
Gemeinsame Sichtung der Sammlung und Unterstützung bei der Zusammenstellung.

Vom kompletten Aufbau über Inbetriebnahme bis hin zur Erläuterung von Versuchen und Funktionalitäten der Einzelgeräte.

Für unsere langlebigen Produkte können wir über viele Jahre hinaus Ersatzteile zusichern.


Für standardmäßig bestellte Waren innerhalb Deutschland frei Haus.

Nutzen Sie unseren rundum-sorglosEinräumservice und lassen Sie Ihre neue Ausstattung einsortieren.

Für Angebote & Beratung zu Produkten & Versuchen
E-Mail: angebote@ld-didactic.de
Telefon: 0 22 33/604 199
Fragen zu Bestellungen & zur Auftragsabwicklung
Montag - Donnerstag 08.00 - 16.00 Uhr
Freitag 08.00 - 14.45 Uhr
E-Mail: info@ld-didactic.de
Telefon: 0 22 33/604 430
Technische Service-Hotline & Reklamationen
E-Mail: service@ld-didactic.de
Telefon: 0 22 33/604 311
CASSY-Line
Bei technischen Fragen rund um das CASSY
E-Mail: cassy@ld-didactic.de

Wird trotz unseres hohen Qualitätsanspruchs ein Defekt am LEYBOLD–Produktes festgestellt, reparieren wir das defektes Gerät selbstverständlich schnellstmöglich.

Wir gewährleisten eine Reparaturlösung für alle Geräte bis 10 Jahre nach dem Kauf –für den Großteil unseres Sortiments auch noch weitaus länger.

Schülerversuche-System
Sie möchten Ihr bewährtes Schülerversuche-System modernisieren und die Vorteile des neuen Science Lab nutzen?
Wir stehen jederzeit für Sie bereit, um Ihnen bei Ihren Fragen zu helfen und zu beraten.
Um Ihnen die Nutzung unseres Kataloges zu erleichtern, möchten wir Ihnen anhand von Beispielseiten erläutern, wie unser Katalog aufgebaut ist.
Der Aufbau der Kapitel und Seiten ist durchgängig gleich und folgendermaßen gegliedert:


Gesamtüberblick der einzelnen Themenbereiche sowie stichpunktartige Aufzählung von Lehrplanthemen.
Themenbereich und -erläuterung

Fachgebiet



Übersicht der Schübe und Themen

Beschreibung der dazugehörigen Materialien um das gewählte Thema „ausführen“ zu können Thema













Erklärung des Basisschubes, welcher für einige Themenbereiche benötigt wird.
Detailinformationen zu den einzelnen Science Lab Schüben, inkl. Lieferumfang, Preisen, etc.

QR-Code für jeden Science Lab Schub (für weitere Informationen)






Übersicht
Vorteile im Überblick
Messgeräte

Literaturauswahl


Ergänzendes Aufbewahrungszubehör






Sensoren
Benötigtes Material pro Schüler Chemikalien
Benötigtes Material pro KIasse
Benötigtes Material pro Gruppe
Empfohlenes Material



LP1.1 MESSMETHODEN, KÖRPEREIGENSCHAFTEN & FLÜSSIGKEITEN
LP1.2 KRÄFTE, EINFACHE MASCHINEN, SCHWINGUNGEN
LP1.3 LINEARE BEWEGUNGEN, FREIER FALL UND STOSSVERSUCHE
LP1.4 AKUSTIK
Hier finden Sie eine Gesamtübersicht über unsere Science Lab Schülerversuche aus dem Bereich der Physik. VERSUCHSTHEMEN



Messung von Länge und Zeit; Messung von Masse und Dichte; Druck in Flüssigkeiten; Kräfte auf Körper in Flüssigkeiten; Kräfte an der Oberfläche von Flüssigkeiten
Mechanik fester Körper; Verformung durch eine Kraft; Zusammensetzung und Zerlegung von Kräften; Hebel; Rolle und schiefe Ebene; Harmonische Schwingungen; Erzwungene Schwingungen und stehende Wellen; Überlagerung von Wellen
Gleichförmige Bewegung; Gleichmäßig beschleunigte Bewegung; Newtonsche Gesetze; Freier Fall; Elastische Stoßversuche; Unelastische Stoßversuche; Impulserhaltung
Schallausbreitung; Schwingungen und Töne; Lärmanalyse; Resonanz und Schwebung; Schallgeschwindigkeit




LP2.1 WÄRMELEHRE Wärmeausdehnung; Wärmetransport; Wärmedämmung; Wärmekapazitäten; Aggregatszustände und Übergänge
LP2.2 ERNEUERBARE ENERGIEN Solarenergie; Windenergie; Peltier-Effekt; Energiespeicherung; Energieumwandlung und Wirkungsgrad
LP2.3 BRENNSTOFFZELLEN



VERSUCHSTHEMEN LEHRPLANTHEMEN
LP3.1 ELEKTROSTATIK



Kontaktelektrizität; Kraftwirkung zwischen Ladungen; Elektrische Influenz; Ladungsspeicher; Elektrostatische Wechselwirkung; Isolatoren und Leiter; Äquipoteniallinien; Plattenkondensator
LP3.2 MAGNETISMUS Magnetwirkung; Magnetische Influenz; Magnetische Felder
LP3.3 ELEKTRISCHE GRUNDSCHALTUNGEN Stromkreis und Schalter; Elektrische Messverfahren; Ohmsche Widerstände; Spezielle Widerstände; Spannungsquellen; Elektrische Anwendungsschaltungen; Solarzellen; Elektrochemie
LP3.4 ELEKTROMAGNETISMUS UND INDUKTION
Elektromagnetismus; Elektromagnetische Anwendungen; Induktion; Transformatoren; Anwendungen der Induktion; Spulen im Gleich- und Wechselstromkreis
LP3.5 MOTOREN UND GENERATOREN Generatoren; Elektromotoren
LP4.1 ELEKTRONISCHE GRUNDSCHALTUNGEN Kondensatoren; Relaisschaltungen; Dioden; Transistoren; Diodenschaltungen; Kippstufen; Verstärkerschaltungen




VERSUCHSTHEMEN LEHRPLANTHEMEN
LP5.1 STRAHLENOPTIK UND GEOMETRISCHE OPTIK Lichtausbreitung und Schattenbildung; Licht und Schatten in der Natur; Reflexion an Spiegeln; Lichtbrechung; Farbzerlegung und Wiedervereinigung des Spektrums; Linsen und Linsenfehler; Optische Instrumente zur Vergrößerung des Sehwinkels; Optische Instrumente und Auge
LP5.2 FARBENLEHRE Untersuchung der Lichtwege durch ein Prisma; Spektralfarben; Farbmischung
LP5.3 WELLENOPTIK Beugung an Beugungsobjekten; Beugung an komplementären Blenden; Zweistrahl-Interferenz
LP5.4 POLARISATION Polarisationsfilter; Spannungsoptische Doppelbrechung; Polarisation infolge Reflexion und Brechung; Polarisation infolge Streuung; optische Aktivität

VERSUCHSTHEMEN
LP6.2 UMWELTRADIOAKTIVITÄT Einführung in die Radioaktivität; Untersuchung des Einflusses der Probenbeschaffenheit und der Größe des Messfensters; Umweltradioaktivität; Statistik des radioaktiven Zerfalls; Abschirmung von Strahlung; Abstand; Untersuchung der Strahlung im Magnetfeld; Halbwertszeit

LP8.1 ARDUINO Einführung in die Programmierung von Mikrocontrollern; Datentypen; Variablen und Operatoren; Fehleranalyse; Kontrollstrukturen; kleinere Projekte
n Dieser Basis-Schub enthält die Grundgeräte für Schülerversuche aus der Physik, die immer wieder benötigt werden.
n Jedes Gerät hat seinen definierten Platz in der gerätegeformten Aufbewahrung.
n In Kombination mit dem Gerätesatz ME1 (207 111S) können zusammen 14 Schülerversuche, mit dem Gerätesatz ME2 (207 112S) mehr als 40 und mit dem Gerätesatz EG1 (207 121S) mehr als 24 Schülerversuche in der S I und S II durchgeführt werden.
n Ein Basis-Schub für die Fachgebiete Mechanik und Energie in der Physik und maximal 2 Schübe auf dem Schülerarbeitsplatz.
n In dem Basis-Schub befindet sich entsprechendes Aufbaumaterial für eine Arbeitsgruppebestehend aus 2 - 3 Schülern.
n Die Versuche aus dem Science Lab Physik können dann themenabhängig mit nur einem weiteren Schub durchgeführt werden.
n Gleiche Geräte = immer wieder gleiche Handhabung: kein Neuerlernen für jedes Thema






Schülerexperimentiersatz des Schülerversuche-Systems Science Lab im Bereich Physik. Grundgeräte für Mechanikund Energieversuche. Aufbaumaterial für eine Arbeitsgruppe in gerätegeformter Aufbewahrung. Die einzelnen Schübe sind stapelbar und können optional mit einem Deckel (647 003) verschlossen werden.
Der Gerätesatz Science Lab Physik Basis PB ermöglicht es, in Kombination mit den Mechaniksätzen ME1 (207 111S) und ME2 (207 112S) sowie dem Energiesatz EG1 (207 121S) lehrplangeforderte Schülerversuche in der S I und S II durchzuführen.
Lieferumfang:
Menge Kat.-Nr. Bezeichnung
1 301 09 Doppelmuffe S
2 301 21 Stativfuß MF
2 301 25 Muffenblock
1 301 26 Stativstange 25 cm, 10 mm Ø
2 301 271 Stativstange 40 cm, 10 mm Ø
1 301 29 Zeiger, Paar
1 309 45 Allschreibstift
1 311 78 Bandmaß 2 m
1 314 01 Zug- und Druckkraftmesser 1,5 N
3 314 04 Haltebügel, steckbar
6 340 851 Laststück, 50 g
1 352 052 Blattfeder 370 mm
1 362 32 Aluminiumquader
1 647 001 Geräteschub, niedrig
1 666 615 Universalmuffe
1 667 017 Schere 125 mm, rund
1 686 50 Metallplatte
1 686 51 Schnur
1 LDS00001 Handstoppuhr, digital
207 100S Science Lab Physik Basis PB (Satz)
Zusätzlich erforderlich:
Menge Kat.-Nr. Bezeichnung
1 207 111S Science Lab Mechanik ME1 (Satz)
1 207 112S* Science Lab Mechanik ME2 (Satz)
1 207 121S* Science Lab Energie EG1 (Satz)
* alternativ
Zusätzlich empfohlen:
Menge Kat.-Nr. Bezeichnung
1 647 003 Deckel zu Geräteschub
Schülergruppe

Jede physikalische Größe hat auch eine Einheit. Um dafür zu sensibilisieren, startet das Science Lab in der Mechanik mit ein paar ganz grundlegenden Versuchen zum Thema Längen- und Dichtebestimmung. Dadurch haben die Schülerinnen und Schüler ebenfalls Gelegenheit sich ganz auf die Beschreibung des Versuchsprotokolls zu konzentrieren. Zu der Mechanik zählen wir neben den Kräften und Schwingungen auch die Lineare Bewegung. Hier lassen sich mit Hilfe von zwei Lichtschranken Zeitdifferenzen und Geschwindigkeiten messen. Das Thema Akustik rundet die Mechanik ab. Von Lärmanalyse bis zur Schallgeschwindigkeitsmessung ist für jede Altersstufe das Passende dabei.
Ein Basis-Schub und vier Mechanik-Schübe ergeben vier Themengebiete mit 96 Versuchen. Diese perfekte Versuchezusammenstellung ist für phänomenologische Versuche wie auch für digitale Auswertung mit Mobile-CASSY 2 WLAN und Sensor geeignet. Für besonders schnelle Schülerinnen und Schüler gibt es noch vertiefende Zusatzaufgaben.

LP1.3.4.1 Bestimmung der Erdbeschleunigung über s(t)-Diagramm
Gegenstände fallen herunter, wenn sie losgelassen werden. Die dabei wirkende Erdbeschleunigung kann in diesem Versuch gemessen werden. Für diesen Versuch benötigen Sie den Schub Science Lab Mechanik ME3 (207 113S)
VERSUCHSTHEMEN
ERFORDERLICHE SCHÜBE
LP1.1 MESSMETHODEN, KÖRPEREIGENSCHAFTEN UND FLÜSSIGKEITEN
LP1.1.1 MESSUNG VON LÄNGE UND ZEIT 14 VERSUCHE S. 32
LP1.1.2 MESSUNG VON MASSE UND DICHTE
LP1.1.3 DRUCK IN FLÜSSIGKEITEN
LP1.1.4 KRÄFTE AUF KÖRPER IN FLÜSSIGKEITEN
LP1.1.5 KRÄFTE AN DER OBERFLÄCHE VON FLÜSSIGKEITEN
LP1.2 KRÄFTE, EINFACHE MASCHINEN, SCHWINGUNGEN
LP1.2.1 MECHANIK FESTER KÖRPER
LP1.2.2 VERFORMUNG DURCH EINE KRAFT
LP1.2.3 ZUSAMMENSETZUNG UND ZERLEGUNG VON KRÄFTEN
LP1.2.4 HEBEL
LP1.2.5 ROLLE UND SCHIEFE EBENE
LP1.2.6 HARMONISCHE SCHWINGUNGEN
LP1.2.7 ERZWUNGENE SCHWINGUNGEN UND STEHENDE WELLEN
LP1.2.8 ÜBERLAGERUNG VON WELLEN




LP1.3 LINEARE BEWEGUNG, FREIER FALL UND STOSSVERSUCHE
LP1.3.1 GLEICHFÖRMIGE BEWEGUNG
LP1.3.2 GLEICHMÄSSIG BESCHLEUNIGTE BEWEGUNG
LP1.3.3 NEWTONSCHE GESETZE
LP1.3.4 FREIER FALL
LP1.3.5 ELASTISCHE STOSSVERSUCHE
LP1.3.6 UNELASTISCHE STOSSVERSUCHE
LP1.3.7 IMPULSERHALTUNG
LP1.4 AKUSTIK
LP1.4.1 SCHALLAUSBREITUNG
LP1.4.2 SCHWINGUNGEN UND TÖNE
LP1.4.3 LÄRMANALYSE
LP1.4.4 RESONANZ UND SCHWEBUNG
LP1.4.5 SCHALLGESCHWINDIGKEIT


Weitere Informationen zu unseren lehrplankonformen Themen und Schülerversuchen sowie die dazugehörigen Schübe finden Sie auf den nachfolgenden Seiten.
LP1.1.1 Messung von Länge und Zeit
LP1.1.1.1
LP1.1.1.2
LP1.1.1.3
Längenmessung
Volumenbestimmung regelmäßig geformter Körper Zeitmessung
LP1.1.2 Messung von Masse und Dichte
LP1.1.2.1
LP1.1.2.2
LP1.1.2.3
Dichtebestimmung regelmäßig geformter Körper Dichtebestimmung unregelmäßig geformter Körper Dichtebestimmung von Flüssigkeiten
LP1.1.3 Druck in Flüssigkeiten
LP1.1.3.1
LP1.1.3.2
LP1.1.3.3
Verbundene Gefäße
Hydrostatischer Druck Wirkung des Luftdruckes
LP1.1.4 Kräfte auf Körper in Flüssigkeiten
LP1.1.4.1
LP1.1.4.2
LP1.1.4.3
LP1.1.4.4
Die Auftriebskraft in Abhängigkeit von der Eintauchtiefe und der Körpermasse
Die Auftriebskraft in Abhängigkeit von der Flüssigkeitsdichte
Das Archimedische Prinzip Sinken - Schweben - Schwimmen
LP1.1.5 Kräfte an der Oberfläche von Flüssigkeiten
LP1.1.5.1 Kapillarwirkung
14 VERSUCHE


Die Schülerinnen und Schüler nutzen ein U-Rohr-Manometer und eine Drucksonde um zu erkennen, dass der hydrostatische Druck proportional zur Tiefe wächst. Für diesen Versuch benötigen Sie die Schübe Science Lab Physik Basis PB (207 100S) und Science Lab Mechanik ME1 (207 111S)


Kat.-Nr. Bezeichnung
207 100S Science Lab Physik Basis PB (Satz)
207 111S Science Lab Mechanik ME1 (Satz) Eine Auswahl der Literaturpakete finden Sie auf den nachfolgenden Seiten.



Schülerexperimentiersatz des Schülerversuche-Systems Science Lab im Bereich Physik. Aufbaumaterial für eine Arbeitsgruppe in gerätegeformter Aufbewahrung. Mit dem Gerätesatz ME1 können, zusammen mit dem Science Lab Physik Basis PB (207 100S), 14 Versuche in der S I und S II durchgeführt werden.
Inhaltlich beschäftigen sich die Schülerinnen und Schüler mit Messmethoden, Körpereigenschaften und Flüssigkeiten. Beim Bearbeiten der lehrplangeforderten Themen werden sie auch in den Kompetenzen Kommunikation und Bewertung geschult. In Verbindung mit dem Mobile-CASSY 2 WLAN (524 005W2) ergeben sich weitere Auswertemöglichkeiten, die digitales Lernen ermöglichen.
Lieferumfang:
Menge Kat.-Nr. Bezeichnung
1 309 83 Trichter PE 40 mm Ø
1 311 53 Messschieber (Schieblehre)
1 340 90 Gummiringe, Satz 8
1 362 291 Doppelrohrhalter
2 362 292 Durchsichtiges Kunststoffrohr mit 2 Kappen
1 362 301 Drucksonde zur Hydrostatik
1 362 352 Stahlkugeln in Dose
1 362 36 Kapillargerät
1 590 08 Messzylinder SAN 100 ml
1 647 002 Geräteschub, hoch
1 664 123 Becherglas PP, 250 ml, n.F.
1 664 181 Petrischale 60 mm
1 665 226 Schlauchverbinder PP, gerade, 6/8 mm Ø
1 665 240 Kunststoffrohr, 240 x 25 mm Ø
1 666 555 Universalklemme 0...80 mm
1 667 194 Silikonschlauch 7 mm Ø, 1 m
1 667 2545 Gummistopfen 1 Loch 6 mm, 17...23 mm Ø
1 667 257 Gummistopfen voll, 19...24 mm Ø
1 686 53 Runddose mit Deckel
207 111S Science Lab Mechanik ME1 (Satz)
Zusätzlich erforderlich:
Menge Kat.-Nr. Bezeichnung
1 207 100S Science Lab Physik Basis PB (Satz)
1 520 711 LIT-digital: LP1 Science Lab Mechanik
Zusätzlich empfohlen:
Menge Kat.-Nr. Bezeichnung
1 315 234 Elektronische Waage MAULtronic S
1 520 7111DE LIT-print: LP1.1 Messmethoden, Körpereigenschaften und Flüssigkeiten
1 520 71 LIT-digital: LP Science Lab Physik
1 647 003 Deckel zu Geräteschub

n Schülerinnen und Schüler lernen Maßeinheiten kennen
n einfache Berechnungen zur Dichtebestimmung können durchgeführt werden
n eine „Drucksonde“ zur Messung des hydrostatischen Drucks ist im Schub enthalten
n Geräte können zu vielen Versuchen zusammengebaut werden
n modular aufbauend auf die Geräte in Physik Basis
n Kompetenzerwerb: Verfassen von Versuchsprotokollen; Unterscheidung zwischen Beobachtung, Messung und Auswertung
SCHÜLERMESSGERÄT DIGITALER UNTERRICHT


Mobile-CASSY 2 WLAN
Das universelle Schülermessgerät mit WLAN für alle Messaufgaben in der Physik, Chemie und Biologie.
524 005W2 Mobile-CASSY 2 WLAN
Detaillierte Informationen zum Mobile-CASSY 2 WLAN finden Sie im Internet unter www.leybold-shop.de/524005W2.
Drucksensor S, ± 70 hPa
EMPFOHLENE SENSOREN
Zur Messung sehr kleiner Druckdifferenzen mit CASSY (524 013, 524 006, 524 018, 524 005W2) oder den Universellen Messinstrumenten (531 835, 531 836, 531 837), z.B. bei Strömungsexperimenten im Windkanal (373 12) oder dem Venturi-Rohr (aus 373 091). Anschluss ans Experiment über zwei Schlauchwellen (4 mm Ø).
Lieferung einschließlich PVC-Schlauch (667 192) und zwei Verbindungsstücken mit Schlaucholive (604 520).
524 066
Drucksensor S, ± 70 hPa
Detaillierte Informationen zu diesem und anderen Sensoren finden Sie im Internet unter www.leybold-shop.de.

Hier finden Sie eine Übersicht über unsere Literaturpakete.
Detaillierte Informationen zu unserer Literatur finden Sie im Internet unter www.leybold-shop.de.
THEMA

FACHGEBIET

UNTERRICHTSFACH

LIT-print: LP1.1 Messmethoden, Körpereigenschaften und Flüssigkeiten
Gedruckte Version
Themas in einem Ringordner
Ausführliche Versuchsanleitungen zum Science Lab Schub ME1 (207 111S) und Science Lab Physik Basis PB (207 100S). Beschreibt 14 Versuche aus dem Thema Messmethoden, Körpereigenschaften und Flüssigkeiten.
Versuchsthemen:
Messung von Länge und Zeit; Messung von Masse und Dichte; Druck in Flüssigkeiten; Kräfte auf Körper in Flüssigkeiten; Kräfte an der Oberfläche von Flüssigkeiten
520 7111DE LIT-print: LP1.1 Messmethoden, Körpereigenschaften und Flüssigkeiten
LIT-digital: LP1 Science Lab Mechanik
Digitale Version EINES Fachgebiets
Ausführliche Versuchsanleitungen zum Themengebiet Mechanik des Unterrichtsfachs Physik im Science Lab. Beschreibt mehr als 95 Versuche zu den Themen Messmethoden, Körpereigenschaften und Flüssigkeiten; Kräfte, Einfache Maschinen, Schwingungen; Lineare Bewegung, Freier Fall und Stoßversuche; Akustik.
Enthält alle interaktiven Versuchsanleitungen (Lab Docs) als html-Datei.
520 711 LIT-digital: LP1 Science Lab Mechanik
LIT-digital: LP Science Lab Physik
Digitale Version ALLER Fachgebiete
Ausführliche Versuchsanleitungen zum Unterrichtsfach Physik im Science Lab. Beschreibt ca. 460 Versuche zu den Fachgebieten Mechanik, Energie, Elektrik und Elektronik, Optik, Atom- und Kernphysik sowie Informatik und Technik.
Enthält alle interaktiven Versuchsanleitungen (Lab Docs) als html-Datei.
520 71 LIT-digital: LP Science Lab Physik
Technische Daten der digitalen Version:
• Lieferung als Produktschlüssel (Aktivierung & Auswahl der Literatursprache über https://register.leylab.de notwendig)
• Systemvoraussetzungen:
Document Center:
PC mit Windows 7 oder höher; Internetzugang während der Installation; lokales Netzwerk zur Verteilung an die Schüler
Leylab:
- PC, Tablet oder Smartphone mit gängigem Browser; Internetzugang





n leichter Zugang zu ersten physikalischen Größen
n effektvolle Versuche, die schnell zu inhaltsbezogenen Kompetenzen führen und Schüler für den Physikunterricht begeistern
n Verknüpfung von „Wiegen“ als Alltagserfahrung mit physikalischen Fragestellungen zur „Gewichtskraft“




n leicht zu handhabende Geräte n überschaubare Anzahl an Geräten n schneller Aufbau


LP1.2.1 Mechanik fester Körper
LP1.2.1.1
LP1.2.1.2
LP1.2.1.3
LP1.2.1.4
Reibungsarten fester Körper Gleitreibung (quantitativ) Schwerpunkt Standfestigkeit
LP1.2.2 Verformung durch eine Kraft
LP1.2.2.1
LP1.2.2.2
LP1.2.2.3
Dehnung einer Schraubenfeder (Hookesches Gesetz) Dehnung eines Gummiringes Auslenkung einer Blattfeder
LP1.2.3 Zusammensetzung und Zerlegung von Kräften
LP1.2.3.1
LP1.2.3.2
LP1.2.3.3
Zusammensetzung von Kräften gleicher oder entgegengesetzter Richtung Zusammensetzung von Kräften vorgegebener Beträge Zerlegung einer Kraft in Kraftkomponenten
LP1.2.4 Hebel
LP1.2.4.1
LP1.2.4.2
LP1.2.4.3
LP1.2.4.4
LP1.2.4.5
LP1.2.4.6
Zweiseitiger Hebel Zweiseitiger Hebel mit mehreren angreifenden Kräften Balkenwaage Einseitiger Hebel Wellrad Riemengetriebe
LP1.2.5 Rolle und schiefe Ebene
LP1.2.5.1
LP1.2.5.2
LP1.2.5.3
LP1.2.5.4
LP1.2.5.4C
LP1.2.5.5
LP1.2.5.5C
LP1.2.5.6
LP1.2.5.6C
LP1.2.5.7
LP1.2.5.7C
LP1.2.5.8
Feste Rolle Lose Rolle
Aufzug mit zwei Rollen
Flaschenzug 1 (offenen Bauweise)
Flaschenzug 1 (offenen Bauweise) (mit Mobile-CASSY 2 WLAN)
Flaschenzug 2 (kompakte Bauweise)
Flaschenzug 2 (kompakte Bauweise) (mit Mobile-CASSY 2 WLAN)
Kräfte an der schiefen Ebene
Kräfte an der schiefen Ebene (mit Mobile-CASSY 2 WLAN)
Arbeit an der schiefen Ebene
Arbeit an der schiefen Ebene (mit Mobile-CASSY 2 WLAN) Energieumwandlung
LP1.2.6 Harmonische Schwingungen
LP1.2.6.1
LP1.2.6.1C
LP1.2.6.2
LP1.2.6.2C
LP1.2.6.3
LP1.2.6.3C
LP1.2.6.4
Fadenpendel (Mathematisches Pendel)
Fadenpendel (Mathematisches Pendel) (mit Mobile-CASSY 2 WLAN)
Stabpendel (Physikalisches Pendel)
Stabpendel (Physikalisches Pendel) (mit Mobile-CASSY 2 WLAN)
Schraubenfederpendel
Schraubenfederpendel (mit Mobile-CASSY 2 WLAN) Schwingungsbilder
LP1.2.7 Erzwungene Schwingungen und stehende Wellen
LP1.2.7.1
LP1.2.7.2
LP1.2.7.2C
LP1.2.7.3
LP1.2.7.4
Erzwungene Schwingungen von Pendeln
Schwingungen mechanisch gekoppelter Stabpendel
Schwingungen mechanisch gekoppelter Stabpendel (mit Mobile-CASSY 2 WLAN) Frequenzen stehender Seilwellen
Stehende Schraubenfederwellen – Bäuche und Knoten in Abhängigkeit von der Erregerfrequenz
LP1.2.8 Überlagerung von Wellen
LP1.2.8.1 Überlagerung von Seilwellen gleicher Frequenz

Flaschenzug 2 (kompakte Bauweise)



Kat.-Nr. Bezeichnung
207 100S Science Lab Physik Basis PB (Satz)
207 112S Science Lab Mechanik ME2 (Satz)
Eine Auswahl der Literaturpakete finden Sie auf den nachfolgenden Seiten.


Schülerexperimentiersatz des Schülerversuche-Systems Science Lab im Bereich Physik. Aufbaumaterial für eine Arbeitsgruppe in gerätegeformter Aufbewahrung. Mit dem Gerätesatz ME2 können, zusammen mit dem Science Lab Physik Basis PB (207 100S), mehr als 40 Versuche in der S I und S II durchgeführt werden. Inhaltlich beschäftigen sich die Schülerinnen und Schüler mit Kräften, einfachen Maschinen und Schwingungen. Beim Bearbeiten der lehrplangeforderten Themen werden sie auch in den Kompetenzen Kommunikation und Bewertung geschult. In Verbindung mit dem Mobile-CASSY 2 WLAN (524 005W2) ergeben sich weitere Auswertemöglichkeiten, die digitales Lernen ermöglichen.
Lieferumfang:
Menge Kat.-Nr. Bezeichnung
1 314 02 Zug- und Druckkraftmesser 3,0 N
1 340 811 Steckachse
1 340 82 Doppelskala
1 340 831 Hebel 37,5 cm
1 340 87 Rollenhaken
1 340 89 Kupplungsstecker 4 mm
1 340 90 Gummiringe, Satz 8
2 340 911 Rolle Ø 50 mm, steckbar
2 340 921 Rolle Ø 100 mm, steckbar
2 340 930 Rollenbrücke
2 342 47 Waagschale mit Schalenbügel
2 346 034 Stabpendel 31,5 cm
1 346 05 Klemmblock für Pendel
1 352 07 Schraubenfeder 10 N/m
1 352 08 Schraubenfeder 25 N/m
1 590 27 Wägesatz 1 g bis 50 g
1 647 002 Geräteschub, hoch
1 686 57 Gummiseil 3 m
Zusätzlich erforderlich:
Menge Kat.-Nr. Bezeichnung
1 207 100S Science Lab Physik Basis PB (Satz)
1 520 711 LIT-digital: LP1 Science Lab Mechanik
Zusätzlich empfohlen:
Menge Kat.-Nr. Bezeichnung
1 501 45 Experimentierkabel 19 A, 50 cm, rot/blau, Paar
1 520 7112DE LIT-print: LP1.2 Kräfte, Einfache Maschinen, Schwingungen
1 520 71 LIT-digital: LP Science Lab Physik
1 522 621 Funktionsgenerator S 12
1 524 005W2 Mobile-CASSY 2 WLAN
2 524 431 Lichtschranke M
1 524 434 Kraftsensor M, ±50 N
1 579 42 Motor mit Schwinghebel, STE 2/19
1 647 003 Deckel zu Geräteschub

n der Begriff „Hebel“ wird veranschaulicht mit Hilfe einer Balkenwaage n variabler Aufbau mit unseren Rollen: von fester Rolle über Flaschenzüge bis zum Getriebe
n Versuche, bei denen Schwingungen per Hand angeregt werden und mit geregelter Frequenz (mit zusätzlichem Motor) sind ebenso möglich
n modular aufbauend auf die Geräte in Physik Basis
n Kompetenzerwerb: Aufbau komplexerer Experimente
SCHÜLERMESSGERÄT DIGITALER UNTERRICHT



Mobile-CASSY 2 WLAN
Das universelle Schülermessgerät mit WLAN für alle Messaufgaben in der Physik, Chemie und Biologie.
524 005W2 Mobile-CASSY 2 WLAN
Detaillierte Informationen zum Mobile-CASSY 2 WLAN finden Sie im Internet unter www.leybold-shop.de/524005W2.
Kraftsensor M, ±50 N
EMPFOHLENE SENSOREN
Zur Messung von Kraftkomponenten bis ±50 N (z. B. Federpendel oder Fliehkraftkomponenten) mit Mobile-CASSY 2 (524 005W2). Seine steife Konstruktion ermöglicht es, Kraftkomponenten bei beliebiger Lage des Kraftsensors zu messen.
524 434
Kraftsensor M, ±50 N
Lichtschranke M
Kaskadierbare Lichtschranke zur Messung von Periodendauern, Fahrzeiten, Wegen und Geschwindigkeiten auf der Schülerfahrbahn oder beim freien Fall mit dem Mobile-CASSY 2 (524 005W2).
524 431
Lichtschranke M
Detaillierte Informationen zu diesen und anderen Sensoren finden Sie im Internet unter www.leybold-shop.de
Hier finden Sie eine Übersicht über unsere Literaturpakete. Detaillierte Informationen zu unserer Literatur finden Sie im Internet unter www.leybold-shop.de.

FACHGEBIET

UNTERRICHTSFACH

LIT-print: LP1.2 Kräfte, Einfache Maschinen, Schwingungen
Ausführliche Versuchsanleitungen zum Science Lab Schub ME2 (207 112S) und Science Lab Physik Basis PB (207 100S). Beschreibt 41 Versuche aus dem Thema Kräfte, Einfache Maschinen und Schwingungen.
Versuchsthemen:
Mechanik fester Körper; Verformung durch eine Kraft; Zusammensetzung und Zerlegung von Kräften; Hebel; Aufbauten und schiefe Ebene; Harmonische Schwingungen; Erzwungene Schwingungen; Überlagerung von Wellen
520 7112DE LIT-print: LP1.2 Kräfte, Einfache Maschinen, Schwingungen
LIT-digital: LP1 Science Lab Mechanik
Digitale
Ausführliche Versuchsanleitungen zum Themengebiet Mechanik des Unterrichtsfachs Physik im Science Lab. Beschreibt mehr als 95 Versuche zu den Themen Messmethoden, Körpereigenschaften und Flüssigkeiten; Kräfte, Einfache Maschinen, Schwingungen; Lineare Bewegung, Freier Fall und Stoßversuche; Akustik.
Enthält alle interaktiven Versuchsanleitungen (Lab Docs) als html-Datei.
520 711 LIT-digital: LP1 Science Lab Mechanik
LIT-digital: LP Science Lab Physik
Ausführliche Versuchsanleitungen zum Unterrichtsfach Physik im Science Lab. Beschreibt ca. 460 Versuche zu den Fachgebieten Mechanik, Energie, Elektrik und Elektronik, Optik, Atom- und Kernphysik sowie Informatik und Technik.
Enthält alle interaktiven Versuchsanleitungen (Lab Docs) als html-Datei.
520 71 LIT-digital: LP Science Lab Physik
Technische Daten der digitalen Version:
• Lieferung als Produktschlüssel (Aktivierung & Auswahl der Literatursprache über https://register.leylab.de notwendig)
• Systemvoraussetzungen:
Document Center:
PC mit Windows 7 oder höher; Internetzugang während der Installation; lokales Netzwerk zur Verteilung an die Schüler
Leylab:
- PC, Tablet oder Smartphone mit gängigem Browser; Internetzugang





Die fantastischen Vier
FLASCHENZUG
LOSE ROLLE
RIEMENGETRIEBE
SCHIEFE EBENE
IN WENIGEN SCHRITTEN ZU SPANNENDEN EXPERIMENTEN











Die Rolle findet zudem auch Anwendung in Schülerversuchen der Elektrik.
LP1.3.1 Gleichförmige Bewegung
LP1.3.1.1C
LP1.3.1.2C
Zusammenhang zwischen Weg und Zeit (mit Mobile-CASSY 2 WLAN)
Einfluss der Reibung - Messung von Geschwindigkeiten (mit Mobile-CASSY 2 WLAN)
LP1.3.2 Gleichmäßig beschleunigte Bewegung
LP1.3.2.1C
LP1.3.2.2C
LP1.3.2.3C
LP1.3.2.4C
Zusammenhang zwischen Weg und Zeit (mit Mobile-CASSY 2 WLAN)
Momentangeschwindigkeit (mit Mobile-CASSY 2 WLAN)
Gleichmäßig beschleunigte Bewegung mit dem Speichenrad (mit Mobile-CASSY 2 WLAN)
Zeit-Geschwindigkeit-Gesetz (mit Mobile-CASSY 2 WLAN)
LP1.3.3 Newtonsche Gesetze
LP1.3.3.1C
LP1.3.3.2C Zusammenhang zwischen Kraft und Beschleunigung (mit Mobile-CASSY 2 WLAN)
Zusammenhang zwischen Masse und Beschleunigung (mit Mobile-CASSY 2 WLAN)
LP1.3.4 Freier Fall
LP1.3.4.1C
LP1.3.4.2C
Bestimmung der Erdbeschleunigung über s(t)-Diagramm (mit Mobile-CASSY 2 WLAN)
Bestimmung der Erdbeschleunigung über v(t)-Diagramm (mit Mobile-CASSY 2 WLAN)
LP1.3.5 Elastische Stoßversuche
LP1.3.5.1C
LP1.3.5.2C
LP1.3.5.3C
LP1.3.5.4C
Elastischer Stoß zwischen zwei fahrenden Wagen gleicher Masse (mit Mobile-CASSY 2 WLAN)
Elastischer Stoß zwischen fahrenden und ruhenden Wagen gleicher Masse (mit Mobile-CASSY 2 WLAN)
Elastischer Stoß zwischen fahrenden und ruhenden Wagen (m1 < m2) (mit Mobile-CASSY 2 WLAN)
Elastischer Stoß zwischen fahrenden und ruhenden Wagen (m1 > m2) (mit Mobile-CASSY 2 WLAN)
LP1.3.6 Unelastische Stoßversuche
LP1.3.6.1C
LP1.3.6.2C
LP1.3.6.3C
LP1.3.6.4C
Unelastischer Stoß zwischen zwei fahrenden Wagen gleicher Masse (mit Mobile-CASSY 2 WLAN)
Unelastischer Stoß zwischen fahrenden und ruhenden Wagen gleicher Masse (mit Mobile-CASSY 2 WLAN)
Unelastischer Stoß zwischen fahrenden und ruhenden Wagen (m1 < m2) (mit Mobile-CASSY 2 WLAN)
Unelastischer Stoß zwischen fahrenden und ruhenden Wagen (m1 > m2) (mit Mobile-CASSY 2 WLAN)
LP1.3.7 Impulserhaltung
LP1.3.7.1C
LP1.3.7.2C
Explosionsstoß bei Wagen gleicher Masse (mit Mobile-CASSY 2 WLAN)
Explosionsstoß bei Wagen unterschiedlicher Masse (mit Mobile-CASSY 2 WLAN)


LP1.3.4.1C Bestimmung der Erdbeschleunigung über s(t)-Diagramm

Kat.-Nr. Bezeichnung
207 113S Science Lab Mechanik ME3 (Satz)
Eine Auswahl der Literaturpakete finden Sie auf den nachfolgenden Seiten.



Schülerexperimentiersatz des Schülerversuche-Systems Science Lab im Bereich Physik. Aufbaumaterial für eine Arbeitsgruppe in gerätegeformter Aufbewahrung. Mit dem Gerätesatz ME3 können, zusammen mit dem Mobile-CASSY 2 WLAN (524 005W2) 20 Versuche in der S I und S II durchgeführt werden.
Inhaltlich beschäftigen sich die Schülerinnen und Schüler mit Dynamik und Bewegung. Beim Bearbeiten der lehrplangeforderten Themen werden sie auch in den Kompetenzen Kommunikation und Bewertung geschult. Und die Kombination mit dem Mobile-CASSY 2 WLAN macht digitales Lernen möglich.
Lieferumfang:
Menge Kat.-Nr. Bezeichnung
1 309 48 Angelschnur
1 aus 309 76 Paste für inelastischen Stoß
1 337 00 Messwagen
1 337 03 Feder und Prallplatte
1 337 04 Antriebsmassen, Satz
1 337 05 Zusatzmasse 100 g
1 337 08 Zusatzmasse 50 g
1 352 513 Stahlkugel 20 mm
2 460 95 Klemmreiter
2 524 431 Lichtschranke M
1 524 4321 Lichtschrankengehäuse
1 524 4322 Speichenrad
1 524 4323 Startvorrichtung, Wagen
1 524 4324 Startvorrichtung, Kugel
1 647 001 Geräteschub, niedrig
1 686 60 Verlängerungsstift
Zusätzlich erforderlich:
Menge Kat.-Nr. Bezeichnung
1 460 81 Präzisions-Metallschiene, 100 cm
1 520 711 LIT-digital: LP1 Science Lab Mechanik
1 524 005W2 Mobile-CASSY 2 WLAN
Zusätzlich empfohlen:
Menge Kat.-Nr. Bezeichnung
1 337 00 Messwagen
1 460 82 Präzisions-Metallschiene, 50 cm
1 520 7113DE LIT-print: LP1.3 Lineare Bewegung, Freier Fall und Stoßversuche
1 520 71 LIT-digital: LP Science Lab Physik
1 647 003 Deckel zu Geräteschub

n Lichtschranke mit flexibler Halterung, z. B. für Speichenrad oder Startauslösung (und durch kleine Öffnung sehr schaltgenau)
n kaskadierbare Lichtschranken sind im Schub enthalten
n Freier Fall als Schülerversuch durchführbar
n Versuche im horizontalen Aufbau (Bewegungen auf der Fahrbahn) und im vertikalen Aufbau (Freier Fall) möglich
n Startvorrichtungen für Kugel und Fahrbahnwagen sind mit der digitalen Messung gekoppelt
n leichte, handliche Präzisionsmetallschiene in unterschiedlichen Längen verfügbar
n Fahrbahnwagen mit reibungsarmen Lauf und geschützten Radlagern und Wegrollsicherung
n Kompetenzerwerb: Digitale Aufnahme & Auswertung der Messwerte mit dem Mobile-CASSY 2 WLAN
SCHÜLERMESSGERÄT


Mobile-CASSY 2 WLAN
DIGITALER UNTERRICHT
Das universelle Schülermessgerät mit WLAN für alle Messaufgaben in der Physik, Chemie und Biologie.
524 005W2 Mobile-CASSY 2 WLAN
Detaillierte Informationen zum Mobile-CASSY 2 WLAN finden Sie im Internet unter www.leybold-shop.de/524005W2.
Lichtschranke M
IM LIEFERUMFANG ENTHALTEN
Kaskadierbare Lichtschranke zur Messung von Periodendauern, Fahrzeiten, Wegen und Geschwindigkeiten auf der Schülerfahrbahn oder beim freien Fall mit dem Mobile-CASSY 2 (524 005W2).
Detaillierte Informationen zu diesem und anderen Sensoren finden Sie im Internet unter www.leybold-shop.de.
Hier finden Sie eine Übersicht über unsere Literaturpakete. Detaillierte Informationen zu unserer Literatur finden Sie im Internet unter www.leybold-shop.de.

FACHGEBIET

UNTERRICHTSFACH

LIT-print: LP1.3 Lineare Bewegung, Freier Fall und Stoßversuche
Gedruckte Version EINES Themas in einem Ringordner
Ausführliche Versuchsanleitungen zum Science Lab Schub ME3 (207 113S). Beschreibt 20 Versuche aus dem Thema Lineare Bewegung, Freier Fall und Stoßversuche.
Versuchsthemen:
Gleichförmige Bewegung; Gleichmäßig beschleunigte Bewegung; Newtonsche Gesetze; Freier Fall; Elastische Stoßversuche; Unelastische Stoßversuche; Impulserhaltung
520 7113DE LIT-print: LP1.3 Lineare Bewegung, Freier Fall und Stoßversuche
LIT-digital: LP1 Science Lab Mechanik
Digitale Version EINES Fachgebiets
Ausführliche Versuchsanleitungen zum Themengebiet Mechanik des Unterrichtsfachs Physik im Science Lab. Beschreibt mehr als 95 Versuche zu den Themen Messmethoden, Körpereigenschaften und Flüssigkeiten; Kräfte, Einfache Maschinen, Schwingungen; Lineare Bewegung, Freier Fall und Stoßversuche; Akustik.
Enthält alle interaktiven Versuchsanleitungen (Lab Docs) als html-Datei.
520 711 LIT-digital: LP1 Science Lab Mechanik
LIT-digital: LP Science Lab Physik
Digitale Version ALLER Fachgebiete
Ausführliche Versuchsanleitungen zum Unterrichtsfach Physik im Science Lab. Beschreibt ca. 460 Versuche zu den Fachgebieten Mechanik, Energie, Elektrik und Elektronik, Optik, Atom- und Kernphysik sowie Informatik und Technik.
Enthält alle interaktiven Versuchsanleitungen (Lab Docs) als html-Datei.
520 71 LIT-digital: LP Science Lab Physik
Technische Daten der digitalen Version:
• Lieferung als Produktschlüssel (Aktivierung & Auswahl der Literatursprache über https://register.leylab.de notwendig)
• Systemvoraussetzungen:
Document Center:
PC mit Windows 7 oder höher; Internetzugang während der Installation; lokales Netzwerk zur Verteilung an die Schüler
Leylab:
- PC, Tablet oder Smartphone mit gängigem Browser; Internetzugang





Versuch LP1.3.2.3C
Gleichmäßig beschleunigte
Bewegung mit dem Speichenrad
n mit Musterantworten und Beispielmessungen
n während der Messung werden die Live-Messwerte aus dem Mobile-CASSY 2 WLAN in das Lab Doc übertragen und n in Echtzeit in den interaktiven Messinstrumenten, Tabellen und Diagrammen angezeigt

In unserem Beispiel sieht man den aktuell gemessenen Weg s = 0,285 m sowohl im Mobile-CASSY 2 WLAN Display als auch im Lab Doc.
Versuche zur gleichförmigen & beschleunigten Bewegung sowie Stoßversuche EIN
HORIZONTAL: FAHRBAHN

VERTIKAL: FREIER FALL


Versuche zum Freien Fall
n Geräte, wie die Lichtschranke, werden in vielen Versuchen genutzt und sind den Schülern und Schülerinnen damit vertraut, geringer Zeitbedarf beim Versuchsaufbau
Materialeinsatz
LP1.4.1 Schallausbreitung
LP1.4.1.1
LP1.4.1.2
LP1.4.1.3
Schallausbreitung in der Luft Schallausbreitung in Festkörpern Schallausbreitung im Wasser
LP1.4.2 Schwingungen und Töne
LP1.4.2.1
LP1.4.2.2
LP1.4.2.3
LP1.4.2.4
LP1.4.2.5C
Schwingungen einer Stimmgabel 1
Schwingungen einer Stimmgabel 2 Tonentstehung 1 Tonentstehung 2
Schwingungsbilder (mit Mobile-CASSY 2 WLAN)
LP1.4.3 Lärmanalyse
LP1.4.3.1
LP1.4.3.2
LP1.4.3.3
LP1.4.3.3C
LP1.4.3.4
LP1.4.3.4C
LP1.4.3.5C
Lautstärke messen (mit Mobile-CASSY 2 WLAN)
Lärm vs. Musik
Schutzmaßnahmen gegen Lärm
Schutzmaßnahmen gegen Lärm (mit Mobile-CASSY 2 WLAN)
Reflexion des Schalls
Reflexion des Schalls (mit Mobile-CASSY 2 WLAN)
Frequenzen messen (mit Mobile-CASSY 2 WLAN)
LP1.4.4 Resonanz und Schwebung
LP1.4.4.1
LP1.4.4.2
LP1.4.4.3
LP1.4.4.3
Resonanzkörper
Sender-Empfänger-Prinzip
Schwebung
Schwebung (mit Mobile-CASSY 2 WLAN)
LP1.4.5 Schallgeschwindigkeit
LP1.4.5.1C
LP1.4.5.2C
Schallgeschwindigkeit bestimmen (mit Mobile-CASSY 2 WLAN)
Schallgeschwindigkeit bestimmen mit 2 Mikrofonen (mit Mobile-CASSY 2 WLAN)


LP1.4.3.3C Schwebung
ÜBERSICHT

Kat.-Nr. Bezeichnung
207 114S Science Lab Mechanik ME4 (Satz)
Eine Auswahl der Literaturpakete finden Sie auf den nachfolgenden Seiten.

Literatur


Schülerexperimentiersatz des Schülerversuche-Systems Science Lab im Bereich Physik. Aufbaumaterial für eine Arbeitsgruppe in gerätegeformter Aufbewahrung. Mit dem Gerätesatz ME4 können mehr als 21 Versuche in der S I und S II durchgeführt werden.
Inhaltlich beschäftigen sich die Schülerinnen und Schüler mit akustischen Schwingungen und Schall. Beim Bearbeiten der lehrplangeforderten Themen werden sie auch in den Kompetenzen Kommunikation und Bewertung geschult. In Verbindung mit dem Mobile-CASSY 2 WLAN (524 005W2) ergeben sich weitere Auswertemöglichkeiten, die digitales Lernen ermöglichen.
Lieferumfang:
Menge Kat.-Nr. Bezeichnung
1 307 70 Schlauch 8 mm Ø, 1 m, Kunststoff
1 311 10 Lineal 15 cm
1 340 90 Gummiringe, Satz 8
1 414 42 Resonanzstimmgabel
1 501 13 Adapterkabel 9 V/4 mm
3 602 0021 Reagenzglas DURAN 16 x 160 mm
1 647 002 Geräteschub, hoch
1 664 123 Becherglas PP, 250 ml, n.F.
2 665 009 Trichter PP, 75 mm Ø
1 667 243 Gummiblasen (Luftballons), Satz 10
1 685 45 Batterie 9 V (9-Volt-Block)
1 aus 688 169 Schallabsorber, 2 Stück
Zusätzlich erforderlich:
Menge Kat.-Nr. Bezeichnung
1 520 711 LIT-digital: LP1 Science Lab Mechanik
Zusätzlich empfohlen:
Menge Kat.-Nr. Bezeichnung
1 414 42 Resonanzstimmgabel
1 520 7114DE LIT-print: LP1.4 Akustik
1 520 71 LIT-digital: LP Science Lab Physik
1 524 005W2 Mobile-CASSY 2 WLAN
1 524 442 Mikrofon M
1 647 003 Deckel zu Geräteschub

n Durchführung von Versuchen in der S I (qualitativ) und S II (quantitativ) n mit Mobile-CASSY 2 WLAN und dem Mikrofon M auch anspruchsvolle Akustik möglich (z. B. Schwingungen)
n Untersuchung von selbst mitgebrachten Materialien bei der Lärmanalyse möglich n Kompetenzerwerb: Vergleich von selbst gemessenen Werten und Literaturwerten am Beispiel vom Thema Schallgeschwindigkeit
SCHÜLERMESSGERÄT

SENSOREN

Mobile-CASSY 2 WLAN
DIGITALER UNTERRICHT
Das universelle Schülermessgerät mit WLAN für alle Messaufgaben in der Physik, Chemie und Biologie.
524 005W2 Mobile-CASSY 2 WLAN
Detaillierte Informationen zum Mobile-CASSY 2 WLAN finden Sie im Internet unter www.leybold-shop.de/524005W2.
Mikrofon M
EMPFOHLENE SENSOREN
Zur Messung von Schallpegel (dBA), Frequenz und dem Verlauf akustischer Signale mit dem Mobile-CASSY 2 (524 005W2).
524 442 Mikrofon M
Detaillierte Informationen zu diesem und anderen Sensoren finden Sie im Internet unter www.leybold-shop.de.
Hier finden Sie eine Übersicht über unsere Literaturpakete.
Detaillierte Informationen zu unserer Literatur finden Sie im Internet unter www.leybold-shop.de.

FACHGEBIET

UNTERRICHTSFACH

LIT-print: LP1.4 Akustik
Gedruckte Version EINES Themas in einem Ringordner
Ausführliche Versuchsanleitungen zum Science Lab Schub ME4 (207 114S). Beschreibt 21 Versuche aus dem Thema Akustik.
Versuchsthemen: Schallausbreitung; Schwingungen und Töne; Lärmanalyse; Resonanz und Schwebung; Schallgeschwindigkeit
520 7114DE LIT-print: LP1.4 Akustik
LIT-digital: LP1 Science Lab Mechanik
Digitale Version EINES Fachgebiets
Ausführliche Versuchsanleitungen zum Themengebiet Mechanik des Unterrichtsfachs Physik im Science Lab. Beschreibt mehr als 95 Versuche zu den Themen Messmethoden, Körpereigenschaften und Flüssigkeiten; Kräfte, Einfache Maschinen, Schwingungen; Lineare Bewegung, Freier Fall und Stoßversuche; Akustik.
Enthält alle interaktiven Versuchsanleitungen (Lab Docs) als html-Datei. 520 711 LIT-digital: LP1 Science Lab Mechanik
LIT-digital: LP Science Lab Physik
Digitale Version ALLER Fachgebiete
Ausführliche Versuchsanleitungen zum Unterrichtsfach Physik im Science Lab. Beschreibt ca. 460 Versuche zu den Fachgebieten Mechanik, Energie, Elektrik und Elektronik, Optik, Atom- und Kernphysik sowie Informatik und Technik.
Enthält alle interaktiven Versuchsanleitungen (Lab Docs) als html-Datei.
520 71 LIT-digital: LP Science Lab Physik
Technische Daten der digitalen Version:
• Lieferung als Produktschlüssel (Aktivierung & Auswahl der Literatursprache über https://register.leylab.de notwendig)
• Systemvoraussetzungen:
Document Center:
PC mit Windows 7 oder höher; Internetzugang während der Installation; lokales Netzwerk zur Verteilung an die Schüler
Leylab:
- PC, Tablet oder Smartphone mit gängigem Browser; Internetzugang





mit dem

Bekannte Alltagserfahrungen und physikalische Phänomene unter Einsatz digitaler Mess- und Endgeräte erforschen

n die bei der Überlagerung von zwei Schwingungen entstehende Schwebung kann am Mobile-CASSY 2 WLAN einfach gemessen und dargestellt werden
n der komplexe Graph mit zu- und abnehmender Amplitude ist nur digital und mit einem schnellen Messsystem erfassbar

MOBILE-CASSY 2 WLAN
n automatische Erkennung des Sensors Mikrofon M n einfache Verbindung zum Lab Doc „Schwebung“
n Einstellungen werden aus dem Lab Doc übergeben
n schnelle Messwertaufnahme
n Messwerte werden direkt in die Tabellen und Diagramme des Lab Docs übernommen
n Schüler hat die Messwerte und die Darstellung der Schwebung im eigenen digitalen Protokoll
n auch als Standalone-Gerät einsetzbar mit großer, grafikfähiger Messwertanzeige für kontrastreiche Diagramme
Energie ist ein Thema, zu dem jeder schon mal etwas gehört hat. Unser Science Lab befasst sich zum einen mit dem klassischen Bereich Wärmelehre, zum anderen werden auch die Erneuerbaren Energien behandelt. Die dabei mögliche Speicherung von Energie mit einer Brennstoffzelle fehlt ebenfalls nicht. Stück für Stück werden die verschiedenen Komponenten in den Versuchen untersucht, womit sich letztendlich ganze Energieketten in einem Versuch aufbauen und nachvollziehen lassen.
Ein Basis-Schub und 3 Energie Schübe resultieren in drei Themengebiete mit insgesamt 64 Versuchen. Die optimale Versuchsauswahl, passend für alle Jahrgangsstufen, ist so gestaltet, dass die Versuche qualitativ und quantitativ durchgeführt werden können. Zudem ergibt sich ein hoher Alltagsbezug zum Thema Erneuerbare Energien, was für viel Motivation bei den Schülerinnen und Schülern sorgt.

LP2.2.2.1C Messung der Spannung an einem Windrad
Die Schülerinnen und Schüler bestimmen die Spannung an einem Windrad für unterschiedliche Windgeschwindigkeiten und unterschiedliche Abstände zwischen Windmaschine und Windrad. Für diesen Versuch benötigen Sie den Schub Science Lab Energie EG2 (207 122S)
VERSUCHSTHEMEN
LP2.1 WÄRMELEHRE
LP2.1.1 WÄRMEAUSDEHNUNG
LP2.1.2 WÄRMETRANSPORT
LP2.1.3 WÄRMEDÄMMUNG
LP2.1.4 WÄRMEKAPAZITÄTEN
LP2.1.5 AGGREGATZUSTÄNDE UND ÜBERGÄNGE
LP2.2 ERNEUERBARE ENERGIEN
LP2.2.1 SOLARENERGIE
LP2.2.2 WINDENERGIE
LP2.2.3 PELTIER-EFFEKT
LP2.2.4 ENERGIEEINSPEISUNG
LP2.2.5 ENERGIEUMWANDLUNG UND WIRKUNGSGRAD
LP2.3 BRENNSTOFFZELLEN
LP2.3.1 REVERSIBLE PEM-BRENNSTOFFZELLE
LP2.3.2 DER ELEKTROLYSEUR
LP2.3.3 DIE BRENNSTOFFZELLE





Weitere Informationen zu unseren lehrplankonformen Themen und Schülerversuchen sowie die dazugehörigen Schübe finden Sie auf den nachfolgenden Seiten.
LP2.1.1 Wärmeausdehnung
LP2.1.1.1
LP2.1.1.2
LP2.1.1.3
LP2.1.1.4
LP2.1.1.5
LP2.1.1.6
Wärmeverhalten von Wasser
Kalibrierung eines Thermometers
Längenausdehnung fester Körper
Wärmeverhalten eines Bimetalls
Erwärmung von Luft (bei konstantem Druck) Boyle-Mariotte
Erwärmung von Luft (bei konstantem Volumen)
LP2.1.2 Wärmetransport
LP2.1.2.1
LP2.1.2.2
LP2.1.2.3
LP2.1.2.4C
LP2.1.2.5
Wärmeempfinden
Wärmetransport in Flüssigkeiten
Temperaturabhängigkeit der Brownsche Molekularbewegung
Wärmeleitung in festen Körpern (mit Mobile-CASSY 2 WLAN)
Wärmetransport in Gasen
LP2.1.3 Wärmedämmung
LP2.1.3.1
LP2.1.3.2
LP2.1.3.3
Erwärmung von Wasser Abkühlung von Wasser Aufbau eines Kalorimeters
LP2.1.4 Wärmekapazitäten
LP2.1.4.1
LP2.1.4.2
LP2.1.4.3
LP2.1.4.4
Mischungstemperatur
Spezifische Wärmekapazität von Wasser
Spezifische Wärmekapazität fester Körper Wärmekapazität eines Kalorimeters
LP2.1.5 Aggregatzustände und Übergänge
LP2.1.5.1
LP2.1.5.1C
LP2.1.5.2
LP2.1.5.3
LP2.1.5.4
LP2.1.5.4C
LP2.1.5.5
Temperaturverlauf bei Erwärmung
Temperaturverlauf bei Erwärmung (mit Mobile-CASSY 2 WLAN)
Schmelzwärme von Eis
Kondensieren von Wasserdampf
Temperaturen bei Wasser-Salz-Mischungen
Temperaturen bei Wasser-Salz-Mischungen (mit Mobile-CASSY 2 WLAN)
Destillation

Die Schülerinnen und Schüler untersuchen die Wärmeleitung in festen Körpern. Sie beobachten den Wärmeübergang von einem warmen zu einem kalten Wasserbad. Dabei werden die Materialien Kupfer und Stahl benutzt. Für diesen Versuch benötigen Sie den Schub Science Lab Energie EG1 (207 121S)
ÜBERSICHT BENÖTIGTES MATERIAL

Kat.-Nr. Bezeichnung
207 121S Science Lab Energie EG1 (Satz)
Eine Auswahl der Literaturpakete finden Sie auf den nachfolgenden Seiten.



Schülerexperimentiersatz des Schülerversuche-Systems Science Lab im Bereich Physik. Aufbaumaterial für eine Arbeitsgruppe in gerätegeformter Aufbewahrung. Mit dem Gerätesatz EG1 können, zusammen mit dem Science Lab Physik Basis PB (207 100S), mehr als 20 Versuche in der S I und S II durchgeführt werden.
Inhaltlich beschäftigen sich die Schülerinnen und Schüler mit der Wärmelehre. Beim Bearbeiten der lehrplangeforderten Themen werden sie auch in den Kompetenzen Kommunikation und Bewertung geschult. In Verbindung mit dem Mobile-CASSY 2 WLAN (524 005W2) ergeben sich weitere Auswertemöglichkeiten, die digitales Lernen ermöglichen.
Lieferumfang:
Menge
1 301 09 Doppelmuffe S
1 309 42 Färbemittel, rot, 10 g
1 309 83 Trichter PE 40 mm Ø
1 340 82 Doppelskala
1 362 291 Doppelrohrhalter
2 362 292 Durchsichtiges Kunststoffrohr mit 2 Kappen
1 381 10 Steigrohr, Kunstglas
1 381 311 Bimetallstreifen
1 381 331 Zeiger für Längenausdehnung
1 381 334 Ausdehnungsrohr Al 400 mm x 8 mm Ø
1 381 335 Ausdehnungsrohr Fe 400 mm x 8 mm Ø
1 382 20 Rührthermometer -30...+110 °C, ungraduiert
1 382 21 Rührthermometer -10...+110 °C/1 K
1 384 24 Deckel zum Glas-Kalorimeter
1 384 502 Wärmeleitstab, Stahl
1 384 503 Wärmeleitstab, Kupfer
1 386 40 Glas-Kalorimeter
1 387 79 Flügelrad
1 590 08 Messzylinder SAN 100 ml
1 590 48 Tauchheizer 12 V/10 W
1 608 120 Wärmeschutznetz 120 mm x 120 mm
1 647 002 Geräteschub, hoch
1 664 130 Becherglas Boro 3.3, 250 ml, nF
1 664 181 Petrischale 60 mm
1 664 248 Erlenmeyerkolben Boro 3.3, 50 ml, eH
1 665 226 Schlauchverbinder PP, gerade, 6/8 mm Ø
1 666 555 Universalklemme 0...80 mm
1 666 573 Stativring mit Stiel 100 mm Ø
1 667 194 Silikonschlauch 7 mm Ø, 1 m
207 121S Science Lab Energie EG1 (Satz)
Zusätzlich erforderlich:
Menge Kat.-Nr. Bezeichnung
1 207 100S Science Lab Physik Basis PB (Satz)
1 520 712 LIT-digital: LP2 Science Lab Energie
1 521 487 AC/DC Netzgerät PRO 0...12 V/3 A
1 607 020 Sicherheitsgasschlauch mit Endmuffe 0,5 m
1 666 695 Bunsenbrenner, Erdgas
1 656 017* Teclubrenner, Allgas
* alternativ
Zusätzlich empfohlen:
Menge Kat.-Nr. Bezeichnung
1 520 7121DE LIT-print: LP2.1 Wärmelehre
1 520 71 LIT-digital: LP Science Lab Physik
1 524 005W2 Mobile-CASSY 2 WLAN
1 647 003 Deckel zu Geräteschub


n Untersuchung der Längenausdehnung und Wärmeleitung verschiedener Materialien n modular aufbauend auf die Geräte in Physik Basis PB n Verständnis der Funktionsweisen eines Kalorimeters
SCHÜLERMESSGERÄT


Mobile-CASSY 2 WLAN
Das universelle Schülermessgerät mit WLAN für alle Messaufgaben in der Physik, Chemie und Biologie.
524 005W2
Mobile-CASSY 2 WLAN
Detaillierte Informationen zum Mobile-CASSY 2 WLAN finden Sie im Internet unter www.leybold-shop.de/524005W2.
Temperaturfühler NiCr-Ni, schnell, Typ K
Bereits im Lieferumfang des Mobile-CASSY 2 WLAN (524 005W2) enthalten.
IM LIEFERUMFANG
Detaillierte Informationen zu diesem und anderen Sensoren finden Sie im Internet unter www.leybold-shop.de.

Hier finden Sie eine Übersicht über unsere Literaturpakete.
Detaillierte Informationen zu unserer Literatur finden Sie im Internet unter www.leybold-shop.de.
LIT-print: LP2.1 Wärmelehre

FACHGEBIET

Gedruckte Version EINES Themas in einem Ringordner
Ausführliche Versuchsanleitungen zum Science Lab Schub EG1 (207 121S) und Science Lab Physik Basis PB (207 100S). Beschreibt 25 Versuche aus dem Thema Wärmelehre.
Versuchsthemen: Wärmeausdehnung; Wärmetransport; Wärmedämmung; Wärmekapazität; Aggregatzustände
520 7121DE LIT-print: LP2.1 Wärmelehre
LIT-digital: LP2 Science Lab Energie
Digitale Version EINES Fachgebiets
Ausführliche Versuchsanleitungen zum Themengebiet Energie des Unterrichtsfachs Physik im Science Lab. Beschreibt ca. 64 Versuche zu den Themen Wärmelehre, Erneuerbare Energien, Brennstoffzellen. Enthält alle interaktiven Versuchsanleitungen (Lab Docs) als html-Datei.
520 712 LIT-digital: LP2 Science Lab Energie
UNTERRICHTSFACH LIT-digital: LP Science Lab Physik

Digitale Version ALLER Fachgebiete
Ausführliche Versuchsanleitungen zum Unterrichtsfach Physik im Science Lab. Beschreibt ca. 460 Versuche zu den Fachgebieten Mechanik, Energie, Elektrik und Elektronik, Optik, Atom- und Kernphysik sowie Informatik und Technik.
Enthält alle interaktiven Versuchsanleitungen (Lab Docs) als html-Datei.
520 71 LIT-digital: LP Science Lab Physik
Technische Daten der digitalen Version:
• Lieferung als Produktschlüssel (Aktivierung & Auswahl der Literatursprache über https://register.leylab.de notwendig)
• Systemvoraussetzungen:
Document Center: PC mit Windows 7 oder höher; Internetzugang während der Installation; lokales Netzwerk zur Verteilung an die Schüler
Leylab:
- PC, Tablet oder Smartphone mit gängigem Browser; Internetzugang





Detaillierte Informationen zum ergänzenden Aufbewahrungszubehör finden Sie im Internet unter www.leybold.shop.de.
n die Messwerte können entweder manuell im eigenen Lab Doc eingegeben werden oder
n bei einer Verbindung mit dem Mobile-CASSY 2 WLAN werden die Messwerte direkt in das Lab Doc übertragen
n das Diagramm „Höhe des Wassertropfens in Abhängigkeit der Wasserbadtemperatur“ vervollständigt sich mit den eingegebenen Messwerten automatisch

LP2.1.1.5 Erwärmung von Luft (bei konstantem Druck)

Die Schülerinnen und Schüler untersuchen den Zusammenhang zwischen Temperaturänderung und Volumenänderung der Luft bei konstantem Druck (Gesetz nach Gay-Lussac).

LP2.2.1 Solarenergie
LP2.2.1.1
LP2.2.1.1C
LP2.2.1.2
LP2.2.1.2C
LP2.2.1.3
LP2.2.1.3C
LP2.2.1.4
LP2.2.1.5
LP2.2.1.5C
LP2.2.1.6
LP2.2.1.6C
Schwarze und weiße Körper
Schwarze und weiße Körper (mit Mobile-CASSY 2 WLAN)
Absorption von Wärmestrahlung
Absorption von Wärmestrahlung (mit Mobile-CASSY 2 WLAN)
Treibhauseffekt
Treibhauseffekt (mit Mobile-CASSY 2 WLAN)
Schaltungen von Solarzellen
Untersuchung an einem Solarmodul in Abhängigkeit vom Abstand
Untersuchung an einem Solarmodul in Abhängigkeit vom Abstand (mit Mobile-CASSY 2 WLAN)
Untersuchung an einem Solarmodul in Abhängigkeit vom Einstrahlwinkel
Untersuchung an einem Solarmodul in Abhängigkeit vom Einstrahlwinkel (mit Mobile-CASSY 2 WLAN)
LP2.2.2 Windenergie
LP2.2.2.1
LP2.2.2.1C
LP2.2.2.2
LP2.2.2.3
LP2.2.2.4
Messung der Spannung an einem Windrad Messung der Spannung an einem Windrad (mit Mobile-CASSY 2 WLAN)
Windrad mit unterschiedlichen Flügeln Windrad mit unterschiedlicher Flügelanzahl Windrad mit unterschiedlichem Flügelwinkel
LP2.2.3 Peltier-Effekt
LP2.2.3.1
LP2.2.3.2
Untersuchung eines Peltier-Elementes als Wärmepumpe Untersuchung eines Peltier-Elementes als Spannungsquelle
LP2.2.4 Energiespeicherung
LP2.2.4.1 Laden eines Kondensators
LP2.2.5 Energieumwandlung und Wirkungsgrad
LP2.2.5.1
LP2.2.5.2
LP2.2.5.3
Betreiben eines Motors durch ein Solarmodul
Betreiben einer Lampe durch ein Solarmodul Betreiben einer Lampe durch einen Generator

Treibhauseffekt
ÜBERSICHT

Kat.-Nr. Bezeichnung
207 122S Science Lab Energie EG2 (Satz)
Eine Auswahl der Literaturpakete finden Sie auf den nachfolgenden Seiten. Literatur



Schülerexperimentiersatz des Schülerversuche-Systems Science Lab im Bereich Physik. Aufbaumaterial für eine Arbeitsgruppe in gerätegeformter Aufbewahrung. Mit dem Gerätesatz EG2 können, mehr als 20 Versuche in der S I und S II durchgeführt werden.
Inhaltlich beschäftigen sich die Schülerinnen und Schüler mit erneuerbaren Energien. Beim Bearbeiten der lehrplangeforderten Themen werden sie auch in den Kompetenzen Kommunikation und Bewertung geschult. In Verbindung mit dem Mobile-CASSY 2 WLAN (524 005W2) ergeben sich weitere Auswertemöglichkeiten, die digitales Lernen ermöglichen.
Lieferumfang:
Menge Kat.-Nr. Bezeichnung
1 311 78 Bandmaß 2 m
2 382 21 Rührthermometer -10...+110 °C/1 K
1 456 110 Lichtquelle, 12 V
1 456 120 Photovoltaikmodul
1 456 130 Windmaschine
1 456 140 Windrad
1 456 150 Peltier-Element in Trog
1 456 160 Dämmgehäuse für Leslie-Körper
1 456 170 Leslie-Körper
2 500 621
2 500 622
1 500 624
Sicherheits-Experimentierkabel 50 cm, rot
Sicherheits-Experimentierkabel 50 cm, blau
Sicherheits-Experimentierkabel 50 cm, schwarz
1 578 425 Kondensator (Elko) 1 F STE2/19
1 579 06 Schraubfassung E10, oben, STE 2/19
1 590 48 Tauchheizer 12 V/10 W
1 664 121 Becherglas PP, 100 ml, n.F.
1 LDS00001 Handstoppuhr, digital
Zusätzlich erforderlich:
Menge Kat.-Nr. Bezeichnung
1 520 712 LIT-digital: LP2 Science Lab Energie
1 521 487 AC/DC Netzgerät PRO 0...12 V/3 A
1 524 005W2 Mobile-CASSY 2 WLAN
2 531 120* Vielfach-Messgerät LDanalog 20 (Multimeter)
* alternativ
Zusätzlich empfohlen:
Menge Kat.-Nr. Bezeichnung
1 520 7122DE LIT-print: LP2.2 Erneuerbare Energien
1 520 71 LIT-digital: LP Science Lab Physik
1 647 003 Deckel zu Geräteschub


n ein Windrad wird untersucht bzgl. Rotorform, -anzahl, -neigung
n der Treibhauseffekt kann nachgestellt werden
n eine Rastersteckplatte ist im Schub enthalten, die ebenfalls in der Elektrik verwendet wird
n Kompetenzerwerb: Fachsprache auf Alltagssituationen anwenden
SCHÜLERMESSGERÄT

SENSOREN

Mobile-CASSY 2 WLAN
DIGITALER UNTERRICHT
Das universelle Schülermessgerät mit WLAN für alle Messaufgaben in der Physik, Chemie und Biologie.
524 005W2 Mobile-CASSY 2 WLAN
Detaillierte Informationen zum Mobile-CASSY 2 WLAN finden Sie im Internet unter www.leybold-shop.de/524005W2.
Temperaturfühler NiCr-Ni, schnell, Typ K
Bereits im Lieferumfang des Mobile-CASSY 2 WLAN (524 005W2) enthalten.
Detaillierte Informationen zu diesem und anderen Sensoren finden Sie im Internet unter www.leybold-shop.de.
Hier finden Sie eine Übersicht über unsere Literaturpakete. Detaillierte Informationen zu unserer Literatur finden Sie im Internet unter www.leybold-shop.de.

FACHGEBIET

UNTERRICHTSFACH

LIT-print: LP2.2 Erneuerbare Energien
Ausführliche Versuchsanleitungen zum Science Lab Schub EG2 (207 122S). Beschreibt 22 Versuche aus dem Thema Erneuerbare Energien.
Versuchsthemen: Solarenergie; Windenergie; Peltier-Effekt; Energieumwandlung und Wirkungsgrad
520 7122DE LIT-print: LP2.2 Erneuerbare Energien
LIT-digital: LP2 Science Lab Energie
Ausführliche Versuchsanleitungen zum Themengebiet Energie des Unterrichtsfachs Physik im Science Lab. Beschreibt ca. 64 Versuche zu den Themen Wärmelehre, Erneuerbare Energien, Brennstoffzellen. Enthält alle interaktiven Versuchsanleitungen (Lab Docs) als html-Datei.
520 712 LIT-digital: LP2 Science Lab Energie
LIT-digital: LP Science Lab Physik
Ausführliche Versuchsanleitungen zum Unterrichtsfach Physik im Science Lab. Beschreibt ca. 460 Versuche zu den Fachgebieten Mechanik, Energie, Elektrik und Elektronik, Optik, Atom- und Kernphysik sowie Informatik und Technik.
Enthält alle interaktiven Versuchsanleitungen (Lab Docs) als html-Datei.
Technische Daten der digitalen Version:
• Lieferung als Produktschlüssel (Aktivierung & Auswahl der Literatursprache über https://register.leylab.de notwendig)
• Systemvoraussetzungen:
Document Center:
PC mit Windows 7 oder höher; Internetzugang während der Installation; lokales Netzwerk zur Verteilung an die Schüler
Leylab:
- PC, Tablet oder Smartphone mit gängigem Browser; Internetzugang





Eine Investion in die Zukunft: Klimafreundliche
UND DIE GESTALTUNG DER ENERGIEVERSORGUNG VON MORGEN
n Themenbereiche: Solarenergie, Windenergie, Energiespeicherung & Energieumwandlung
n erlebnisorientierte Versuche durch Nutzung anschaulicher Objekte, wie dem Solarmodul oder auch dem Miniatur-Windrad mit der Windmaschine
n qualitative Untersuchungen und quantitative Messungen mit digitaler Messtechnik und mit Hilfe interaktiver Versuchsanleitungen
n Schülerinnen und Schüler erlernen:
n Aufbau und Funktionsweise von Anlagen zur Energiegewinnung
n die physikalischen Gesetzmäßigkeiten bezüglich der Energieumwandlung, -gewinnung und -speicherung



n Solarzelle und Solarmodul
n Umwandlung von Strahlungsenergie (Sonnenergie) in elektrische Energie
n Abhängigkeiten von der Beleuchtungsstärke (Abstand zur Sonne) sowie dem Einstrahlwinkel (Ausrichtung zur Sonne)
n Umwandlung von mechanischer Energie (Windenergie) in elektrische Energie
n Einfluss der Form, Anzahl und Stellwinkel unterschiedlicher Rotorblätter
n realitätsnahe Untersuchung des Wirkungsgrades

LP2.3.1 Reversible PEM-Brennstoffzelle
LP2.3.1.1 Vorbereitung einer Brennstoffzelle
LP2.3.2 Der Elektrolyseur
LP2.3.2.1
LP2.3.2.2
LP2.3.2.3
LP2.3.2.3C
LP2.3.2.4
LP2.3.2.5
LP2.3.2.6
Verwendung der reversiblen Brennstoffzelle als Elektrolyseur
Betreiben des Elektrolyseurs mit einer Solarzelle Kennlinie des Elektrolyseurs
Kennlinie des Elektrolyseurs (mit Mobile-CASSY 2 WLAN)
Das 1. Faradaysche Gesetz am Elektrolyseur Bestimmung der Faraday-Konstante Energie-Wirkungsgrad am Elektrolyseur
LP2.3.3 Die Brennstoffzelle
LP2.3.3.1
LP2.3.3.2
LP2.3.3.3
LP2.3.3.3C
LP2.3.3.4
LP2.3.3.4C
LP2.3.3.5
LP2.3.3.6
LP2.3.3.6C
Umsetzung von Wasserstoff und Sauerstoff in einer Brennstoffzelle Betreiben eines Motors mit einer Brennstoffzelle
Kennlinie und Leistung einer Brennstoffzelle Kennlinie und Leistung einer Brennstoffzelle (mit Mobile-CASSY 2 WLAN)
Wirkungsgrad einer Brennstoffzelle
Wirkungsgrad einer Brennstoffzelle (mit Mobile-CASSY 2 WLAN)
Energiespeicherung Wirkungsgrad des Systems: Elektrolyseur und Brennstoffzelle Wirkungsgrad des Systems: Elektrolyseur und Brennstoffzelle (mit Mobile-CASSY 2 WLAN) 17 VERSUCHE

LP2.3.2.1 Verwendung der reversiblen Brennstoffzelle als Elektrolyseur


Kat.-Nr. Bezeichnung
207 122S Science Lab Energie EG2 (Satz)
207 123S Science Lab Energie EG3 (Satz)
Auswahl der Literaturpakete siehe S. 74



Schülerexperimentiersatz des Schülerversuche-Systems Science Lab im Bereich Physik. Aufbaumaterial für eine Arbeitsgruppe in gerätegeformter Aufbewahrung. Mit dem Gerätesatz EG3 können, zusammen mit dem Science Lab Energie EG2 (207 122S), 17 Versuche in der S II durchgeführt werden.
Inhaltlich beschäftigen sich die Schülerinnen und Schüler mit Brennstoffzellen. Beim Bearbeiten der lehrplangeforderten Themen werden sie auch in den Kompetenzen Kommunikation und Bewertung geschult. In Verbindung mit dem Mobile-CASSY 2 WLAN (524 005W2) ergeben sich weitere Auswertemöglichkeiten, die digitales Lernen ermöglichen.
Lieferumfang:
Menge Kat.-Nr. Bezeichnung
1 456 210 H2+O2 Speicher
1 456 220 Platte für Brennstoffzelle und H2+O2 Spe
1 571 260 Adapterkabel 2-/4-mm, 30 cm, blau
1 571 262 Adapterkabel 2-/4-mm, 30 cm, rot
1 577 21 Widerstand 5,1 Ohm, STE 2/19
1 577 90 Potentiometer 220 Ohm, STE 4/50
1 667 198 Silikonschlauch 2 mm Ø, 1 m
1 667 4044 Reversible PEM-Brennstoffzelle
207 123S Science Lab Energie EG3 (Satz)
Zusätzlich erforderlich:
Menge Kat.-Nr. Bezeichnung
1 207 122S Science Lab Energie EG2 (Satz)
1 520 712 LIT-digital: LP2 Science Lab Energie
1 521 487 AC/DC Netzgerät PRO 0...12 V/3 A
1 524 005W2 Mobile-CASSY 2 WLAN
2 531 120* Vielfach-Messgerät LDanalog 20 (Multimeter)
* alternativ
Zusätzlich empfohlen:
Menge Kat.-Nr. Bezeichnung
1 520 7123DE LIT-print: LP2.3 Brennstoffzellen
1 520 71 LIT-digital: LP Science Lab Physik
1 647 003 Deckel zu Geräteschub


n Energieketten werden nachgestellt
n im Schub enthalten: PEM (Elektrolyseur und Brennstoffzelle in Einem)
n Kompetenzerwerb: Speicherungsmöglichkeiten von Erneuerbaren Energien kennenlernen
SCHÜLERMESSGERÄT DIGITALER UNTERRICHT

Mobile-CASSY 2 WLAN
Das universelle Schülermessgerät mit WLAN für alle Messaufgaben in der Physik, Chemie und Biologie.
524 005W2 Mobile-CASSY 2 WLAN
Detaillierte Informationen zum Mobile-CASSY 2 WLAN finden Sie im Internet unter www.leybold-shop.de/524005W2.
MOBILE-CASSY 2 WLAN

AUSWERTEMÖGLICHKEITEN
Mit dem Mobile-CASSY 2 WLAN kann direkt über 4-mm-Sicherheitsbuchsen Spannung (U), Stromstärke (I), Leistung (P) und Energie (E) gemessen werden.
Hier finden Sie eine Übersicht über unsere Literaturpakete.
Detaillierte Informationen zu unserer Literatur finden Sie im Internet unter www.leybold-shop.de.

FACHGEBIET

UNTERRICHTSFACH

LIT-print: LP2.3 Brennstoffzellen
Gedruckte Version EINES Themas in einem Ringordner
Ausführliche Versuchsanleitungen zum Science Lab Schub EG3 (207 123S). Beschreibt 17 Versuche aus dem Thema Brennstoffzelle.
Versuchsthemen: Der Elektrolyser; die Brennstoffzelle
520 7123DE LIT-print: LP2.3 Brennstoffzellen
LIT-digital: LP2 Science Lab Energie
Digitale Version EINES Fachgebiets
Ausführliche Versuchsanleitungen zum Themengebiet Energie des Unterrichtsfachs Physik im Science Lab. Beschreibt ca. 64 Versuche zu den Themen Wärmelehre, Erneuerbare Energien, Brennstoffzellen. Enthält alle interaktiven Versuchsanleitungen (Lab Docs) als html-Datei.
520 712 LIT-digital: LP2 Science Lab Energie
LIT-digital: LP Science Lab Physik
Digitale Version ALLER Fachgebiete
Ausführliche Versuchsanleitungen zum Unterrichtsfach Physik im Science Lab. Beschreibt ca. 460 Versuche zu den Fachgebieten Mechanik, Energie, Elektrik und Elektronik, Optik, Atom- und Kernphysik sowie Informatik und Technik. Enthält alle interaktiven Versuchsanleitungen (Lab Docs) als html-Datei.
520 71 LIT-digital: LP Science Lab Physik
Technische Daten der digitalen Version:
• Lieferung als Produktschlüssel (Aktivierung & Auswahl der Literatursprache über https://register.leylab.de notwendig)
• Systemvoraussetzungen:
Document Center:
PC mit Windows 7 oder höher; Internetzugang während der Installation; lokales Netzwerk zur Verteilung an die Schüler
Leylab:
- PC, Tablet oder Smartphone mit gängigem Browser; Internetzugang





Detaillierte Informationen zum ergänzenden Aufbewahrungszubehör finden Sie im Internet unter www.leybold.shop.de.
n Zukunftstechnologie im Schülerversuch erlernen
n Brennstoffzelle und ihre Funktionsweise
n Elektrolyseur für die Zerlegung von Wasser in seine Bestandteile
n Umwandlung zwischen chemischer und elektrischer Energie mit einer reversiblen PEM-Brennstoffzelle
n Wirkungsgrad sowie Aufgaben zur Energiespeicherung und zum Energietransport
n lösungsorientiertes Lernen mit Alltagsbezug, z. B. Autos mit Wasserstoff-Antrieb - Vorteile und Herausforderungen
n eigenständige qualitative Untersuchungen und quantitative Messungen mit dem Mobile-CASSY 2 WLAN sowie den interaktiven Versuchsanleitungen Lab Docs
FÜR EINE ZUKUNFTSSICHERE ENERGIEVERSORGUNG

Der Einstieg in die Elektrik beginnt für die Schülerinnen und Schüler meistens mit Versuchen, wie dem einfachen Stromkreis. Dabei erlernen sie grundlegende Prinzipien, die für das Verständnis der darauf aufbauenden Versuche unbedingt notwendig sind.
Die Verwendung der innovativen modular aufgebauten Rastersteckplatte macht es besonders einfach, die Versuche auf das Notwendigste zu reduzieren. Die Sicherheitsbuchsen auf der Rastersteckplatte lassen die Verwendung von Sicherheitskabeln zu. 5 Elektrik-Schübe ergeben 6 Themengebiete mit 149 Versuchen.
Die Strom- und Spannungsmessungen können sowohl mit dem Mobile-CASSY 2 WLAN als auch mit Multimetern durchgeführt werden.

HIGHLIGHT LP3.1.7.1C Äquipotentiallinien zwischen gleich geformten Elektroden
Die Schülerinnen und Schüler sollen in diesem Versuch die Äquipotentiallinien zwischen zwei gleich geformten Elektroden aufzeichnen, indem sie die Orte gleicher Potentialdifferenz zwischen der 0-V-Elektrode und der Stahlnadel mit dem Mobile-CASSY 2 WLAN suchen und diese Punkte grafisch darstellen. Für diesen Versuch benötigen Sie den Schub Science Lab Elektrik EL1 (207 131S)
Weitere Informationen zu unseren lehrplankonformen Themen und Schülerversuchen sowie die dazugehörigen Schübe finden Sie auf den nachfolgenden Seiten.
VERSUCHSTHEMEN ERFORDERLICHE SCHÜBE
LP3.1 ELEKTROSTATIK
LP3.1.1 KONTAKTELEKTRIZITÄT
LP3.1.2 KRAFTWIRKUNG ZWISCHEN LADUNGEN
LP3.1.3 ELEKTRISCHE INFLUENZ
LP3.1.4 LADUNGSSPEICHER
LP3.1.5 ELEKTROSTATISCHE WECHSELWIRKUNG
LP3.1.6 ISOLATOREN UND LEITER
LP3.1.7 ÄQUIPOTENTIALLINIEN
LP3.1.8 PLATTENKONDENSATOR
LP3.2 MAGNETISMUS
LP3.2.1 MAGNETWIRKUNG
LP3.2.2 MAGNETISCHE INFLUENZ
LP3.2.3 MAGNETISCHE FELDER


LP3.3 ELEKTRISCHE GRUNDSCHALTUNGEN
LP3.3.1 STROMKREIS UND SCHALTER
LP3.3.2 ELEKTRISCHE MESSVERFAHREN
LP3.3.3 OHMSCHE WIDERSTÄNDE
LP3.3.4 SPEZIELLE WIDERSTÄNDE
LP3.3.5 SPANNUNGSQUELLEN
LP3.3.6 ELEKTRISCHE ANWENDUNGSSCHALTUNGEN
LP3.3.7 SOLARZELLEN
LP3.3.8 ELEKTROCHEMIE
LP3.4 ELEKTROMAGNETISMUS UND INDUKTION
LP3.4.1 ELEKTROMAGNETISMUS
LP3.4.2 ELEKTROMAGNETISCHE ANWENDUNGEN
LP3.4.3 INDUKTION
LP3.4.4 TRANSFORMATOREN
LP3.4.5 ANWENDUNGEN DER INDUKTION
LP3.4.6 SPULEN IM GLEICH- UND WECHSELSTROMKREIS
LP3.5 MOTOREN UND GENERATOREN
LP3.5.1 GENERATOREN
LP3.5.2 ELEKTROMOTOREN
S.





VERSUCHSTHEMEN
LP4.1 ELEKTRONISCHE GRUNDSCHALTUNGEN
LP4.1.1 KONDENSATOREN
LP4.1.2 RELAISSCHALTUNGEN
LP4.1.3 DIODEN
LP4.1.4 TRANSISTOREN
LP4.1.5 DIODENSCHALTUNGEN
LP4.1.6 KIPPSTUFEN
LP4.1.7 VERSTÄRKERSCHALTUNGEN


LP3.1.1 Kontaktelektrizität
LP3.1.1.1
LP3.1.1.2
LP3.1.1.3
Nachweis von Ladungsarten an Reibstäben mit einer Glimmlampe Nachweis von Ladungsarten an Folien und Platten mit einer Glimmlampe Kontaktelektrizität durch Reibung
LP3.1.2 Kraftwirkung zwischen Ladungen
LP3.1.2.1
LP3.1.2.2
LP3.1.2.3
Kraftwirkung zwischen Ladungen auf Reibstäben Kräfte am geladenem Pendelpaar Funktionsweise eines Elektroskops
LP3.1.3 Elektrische Influenz
LP3.1.3.1
LP3.1.3.2
LP3.1.3.3
LP3.1.3.4
Influenzerscheinungen bei Leitern und Nichtleitern Influenzerscheinungen an einem Zeiger Elektrische Influenz am Pendelpaar Influenzerscheinungen am Elektroskop durch Reibstäbe
LP3.1.4 Ladungsspeicher
LP3.1.4.1
LP3.1.4.2 Leitende Körper als Ladungsspeicher Ladungsnachweis beim Faraday-Becher
LP3.1.5 Elektrostatische Wechselwirkung
LP3.1.5.1
LP3.1.5.2 Elektrostatische Krafteinwirkungen zwischen Reibstab und Pendel Ladungstransport durch ein Pendel
LP3.1.6 Isolatoren und Leiter
LP3.1.6.1
LP3.1.6.2
LP3.1.6.3
Ladungen auf Isolatoren Leitfähigkeitsnachweis mit dem Elektroskop Die Abgabe von Ladungen durch elektrische Funken
LP3.1.7 Äquipotentiallinien
LP3.1.7.1
LP3.1.7.1C
LP3.1.7.2
LP3.1.7.2C
LP3.1.7.3
LP3.1.7.3C Äquipotentiallinien zwischen gleich geformten Elektroden Äquipotentiallinien zwischen gleich geformten Elektroden (mit Mobile-CASSY 2 WLAN) Äquipotentiallinien zwischen ungleich geformten Elektroden Äquipotentiallinien zwischen ungleich geformten Elektroden (mit Mobile-CASSY 2 WLAN) Verzerrung von Äquipotentiallinien Verzerrung von Äquipotentiallinien (mit Mobile-CASSY 2 WLAN)
LP3.1.8 Plattenkondensator
LP3.1.8.1
LP3.1.8.1C Das elektrische Feld im Plattenkondensator Das elektrische Feld im Plattenkondensator (mit Mobile-CASSY 2 WLAN)

Die Schülerinnen und Schüler sollen zeigen, dass die beiden unterschiedlichen Ladungen auf einem Faraday-Becher gespeichert und mit der Glimmlampe nachgewiesen werden können. Für diesen Versuch benötigen Sie den Schub Science Lab EL1 (207 131S)
ÜBERSICHT BENÖTIGTES MATERIAL

Kat.-Nr. Bezeichnung
207 131S Science Lab Elektrik EL1 (Satz)
Eine Auswahl der Literaturpakete finden Sie auf den nachfolgenden Seiten.



Schülerexperimentiersatz des Schülerversuche-Systems Science Lab im Bereich Physik. Aufbaumaterial für eine Arbeitsgruppe in gerätegeformter Aufbewahrung. Mit dem Gerätesatz EL1 können mehr als 24 Versuche in der S I und S II durchgeführt werden.
Inhaltlich beschäftigen sich die Schülerinnen und Schüler mit den Themen Elektrostatik und elektrische Felder. Beim Bearbeiten der lehrplangeforderten Themen werden sie auch in den Kompetenzen Kommunikation und Bewertung geschult. In Verbindung mit dem Mobile-CASSY 2 WLAN (524 005W2) ergeben sich weitere Auswertemöglichkeiten, die digitales Lernen ermöglichen.
Lieferumfang:
Menge Kat.-Nr. Bezeichnung
2 500 621 Sicherheits-Experimentierkabel 50 cm, rot
2 500 622 Sicherheits-Experimentierkabel 50 cm, blau
3 501 85 Adapter 4-mm-Stecker/4-mm-Buchse
1 501 86 Krokodilklemme, blank
1 505 43 Glimmlampe, Soffite 90 V
1 540 08 Elektroskop
2 541 00 Reibstäbe, PVC und Acrylglas
1 542 51 Influenzplatte 8 cm x 4 cm
1 545 092 Stabelektrode zu 54509, Satz 2
1 545 093 Satz 3 runde Elektroden zu 54509
1 546 12 Faraday-Becher
1 590 011 Klemmstecker
1 647 002 Geräteschub, hoch
1 647 003 Deckel zu Geräteschub
1 686 51 Schnur
1 686 61 Paar Kunststoffklammern
1 686 62 Elektrostatisches Pendelpaar
1 686 64 Metallnadel
1 686 65 Mikrofasertuch (Reibzeug)
5 aus 688 106 Acetat-Folien 300 x 300 x 0,1 mm, Satz 10
131S Science Lab Elektrik EL1 (Satz)
Zusätzlich erforderlich:
Menge Kat.-Nr. Bezeichnung
1 520 713 LIT-digital: LP3 Science Lab Elektrik
1 521 487 AC/DC Netzgerät PRO 0...12 V/3 A
1 524 005W2 Mobile-CASSY 2 WLAN
1 531 120* Vielfach-Messgerät LDanalog 20 (Multimeter)
* alternativ
Zusätzlich empfohlen:
Menge Kat.-Nr. Bezeichnung
1 520 7131DE LIT-print: LP3.1 Elektrostatik
1 520 71 LIT-digital: LP Science Lab Physik


n Schülerinnen und Schüler bauen ihr „eigenes“ Elektroskop und erkennen, wie es arbeitet bzw. funktioniert
n einfache Versuche zum Nachweis und zur Speicherung unterschiedlicher Ladungen und zu elektrischen Feldern
n Kompetenzerwerb: Aufbau und Funktion elektrischer Messgeräte
SCHÜLERMESSGERÄT

Mobile-CASSY 2 WLAN
DIGITALER UNTERRICHT
Das universelle Schülermessgerät mit WLAN für alle Messaufgaben in der Physik, Chemie und Biologie.
524 005W2
Mobile-CASSY 2 WLAN
Detaillierte Informationen zum Mobile-CASSY 2 WLAN finden Sie im Internet unter www.leybold-shop.de/524005W2
MOBILE-CASSY 2 WLAN

AUSWERTEMÖGLICHKEITEN
Mit dem Mobile-CASSY 2 WLAN kann direkt über 4-mm-Sicherheitsbuchsen Spannung (U), Stromstärke (I), Leistung (P) und Energie (E) gemessen werden.

Hier finden Sie eine Übersicht über unsere Literaturpakete.
Detaillierte Informationen zu unserer Literatur finden Sie im Internet unter www.leybold-shop.de.

FACHGEBIET

UNTERRICHTSFACH

LIT-print: LP3.1 Elektrostatik
Ausführliche Versuchsanleitungen zum Science Lab Schub EL1 (207 131S). Beschreibt 25 Versuche aus dem Thema Elektrostatik.
Versuchsthemen: Kontaktelektrizität; Kraftwirkung zwischen Ladungen; Elektrische Influenz; Ladungsspeicher; Elektrostatische Wechselwirkung; Isolatoren und Leiter; Äquipotentiallinien; Plattenkondensator
520 7131DE LIT-print: LP3.1 Elektrostatik
LIT-digital: LP3 Science Lab Elektrik
Ausführliche Versuchsanleitungen zum Themengebiet Elektrik des Unterrichtsfachs Physik im Science Lab. Beschreibt ca. 149 Versuche zu den Themen Elektrostatik, Magnetismus, Elektrische Grundschaltungen und Elektrochemie, Elektromagnetismus und Induktion, Motoren und Generatoren und Elektronik.
Enthält alle interaktiven Versuchsanleitungen (Lab Docs) als html-Datei.
520 713 LIT-digital: LP3 Science Lab Elektrik
LIT-digital: LP Science Lab Physik
Ausführliche Versuchsanleitungen zum Unterrichtsfach Physik im Science Lab. Beschreibt ca. 460 Versuche zu den Fachgebieten Mechanik, Energie, Elektrik und Elektronik, Optik, Atom- und Kernphysik sowie Informatik und Technik.
Enthält alle interaktiven Versuchsanleitungen (Lab Docs) als html-Datei.
520 71 LIT-digital: LP Science Lab Physik
Technische Daten der digitalen Version:
• Lieferung als Produktschlüssel (Aktivierung & Auswahl der Literatursprache über https://register.leylab.de notwendig)
• Systemvoraussetzungen:
Document Center:
PC mit Windows 7 oder höher; Internetzugang während der Installation; lokales Netzwerk zur Verteilung an die Schüler
Leylab:
- PC, Tablet oder Smartphone mit gängigem Browser; Internetzugang





Die Bezeichnung der Versuche hören sich für Schüler nach allem anderen als Spaß und Spannung an, doch die Elektrostatik beinhaltet viele Erklärungen, um bereits im Alltag Erlebtes anschaulich darzustellen.



BEISPIELSWEISE WERDEN DIESE FRAGEN DER SCHÜLER
BEANTWORTET:
n Warum bekomme ich einen Stromschlag, wenn ich eine Metalltür anfasse, nachdem ich mit Schuhen über einen Teppich gelaufen bin?
n Warum ist das scheinbar mit manchen Schuhen schlimmer als mit anderen?
n Warum kleben die Haare am Luftballon, wenn ich diesen vorher am T-Shirt gerieben habe?
LP3.2.1 Magnetwirkung
LP3.2.1.1
LP3.2.1.2
LP3.2.1.3
Magnetische und nichtmagnetische Stoffe Lage der Magnetpole bei einem Stabmagneten Polarität von Magneten
LP3.2.2 Magnetische Influenz
LP3.2.2.1
LP3.2.2.2
LP3.2.2.3
Magnetisieren Zerlegen von Magneten Zusammensetzen von Magneten
LP3.2.3 Magnetische Felder
LP3.2.3.1
LP3.2.3.2
LP3.2.3.3
LP3.2.3.4
LP3.2.3.5
LP3.2.3.6
Darstellung eines Magnetfeldes mit Eisenpulver Feldlinienbild eines Stabmagneten Modellversuch zum Erdmagnetfeld Feldlinienbild eines Hufeisenmagneten Feldlinienbild sich anziehender Magnetpole Feldlinienbild sich abstoßender Magnetpole
12 VERSUCHE

LP3.2.1.1 Magnetische und nichtmagnetische Stoffe

LP3.2.3.1 Feldlinienbild sich anziehender Magnetpole
ÜBERSICHT BENÖTIGTES

Kat.-Nr. Bezeichnung
207 132S Science Lab Elektrik EL2 (Satz)
Eine Auswahl der Literaturpakete finden Sie auf den nachfolgenden Seiten.



Schülerexperimentiersatz des Schülerversuche-Systems Science Lab im Bereich Physik. Aufbaumaterial für eine Arbeitsgruppe in gerätegeformter Aufbewahrung. Mit dem Gerätesatz EL2 können mehr als 11 Versuche in der S I und S II durchgeführt werden.
Inhaltlich beschäftigen sich die Schülerinnen und Schüler mit dem Thema Magnetismus. Beim Bearbeiten der lehrplangeforderten Themen werden sie auch in den Kompetenzen Kommunikation und Bewertung geschult. In Verbindung mit dem Mobile-CASSY 2 WLAN (524 005W2) ergeben sich weitere Auswertemöglichkeiten, die digitales Lernen ermöglichen.
Lieferumfang:
Menge Kat.-Nr. Bezeichnung
2 510 50 Stabmagnet
2 510 52 Zeichenkompass
1 510 54 Satz 4 magnetisierbare Stangen
1 510 56 Halbkugel zum Erdmagnetismus
1 510 57 Experimentierfeld Magnetismus
1 510 60 Eisenjoche, Paar
1 513 70 Taschenkompass
1 514 011 Magnetfeldzeiger
1 514 72 Streuer für Eisenpulver
1 647 001 Geräteschub, niedrig
1 671 8300 Eisen Pulver, reduziert, 50 g
1 686 51 Schnur
207 132S Science Lab Elektrik EL2 (Satz)
Zusätzlich erforderlich:
Menge Kat.-Nr. Bezeichnung
1 520 713 LIT-digital: LP3 Science Lab Elektrik
Zusätzlich empfohlen:
Menge Kat.-Nr. Bezeichnung
1 510 55 Aufbau-Peilkompass
1 520 7132DE LIT-print: LP3.2 Magnetismus
1 520 71 LIT-digital: LP Science Lab Physik
1 524 005W2 Mobile-CASSY 2 WLAN
1 524 436 Magnetfeldsensor M, ±100 mT
1 647 003 Deckel zu Geräteschub


n verständliche Versuche zur Unterscheidung der anziehenden und abstoßenden magnetischen Kräfte, die sich mit Hilfe der Experimentierplatte und Eisenspäne visualisieren lassen
n Untersuchung des Erdmagnetfeldes in einem einfachen Modell
n Kompetenzerwerb: Erklären von Alltagsphänomenen anhand einfacher Modelle
SCHÜLERMESSGERÄT

SENSOREN

Mobile-CASSY 2 WLAN
DIGITALER UNTERRICHT
Das universelle Schülermessgerät mit WLAN für alle Messaufgaben in der Physik, Chemie und Biologie.
524 005W2 Mobile-CASSY 2 WLAN
Detaillierte Informationen zum Mobile-CASSY 2 WLAN finden Sie im Internet unter www.leybold-shop.de/524005W2
Magnetfeldsensor M, ±100 mT
EMPFOHLENE SENSOREN
Zur Messung der tangentialen oder axialen magnetischen Flussdichte bis ±100 mT mit dem Mobile-CASSY 2 (524 005/524 005W2).
524 436 Magnetfeldsensor M, ±100 mT
Detaillierte Informationen zu diesem und anderen Sensoren finden Sie im Internet unter www.leybold-shop.de

Hier finden Sie eine Übersicht über unsere Literaturpakete.
Detaillierte Informationen zu unserer Literatur finden Sie im Internet unter www.leybold-shop.de.

FACHGEBIET

UNTERRICHTSFACH

LIT-print: LP3.2 Magnetismus
Ausführliche Versuchsanleitungen zum Science Lab Schub EL2 (207 132S). Beschreibt 12 Versuche aus dem Thema Magnetismus.
Versuchsthemen: Magnetkraftwirkung; Magnetische Influenz; Magnetische Felder
520 7132DE LIT-print: LP3.2 Magnetismus
LIT-digital: LP3 Science Lab Elektrik
Ausführliche Versuchsanleitungen zum Themengebiet Elektrik des Unterrichtsfachs Physik im Science Lab. Beschreibt ca. 149 Versuche zu den Themen Elektrostatik, Magnetismus, Elektrische Grundschaltungen und Elektrochemie, Elektromagnetismus und Induktion, Motoren und Generatoren und Elektronik.
Enthält alle interaktiven Versuchsanleitungen (Lab Docs) als html-Datei.
520 713 LIT-digital: LP3 Science Lab Elektrik
LIT-digital: LP Science Lab Physik
Ausführliche Versuchsanleitungen zum Unterrichtsfach Physik im Science Lab. Beschreibt ca. 460 Versuche zu den Fachgebieten Mechanik, Energie, Elektrik und Elektronik, Optik, Atom- und Kernphysik sowie Informatik und Technik.
Enthält alle interaktiven Versuchsanleitungen (Lab Docs) als html-Datei.
520 71 LIT-digital: LP Science Lab Physik
Technische Daten der digitalen Version:
• Lieferung als Produktschlüssel (Aktivierung & Auswahl der Literatursprache über https://register.leylab.de notwendig)
• Systemvoraussetzungen:
Document Center:
PC mit Windows 7 oder höher; Internetzugang während der Installation; lokales Netzwerk zur Verteilung an die Schüler
Leylab:
- PC, Tablet oder Smartphone mit gängigem Browser; Internetzugang





Magnetismus ganz einfach selber erleben und erkunden

FELDLINIENBILDER BESCHREIBEN UND DAS VERHALTEN DER MAGNETE INTERPRETIEREN



MAGNETFELDER
AUF EINFACHE WEISE SICHTBAR MACHEN

RÜCKSCHLÜSSE AUF
DAS MAGNETFELD
DER ERDE ZIEHEN

FUNKTION VON EINEM KOMPASS VERSTEHEN
MIT DER HALBKUGEL ERKENNEN, DASS DIE ERDE EIN DIPOL IST
LP3.3.1 Stromkreis und Schalter
LP3.3.1.1
LP3.3.1.2
LP3.3.1.3
LP3.3.1.4
LP3.3.1.5
Der einfache Stromkreis
Leiter und Nichtleiter
Umschaltung Wechselschaltung
UND-Schaltung, ODER-Schaltung
LP3.3.2 Elektrische Messverfahren
LP3.3.2.1
LP3.3.2.1C
LP3.3.2.2
LP3.3.2.2C
Messung der Stromstärke im einfachen Stromkreis
Messung der Stromstärke im einfachen Stromkreis (mit Mobile-CASSY 2 WLAN)
Messung der Spannung im einfachen Stromkreis
Messung der Spannung im einfachen Stromkreis (mit Mobile-CASSY 2 WLAN)
LP3.3.3 Ohmsche Widerstände
LP3.3.3.1
LP3.3.3.1C
LP3.3.3.2
LP3.3.3.2C
LP3.3.3.3
LP3.3.3.3C
LP3.3.3.4
LP3.3.3.4C
LP3.3.3.5
LP3.3.3.5C
Ohmsches Gesetz
Ohmsches Gesetz (mit Mobile-CASSY 2 WLAN)
Abhängigkeit des Widerstandes eines Drahtes von Material, Länge und Querschnitt
Abhängigkeit des Widerstandes eines Drahtes von Material, Länge und Querschnitt (mit Mobile-CASSY 2 WLAN)
Spannungsverteilung an einem stromdurchflossenen Draht (Potentiometer)
Spannungsverteilung an einem stromdurchflossenen Draht (Potentiometer) (mit Mobile-CASSY 2 WLAN)
Reihenschaltung von Widerständen
Reihenschaltung von Widerständen (mit Mobile-CASSY 2 WLAN)
Parallelschaltung von Widerständen
Parallelschaltung von Widerständen (mit Mobile-CASSY 2 WLAN)
LP3.3.4 Spezielle Widerstände
LP3.3.4.1
LP3.3.4.1C
LP3.3.4.2
LP3.3.4.2C
Temperaturabhängiger Widerstand NTC
Temperaturabhängiger Widerstand NTC (mit Mobile-CASSY 2 WLAN)
Lichtabhängiger Widerstand LDR (Fotowiderstand)
Lichtabhängiger Widerstand LDR (Fotowiderstand) (mit Mobile-CASSY 2 WLAN)
LP3.3.5 Spannungsquellen
LP3.3.5.1
LP3.3.5.1C
LP3.3.5.2
LP3.3.5.2C
Reihen- und Parallelschaltung von Monozellen
Reihen- und Parallelschaltung von Monozellen (mit Mobile-CASSY 2 WLAN)
Klemmenspannung und Innenwiderstand einer Spannungsquelle Klemmenspannung und Innenwiderstand einer Spannungsquelle (mit Mobile-CASSY 2 WLAN)
LP3.3.6 Elektrische Anwendungsschaltungen
LP3.3.6.1
LP3.3.6.1C
LP3.3.6.2
LP3.3.6.3
LP3.3.6.4
LP3.3.6.4C
Eigenerwärmung und Temperaturabhängigkeit von Drahtwiderständen Eigenerwärmung und Temperaturabhängigkeit von Drahtwiderständen (mit Mobile-CASSY 2 WLAN) Modell einer Schmelzsicherung
Bimetallschalter (Modell eines Feuermelders)
Leistung und Arbeit des elektrischen Stromes
Leistung und Arbeit des elektrischen Stromes (mit Mobile-CASSY 2 WLAN)
LP3.3.7 Solarzellen
LP3.3.7.1
LP3.3.7.1C
LP3.3.7.2
LP3.3.7.2C
LP3.3.7.3
LP3.3.7.3C
Durchlass- und Sperr-Richtung einer Solarzelle
Durchlass- und Sperr-Richtung einer Solarzelle (mit Mobile-CASSY 2 WLAN)
Ausgangs- und Leistungskennlinie einer Solarzelle
Ausgangs- und Leistungskennlinie einer Solarzelle (mit Mobile-CASSY 2 WLAN)
Leerlaufspannung einer Solarzelle
Leerlaufspannung einer Solarzelle (mit Mobile-CASSY 2 WLAN)
LP3.3.8 Elektrochemie
LP3.3.8.1
LP3.3.8.1C
LP3.3.8.2
LP3.3.8.2C
LP3.3.8.3
LP3.3.8.4
LP3.3.8.4C
Leitfähigkeit wässriger Lösungen (Elektrolyte)
Leitfähigkeit wässriger Lösungen (Elektrolyte) (mit Mobile-CASSY 2 WLAN)
Zusammenhang zwischen Strom und Spannung bei einem Elektrolyten Zusammenhang zwischen Strom und Spannung bei einem Elektrolyten (mit Mobile-CASSY 2 WLAN)
Galvanisieren
Galvanische Elemente
Galvanische Elemente (mit Mobile-CASSY 2 WLAN)

LP3.3.1.4 Wechselschaltung
ÜBERSICHT BENÖTIGTES MATERIAL

Kat.-Nr. Bezeichnung
207 133S Science Lab Elektrik EL3 (Satz)
Eine Auswahl der Literaturpakete finden Sie auf den nachfolgenden Seiten.



Schülerexperimentiersatz des Schülerversuche-Systems Science Lab im Bereich Physik. Aufbaumaterial für eine Arbeitsgruppe in gerätegeformter Aufbewahrung. Mit dem Gerätesatz EL3 können mehr als 45 Versuche in der S I und S II durchgeführt werden.
Inhaltlich beschäftigen sich die Schülerinnen und Schüler mit den Themen elektrische Grundschaltungen und Elektrochemie. Beim Bearbeiten der lehrplangeforderten Themen werden sie auch in den Kompetenzen Kommunikation und Bewertung geschult. In Verbindung mit dem Mobile-CASSY 2 WLAN (524 005W2) ergeben sich weitere Auswertemöglichkeiten, die digitales Lernen ermöglichen.
Lieferumfang:
Menge Kat.-Nr.
Bezeichnung
2 340 89 Kupplungsstecker 4 mm
1 381 311 Bimetallstreifen
2 500 621 Sicherheits-Experimentierkabel 50 cm, rot
2 500 622 Sicherheits-Experimentierkabel 50 cm, blau
1 500 624 Sicherheits-Experimentierkabel 50 cm, schwarz
1 501 48 Brückenstecker STE 2/19, Satz 10
2 501 86 Krokodilklemme, blank
1 567 06 Leiter/ Nichtleiter, Satz 6
1 567 18 Draht-Wickelplatte
2 576 81 Rastersteckplatte Si-Bu, 20/10
2 576 86 Monozellenhalter STE 2/50
1 577 28 Widerstand 47 Ohm, STE 2/19
2 577 32 Widerstand 100 Ohm, STE 2/19
1 577 44 Widerstand 1 kOhm, STE 2/19
1 577 56 Widerstand 10 kOhm, STE 2/19
1 577 82 Stellwiderstand 47 kOhm, STE 2/19
1 578 02 Fotowiderstand LDR 05, STE 2/19
1 578 05 NTC-Widerstand 2,2 kOhm, STE 2/19
1 578 07 PTC-Widerstand 100 Ohm, STE 2/19
2 579 05 Schraubfassung E10, seitlich, STE 2/19
1 579 13 Kippschalter STE 2/19
2 579 331 Steckhalter STE
1 579 333 Kontaktstreifen
2 582 81 Umschalter STE 4/50
1 591 51 Flachtrog / Elektrolysetrog
2 591 531 Plattenelektrode Kupfer 76 x 40 mm
1 591 541 Plattenelektrode Zink 76 x 40 mm
1 591 551 Plattenelektrode Eisen, 76 x 40 mm
1 647 002 Geräteschub, hoch
1 664 391 Schmirgelstein
207
Zusätzlich erforderlich:
Menge Kat.-Nr. Bezeichnung
1 aus 505 07 Glühlampe 4 V/0,16 W, E10, Satz 10
1 aus 505 08 Glühlampe 12 V/3 W, E10, Satz 10
2 aus 505 11 Glühlampe 2,5 V/0,25 W, E10, Satz 10
1 520 713 LIT-digital: LP3 Science Lab Elektrik
1 521 487 AC/DC Netzgerät PRO 0...12 V/3 A
1 524 005W2 Mobile-CASSY 2 WLAN
2 531 120* Vielfach-Messgerät LDanalog 20 (Multimeter)
* alternativ
Zusätzlich empfohlen:
Menge Kat.-Nr. Bezeichnung
1 500 622 Sicherheits-Experimentierkabel 50 cm, blau
1 520 7133DE LIT-print: LP3.3 Grundschaltungen Elektrik und Elektrochemie
1 520 71 LIT-digital: LP Science Lab Physik
1 524 438 Spannungssensor M, ±30 V
1 550 42 Konstantandraht (Widerstandsdraht), 0,35 mm Ø, 100 m
1 550 46
1 550 47
Chromnickeldraht (Widerstandsdraht), 0,25 mm Ø, 100 m
Chromnickeldraht (Widerstandsdraht), 0,35 mm Ø, 100 m
1 550 51 Eisendraht (Widerstandsdraht), 0,2 mm Ø, 100 m
1 647 003 Deckel zu Geräteschub
1 672 9650 Kupfersulfatlösung 1 %, 50 ml
1 673 5700 Natriumchlorid 250 g
1 674 7960 Schwefelsäure 0,05 mol/l, 1 l
1 675 3400 Wasser, rein, 1 l


n das Stecksystem ermöglicht, auch größere Schaltungen kompakt auf den Rastersteckplatten aufzubauen
n variable Rastersteckplatte mit Sicherheitsbuchsen für 4-mm-Stecker
n mit der Rastersteckplatte können Experimente in L- oder T-Form aufgebaut werden
n für komplexere Schaltungen einfach erweiterbar durch Zusammenstecken mehrerer Platten
n Drahtwickelplatte erlaubt einfaches Experimentieren zum Widerstand von Drähten mit wenig Materialverbrauch
n Schub Elektrik EL3 dient zugleich als Basis für die weiteren Elektrik-Schübe

SENSOREN

Mobile-CASSY 2 WLAN
Das universelle Schülermessgerät mit WLAN für alle Messaufgaben in der Physik, Chemie und Biologie.
Detaillierte Informationen zum Mobile-CASSY 2 WLAN finden Sie im Internet unter www.leybold-shop.de/524005W2
Spannungssensor M, ±30 V
EMPFOHLENE SENSOREN
Zur Messung der elektrischen Spannung bis ±30 V mit dem Mobile-CASSY 2 WLAN. In Verbindung mit dem integrierten Spannungseingang wird aus dem Mobile-CASSY 2 WLAN (524 005W2) dadurch ein 2-kanaliges Speicheroszilloskop.
524 4368 Spannungssensor M, ±30 V
Detaillierte Informationen zu diesem und anderen Sensoren finden Sie im Internet unter www.leybold-shop.de

Mit dem Mobile-CASSY 2 WLAN kann direkt über 4-mm-Sicherheitsbuchsen Spannung (U), Stromstärke (I), Leistung (P) und Energie (E) gemessen werden.
Hier finden Sie eine Übersicht über unsere Literaturpakete.
Detaillierte Informationen zu unserer Literatur finden Sie im Internet unter www.leybold-shop.de.

FACHGEBIET

UNTERRICHTSFACH

LIT-print: LP3.3 Grundschaltungen Elektrik und Elektrochemie
Gedruckte
EINES Themas in einem Ringordner
Ausführliche Versuchsanleitungen zum Science Lab Schub EL3 (207 133S). Beschreibt 46 Versuche aus dem Thema Grundschaltungen Elektrik und Elektrochemie.
Versuchsthemen:
Stromkreis und Schalter; Elektrische Messverfahren; Ohmscher Widerstand; Spezielle Widerstände; Spannungsquellen; Elektrische Anwendungsschaltungen; Strom und Spannung in Flüssigkeiten
520 7133DE LIT-print: LP3.3 Grundschaltungen Elektrik und Elektrochemie
LIT-digital: LP3 Science Lab Elektrik
Digitale
Ausführliche Versuchsanleitungen zum Themengebiet Elektrik des Unterrichtsfachs Physik im Science Lab. Beschreibt ca. 149 Versuche zu den Themen Elektrostatik, Magnetismus, Elektrische Grundschaltungen und Elektrochemie, Elektromagnetismus und Induktion, Motoren und Generatoren und Elektronik.
Enthält alle interaktiven Versuchsanleitungen (Lab Docs) als html-Datei.
520 713 LIT-digital: LP3 Science Lab Elektrik
LIT-digital: LP Science Lab Physik
Ausführliche Versuchsanleitungen zum Unterrichtsfach Physik im Science Lab. Beschreibt ca. 460 Versuche zu den Fachgebieten Mechanik, Energie, Elektrik und Elektronik, Optik, Atom- und Kernphysik sowie Informatik und Technik.
Enthält alle interaktiven Versuchsanleitungen (Lab Docs) als html-Datei.
520 71 LIT-digital: LP Science Lab Physik
Technische Daten der digitalen Version:
• Lieferung als Produktschlüssel (Aktivierung & Auswahl der Literatursprache über https://register.leylab.de notwendig)
• Systemvoraussetzungen:
Document Center:
PC mit Windows 7 oder höher; Internetzugang während der Installation; lokales Netzwerk zur Verteilung an die Schüler
Leylab:
- PC, Tablet oder Smartphone mit gängigem Browser; Internetzugang





EIN BLICK IN DAS THEMA
Die Möglichkeiten der RastersteckplatteWandelbar und anpassungsfähig



FÜR EINFACHE VERSUCHE AUS
DER ELEKTRIK BIS HIN ZU KOMPLEXEN SCHALTUNGEN
AUS DER ELEKTRONIK

FLEXIBEL UND MODULAR ZUSAMMENSTECKBAR
n Experimentieren mit Sicherheitskabeln möglich
n Aufbau von Experimenten in T-Form und L-Form
n robust
n minimaler Platzbedarf

LEICHT UND BEDENKENLOS
ZUSAMMENSTECKEN UND AUSEINANDER BAUEN




LP3.4.1 Elektromagnetismus
LP3.4.1.1
LP3.4.1.2
LP3.4.1.3
Magnetische Wirkung des elektrischen Stromes
Stromdurchflossener Leiter im Magnetfeld Magnetfeld einer Spule
LP3.4.2 Elektromagnetische Anwendungen
LP3.4.2.1
LP3.4.2.2
LP3.4.2.3
Elektromagnet
Modell eines Magnetrelais Die elektrische Klingel
LP3.4.3 Induktion
LP3.4.3.1
LP3.4.3.1C
LP3.4.3.2
LP3.4.3.2C
Elektromagnetische Induktion mit Stabmagnet und Spule I
Elektromagnetische Induktion mit Stabmagnet und Spule I (mit Mobile-CASSY 2 WLAN)
Elektromagnetische Induktion mit zwei Spulen
Elektromagnetische Induktion mit zwei Spulen (mit Mobile-CASSY 2 WLAN)
LP3.4.4 Transformatoren
LP3.4.4.1
LP3.4.4.2 Spannungstransformation Stromtransformation
LP3.4.5 Anwendungen der Induktion
LP3.4.5.1
LP3.4.5.2
Selbstinduktion einer Spule (Modell eines Funkeninduktors) Modell eines Wechselspannungs-Generators
LP3.4.6 Spulen im Gleich- und Wechselstromkreis
LP3.4.6.1
LP3.4.6.2
LP3.4.6.2C
Gleich- und Wechselstromwiderstand einer Spule I (Beobachtungsversuch)
Gleich- und Wechselstromwiderstand einer Spule II (Messversuch)
Gleich- und Wechselstromwiderstand einer Spule II (Messversuch) (mit Mobile-CASSY 2 WLAN)


LP3.4.3.1C Elektromagnetische Induktion mit Stabmagnet und Spule I
ÜBERSICHT BENÖTIGTES MATERIAL


Kat.-Nr. Bezeichnung
207 133S Science Lab Elektrik EL3 (Satz)
207 134S Science Lab Elektrik EL4 (Satz)
Eine Auswahl der Literaturpakete finden Sie auf den nachfolgenden Seiten.



Schülerexperimentiersatz des Schülerversuche-Systems Science Lab im Bereich Physik. Aufbaumaterial für eine Arbeitsgruppe in gerätegeformter Aufbewahrung. Mit dem Gerätesatz EL4 können, zusammen mit dem Science Lab Elektrik EL3 (207 133S), 17 Versuche in der S I und S II durchgeführt werden.
Inhaltlich beschäftigen sich die Schülerinnen und Schüler mit dem Thema Elektromagnetismus. Beim Bearbeiten der lehrplangeforderten Themen werden sie auch in den Kompetenzen Kommunikation und Bewertung geschult. In Verbindung mit dem Mobile-CASSY 2 WLAN (524 005W2) ergeben sich weitere Auswertemöglichkeiten, die digitales Lernen ermöglichen.
Lieferumfang:
Menge Kat.-Nr. Bezeichnung
1 510 50 Stabmagnet
1 510 52 Zeichenkompass
1 510 54 Satz 4 magnetisierbare Stangen
1 579 32 Glockenschale
1 579 334 Blattfeder
1 590 83 Spule 500 Windungen STE 2/50
1 590 84 Spule 1000 Windungen STE 2/50
1 593 21 Trafokern, zerlegbar
1 647 001 Geräteschub, niedrig
207 134S Science Lab Elektrik EL4 (Satz)
Zusätzlich erforderlich:
Menge Kat.-Nr. Bezeichnung
1 207 133S Science Lab Elektrik EL3 (Satz)
1 520 713 LIT-digital: LP3 Science Lab Elektrik
1 521 487 AC/DC Netzgerät PRO 0...12 V/3 A
1 524 005W2 Mobile-CASSY 2 WLAN
2 531 120* Vielfach-Messgerät LDanalog 20 (Multimeter)
* alternativ
Zusätzlich empfohlen:
Menge Kat.-Nr. Bezeichnung
1 500 622 Sicherheits-Experimentierkabel 50 cm, blau
1 520 7134DE LIT-print: LP3.4 Elektromagnetismus und Induktion
1 520 71 LIT-digital: LP Science Lab Physik
1 524 436 Magnetfeldsensor M, ±100 mT
1 524 438 Spannungssensor M, ±30 V
1 647 003 Deckel zu Geräteschub


n Schülerinnen und Schüler stellen in EL 4 die Verknüpfung von Elektrizität und Magnetismus her - beispielsweise durch Versuche zur Induktion
n durch die einfache Handhabung des zerlegbaren Trafokerns lässt sich die Transformation von Spannungen schnell und verständlich erarbeiten
n modular aufbauend auf die Basisgeräte in Elektrik EL3
n Zusammenstellung der Sätze ist immer so organisiert, dass die Gruppe Material aus maximal 2 Schüben benötigt
n gleiche Geräte = gleiche Handhabung! Häufiger Einsatz der gleichen Geräte ermöglicht routinierten Umgang und Effizienzsteigerung beim Experimentieren.
n Kompetenzerwerb: Verständnis für die Zusammenhänge zwischen magnetischen und elektrischen Phänomenen
SCHÜLERMESSGERÄT DIGITALER UNTERRICHT

SENSOREN


Mobile-CASSY 2 WLAN
Das universelle Schülermessgerät mit WLAN für alle Messaufgaben in der Physik, Chemie und Biologie.
524 005W2 Mobile-CASSY 2 WLAN
Detaillierte Informationen zum Mobile-CASSY 2 WLAN finden Sie im Internet unter www.leybold-shop.de/524005W2
Magnetfeldsensor M, ±100 mT
EMPFOHLENE SENSOREN
Zur Messung der tangentialen oder axialen magnetischen Flussdichte bis ±100 mT mit dem Mobile-CASSY 2 (524 005W2).
524 436 Magnetfeldsensor M, ±100 mT
Spannungssensor M, ±30 V
Zur Messung der elektrischen Spannung bis ±30 V mit dem Mobile-CASSY 2 WLAN. In Verbindung mit dem integrierten Spannungseingang wird aus dem Mobile-CASSY 2 WLAN (524 005W2) dadurch ein 2-kanaliges Speicheroszilloskop.
524 4368 Spannungssensor M, ±30 V
Detaillierte Informationen zu diesen und anderen Sensoren finden Sie im Internet unter www.leybold-shop.de
Hier finden Sie eine Übersicht über unsere Literaturpakete. Detaillierte Informationen zu unserer Literatur finden Sie im Internet unter www.leybold-shop.de.

FACHGEBIET

UNTERRICHTSFACH

LIT-print: LP3.4 Elektromagnetismus und Induktion
Gedruckte
Ausführliche Versuchsanleitungen zum Science Lab Schub EL4 (207 134S) in Verbindung mit dem Science Lab Schub EL3 (207 133S). Beschreibt 17 Versuche aus dem Thema Elektromagnetismus und Induktion.
Versuchsthemen: Elektromagnetismus; Elektromagnetische Anwendungen; Induktion; Transformatoren; Anwendungen der Induktion; Spulen im Gleich- und Wechselstromkreis
520 7134DE LIT-print: LP3.4 Elektromagnetismus und Induktion
LIT-digital: LP3 Science Lab Elektrik
Ausführliche Versuchsanleitungen zum Themengebiet Elektrik des Unterrichtsfachs Physik im Science Lab. Beschreibt ca. 149 Versuche zu den Themen Elektrostatik, Magnetismus, Elektrische Grundschaltungen und Elektrochemie, Elektromagnetismus und Induktion, Motoren und Generatoren und Elektronik.
Enthält alle interaktiven Versuchsanleitungen (Lab Docs) als html-Datei. 520 713 LIT-digital: LP3 Science Lab Elektrik
LIT-digital: LP Science Lab Physik
Ausführliche Versuchsanleitungen zum Unterrichtsfach Physik im Science Lab. Beschreibt ca. 460 Versuche zu den Fachgebieten Mechanik, Energie, Elektrik und Elektronik, Optik, Atom- und Kernphysik sowie Informatik und Technik.
Enthält alle interaktiven Versuchsanleitungen (Lab Docs) als html-Datei.
520 71 LIT-digital: LP Science Lab Physik
Technische Daten der digitalen Version:
• Lieferung als Produktschlüssel (Aktivierung & Auswahl der Literatursprache über https://register.leylab.de notwendig)
• Systemvoraussetzungen:
Document Center:
PC mit Windows 7 oder höher; Internetzugang während der Installation; lokales Netzwerk zur Verteilung an die Schüler
Leylab:
- PC, Tablet oder Smartphone mit gängigem Browser; Internetzugang






n Untersuchung der Funktionsweise einer elektrischen Klinge
n mit den eingesetzten Materialien kann der Aufbau einer mit Wechselspannung betriebenen Klingel realisiert werden
ALLTAGSERFAHRUNG - Was passiert, wenn ich auf einen Klingelknopf drücke? + GEWONNENE KENNTNISSE ÜBER MAGNETISMUS + ELEKTRISCHE PHÄNOMENE VERSTEHEN
INTERESSANTE & LEICHT VERSTÄNDLICHE VERSUCHSANLEITUNGEN
DIGITAL ODER IN PAPIERFORM



Lab Docs sind responsive. Damit passt sich das Layout der Bildschirmgröße an.
Vom kleinsten Smartphone über ein Tablet oder Laptop bis hin zum Beamer.
LP3.5.1 Generatoren
LP3.5.1.1
LP3.5.1.1C
LP3.5.1.2
LP3.5.1.2C
LP3.5.1.3
LP3.5.1.3C
LP3.5.1.4
LP3.5.1.4C
Dynamo
Dynamo (mit Mobile-CASSY 2 WLAN)
Universalgenerator - Funktionsprinzip
Universalgenerator - Funktionsprinzip (mit Mobile-CASSY 2 WLAN)
Kraftwerksgenerator
Kraftwerksgenerator (mit Mobile-CASSY 2 WLAN)
AC/DC-Generator mit elektromagnetischem Stator
AC/DC-Generator mit elektromagnetischem Stator (mit Mobile-CASSY 2 WLAN)
LP3.5.2 Elektromotoren
LP3.5.2.1
LP3.5.2.1C
LP3.5.2.2
LP3.5.2.2C
LP3.5.2.3
LP3.5.2.3C
Gleichstrommotor - Funktionsprinzip
Gleichstrommotor - Funktionsprinzip (mit Mobile-CASSY 2 WLAN)
Nebenschluss-Universalmotor
Nebenschluss-Universalmotor (mit Mobile-CASSY 2 WLAN)
Hauptschluss-Universalmotor - Funktionsprinzip
Hauptschluss-Universalmotor - Funktionsprinzip (mit Mobile-CASSY 2 WLAN)


LP3.5.2.1C Gleichstrommotor - Funktionsprinzip
ÜBERSICHT BENÖTIGTES MATERIAL



Kat.-Nr. Bezeichnung
207 133S Science Lab Elektrik EL3 (Satz)
207 135S Science Lab Elektrik EL5 (Satz) Eine Auswahl der Literaturpakete finden Sie auf den nachfolgenden Seiten.


Schülerexperimentiersatz des Schülerversuche-Systems Science Lab im Bereich Physik. Aufbaumaterial für eine Arbeitsgruppe. Die Aufbewahrung der Geräte erfolgt in Science Lab Elektrik EL4 (207 134S). Mit dem Ergänzungssatz EL5 können, zusammen mit dem Science Lab Elektrik EL3 (207 133S) und EL4 (207 134S), mehr als 14 Versuche in der S I und S II durchgeführt werden.
Inhaltlich beschäftigen sich die Schülerinnen und Schüler mit den Themen Motoren und Generatoren. Beim Bearbeiten der lehrplangeforderten Themen werden sie auch in den Kompetenzen Kommunikation und Bewertung geschult. In Verbindung mit dem Mobile-CASSY 2 WLAN (524 005W2) ergeben sich weitere Auswertemöglichkeiten, die digitales Lernen ermöglichen.
Lieferumfang:
Menge Kat.-Nr. Bezeichnung
1 340 811 Steckachse
1 340 90 Gummiringe, Satz 8
1 340 921 Rolle Ø 100 mm, steckbar
1 579 45 Stator STE 4/50
1 579 46 Spulenrotor STE
1 579 47 Bürstenbrücke STE
1 579 48 Magnetrotor STE
207 135S Science Lab Elektrik EL5 (Satz)
Zusätzlich erforderlich:
Menge Kat.-Nr. Bezeichnung
1 207 133S Science Lab Elektrik EL3 (Satz)
1 207 134S Science Lab Elektrik EL4 (Satz)
1 520 713 LIT-digital: LP3 Science Lab Elektrik
1 521 487 AC/DC Netzgerät PRO 0...12 V/3 A
1 524 005W2 Mobile-CASSY 2 WLAN
2 531 120* Vielfach-Messgerät LDanalog 20 (Multimeter)
* alternativ
Zusätzlich empfohlen:
Menge Kat.-Nr. Bezeichnung
1 500 622 Sicherheits-Experimentierkabel 50 cm, blau
1 520 7135DE LIT-print: LP3.5 Motoren und Generatoren
1 520 71 LIT-digital: LP Science Lab Physik
1 524 438 Spannungssensor M, ±30 V


n Alltagsbezug: Fortsetzung des Themengebietes Elektromagnetismus durch Versuche mit einfachen Motoren und Generatoren
n Motor- und Generatormodelle sind sehr schnell aufgebaut und funktionssicher
n modular aufbauend auf die Basisgeräte in Elektrik EL3
n Zusammenstellung der Sätze ist immer so organisiert, dass die Gruppe Material aus maximal 2 Schüben benötigt
n Elektrik EL5 wird in dem Schub Elektrik EL4 untergebracht
n Kompetenzerwerb: Verständnis unterschiedlicher Antriebskonzepte passend zur Debatte bezüglich der Elektromobilität
SCHÜLERMESSGERÄT

Mobile-CASSY 2 WLAN
DIGITALER UNTERRICHT
Das universelle Schülermessgerät mit WLAN für alle Messaufgaben in der Physik, Chemie und Biologie.
524 005W2 Mobile-CASSY 2 WLAN
Detaillierte Informationen zum Mobile-CASSY 2 WLAN finden Sie im Internet unter www.leybold-shop.de/524005W2
MOBILE-CASSY 2 WLAN

AUSWERTEMÖGLICHKEITEN
Mit dem Mobile-CASSY 2 WLAN kann direkt über 4-mm-Sicherheitsbuchsen Spannung (U), Stromstärke (I), Leistung (P) und Energie (E) gemessen werden.
Hier finden Sie eine Übersicht über unsere Literaturpakete. Detaillierte Informationen zu unserer Literatur finden Sie im Internet unter www.leybold-shop.de.

FACHGEBIET

UNTERRICHTSFACH

LIT-print: LP3.5 Motoren und Generatoren
Ausführliche Versuchsanleitungen zum Science Lab Schub EL5 (207 135S) in Verbindung mit dem Science Lab Schub EL3 (207 133S). Beschreibt 14 Versuche aus dem Thema Motoren und Generatoren.
Versuchsthemen: Generatoren; Elektromotoren
520 7135DE LIT-print: LP3.5 Motoren und Generatoren
LIT-digital: LP3 Science Lab Elektrik

Digitale Version EINES Fachgebiets
Ausführliche Versuchsanleitungen zum Themengebiet Elektrik des Unterrichtsfachs Physik im Science Lab. Beschreibt ca. 149 Versuche zu den Themen Elektrostatik, Magnetismus, Elektrische Grundschaltungen und Elektrochemie, Elektromagnetismus und Induktion, Motoren und Generatoren und Elektronik.
Enthält alle interaktiven Versuchsanleitungen (Lab Docs) als html-Datei.
LIT-digital: LP Science Lab Physik
Gedruckte Version EINES Themas in einem Ringordner Digitale Version ALLER Fachgebiete
Ausführliche Versuchsanleitungen zum Unterrichtsfach Physik im Science Lab. Beschreibt ca. 460 Versuche zu den Fachgebieten Mechanik, Energie, Elektrik und Elektronik, Optik, Atom- und Kernphysik sowie Informatik und Technik.
Enthält alle interaktiven Versuchsanleitungen (Lab Docs) als html-Datei.
520 71 LIT-digital: LP Science Lab Physik
Technische Daten der digitalen Version:
• Lieferung als Produktschlüssel (Aktivierung & Auswahl der Literatursprache über https://register.leylab.de notwendig)
• Systemvoraussetzungen:
Document Center:
PC mit Windows 7 oder höher; Internetzugang während der Installation; lokales Netzwerk zur Verteilung an die Schüler
Leylab:
- PC, Tablet oder Smartphone mit gängigem Browser; Internetzugang





n bei jedem Trend geht es natürlich auch um die Gewinnung von Grundlagenkenntnissen
n beim Drehen der Antriebsrolle kann der Spannungsverlauf gemessen oder durch Verwendung einer Glühlampe visualisiert werden
n generelles Verständnis zum Generator
n übertragbar auf die Windenergie

n der Gleichstrommotor ist vergleichbar mit einem E-Bike Motor
n durch den Zusammenbau und die Inbetriebnahme verschiedener Motoren erlangen die Schüler und Schülerinnen Kenntnisse über die jeweilige Funktion
n durch diese Untersuchung und die weiteren Versuche zum Elektromotor bekommen die Schüler und Schülerinnen einen ersten Einblick in das Thema Elektromobilität

LP4.1.1 Kondensatoren
LP4.1.1.1
LP4.1.1.1C
LP4.1.1.2
LP4.1.1.2C
Kondensator im Gleichstromkreis
Kondensator im Gleichstromkreis (mit Mobile-CASSY 2 WLAN)
Kondensator im Wechselstromkreis
Kondensator im Wechselstromkreis (mit Mobile-CASSY 2 WLAN)
LP4.1.2 Relaisschaltungen
LP4.1.2.1
LP4.1.2.1C Lichtgesteuertes Relais
Lichtgesteuertes Relais (mit Mobile-CASSY 2 WLAN)
LP4.1.3 Dioden
LP4.1.3.1
LP4.1.3.1C
LP4.1.3.2
LP4.1.3.2C
LP4.1.3.3
LP4.1.3.3C
LP4.1.3.4
LP4.1.3.4C
LP4.1.3.5
LP4.1.3.6
LP4.1.3.6C
LP4.1.3.7
LP4.1.3.7C
Kennlinie einer Diode
Kennlinie einer Diode (mit Mobile-CASSY 2 WLAN)
Einweg-Gleichrichtung
Einweg-Gleichrichtung (mit Mobile-CASSY 2 WLAN)
Zweiweg-Gleichrichtung
Zweiweg-Gleichrichtung (mit Mobile-CASSY 2 WLAN)
Leuchtdioden
Leuchtdioden (mit Mobile-CASSY 2 WLAN)
Polprüfer mit Dioden Kennlinie einer Z-Diode
Kennlinie einer Z-Diode (mit Mobile-CASSY 2 WLAN)
Überspannungsschutz durch eine Z-Diode Überspannungsschutz durch eine Z-Diode (mit Mobile-CASSY 2 WLAN)
LP4.1.4 Transistoren
LP4.1.4.1
LP4.1.4.2
LP4.1.4.2C
LP4.1.4.3
LP4.1.4.3C
LP4.1.4.4
LP4.1.4.5
LP4.1.4.5C
Diodenstrecken an Transistoren, Prüfschaltung mit Leuchtdioden
Übertragungs-Kennlinie eines Transistors Übertragungs-Kennlinie eines Transistors (mit Mobile-CASSY 2 WLAN) Transistorschaltung I, Spannungsteuerung Transistorschaltung I, Spannungsteuerung (mit Mobile-CASSY 2 WLAN) Lichtgesteuerter Transistor I, Lichtschranke Verzögerungsschalter Verzögerungsschalter (mit Mobile-CASSY 2 WLAN)
LP4.1.5 Diodenschaltungen
LP4.1.5.1
LP4.1.5.1C
LP4.1.5.2
LP4.1.5.2C
Überspannungs- und Verpolungsschutz durch Dioden Überspannungs- und Verpolungsschutz durch Dioden (mit Mobile-CASSY 2 WLAN) Glätten pulsierender Gleichspannungen mit Kondensatoren Glätten pulsierender Gleichspannungen mit Kondensatoren (mit Mobile-CASSY 2 WLAN)
LP4.1.6 Kippstufen
LP4.1.6.1
LP4.1.6.1C Grundversuche zu Kippstufen Grundversuche zu Kippstufen (mit Mobile-CASSY 2 WLAN)
LP4.1.7 Verstärkerschaltungen
LP4.1.7.2
LP4.1.7.2C Berührungs-Schalter, Feuchtigkeits- und Füllstandanzeiger Berührungs-Schalter, Feuchtigkeits- und Füllstandanzeiger (mit Mobile-CASSY 2 WLAN)

Zweiweg-Gleichrichtung
ÜBERSICHT BENÖTIGTES


Kat.-Nr. Bezeichnung
207 133S Science Lab Elektrik EL3 (Satz)
207 136S Science Lab Elektrik EL6 (Satz)
Eine Auswahl der Literaturpakete finden Sie auf den nachfolgenden Seiten.



Schülerexperimentiersatz des Schülerversuche-Systems Science Lab im Bereich Physik. Aufbaumaterial für eine Arbeitsgruppe in gerätegeformter Aufbewahrung. Mit dem Gerätesatz EL6 können, zusammen mit dem Science Lab Elektrik EL3 (207 133S), 35 Versuche in der S I und S II durchgeführt werden.
Inhaltlich beschäftigen sich die Schülerinnen und Schüler mit den Themen elektronische Grundschaltungen und Transistorelektronik. Beim Bearbeiten der lehrplangeforderten Themen werden sie auch in den Kompetenzen Kommunikation und Bewertung geschult. In Verbindung mit dem Mobile-CASSY 2 WLAN (524 005W2) ergeben sich weitere Auswertemöglichkeiten, die digitales Lernen ermöglichen.
Lieferumfang:
Menge Kat.-Nr. Bezeichnung
1 576 81 Rastersteckplatte Si-Bu, 20/10
1 577 40 Widerstand 470 Ohm, STE 2/19
1 577 52 Widerstand 4,7 kOhm, STE 2/19
1 577 90 Potentiometer 220 Ohm, STE 4/50
1 578 35 Kondensator 1 µF, STE 2/19
1 578 39 Kondensator (Elko) 100 µF, STE 2/19
1 578 40 Kondensator (Elko) 470 µF, STE 2/19
1 578 48 Leuchtdiode rot, STE 2/19
4 578 51 Diode 1N 4007, STE 2/19
1 578 55 Z-Diode 6,2, STE 2/19
1 578 57 Leuchtdiode grün, STE 2/19
1 578 618 Fotodiode, seitlich
1 578 62 Solarzelle STE 2/19
1 578 67 Transistor BD 137, NPN, E.u., STE 4/50
1 578 68 Transistor BD 138, PNP, E.u., STE 4/50
1 579 21 Relais mit Umschalter STE 4/50
1 579 29 Kopfhörer
1 647 001 Geräteschub, niedrig 207 136S Science Lab Elektrik EL6 (Satz)
Zusätzlich erforderlich:
Menge Kat.-Nr. Bezeichnung
1 207 133S Science Lab Elektrik EL3 (Satz)
1 520 713 LIT-digital: LP3 Science Lab Elektrik
1 521 487 AC/DC Netzgerät PRO 0...12 V/3 A
1 524 005W2 Mobile-CASSY 2 WLAN
2 531 120* Vielfach-Messgerät LDanalog 20 (Multimeter) * alternativ
Zusätzlich empfohlen:
Menge Kat.-Nr. Bezeichnung
1 500 622 Sicherheits-Experimentierkabel 50 cm, blau
1 520 7136DE LIT-print: LP4.1 Elektronik
1 520 71 LIT-digital: LP Science Lab Physik
1 524 438 Spannungssensor M, ±30 V


n direkte Strom- und Spannungsmessungen auf der Steckplatte ohne zusätzliche Bauteile n Schülerinnen und Schüler lernen durch die strukturierten Versuchsanleitungen komplexere Aufbauten bis hin zu Dioden- und Transistorschaltungen zu verstehen n zusammen mit den beiden Rastersteckplatten aus dem Schub EL3 bietet die im Schub enthaltene Rastersteckplatte einen sehr flexiblen Einsatz für übersichtliche Versuchsanordnungen
n Parallelen zum Einsatz von Leiterplatten in elektronischen Bauteilen werden sichtbar
n modular aufbauend auf die Basisgeräte in Elektrik EL3 n Zusammenstellung der Sätze ist immer so organisiert, dass eine Schülergruppe Material aus maximal 2 Schüben benötigt
n Kompetenzerwerb: Verständnis für die Funktionsweise elektronischer Bauteile in modernen, technischen Geräten
SCHÜLERMESSGERÄT

SENSOREN

Mobile-CASSY 2 WLAN
Das universelle Schülermessgerät mit WLAN für alle Messaufgaben in der Physik, Chemie und Biologie.
524 005W2 Mobile-CASSY 2 WLAN
Detaillierte Informationen zum Mobile-CASSY 2 WLAN finden Sie im Internet unter www.leybold-shop.de/524005W2
Spannungssensor M, ±30 V
EMPFOHLENE SENSOREN
Zur Messung der elektrischen Spannung bis ±30 V mit dem Mobile-CASSY 2 WLAN. In Verbindung mit dem integrierten Spannungseingang wird aus dem Mobile-CASSY 2 WLAN (524 005W2) dadurch ein 2-kanaliges Speicheroszilloskop.
524 4368 Spannungssensor M, ±30 V
Detaillierte Informationen zu diesem und anderen Sensoren finden Sie im Internet unter www.leybold-shop.de
Hier finden Sie eine Übersicht über unsere Literaturpakete.
Detaillierte Informationen zu unserer Literatur finden Sie im Internet unter www.leybold-shop.de.

FACHGEBIET

UNTERRICHTSFACH

LIT-print: LP4 Elektronik
Ausführliche Versuchsanleitungen zum Science Lab Schub EL6 (207 136S) in Verbindung mit dem Science Lab Schub EL3 (207 133S). Beschreibt 35 Versuche aus dem Thema Elektronik.
Versuchsthemen: Kondensatoren; Relaisschaltungen; Dioden; Transistoren; Diodenschaltungen; Kippstufen; Verstärkerschaltungen
520 7136DE LIT-print: LP4 Elektronik
LIT-digital: LP3 Science Lab Elektrik
Digitale
Ausführliche Versuchsanleitungen zum Themengebiet Elektrik des Unterrichtsfachs Physik im Science Lab. Beschreibt ca. 149 Versuche zu den Themen Elektrostatik, Magnetismus, Elektrische Grundschaltungen und Elektrochemie, Elektromagnetismus und Induktion, Motoren und Generatoren und Elektronik.
Enthält alle interaktiven Versuchsanleitungen (Lab Docs) als html-Datei.
520 713 LIT-digital: LP3 Science Lab Elektrik
LIT-digital: LP Science Lab Physik
Digitale Version
Ausführliche Versuchsanleitungen zum Unterrichtsfach Physik im Science Lab. Beschreibt ca. 460 Versuche zu den Fachgebieten Mechanik, Energie, Elektrik und Elektronik, Optik, Atom- und Kernphysik sowie Informatik und Technik.
Enthält alle interaktiven Versuchsanleitungen (Lab Docs) als html-Datei.
520 71 LIT-digital: LP Science Lab Physik
Technische Daten der digitalen Version:
• Lieferung als Produktschlüssel (Aktivierung & Auswahl der Literatursprache über https://register.leylab.de notwendig)
• Systemvoraussetzungen:
Document Center:
PC mit Windows 7 oder höher; Internetzugang während der Installation; lokales Netzwerk zur Verteilung an die Schüler
Leylab:
- PC, Tablet oder Smartphone mit gängigem Browser; Internetzugang





Beobachtung
4,10
9,05 0,888 9,84 0,966



n mit dem Mobile-CASSY 2 WLAN können zwei oder mehr Messgrößen gegeneinander gemessen und gleichzeitig aufgenommen werden, wie z. B.
n Strom und Spannung
n Temperatur und Spannung
n damit können Abhängigkeiten zwischen Messgrößen in Diagrammen ausgezeichnet dargestellt werden
Strom- und Spannungsmessung an einem Widerstand
Abb. 3:Strom- und Spannungsmessung eines Widerstands. Ursprungsgerade y = m · x mit m = 10,18 V/A
Bereich ändern
n dadurch erlangen Schüler und Schülerinnen ein tiefergehendes Verständnis für die Grundprinzipien der Elektronik
n ein einfaches Messen von Kennlinien ist nur mit digitaler Messtechnik möglich
http://192.168.30.178/LD/preview.html?hash=tIF2DR+Cz&preview
VERSUCHSLITERATUR
Durch die Interaktivität zwischen dem Mobile-CASSY 2 WLAN und den Lab Docs werden die Messwerte in Echtzeit in das Lab Doc übertragen und die Kennlinien direkt in den Diagrammen angezeigt.
Das Lab Doc mit den aufgenommenen Kennlinien ist zudem als digitales Protokoll speicherbar und anschließend mit dem Lehrer teilbar.
Mit dem Lab Docs Editor können unter anderem die Diagramme angepasst werden.

Die Optik kann dazu dienen, den Schüler schon sehr früh mit einfachen Experimenten an die Methodik zur Untersuchung von Phänomenen heranzuführen. Durch den flexiblen Einsatz der LED-Leuchte können Strahlengänge durch verschiedene Objekte auf dem Tisch mit einfachsten Aufbauten beobachtet und beschrieben werden. Zudem lassen sich auch komplexere Inhalte, wie z. B. Interferenz- und Beugungsphänomene, für den Unterricht in der Oberstufe in einem einfachen und verständlichen Rahmen erarbeiten.
2 Optik-Schübe ergeben 4 Themengebiete mit mehr als 70 Versuchen. Dabei können Messwerte in einigen ausgewählten Versuchen sowohl auf klassischem Weg als auch mit Hilfe des Mobile-CASSY 2 WLAN und dem Luxsensor M digital aufgenommen werden.

Die Schülerinnen und Schüler sollen in diesem Versuch erkennen, dass die Beleuchtungsstärke E einer „Punktquelle“ mit 1/r² abnimmt und somit dem Abstandsgesetz unterliegt. Für diesen Versuch benötigen Sie den Schub Science Lab Optik OP1 (207 141S)
VERSUCHSTHEMEN
LP5.1 STRAHLENOPTIK UND GEOMETRISCHE OPTIK
LP5.1.1 LICHTAUSBREITUNG UND SCHATTENBILDUNG
LP5.1.2 LICHT UND SCHATTEN IN DER NATUR
LP5.1.3 REFLEXION AN SPIEGELN
LP5.1.4 LICHTBRECHUNG
LP5.1.5 FARBZERLEGUNG UND WIEDERVEREINIGUNG DES SPEKTRUMS
LP5.1.6 LINSEN UND LINSENFEHLER
LP5.1.7 OPTISCHE INSTRUMENTE ZUR VERGRÖSSERUNG DES SEHWINKELS
LP5.1.8 OPTISCHE INSTRUMENTE UND AUGE
LP5.2 FARBENLEHRE
LP5.2.1 UNTERSUCHUNG DER LICHTWEGE DURCH EIN PRISMA
LP5.2.2 SPEKTRALFARBEN
LP5.2.3 FARBMISCHUNG


VERSUCHE S. 116
VERSUCHE


LP5.3 WELLENOPTIK
LP5.3.1 BEUGUNG AN BEUGUNGSOBJEKTEN
LP5.3.2 BEUGUNG AN KOMPLEMENTÄREN BLENDEN
LP5.3.3 ZWEISTRAHL-INTERFERENZ


LP5.4 POLARISATION
LP5.4.1 POLARISATIONSFILTER
LP5.4.2 SPANNUNGSOPTISCHE DOPPELBRECHUNG
LP5.4.3 POLARISATION INFOLGE REFLEXION UND BRECHUNG
LP5.4.4 POLARISATION INFOLGE STREUUNG
LP5.4.5 OPTISCHE AKTIVITÄT


Weitere Informationen zu unseren lehrplankonformen Themen und Schülerversuchen sowie die dazugehörigen Schübe finden Sie auf den nachfolgenden Seiten.
LP5.1.1 Lichtausbreitung und Schattenbildung
LP5.1.1.1
LP5.1.1.2
LP5.1.1.3
LP5.1.1.4
LP5.1.1.4C
Lichtausbreitung Durchdringt Licht alle Stoffe? Schatten Die Beleuchtungsstärke Die Beleuchtungsstärke (mit Mobile-CASSY 2 WLAN)
LP5.1.2 Licht und Schatten in der Natur
LP5.1.2.1
LP5.1.2.2
LP5.1.2.3
LP5.1.2.4 Tag und Nacht Die Jahreszeiten Die Mondphasen Mond- und Sonnenfinsternis
LP5.1.3 Reflexion an Spiegeln
LP5.1.3.1
LP5.1.3.2
LP5.1.3.3
LP5.1.3.4
LP5.1.3.5
LP5.1.3.6
LP5.1.3.7 Reflexion am Planspiegel Das Spiegelbild am Planspiegel Strahlengang mit Hohlspiegel Brennweite des Konvexspiegels Brennweite des Konkavspiegels Bilder am Konkavspiegel Bilder am Konvexspiegel
LP5.1.4 Lichtbrechung
LP5.1.4.1
LP5.1.4.2
LP5.1.4.3
LP5.1.4.4
LP5.1.4.5
Brechung des Lichtes am Halbkreiskörper Brechung an einer planparallelen Platte Totalreflexion Umlenk- und Umkehrprisma Brechung in verschiedenen Medien an Halbkreistrog und Halbkreiskörper
LP5.1.5 Farbzerlegung und Wiedervereinigung des Spektrums
LP5.1.5.1
LP5.1.5.2 Zerlegung des weißen Lichtes mit einem Prisma Wiedervereinigung des Spektrums
LP5.1.6 Linsen und Linsenfehler
LP5.1.6.1
LP5.1.6.2
LP5.1.6.3
LP5.1.6.4
LP5.1.6.5
LP5.1.6.6
LP5.1.6.7
LP5.1.6.8
LP5.1.6.9
LP5.1.6.10
LP5.1.6.11
Strahlengang durch eine Konvexlinse
Konstruktionsstrahlen an einer Konvexlinse Bilder der konvexen Linse Sphärischer Linsenfehler
Brennweitenbestimmung der konvexen Linse durch Autokollimation Strahlengang durch eine Konkavlinse Konstruktionsstrahlen an einer Konkavlinse
Die Abbildungsformel Kissen- und tonnenförmige Verzeichnungen Strahlengang bei Linsenkombinationen Brennweite von Linsensystemen
LP5.1.7 Optische Instrumente zur Vergrößerung des Sehwinkels
LP5.1.7.1
LP5.1.7.2
LP5.1.7.3
LP5.1.7.4
LP5.1.7.5
LP5.1.7.6
Vergrößerung durch eine Lupe
Das Mikroskop Veränderung der Vergrößerung eines Mikroskops Fernrohrmodelle
Vergrößerung eines holländischen Fernrohrs Vergrößerung eines astronomischen Fernrohrs
LP5.1.8 Optische Instrumente und Auge
LP5.1.8.1
LP5.1.8.2
LP5.1.8.3
LP5.1.8.4
LP5.1.8.5
LP5.1.8.6
Die Kamera
Die Tiefenschärfe der Kamera
Der Diaprojektor
Das menschliche Auge Augenfehler und deren Korrektur Optische Täuschungen

Die Schülerinnen und Schüler sollen lernen, dass komplementäre Blenden gleiche Beugungsbilder erzeugen. Im Vergleich zu dem Versuch Spalt und Steg stellen die Kreuzgitter eine weitaus komplexere Struktur dar. Für diesen Versuch benötigen Sie die Schübe Science Lab Optik OP1 (207 141S) und Science Lab Optik OP3 (207 143S).

Kat.-Nr. Bezeichnung
207 141S Science Lab Optik OP1 (Satz)
Eine Auswahl der Literaturpakete finden Sie auf den nachfolgenden Seiten.

Literatur


Schülerexperimentiersatz des Schülerversuche-Systems Science Lab im Bereich Physik. Aufbaumaterial für eine Arbeitsgruppe in gerätegeformter Aufbewahrung. Mit dem Gerätesatz OP1 können 46 Versuche in der S I und S II durchgeführt werden.
Inhaltlich beschäftigen sich die Schülerinnen und Schüler mit der Strahlenoptik und geometrischer Optik. Beim Bearbeiten der lehrplangeforderten Themen werden sie auch in den Kompetenzen Kommunikation und Bewertung geschult. In Verbindung mit dem Mobile-CASSY 2 WLAN (524 005W2) ergeben sich weitere Auswertemöglichkeiten, die digitales Lernen ermöglichen.
Lieferumfang:
Menge Kat.-Nr. Bezeichnung
1 311 78 Bandmaß 2 m
1 340 90 Gummiringe, Satz 8
1 459 093 Lichtboxgehäuse, LED
1 459 094 LED-Leuchte
1 459 095 USB-Steckernetzgerät 5 V DC (A-Buchse)
1 459 096 USB-Kabel (A-ST - Mini-B St)
1 459 24 Transparentschirm auf Stiel
1 459 30 Plattenhalter auf Stiel
1 459 33 Halter für Blenden und Dias auf Stiel
1 459 38 Planspiegel 7,5 cm x 5 cm
1 459 39 Erde-Mond-Modell auf Stiel
1 459 41 Kombi-Spiegelmodell
1 459 44 Trapezkörper 60 mm/45 mm x 30 mm
1 459 45 Halbkreiskörper r = 30 mm
1 459 46 Rechtwinkeliges Prisma h = 30 mm
1 459 48 Linsenmodell plankonvex
1 459 50 Linsenmodell plankonkav
1 459 52 Halbkreistrog r = 30 mm
1 459 60 Linse auf Stiel f = +50 mm
1 459 62 Linse auf Stiel f = +100 mm
1 459 64 Linse auf Stiel f = +300 mm
1 459 68 Linse auf Stiel f = -100 mm
1 459 71 Konvex-Konkav-Spiegel auf Stiel
1 460 82 Präzisions-Metallschiene, 50 cm
5 460 95 Klemmreiter
1 461 62 Blenden mit Schlitz, Satz 2
1 461 63 Blenden mit verschiedenen Öffnungen, Satz 4
1 461 64 Blenden mit Loch, Satz 4
1 461 66 Abbildungsobjekte, Paar
1 461 69 Optische Täuschungen, Satz 6
1 647 002 Geräteschub, hoch
Zusätzlich erforderlich:
Menge Kat.-Nr. Bezeichnung
1 520 714 LIT-digital: LP5 Science Lab Optik
Zusätzlich empfohlen:
Menge Kat.-Nr. Bezeichnung
1 459 40 Scheibe mit Winkelskala
1 520 7141DE LIT-print: LP5.1 Strahlenoptik und geometrische Optik
1 520 71 LIT-digital: LP Science Lab Physik
1 524 005W2 Mobile-CASSY 2 WLAN
1 524 444 Luxsensor M
1 647 003 Deckel zu Geräteschub

n beinhaltet optische Basisgeräte und alle weiteren Geräte für die Strahlenoptik und die geometrische Optik
n die LED-Leuchte kann sowohl für Experimente auf der Tischplatte (Lichtbox) als auch auf der Präzisionsmetallschiene eingesetzt werden
n Einsatz einer sehr handlichen 50 cm-Präzisionsmetallschiene, z. B. zum Aufbau eines Fernrohrs oder als optische Bank (auch in der Mechanik einsetzbar)
n kompatibel auch mit den älteren Optik-Schienensystemen der LD DIDACTIC
n Messung von Lichtstärke mit dem Mobile-CASSY 2 WLAN und dem Luxsensor M ermöglicht einen frühen Einstieg in die digitale Messwerterfassung
n Schub Optik OP1 dient zugleich als Basis für die weiteren Optik-Schübe
SCHÜLERMESSGERÄT

SENSOREN

Mobile-CASSY 2 WLAN
Das universelle Schülermessgerät mit WLAN für alle Messaufgaben in der Physik, Chemie und Biologie.
524 005W2 Mobile-CASSY 2 WLAN
Detaillierte Informationen zum Mobile-CASSY 2 WLAN finden Sie im Internet unter www.leybold-shop.de/524005W2
Luxsensor M
Zur Messung der Beleuchtungsstärke von sichtbarem Licht mit Mobile-CASSY 2 (524 005W2). Der Luxsensor ist flach ausgeführt, damit er beispielsweise direkt in den Halter für Blenden und Dias auf Stiel (459 33) eingesetzt werden kann. Mit dem Luxsensor lassen sich Versuche entlang und orthogonal zur optischen Achse durchführen. Eine aufgedruckte Millimeterskala dient dazu, den Sensor auf der optischen Achse zu positionieren und ermöglicht zudem die Aufnahme von Intensitätsverteilungen verschiedener Beugungsobjekte ohne weitere Hilfsmittel.
524 444 Luxsensor M
Detaillierte Informationen zu diesem und anderen Sensoren finden Sie im Internet unter www.leybold-shop.de.
STROMVERSORGUNG

USB Powerbank 2200 mAh
Powerbank mit 2200 mAh passend zur LED-Leuchte (459 094), Dreifach-LED-Leuchte (459 098) und dem Laser Klasse 1, rot (459 097). Für das Laden der Powerbank kann das USB-Steckernetzgerät 5V DC (459 095) und das USB-Kabel (459 096) verwendet werden.
459 099
USB Powerbank 2200 mAh
Hier finden Sie eine Übersicht über unsere Literaturpakete.
Detaillierte Informationen zu unserer Literatur finden Sie im Internet unter www.leybold-shop.de.

FACHGEBIET

UNTERRICHTSFACH

LIT-print: LP5.1 Strahlenoptik und geometrische Optik
Ausführliche Versuchsanleitungen zum Science Lab Schub OP1 (207 141S). Beschreibt 46 Versuche aus dem Thema Strahlenoptik und geometrische Optik. Versuchsthemen: Lichtausbreitung und Schattenbildung; Licht und Schatten in der Natur; Reflexion an Spiegeln; Lichtbrechung; Farbzerlegung und Wiedervereinigung des Spektrums; Linsen und Linsenfehler; Optische Instrumente zur Vergrößerung des Sehwinkels; Optische Instrumente und Auge
520 7141DE LIT-print: LP5.1 Strahlenoptik und geometrische Optik
LIT-digital: LP5 Science Lab Optik
Ausführliche Versuchsanleitungen zum Themengebiet Optik des Unterrichtsfachs Physik im Science Lab. Beschreibt ca. 70 Versuche zu den Themen Strahlenoptik und geometrische Optik, Farbenlehre, Wellenoptik und Polarisation.
Enthält alle interaktiven Versuchsanleitungen (Lab Docs) als html-Datei.
520 714 LIT-digital: LP5 Science Lab Optik
LIT-digital: LP Science Lab Physik
Ausführliche Versuchsanleitungen zum Unterrichtsfach Physik im Science Lab. Beschreibt ca. 460 Versuche zu den Fachgebieten Mechanik, Energie, Elektrik und Elektronik, Optik, Atom- und Kernphysik sowie Informatik und Technik.
Enthält alle interaktiven Versuchsanleitungen (Lab Docs) als html-Datei.
520 71 LIT-digital: LP Science Lab Physik
Technische Daten der digitalen Version:
• Lieferung als Produktschlüssel (Aktivierung & Auswahl der Literatursprache über https://register.leylab.de notwendig)
• Systemvoraussetzungen:
Document Center:
PC mit Windows 7 oder höher; Internetzugang während der Installation; lokales Netzwerk zur Verteilung an die Schüler
Leylab:
- PC, Tablet oder Smartphone mit gängigem Browser; Internetzugang





Nur noch eine Lichtquelle! Für Versuche mit der Lichtbox auf dem Tisch und auf der Präzisionsmetallschiene

FÜR VERSUCHE IN DER STRAHLENOPTIK MIT DER LICHTBOX AUF DEM TISCH


n unsere LED-Leuchte ist nach DIN EN 62471 in die Risikogruppe 1 eingestuft
n keine Gefahr für die Augen der Schüler und Schülerinnen beim Experimentieren
n minimale Hitzeentwicklung gegenüber Halogenlampen
n robustes Gehäuse und einfache Bedienbarkeit
Die LED-Leuchte FÜR VERSUCHE IN DER GEOMETRISCHEN OPTIK AUF DER PRÄZISIONSMETALLSCHIENE


Lab Doc zum Versuch Beleuchtungsstärke

LP5.2.1
LP5.2.1.1
Untersuchung der Lichtwege durch ein Prisma
LP5.2.1.2 Lichtwege durch ein Prisma Ablenkungen im Prisma
LP5.2.2 Spektralfarben
LP5.2.2.1
LP5.2.2.2
LP5.2.2.3
LP5.2.2.4
Zerlegung von weißem Licht Farbfehler bei Abbildungen
Untersuchung von Spektralfarben Spektren von verschiedenen Schlitzen
LP5.2.3 Farbmischung
LP5.2.3.1
LP5.2.3.2
LP5.2.3.3
LP5.2.3.4
LP5.2.3.5
Wiedervereinigung des Spektrums Licht und Körperfarben
Additive Mischung von zwei Lichtfarben
Additive Mischung von drei Lichtfarben
Subtraktive Farbmischung

LP5.2.2.1 Zerlegung von weißem Licht

LP5.2.3.4 Additive Mischung von drei Lichtfarben
ÜBERSICHT



Kat.-Nr. Bezeichnung
207 141S Science Lab Optik OP1 (Satz)
207 142S Science Lab Optik OP2 (Satz)
Eine Auswahl der Literaturpakete finden Sie auf den nachfolgenden Seiten.



Schülerexperimentiersatz des Schülerversuche-Systems Science Lab im Bereich Physik. Aufbaumaterial für eine Arbeitsgruppe. Die Aufbewahrung der Geräte erfolgt in Science Lab Optik OP1 (207 141S). Mit dem Ergänzungsatz OP2 können, zusammen mit dem Science Lab Optik OP1, mehr als 11 Versuche in der S I und S II durchgeführt werden.
Inhaltlich beschäftigen sich die Schülerinnen und Schüler mit der Farbenlehre. Beim Bearbeiten der lehrplangeforderten Themen werden sie auch in den Kompetenzen Kommunikation und Bewertung geschult.
Lieferumfang:
Menge Kat.-Nr. Bezeichnung
1 459 098 Dreifach-LED-Leuchte
1 459 31 Kerzenhalter
1 465 20 Prisma, Kunstglas
1 467 95 Farbfilter primär, Satz 3
1 467 96 Farbfilter sekundär, Satz 3
1 467 97 Dreifach-Filter
1 469 99 Durchlicht-Beugungsgitter 500/mm
1 686 60 Verlängerungsstift
207 142S Science Lab Optik OP2 (Satz)
Zusätzlich erforderlich:
Menge Kat.-Nr. Bezeichnung
1 207 141S Science Lab Optik OP1 (Satz)
1 520 714 LIT-digital: LP5 Science Lab Optik
Zusätzlich empfohlen:
Menge Kat.-Nr. Bezeichnung
1 520 7142DE LIT-print: LP5.2 Farbenlehre
1 520 71 LIT-digital: LP Science Lab Physik


n Versuche von der Farbmischung bis zu Grundlagen der Beugung n ausgeklügelte und einfach zu bedienende Dreifach-LED-Leuchte kann durch einfaches Ein- und Ausschalten einer der verbauten LED-Chips sowohl für die Mischung von drei als auch zwei Farben eingesetzt werden
n mit dem beiliegenden Durchlichtbeugungsgitter können, neben der Farbzerlegung, erste Ansätze der Beugung mit den Schülerinnen und Schülern diskutiert werden
n modular aufbauend auf die Basisgeräte in Optik OP1 n Geräte aus OP2 werden im Schub Optik OP1 untergebracht

SENSOREN

Mobile-CASSY 2 WLAN
Das universelle Schülermessgerät mit WLAN für alle Messaufgaben in der Physik, Chemie und Biologie.
524 005W2 Mobile-CASSY 2 WLAN
Detaillierte Informationen zum Mobile-CASSY 2 WLAN finden Sie im Internet unter www.leybold-shop.de/524005W2
Luxsensor M
EMPFOHLENE SENSOREN
Zur Messung der Beleuchtungsstärke von sichtbarem Licht mit Mobile-CASSY 2 (524 005W2). Der Luxsensor ist flach ausgeführt, damit er beispielsweise direkt in den Halter für Blenden und Dias auf Stiel (459 33) eingesetzt werden kann. Mit dem Luxsensor lassen sich Versuche entlang und orthogonal zur optischen Achse durchführen. Eine aufgedruckte Millimeterskala dient dazu, den Sensor auf der optischen Achse zu positionieren und ermöglicht zudem die Aufnahme von Intensitätsverteilungen verschiedener Beugungsobjekte ohne weitere Hilfsmittel.
524 444 Luxsensor M
Detaillierte Informationen zu diesem und anderen Sensoren finden Sie im Internet unter www.leybold-shop.de.

Mit dem Mobile-CASSY 2 WLAN kann direkt über 4-mm-Sicherheitsbuchsen
Spannung (U), Stromstärke (I), Leistung (P) und Energie (E) gemessen werden.
Hier finden Sie eine Übersicht über unsere Literaturpakete.
Detaillierte Informationen zu unserer Literatur finden Sie im Internet unter www.leybold-shop.de.

FACHGEBIET

UNTERRICHTSFACH

LIT-print: LP5.2 Farbenlehre
Ausführliche Versuchsanleitungen zum Science Lab Schub OP2 (207 142S) in Verbindung mit dem Science Lab Schub OP1 (207 141S). Beschreibt 11 Versuche aus dem Thema Farbenlehre.
Versuchsthemen:
Untersuchung der Lichtwege durch ein Prisma; Spektralfarben; Farbmischung
520 7142DE LIT-print: LP5.2 Farbenlehre
LIT-digital: LP5 Science Lab Optik
Digitale Version EINES Fachgebiets
Ausführliche Versuchsanleitungen zum Themengebiet Optik des Unterrichtsfachs Physik im Science Lab. Beschreibt ca. 70 Versuche zu den Themen Strahlenoptik und geometrische Optik, Farbenlehre, Wellenoptik und Polarisation.
Enthält alle interaktiven Versuchsanleitungen (Lab Docs) als html-Datei.
520 714 LIT-digital: LP5 Science Lab Optik
LIT-digital: LP Science Lab Physik
Digitale Version
Fachgebiete
Ausführliche Versuchsanleitungen zum Unterrichtsfach Physik im Science Lab. Beschreibt ca. 460 Versuche zu den Fachgebieten Mechanik, Energie, Elektrik und Elektronik, Optik, Atom- und Kernphysik sowie Informatik und Technik.
Enthält alle interaktiven Versuchsanleitungen (Lab Docs) als html-Datei.
520 71 LIT-digital: LP Science Lab Physik
Technische Daten der digitalen Version:
• Lieferung als Produktschlüssel (Aktivierung & Auswahl der Literatursprache über https://register.leylab.de notwendig)
• Systemvoraussetzungen:
Document Center:
PC mit Windows 7 oder höher; Internetzugang während der Installation; lokales Netzwerk zur Verteilung an die Schüler
Leylab:
- PC, Tablet oder Smartphone mit gängigem Browser; Internetzugang





Durchdachte

n die Dreifach-LED-Leuchte kann über den USB-Ausgang des Mobile-CASSY 2 WLAN, über eine Powerbank oder das USBSteckernetzgerät betrieben werden
n mit dem Mobile-CASSY 2 WLAN oder einer Powerbank können alle Versuche mit der Dreifach-LED-Leuchte ohne Netzanschluss durchgeführt werden

Betrieb über das Mobile-CASSY 2 WLAN
FARBMISCHUNG
Durch einfaches Umschalten der Dreifach-LED-Leuchte von 2 auf 3 Lichtquellen, können sowohl Experimente zur Farbmischung mit zwei Farben als auch mit drei Farben durchgeführt werden.

Betrieb über einen Netzanschluss
LP5.3.1 Beugung an Beugungsobjekten
LP5.3.1.1
LP5.3.1.1C
LP5.3.1.2
LP5.3.1.3
LP5.3.1.4
LP5.3.1.5
Beugung an einem Spalt Beugung an einem Spalt (mit Mobile-CASSY 2 WLAN) Beugung an Doppelspalten Beugung an Mehrfachspalten Beugung an Gittern Beugung an Reflexionsgittern
LP5.3.2 Beugung an komplementären Blenden
LP5.3.2.1
LP5.3.2.2 Spalt und Steg (Babinetsches Prinzip) Komplementäre Kreuzgitter (Babinetsches Prinzip)
LP5.3.3 Zweistrahl-Interferenz
LP5.3.3.1
LP5.3.3.2
LP5.3.3.3
Doppelspiegel-Versuch von Fresnel Biprisma-Versuch von Fresnel Newtonsche Ringe
LP5.3.1.1C Beugung an einem Spalt 11 VERSUCHE




Kat.-Nr. Bezeichnung
207 141S Science Lab Optik OP1 (Satz)
207 143S Science Lab Optik OP3 (Satz)
Eine Auswahl der Literaturpakete finden Sie auf den nachfolgenden Seiten.



Schülerexperimentiersatz des Schülerversuche-Systems Science Lab im Bereich Physik. Aufbaumaterial für eine Arbeitsgruppe in gerätegeformter Aufbewahrung. Mit dem Gerätesatz OP3 können, zusammen mit dem Science Lab Optik OP1 (207 141S), mehr als 11 Versuche in der S II durchgeführt werden.
Inhaltlich beschäftigen sich die Schülerinnen und Schüler mit der Wellenoptik. Beim Bearbeiten der lehrplangeforderten Themen werden sie auch in den Kompetenzen Kommunikation und Bewertung geschult. In Verbindung mit dem Mobile-CASSY 2 WLAN (524 005W2) ergeben sich weitere Auswertemöglichkeiten, die digitales Lernen ermöglichen.
Lieferumfang:
Menge Kat.-Nr. Bezeichnung
1 459 097 Laser Klasse 1, rot
1 469 731 Blende mit Einzelspalten
1 469 732 Blende mit Doppelspalten (b=konst.)
1 469 733 Blende mit Doppelspalten (d=konst.)
1 469 734 Blende mit Mehrfachspalten
1 469 735 Blende mit Spalt und Steg
1 469 736 Blende mit koplementären Gittern
1 647 001 Geräteschub, niedrig
207 143S Science Lab Optik OP3 (Satz)
Zusätzlich erforderlich:
Menge Kat.-Nr. Bezeichnung
1 207 141S Science Lab Optik OP1 (Satz)
1 520 714 LIT-digital: LP5 Science Lab Optik
Zusätzlich empfohlen:
Menge Kat.-Nr. Bezeichnung
1 459 33 Halter für Blenden und Dias auf Stiel
1 460 82 Präzisions-Metallschiene, 50 cm
1 471 04 Fresnelspiegel auf Platte
1 471 08 Platte und Linse für Newtonsche Ringe
1 471 09 Biprisma
1 520 7143DE LIT-print: LP5.3 Wellenoptik
1 520 71 LIT-digital: LP Science Lab Physik
1 524 005W2 Mobile-CASSY 2 WLAN
1 524 444 Luxsensor M
1 647 003 Deckel zu Geräteschub
1 667 017 Schere 125 mm, rund


n schülersicherer Laser Klasse 1 (RISU-konform)
n neue, verbesserte Beugungsobjekte
n Beugungsphänomene können mit einem einfachem Aufbau auf der Präzisionsmetallschiene (50 cm) veranschaulicht werden
n Einsatz des Luxsensor M ermöglicht es Intensitätsverteilungen für verschiedene Beugungsobjekte aufzunehmen und das Thema auf einem höheren Niveau zu erarbeiten
n modular aufbauend auf die Basisgeräte in Optik OP1
SCHÜLERMESSGERÄT

SENSOREN

Das universelle Schülermessgerät mit WLAN für alle Messaufgaben in der Physik, Chemie und Biologie.
Detaillierte Informationen zum Mobile-CASSY 2 WLAN finden Sie im Internet unter www.leybold-shop.de/524005W2
Luxsensor M
EMPFOHLENE SENSOREN
Zur Messung der Beleuchtungsstärke von sichtbarem Licht mit Mobile-CASSY 2 (524 005W2). Der Luxsensor ist flach ausgeführt, damit er beispielsweise direkt in den Halter für Blenden und Dias auf Stiel (459 33) eingesetzt werden kann. Mit dem Luxsensor lassen sich Versuche entlang und orthogonal zur optischen Achse durchführen. Eine aufgedruckte Millimeterskala dient dazu, den Sensor auf der optischen Achse zu positionieren und ermöglicht zudem die Aufnahme von Intensitätsverteilungen verschiedener Beugungsobjekte ohne weitere Hilfsmittel.
524 444 Luxsensor M
Detaillierte Informationen zu diesem und anderen Sensoren finden Sie im Internet unter www.leybold-shop.de.
Hier finden Sie eine Übersicht über unsere Literaturpakete. Detaillierte Informationen zu unserer Literatur finden Sie im Internet unter www.leybold-shop.de.

FACHGEBIET

UNTERRICHTSFACH

LIT-print: LP5.3 Wellenoptik
Ausführliche Versuchsanleitungen zum Science Lab Schub OP3 (207 143S) in Verbindung mit dem Science Lab Schub OP1 (207 141S). Beschreibt 11 Versuche aus dem Thema Wellenoptik.
Versuchsthemen:
Beugung an Beugungsobjekten; Beugung an komplementären Blenden
520 7143DE LIT-print: LP5.3 Wellenoptik
LIT-digital: LP5 Science Lab Optik
Digitale Version EINES Fachgebiets
Ausführliche Versuchsanleitungen zum Themengebiet Optik des Unterrichtsfachs Physik im Science Lab. Beschreibt mehr als 70 Versuche zu den Themen Strahlenoptik und geometrische Optik, Farbenlehre, Wellenoptik und Polarisation.
Enthält alle interaktiven Versuchsanleitungen (Lab Docs) als html-Datei.
520 714 LIT-digital:
LIT-digital: LP Science Lab Physik
Digitale Version
Fachgebiete
Ausführliche Versuchsanleitungen zum Unterrichtsfach Physik im Science Lab. Beschreibt mehr als 460 Versuche zu den Fachgebieten Mechanik, Energie, Elektrik und Elektronik, Optik, Atom- und Kernphysik und Arduino.
Enthält alle interaktiven Versuchsanleitungen (Lab Docs) als html-Datei.
520 71 LIT-digital: LP Science Lab Physik
Technische Daten der digitalen Version:
• Lieferung als Produktschlüssel (Aktivierung & Auswahl der Literatursprache über https://register.leylab.de notwendig)
• Systemvoraussetzungen:
Document Center:
PC mit Windows 7 oder höher; Internetzugang während der Installation; lokales Netzwerk zur Verteilung an die Schüler
Leylab:
- PC, Tablet oder Smartphone mit gängigem Browser; Internetzugang






BEUGUNG UND INTERFERENZSPANNENDE THEMENFELDER
n RiSU-konformer Laser (Klasse 1 nach DIN EN 60825-1:2015-07)
n zum Vergleich: die meisten handelsüblichen Laserpointer sind in die Klasse 2 eingestuft und nur bedingt für Schülerversuche geeignet

NACHVOLLZIEHBAR BEOBACHTEN & DIGITAL MESSEN

n einfache Durchführung von Beugungsversuchen auf engstem Raum
n durch Bereitstellung geeigneter Beugungsobjekte
n keine zusätzliche und schwer verständliche Beobachtungsoptik notwendig
n geringer Geräteaufwand
n mit dem Luxsensor M können Intensitätsverteilungen auch quantitativ aufgenommen werden
n flexible Stromversorgung des Lasers über
n Powerbank
n USB-Ausgang des Mobile-CASSY 2 WLAN
n USB-Steckernetzgerät
LP5.4.1 Polarisationsfilter
LP5.4.1.1
LP5.4.1.2C Anwendung von Polarisationsfiltern Gesetz von Malus (mit Mobile-CASSY 2 WLAN)
LP5.4.2 Spannungsoptische Doppelbrechung
LP5.4.2.1 Chromatische Polarisation
LP5.4.3 Polarisation infolge Reflexion und Brechung
LP5.4.3.1
LP5.4.3.2 Polarisation infolge Reflexion Brewstersches Gesetz
LP5.4.4 Polarisation infolge Streuung
LP5.4.4.1 Tyndall-Effekt an einer Emulsion
LP5.4.5 Optische Aktivität
LP5.4.5.1
LP5.4.5.1C Polarimetrie (Saccharimetrie) Polarimetrie (Saccharimetrie) (mit Mobile-CASSY 2 WLAN)


LP5.4.5.1 Polarimetrie (Saccharimetrie)
ÜBERSICHT


Kat.-Nr. Bezeichnung
207 141S Science Lab Optik OP1 (Satz)
207 144S Science Lab Optik OP4 (Satz)
Eine Auswahl der Literaturpakete finden Sie auf den nachfolgenden Seiten.



Schülerexperimentiersatz des Schülerversuche-Systems Science Lab im Bereich Physik. Aufbaumaterial für eine Arbeitsgruppe. Die Aufbewahrung der Geräte erfolgt in Science Lab Optik OP3 (207 143S). Mit dem Gerätesatz OP4 können, zusammen mit dem Science Lab Optik OP1 (207 141S), mehr als 8 Versuche in der S II durchgeführt werden.
Inhaltlich beschäftigen sich die Schülerinnen und Schüler mit der Polarisation. Beim Bearbeiten der lehrplangeforderten Themen werden sie auch in den Kompetenzen Kommunikation und Bewertung geschult. In Verbindung mit dem Mobile-CASSY 2 WLAN (524 005W2) ergeben sich weitere Auswertemöglichkeiten, die digitales Lernen ermöglichen.
Lieferumfang:
Menge Kat.-Nr. Bezeichnung
1 459 23 Acrylglasschirm auf Stiel
2 472 38 Polarisationsfilter auf Stiel
1 477 04 Glas-Trog (Küvette), 100 x 50 x 93 mm
1 662 093 Objektträger 76 mm x 26 mm x 1 mm, Satz 50 Stück
1 664 123 Becherglas PP, 250 ml, n.F.
207 144S Science Lab Optik OP4 (Satz)
Zusätzlich erforderlich:
Menge Kat.-Nr. Bezeichnung
1 207 141S Science Lab Optik OP1 (Satz)
1 520 714 LIT-digital: LP5 Science Lab Optik
Zusätzlich empfohlen:
Menge Kat.-Nr. Bezeichnung
1 520 7144DE LIT-print: LP5.4 Polarisation
1 520 71 LIT-digital: LP Science Lab Physik
1 524 005W2 Mobile-CASSY 2 WLAN
1 524 444 Luxsensor M


n Experimente zum Zustandekommen der Polarisation von Licht n Gesetz von Malus kann mit dem Mobile CASSY 2 WLAN und dem Luxsensor M leicht und anschaulich nachgewiesen werden n modular aufbauend auf die Basisgeräte in Optik OP1 n Geräte aus OP4 werden im Schub Optik OP3 untergebracht
SCHÜLERMESSGERÄT

SENSOREN

Mobile-CASSY 2 WLAN
Das universelle Schülermessgerät mit WLAN für alle Messaufgaben in der Physik, Chemie und Biologie.
524 005W2 Mobile-CASSY 2 WLAN
Detaillierte Informationen zum Mobile-CASSY 2 WLAN finden Sie im Internet unter www.leybold-shop.de/524005W2
Luxsensor M
EMPFOHLENE SENSOREN
Zur Messung der Beleuchtungsstärke von sichtbarem Licht mit Mobile-CASSY 2 (524 005W2). Der Luxsensor ist flach ausgeführt, damit er beispielsweise direkt in den Halter für Blenden und Dias auf Stiel (459 33) eingesetzt werden kann. Mit dem Luxsensor lassen sich Versuche entlang und orthogonal zur optischen Achse durchführen. Eine aufgedruckte Millimeterskala dient dazu, den Sensor auf der optischen Achse zu positionieren und ermöglicht zudem die Aufnahme von Intensitätsverteilungen verschiedener Beugungsobjekte ohne weitere Hilfsmittel.
524 444 Luxsensor M
Detaillierte Informationen zu diesem und anderen Sensoren finden Sie im Internet unter www.leybold-shop.de
Hier finden Sie eine Übersicht über unsere Literaturpakete.
Detaillierte Informationen zu unserer Literatur finden Sie im Internet unter www.leybold-shop.de.

FACHGEBIET

UNTERRICHTSFACH

LIT-print: LP5.4 Polarisation
Gedruckte
Ausführliche Versuchsanleitungen zum Science Lab Schub OP4 (207 144S) in Verbindung mit dem Science Lab Schub OP1 (207 141S). Beschreibt 8 Versuche aus dem Thema Polarisation.
Versuchsthemen:
Polarisationsfilter; Spannungsoptische Doppelbrechung; Polarisation infolge Reflexion und Brechung; Polarisation infolge Streuung; Optische Aktivität
520 7144DE LIT-print: LP5.4 Polarisation
LIT-digital: LP5 Science Lab Optik
Ausführliche Versuchsanleitungen zum Themengebiet Optik des Unterrichtsfachs Physik im Science Lab. Beschreibt ca. 70 Versuche zu den Themen Strahlenoptik und geometrische Optik, Farbenlehre, Wellenoptik und Polarisation.
Enthält alle interaktiven Versuchsanleitungen (Lab Docs) als html-Datei.
520 714 LIT-digital: LP5 Science Lab Optik
LIT-digital: LP Science Lab Physik
Ausführliche Versuchsanleitungen zum Unterrichtsfach Physik im Science Lab. Beschreibt ca. 460 Versuche zu den Fachgebieten Mechanik, Energie, Elektrik und Elektronik, Optik, Atom- und Kernphysik sowie Informatik und Technik.
Enthält alle interaktiven Versuchsanleitungen (Lab Docs) als html-Datei.
520 71 LIT-digital: LP Science Lab Physik
Technische Daten der digitalen Version:
• Lieferung als Produktschlüssel (Aktivierung & Auswahl der Literatursprache über https://register.leylab.de notwendig)
• Systemvoraussetzungen:
Document Center:
PC mit Windows 7 oder höher; Internetzugang während der Installation; lokales Netzwerk zur Verteilung an die Schüler
Leylab:
- PC, Tablet oder Smartphone mit gängigem Browser; Internetzugang






DOCFRAGEN BEANTWORTEN
Der Schüler beantwortet die Fragen in seinem eigenen Lab Doc.
LAB DOC - MESSWERTE EINTRAGEN
n ohne Verbindung zum Mobile-CASSY 2 WLAN können die abgelesenen Messwerte manuell eingetragen werden
n Diagramm vervollständigt sich dann automatisch
Der Schüler gibt gerade den sechsten Messwert für die Beleuchtungsstärke ein.

LAB DOC
MOBILE-CASSY 2 WLAN


n CASSY-Sensor Luxsensor M wird automatisch vom Mobile-CASSY 2 WLAN erkannt
n Interaktivität zwischen Messtechnik und Lab Doc
n Beleuchtungsstärke wird bei der Nutzung des Luxsensor M direkt gemessen

DURCHFÜHRUNG DES EXPERIMENTS
LUXSENSOR M

Radioaktivität wird meist mit negativen Assoziationen verbunden, wie beispielsweise Reaktorunfälle. Doch sie ist auch ganz natürlich. Die Umgebungsluft beispielsweise enthält Zerfallsprodukte von Radon. Diese lassen sich in einem einfachen Experiment nachweisen.
Auch in Leitungs- und Regenwasser lässt sich je nach Region eine unterschiedliche Konzentration feststellen. Auf diese Umweltradioaktivität hat sich der menschliche Körper eingestellt und kommt gut damit zurecht. Man nennt diese auch Untergrundstrahlung.
Im Science Lab Atom- und Kernphysik untersuchen die Schülerinnen und Schüler die Umweltradioaktivität.

LP6.2.3.1 Nachweis von Zerfallsprodukten in der Luft
Die Schülerinnen und Schüler untersuchen die Zerfallsprodukte von Radon. Für diesen Versuch benötigen Sie den Schub Science Lab Radioaktivität RA (207 152S)
VERSUCHSTHEMEN
LP6.2 UMWELTRADIOAKTIVITÄT
ERFORDERLICHE SCHÜBE
LP6.2.1 EINFÜHRUNG IN DIE RADIOAKTIVITÄT 29 VERSUCHE S. 142
LP6.2.2 UNTERSUCHUNG DES EINFLUSSES DER PROBENBESCHAFFENHEIT UND DER GRÖSSE DES MESSFENSTERS
LP6.2.3 UMWELTRADIOAKTIVITÄT
LP6.2.4 STATISTIK DES RADIOAKTIVEN ZERFALLS
LP6.2.5 ABSCHIRMUNG VON STRAHLUNG
LP6.2.6 ABSTAND
LP6.2.7 UNTERSUCHUNG DER STRAHLUNG IM MAGNETFELD
LP6.2.8 HALBWERTSZEIT

Umweltradioaktivität RA 207 152S

Die Schülerinnen und Schüler untersuchen, dass ein Magnetfeld ß-Strahlung ablenken kann. Für diesen Versuch benötigen Sie den Schub Science Lab Radioaktivität RA (207 152S)
Weitere Informationen zu unseren lehrplankonformen Themen und Schülerversuchen sowie die dazugehörigen Schübe finden Sie auf den nachfolgenden Seiten.
LP6.2.1 Einführung in die Radioaktivität
LP6.2.1.1
LP6.2.1.2
LP6.2.1.3
LP6.2.1.3C
LP6.2.1.4
LP6.2.1.5
LP6.2.1.5C
Nachweis radioaktiver Strahlung in der Umgebung
Nachweis radioaktiver Strahlung in der Umgebungsluft (Untergrund)
Nachweis radioaktiver Strahlung bei einem Knopfstrahler
Nachweis radioaktiver Strahlung bei einem Knopfstrahler (mit Mobile-CASSY 2 WLAN)
Sicherheitsregeln beim Umgang mit radioaktiven Materialien
Anzahl der Impulse N und Zählrate R
Anzahl der Impulse N und Zählrate R (mit Mobile-CASSY 2 WLAN)
LP6.2.2 Untersuchung des Einflusses der Probenbeschaffenheit und der Größe des Messfensters
LP6.2.2.1
LP6.2.2.2
LP6.2.2.3
Kaliumchlorid in unterschiedlichen Schichtdicken
Kaliumchlorid als Normal Zählrate bei Abschirmung des Eintrittsfensters
LP6.2.3 Umweltradioaktivität
LP6.2.3.1
LP6.2.3.1C
LP6.2.3.2
LP6.2.3.3
LP6.2.3.4
Nachweis von Zerfallsprodukten in der Luft
Nachweis von Zerfallsprodukten in der Luft (mit Mobile-CASSY 2 WLAN)
Nachweis von Zerfallsprodukten in frischem Leitungswasser
Nachweis von Zerfallsprodukten im Regenwasser
Nachweis von Zerfallsprodukten in frisch gefallenem Schnee
LP6.2.4 Statistik des radioaktiven Zerfalls
LP6.2.4.1
LP6.2.4.1C
LP6.2.4.2
LP6.2.4.3
Untersuchung der Schwankungen bei Messung der Anzahl der Impulse Untersuchung der Schwankungen bei Messung der Anzahl der Impulse Statistische Untersuchungen der Strahlung des Knopfstrahlers Statistische Untersuchungen der Strahlung des Kaliumchlorids
LP6.2.5 Abschirmung von Strahlung
LP6.2.5.1
LP6.2.5.1C
LP6.2.5.2
LP6.2.5.2C
Abschirmung der Strahlung des Knopfstrahlers durch unterschiedliche Materialien Abschirmung der Strahlung des Knopfstrahlers durch unterschiedliche Materialien (mit Mobile-CASSY 2 WLAN) Abschirmung der Strahlung des Knopfstrahlers durch unterschiedliche Materialdicken Abschirmung der Strahlung des Knopfstrahlers durch unterschiedliche Materialdicken (mit Mobile-CASSY 2 WLAN)
LP6.2.6 Abstand
LP6.2.6.1
LP6.2.6.1C Abhängigkeit der Zählrate vom Abstand zwischen Knopfstrahler und Zählrohr Abhängigkeit der Zählrate vom Abstand zwischen Knopfstrahler und Zählrohr (mit Mobile-CASSY 2 WLAN)
LP6.2.7 Untersuchung der Strahlung im Magnetfeld
LP6.2.7.1
LP6.2.7.1C
LP6.2.7.2
Einfluss eines Magneten auf β-Strahlung Einfluss eines Magneten auf β-Strahlung (mit Mobile-CASSY 2 WLAN) Nutzung des Einflusses eines Magneten auf β-Strahlung
LP6.2.8 Halbwertszeit
LP6.2.8.1 Auswertung einer Versuchsreihe mit Radonwasser

Nachweis radioaktiver Strahlung bei einem Knopfstrahler
ÜBERSICHT BENÖTIGTES MATERIAL

Kat.-Nr. Bezeichnung
207 152S Science Lab Radioaktivität RA (Satz)
Eine Auswahl der Literaturpakete finden Sie auf den nachfolgenden Seiten.



Schülerexperimentiersatz des Schülerversuche-Systems Science Lab im Bereich Physik. Aufbaumaterial für eine Arbeitsgruppe in gerätegeformter Aufbewahrung. Mit dem Gerätesatz RA können, in Verbindung mit dem Mobile-CASSY 2 WLAN (524 005W2) und GM-Adapter M (524 440) oder dem Zählgerät S (575 471), mehr als 25 Versuche in der S II durchgeführt werden.
Inhaltlich beschäftigen sich die Schülerinnen und Schüler mit dem Thema Radioaktivität und insbesondere mit der Umweltradioaktivität. Beim Bearbeiten der lehrplangeforderten Themen werden sie auch in den Kompetenzen Kommunikation und Bewertung geschult. Durch die zusätzliche Möglichkeit der Verwendung des Mobile-CASSY 2 WLAN wird den Schülern der Zugang zu digitalem Lernen ermöglicht.
Lieferumfang:
Menge Kat.-Nr. Bezeichnung
1 459 30 Plattenhalter auf Stiel
1 460 84 Präzisions-Metallschiene, 25 cm
4 460 95 Klemmreiter
1 510 20 Hufeisen-Magnet, klein
1 541 10 Reibholz und Kunststoffplatten
1 559 012 Großflächenzählrohr
1 559 014 Halter für Großflächenzählrohr
1 559 466 Halter für Präparat und Magnet
1 647 001 Geräteschub, niedrig
25 aus 661 0305 Rundfilter Glasfaser, 55 mm Ø, Satz 100
1 664 181 Petrischale 60 mm
1 665 1615 Büchnertrichter Porzellan, für Filter mit 55 mm Ø
2 aus 686 657 Kunststoff-Klammern, Spannweite 1,2 cm, Satz 3
1 686 666 Kaliumchlorid 50 g
1 686 667 Rahmen und Satz Al-Platten
207 152S Science Lab Radioaktivität RA (Satz)
Zusätzlich erforderlich:
Menge Kat.-Nr. Bezeichnung
1 520 715 LIT-digital: LP6 Science Lab Atom- und Kernphysik
1 524 005W2 Mobile-CASSY 2 WLAN
1 524 440 GM-Adapter M
1 559 460 Knopfstrahler
1 575 471* Zählgerät S
* alternativ
Zusätzlich empfohlen:
Menge Kat.-Nr. Bezeichnung
1 520 7151DE LIT-print: LP6.2 Umweltradioaktivität
1 520 71 LIT-digital: LP Science Lab Physik
1 647 003 Deckel zu Geräteschub
1 666 767 Heizplatte 1500 W, 180 mm Ø
1 ADACB501 Kompaktwaage 500 g : 0,1 g
1 LDS00001 Handstoppuhr, digital


n Nachweis aller relevanten Phänomene der Umweltradioaktivität
n ein Großflächenzählrohr mit stabilem Schutznetz gegen Beschädigung, welches die Messung geringer Zerfallsraten möglich macht, ist im Schub enthalten
n bei Verwendung dieses Schubs in Verbindung mit dem Knopfstrahler ist auch bei Einsatz im Klassensatz kein Strahlenschutzbeauftragter erforderlich
n der Knopfstrahler ist ein Freigrenzenpräparat (2,5 % der aktuellen Freigrenze, Stand 2017) ohne Bauartzulassung
n Geräte und detaillierte Anleitungen wurden in Zusammenarbeit mit Prof. Dr. phil. Henning von Philipsborn (Universität Regensburg) entwickelt
n Kompetenzerwerb: Kommunikation und Bewertung
SCHÜLERMESSGERÄT

SENSOREN

Mobile-CASSY 2 WLAN
Das universelle Schülermessgerät mit WLAN für alle Messaufgaben in der Physik, Chemie und Biologie.
524 005W2 Mobile-CASSY 2 WLAN
Detaillierte Informationen zum Mobile-CASSY 2 WLAN finden Sie im Internet unter www.leybold-shop.de/524005W2
GM-Adapter M
ERFORDERLICHE SENSOREN
Zur Messung radioaktiver Strahlung mit einem Geiger-Müller-Zählrohr (559 01 oder 559 012) mit dem MobileCASSY 2 (524 005W2).
524 440 GM-Adapter M
Detaillierte Informationen zu diesem und anderen Sensoren finden Sie im Internet unter www.leybold-shop.de.
Hier finden Sie eine Übersicht über unsere Literaturpakete.
Detaillierte Informationen zu unserer Literatur finden Sie im Internet unter www.leybold-shop.de.

FACHGEBIET

UNTERRICHTSFACH

ERGÄNZENDES

LIT-print: LP6.2 Umweltradioaktivität
Ausführliche Versuchsanleitungen zum Science Lab Schub RA (207 152S). Beschreibt 29 Versuche aus dem Thema Umweltradioaktivität.
Versuchsthemen:
Einführung in die Radioaktivität; Untersuchung des Einflusses der Probenbeschaffenheit und der Größe des Messfensters; Umweltradioaktivität; Statistik des radioaktiven Zerfalls; Abschirmung von Strahlung; Abstand; Untersuchung der Strahlung im Magnetfeld; Halbwertszeit
520 7151DE LIT-print: LP6.2 Umweltradioaktivität
LIT-digital: LP6 Science Lab Atom- und Kernphysik
Ausführliche Versuchsanleitungen zum Themengebiet Atom- und Kernphysik des Unterrichtsfachs Physik im Science Lab. Beschreibt ca. 29 Versuche zu dem Thema Umweltradioaktivität.
Enthält alle interaktiven Versuchsanleitungen (Lab Docs) als html-Datei.
520 715 LIT-digital: LP6 Science Lab Atom- und Kernphysik
LIT-digital: LP Science Lab Physik
Ausführliche Versuchsanleitungen zum Unterrichtsfach Physik im Science Lab. Beschreibt ca. 460 Versuche zu den Fachgebieten Mechanik, Energie, Elektrik und Elektronik, Optik, Atom- und Kernphysik sowie Informatik und Technik.
Enthält alle interaktiven Versuchsanleitungen (Lab Docs) als html-Datei.
520 71 LIT-digital: LP Science Lab Physik
Technische Daten der digitalen Version:
• Lieferung als Produktschlüssel (Aktivierung & Auswahl der Literatursprache über https://register.leylab.de notwendig)
• Systemvoraussetzungen:
Document Center:
PC mit Windows 7 oder höher; Internetzugang während der Installation; lokales Netzwerk zur Verteilung an die Schüler
Leylab:
- PC, Tablet oder Smartphone mit gängigem Browser; Internetzugang




Der Begriff „Radioaktivität“ erzeugt bei den meisten Menschen Unsicherheit und Befürchtungen, denn sie denken direkt an Nuklearkatastrophen. Deshalb ist es wichtig, dass Schüler und Schülerinnen ein differenziertes Bild bekommen und sie lernen, dass es eine natürliche Radioaktivität gibt, der wir uns im alltäglichen Leben nicht entziehen können und was diese bedeutet. Mit dem Schub RA lässt sich beispielsweise das radioaktive Radon in der Umgebungsluft sammeln, konzentrieren und nachweisen.
QUANTITATIVE EXPERIMENTE ZUR EIGENSCHAFT VON IONISIERENDER STRAHLUNG
n Knopfstrahler ermöglicht reproduzierbare und quantitative Experimente zu den grundlegenden Eigenschaften der radioaktiven Strahlung
n in Verbindung mit dem Großflächenzählrohr aus dem Schub RA sind alle Versuche trotz schwacher Aktivität durchführbar
n schnelle und einfache Durchführung der Versuchsthemen



n ein „Knopf“ aus urangefärbtem grünem Glas
n eingesetzt in eine Halterung
n Lieferung mit einem Zertifikat zur Bestätigung:
n maximale Aktivität von 250 Bq U-238
n kein Aktivität von Thorium oder Radium
n keine Ausbreitung der Aktivität in die Umwelt durch Einbettung des Urans in Glas
n leichte Handhabung im Unterricht
n Schutz gegen unbemerktes Entwenden
n der Knopfstrahler liegt weit unterhalb der Freigrenze (2,5 %)
n diese Strahler dürfen nach SrtlSchG im Unterricht ohne besonderen Aufwand (z. B. Fortbildung) eingesetzt werden
n durch die geringe Aktivität der radioaktiven Stoffe besteht keine Gefahr bei der Handhabung durch Ungeübte
Mikrocontroller sind in vielfältiger Art und Weise in unseren Alltag eingebunden. Unter anderem werden sie in Alltagsgeräten, wie Temperaturreglern, Alarmanlagen, Spielzeugen oder sogar im Bereich Smart Home eingesetzt. Im Science Lab Arduino sollen die Schülerinnen und Schüler spielerisch die faszinierende Welt der Technik entdecken und das Zusammenspiel zwischen Programmierung zu Elektronik erlernen. Nach einer Einführung in den Umgang mit Mikrocontrollern werden die Schülerinnen und Schüler anhand von Alltagsbeispielen sukzessive in die Programmierung eingeführt, um anschließend größere Projekte, z.B. im Bereich künstlicher Intelligenz realisieren zu können. Im Science Lab Arduino erlernen die Schülerinnen und Schüler, auf welche Art und Weise sich Aufgaben von einem Mikrocontroller übernehmen lassen.

LP8.1.3.1
Die Schülerinnen und Schüler werden sich in diesem Versuch mit Variablen und Operatoren auseinandersetzen, um ein digitales Thermometer zu programmieren, welches die Temperaturen in verschiedenen Temperaturskalen auf dem seriellen Monitor ausgeben soll. Für diesen Versuch benötigen Sie den Schub Science Lab Physik Arduino IT1 (207 161)
VERSUCHSTHEMEN
LP8.1.1 EINFÜHRUNG IN DIE PROGRAMMIERUNG VON MIKROCONTROLLERN 14
LP8.1.2 DATENTYPEN
LP8.1.3 VARIABLEN UND OPERATOREN
LP8.1.4 FEHLERANALYSE
LP8.1.5 KONTROLLSTRUKTUREN
LP8.1.6 KLEINERE PROJEKTE


Ultraschallsensor
Weitere Informationen zu unseren Themen und Schülerversuchen sowie die dazugehörigen Schübe finden Sie auf den nachfolgenden Seiten.
LP8.1.1 Einführung in die Programmierung von Mikrocontrollern
LP8.1.1.1
LP8.1.1.2
LP8.1.1.3 Die blinkende LED Hallo Welt Die Abstandsmessung
LP8.1.2 Datentypen
LP8.1.2.1
LP8.1.2.2 Die Temperaturmessung Der Lichtschalter
LP8.1.3 Variablen und Operatoren
LP8.1.3.1
LP8.1.3.2 Der Temperaturrechner Die Schrittmotorsteuerung
LP8.1.4 Fehleranalyse
LP8.1.4.1
LP8.1.4.2 Der Timer Die einfache Ampelschaltung
LP8.1.5 Kontrollstrukturen
LP8.1.5.1
LP8.1.5.2
LP8.1.5.3
LP8.1.5.4 Der automatische Rolladen Die Einparkhilfe Das SOS-Signal Die fußgängerabhängige Ampelschaltung
LP8.1.6 Kleinere Projekte
LP8.1.6.1 Die Helligkeitsregelung
Eintauchen in die Welt der Mikrocontroller-Programmierung
VERSUCHE
Das Erlernen von Programmierung mithilfe eines Mikrocontrollers ist eine äußerst wertvolle Fähigkeit, die Schülerinnen und Schülern zahlreiche Vorteile bietet. Diese Methode ermöglicht es, Schritt für Schritt in die Welt der Programmierung einzutauchen, indem sie sich auf Alltagsbeispiele und praktische Anwendungen stützt, wie sie in der Versucheliste aufgeführt sind.
Zu den Fertigkeiten, die im Rahmen der Experimente erlernt werden sollen, gehören:
Anwendungsorientiertes Lernen: Programmieren mit Mikrocontrollern ermöglicht es den Schülerinnen und Schülern, unmittelbare Ergebnisse und Erfahrungen zu erzielen. Sie können Programme schreiben, die echte Probleme lösen, wie das Steuern von Lichtern, Motoren oder Sensoren.
Förderung von Problemlösungskompetenzen: Die Schülerinnen und Schüler lernen, wie sie analytisch denken und komplexe Probleme in kleinere, leichter handhabbare Teilaufgaben zerlegen können.
Kreativität und Innovation: Die Programmierung eröffnet den Schülerinnen und Schülern die Möglichkeit, ihre kreativen Ideen in die Tat umzusetzen. Sie können eigene Projekte entwickeln und personalisierte Lösungen für spezifische Herausforderungen entwerfen.
Digitale Kompetenz: In einer zunehmend digitalisierten Welt ist das Verständnis von Programmierung und Mikrocontrollern von großer Bedeutung.
Vorbereitung auf die Zukunft: Programmierkenntnisse sind in vielen Berufen gefragt, sei es in der Informatik, Ingenieurwissenschaften, Robotik oder sogar in Bereichen wie Medizin und Kunst.

LP8.1.4.2
Die Schülerinnen und Schüler werden durch die systematische Analyse und Behebung von semantischen Fehlern eine funktionierende Ampelschaltung ohne zusätzlich Abhängigkeiten programmieren, durch das Ampelmodul testen und optimieren. Für diesen Versuch benötigen Sie den Schub Science Lab Physik Arduino IT1 (207 161)


Detaillierte Information zu diesen und weiteren zusätzlich erforderlichen Produkten finden Sie auf den nachfolgenden Seiten.


Schülerexperimentiersatz des Schülerversuche-Systems Science Lab im Bereich Technik. Aufbaumaterial für 4 Schüler/-innen in gerätegeformter Aufbewahrung. Mit dem Gerätesatz IT1 können mehr als 14 Versuche in der S I und S II durchgeführt werden. Inhaltlich beschäftigen sich die Schülerinnen und Schüler mit der Programmierung und dem Einsatz von Mikrocontrollern in Experimenten mit klarem Alltagsbezug. Beim Bearbeiten der lehrplangeforderten Themen werden sie auch in den Kompetenzen Kommunikation und Bewertung geschult.
Lieferumfang:
Menge Kat.-Nr. Bezeichnung
4 576 11 Arduino UNO R3 Mikrocontroller
1 576 12 OLED - 0.96" Display VGSS, I2C (4er Set)
1 576 13 Temperatursensor LM35 (4er Set)
1 576 14 Taster mit XH2.54 3P Buchse (4er Set)
1 576 15 Drehgeber CJMCU-111 (4er Set)
1 576 16 Schrittmotor 28BYJ-48 (4er Set)
1 576 17 3x4 Tastenfeld (4er Set)
1 576 18 Sensor Shield V 5.0 (4er Set)
1 576 19 Ultraschallsensor HC-SR04 (4er Set)
1 576 20 Ampelmodul 5 V (4er Set)
Menge Kat.-Nr. Bezeichnung
1 576 21 Passiver Buzzer KY-006 (4er Set)
1 576 22 Batterieklemme 9 V mit DC-Stecker (4er Set)
1 576 23 Fotowiderstand LDR 10 K (4er Set)
1 576 24 Breadboardkabel w/w 20 cm 40 Stk (4er Set)
1 576 25 Breadboardkabel m/w 20 cm 40 Stk (4er Set)
207 161 Science Lab Arduino IT1 (Satz)

Zusätzlich erforderlich pro Schüler:in
Menge Kat.-Nr. Artikelbezeichnung Bemerkung
1 685 45 Batterie 9 V (9-Volt-Block)
Zusätzlich erforderlich pro Klasse
Menge Kat.-Nr. Artikelbezeichnung Bemerkung
1 520 718 LIT-digital: LP8 Sience Lab Projekte Arduino
Geräteschub mit Materialien in 4-facher Ausführung
insgesamt 14 Experimente
sukzessive Einführung in die Programmierung von Mikrocontrollern
alltagsnahe Beispiele zur Vorbereitung auf größere Projekte
wenig Vorbereitung für die Lehrkraft nötig
LITERATURPAKETE
Hier finden Sie eine Übersicht über unsere Literaturpakete.
Detaillierte Informationen zu unserer Literatur finden Sie im Internet unter www.leybold-shop.de.
FACHGEBIET

UNTERRICHTSFACH

LIT-digital: LP8 Science Lab Projekte Arduino
Digitale Version EINES Fachgebiets
Ausführliche Versuchsanleitungen zu unserem Projekt Arduino im Unterrichtsfach Physik im Science Lab. Beschreibt mehr als 14 Versuche zu den Themen Steuern, Regeln und Programmierung von Mikrocontrollern.
Enthält alle interaktiven Versuchsanleitungen (Lab Docs) als html-Datei.
520 718 LIT-digital: LP8 Science Lab Projekte Arduino
LIT-digital: LP Science Lab Physik
Digitale Version ALLER Fachgebiete
Ausführliche Versuchsanleitungen zum Unterrichtsfach Physik im Science Lab. Beschreibt ca. 460 Versuche zu den Fachgebieten Mechanik, Energie, Elektrik und Elektronik, Optik, Atom- und Kernphysik sowie Informatik und Technik Enthält alle interaktiven Versuchsanleitungen (Lab Docs) als html-Datei.
520 71 LIT-digital: LP Science Lab Physik
Technische Daten der digitalen Version:
• Lieferung als Produktschlüssel (Aktivierung & Auswahl der Literatursprache über https://register.leylab.de notwendig)
• Systemvoraussetzungen:
Document Center:
PC mit Windows 7 oder höher; Internetzugang während der Installation; lokales Netzwerk zur Verteilung an die Schüler Leylab:
- PC, Tablet oder Smartphone mit gängigem Browser; Internetzugang





Detaillierte Informationen zum ergänzenden Aufbewahrungszubehör finden Sie im Internet unter
WAS IST EINE BLOCKWEISE AUFBEWAHUNG?
Schülerexperimentierblocks des Schülerversuche-Systems Science Lab im Bereich Physik. Aufbaumaterial für bis zu 16 Arbeitsgruppen in nach Geräten sortierter Aufbewahrung. Von 4 bis 16 Arbeitsgruppen verfügbar.
WIE FUNKTIONIERT UNSERE BLOCKWEISE AUFBEWAHRUNG?



Unsere Empfehlung:




2 - 3 Schülerinnen oder Schüler in einer Gruppe
Beispielsituation 1

2. Wie oft wird das Material benötigt?
BEISPIEL:
Klassenstärke: 20 Schüler Gruppenstärke: 2 Schüler Anzahl Gruppen: 10 10-fach



Die Klasse besteht aus 20 Schülerinnen und Schülern und möchte sich Science Lab Mechanik ME1 (207 111S) anschaffen. Der Science Lab Physik Basis-Schub PB (207 100S) wird ebenfalls benötigt.


20 : = 10

Beispielsituation 2
Die gleiche Klasse möchte zusätzlich Science Lab Mechanik ME2 (207 112S) anschaffen. Der Science Lab Physik Basis-Schub PB (207 100S) wird auch hier benötigt.


20 : = 10

Bezeichnung
*Der Basisschub muss nicht erneut angeschafft werden, da er bereits aus dem ersten Kauf 10 x für die Gruppenstärke vorhanden ist.
Detaillierte Informationen zu unserer satz- und blockweisen Aufbewahrung finden Sie auf den S. 8 + 9.





207
207
207
207
207




207
207
207
207






Kat.-Nr.
207
207
207
207
207 135xx Science Lab Elektrik EL5
207 136xx Science Lab Elektrik EL6




207
207
207


Hier finden Sie eine Gesamtübersicht über unsere Science Lab Schülerversuche aus dem Bereich der Chemie.


VERSUCHSTHEMEN
LEHRPLANTHEMEN
LC1.1 GRUNDVERFAHREN/TRENNVERFAHREN Eigenschaften von Stoffen; Stoffgemische; Stofftrennung
LC1.2 WASSER Wasser als Lösungsmittel; Analyse, Synthese und Nachweis von Wasser; Wasseraufbereitung
LC1.3 LUFT, GASE UND IHRE EIGENSCHAFTEN
LC1.4 SÄUREN UND LAUGEN
LC1.5 SALZE
LC1.6 METALLE
LC1.7 REDOXREAKTIONEN
LC1.8 CHEMISCHE REAKTIONEN
LC1.9 NEUE FELDER DER CHEMIE


VERSUCHSTHEMEN
LC2.1 ORGANISCHE STOFFE
LC2.2 KOHLENWASSERSTOFFE
LC2.3 ALKOHOLE, ALDEHYDE UND KETONE
LC2.4 CARBONSÄUREN UND ESTER


Gase - Herstellung und Nachweis und Eigenschaften; Luft und Verbrennung
Sauer und alkalisch; Säuren; Laugen; Protolysegleichgewicht; Titrationen; Neutralisation und Salzbildung
Ionennachweise; Verwendung von Salzen
Eigenschaften von Metallen; Verwendung von Metallen; Komplexchemie
Oxidation; Redoxtitration
Kennzeichen einer chemischen Reaktion; Chemische Gesetze
Nanochemie
Kennzeichen von organischen Stoffen; Elemente in organischen Stoffen
Gesättigte Kohlenwasserstoffe; Ungesättigte Kohlenwasserstoffe; Erdölchemie
Herstellung von Alkoholen; Alkoholnachweise; Eigenschaften und Verwendung von Alkoholen; Aldehyde; Ketone
Herstellung von Carbonsäuren; Eigenschaften und Verwendung von Carbonsäuren; Herstellung und Eigenschaften von Estern
LC2.5 REAKTIONEN DER ORGANISCHEN CHEMIE Additionsreaktionen; Substitutionsreaktionen
LC2.6 METHODEN DER ORGANISCHEN CHEMIE Destillationen
LC3.1 ELEKTROCHEMIE Elektrische Leitfähigkeit; Elektrochemische Potenziale; Galvanische Elemente; Angewandte Elektrochemie; Elektrolyse
LC3.2 PHYSIKALISCHE PROZESSE Teilchenbewegung
LC3.3 ENERGIE BEI CHEMISCHEN REAKTIONEN Kalorimetrie; Reaktionswärme
LC3.4 REAKTIONSGESCHWINDIGKEIT Verlauf einer Reaktion; Beeinflussung der Reaktionsgeschwindigkeit
LC3.5 DAS CHEMISCHE GLEICHGEWICHT Das chemische Gleichgewicht; Das Prinzip von Le Chatelier; Das Massenwirkungsgesetz und seine Andwendungen



VERSUCHSTHEMEN
LC4.1 BAUSTOFFE Kalk und Gips
LC4.2 GLAS Glas
LC4.3 METALLE Gewinnung von Metallen; Legierungen
LC4.4 CHEMISCHE ANWENDUNGEN Düngemittel; Fotografie
LC4.5 PRODUKTE DER ORGANISCHEN INDUSTRIE Farbstoffe; Kunststoffe; Seifen
VERSUCHSTHEMEN
LC5.1 FETTE
LC5.2 KOHLENHYDRATE
LEHRPLANTHEMEN
Eigenschaften von Fetten; Fetthaltige Lebensmittel; Untersuchung von Fetten
Eigenschaften von Kohlenhydraten; Gewinnung von Zuckern; Nachweis von Zuckern; Stärke und Zellulose
LC5.3 AMINOSÄUREN UND PROTEINE Eigenschaften von Proteinen; Nachweis von Proteinen
LC5.4 LEBENSMITTEL Konservierungsstoffe; Zusatzstoffe

VERSUCHSTHEMEN LEHRPLANTHEMEN
LC6.1 BRENNSTOFFZELLE Die reversible Brennstoffzelle; der Elektrolyseur; die Brennstoffzelle; das Solarmodul; Energienutzung
n Dieser Basis-Schub enthält die Grundgeräte für die Schülerversuche der Chemie, die immer wieder benötigt werden.
n Jedes Gerät hat seinen definierten Platz in der gerätegeformten Aufbewahrung.
n In Kombination mit den verschiedenen Themenschüben können zusammen mehr als 250 Schülerversuche in der S I und S II in der Chemie durchgeführt werden.
n Ein Basis-Schub für alle Themen in der Chemie und maximal 2 Schübe auf dem Schülerarbeitsplatz.
n In dem Basis-Schub befindet sich entsprechendes Aufbaumaterial für eine Arbeitsgruppebestehend aus 2-3 Schülern.
n Die Versuche aus dem Science Lab Chemie können dann themenabhängig mit einem weiteren Schub durchgeführt werden.
n Gleiche Geräte = immer wieder gleiche Handhabung: kein Neuerlernen für jedes Thema







Schülerexperimentiersatz des Schülerversuche-Systems Science Lab im Bereich Chemie. Grundgeräte für Versuche aus den Themen Allgemeine und Anorganische Chemie, Organische Chemie, Physikalische Chemie, Technische Chemie und Biochemie. Aufbaumaterial für eine Arbeitsgruppe in gerätegeformter Aufbewahrung. Die einzelnen Schübe sind stapelbar und können optional mit einem Deckel (647 003) verschlossen werden.
Der Gerätesatz Science Lab Chemie Basis CB ermöglicht es, in Kombination mit mindestens einem der folgenden Science Lab Chemie-Sätze, lehrplangeforderte Schülerversuche in der S I und S II durchzuführen:
• Gerätesatz Science Lab Anorganische Chemie AC 207 211S
• Gerätesatz Science Lab Organische Chemie OC 207 221S
• Gerätesatz Science Lab Physikalische Chemie PC 207 231S
• Gerätesatz Science Lab Technische und Biochemie TBC 207 241S
Lieferumfang:
Menge Kat.-Nr. Bezeichnung
2 301 09 Doppelmuffe S
2 301 21 Stativfuß MF
1 301 23 Stützfüße, Paar
3 301 271 Stativstange 40 cm, 10 mm Ø
1 309 45 Allschreibstift
1 382 33 Thermometer, -10...+150 °C/1 K
1 604 5682 Pulverspatel Edelstahl 185 mm
1 647 002 Geräteschub, hoch
1 661 035 Rundfilter Sorte 595, 125 mm Ø, Satz 100
1 661 091 Siedesteine 100 g
5 664 154 Uhrglas 80 mm Ø
3 665 212 Glasrührstab 200 mm x 8 mm Ø
1 665 754 Messzylinder 100 ml, Kunststofffuß
5 665 9531 Tropfpipette 150 mm x 7 mm Ø
5 665 9541 Pipettenhütchen
2 665 997 Messpipette 10 ml
1 666 003 Pipettierball (Peleusball)
2 666 555 Universalklemme 0...80 mm
1 666 943 Reagenzglasbürste mit Kopfbündel 20 mm Ø
1 667 017 Schere 125 mm, rund
1 667 018 Labormesser
1 667 027 Pinzette, vernickelt, stumpf, 130 mm
1 667 031 Reagenzglashalter Holz, 20 mm Ø
1 667 035 Tiegelzange 200 mm
1 667 057 Reagenzglasgestell Metall, 20 mm Ø
1 MA90204 Universalindikatorpapier pH 1...14, Rolle
Zusätzlich erforderlich:
Menge Kat.-Nr. Bezeichnung
1 207 211S Science Lab Anorganische Chemie AC (Satz)
1 207 221S* Science Lab Organische Chemie OC (Satz)
1 207 231S* Science Lab Physikalische Chemie PC (Satz)
1 207 241S* Science Lab Technische und Biochemie TBC (Satz)
* alternativ
Zusätzlich empfohlen:
Menge Kat.-Nr. Bezeichnung
1 647 003 Deckel zu Geräteschub

Mit der Versuchesammlung Allgemeine und Anorganische Chemie vermitteln Sie mühelos die Faszination am Fach Chemie: Die Schübe Anorganische Chemie AC1 + AC2 umfassen sowohl Geräte für Grundlagenversuche als auch für weiterführende Versuche, die für den Chemie-Unterricht der Sekundarstufen I und II von Bedeutung sind.
Dabei führen Ihre Schüler mit diesem Set sowohl phänomenologische Experimente, wie z. B. „Rotkohl als Indikator“, durch als auch komplexe Versuche wie Leitfähigkeits- oder Redoxtitrationen.

LC1.1.1.2C Siedetemperatur
In diesem Versuch werden die Siedetemperaturen von Wasser und Brennspiritus ermittelt. Dazu wird die Temperatur beim Erhitzen der jeweiligen Flüssigkeit mit Hilfe des Mobile-CASSY 2 WLAN in konstanten Zeitabständen gemessen. Die Wertepaare werden anschließend graphisch aufgetragen, um aus dem Kurvenverlauf die Siedetemperatur zu bestimmen. Für diesen Versuch benötigen Sie die Schübe Science Lab Chemie Basis CB (207 200S) und Science Lab Anorganische Chemie AC (207 211S)
VERSUCHSTHEMEN
LC1.1 GRUNDVERFAHREN/TRENNVERFAHREN
LC1.2 WASSER
LC1.3 LUFT, GASE UND IHRE EIGENSCHAFTEN
LC1.4 SÄUREN UND LAUGEN
LC1.5 SALZE
LC1.6 METALLE
LC1.7 REDOXREAKTIONEN
LC1.8 CHEMISCHE REAKTION
LC1.9 NEUE FELDER DER CHEMIE
ERFORDERLICHE SCHÜBE



LC1.4.1.5C pH-Papier versus pH-Elektrode
In diesem Versuch lernen die Schülerinnen und Schüler den pH-Wert von Lösungen einerseits mit dem pH-Papier zu bestimmen und andererseits mit dem Mobile-CASSY 2 WLAN und einer pH-Sonde zu messen. Für diesen Versuch benötigen Sie die Schübe Science Lab Chemie Basis CB (207 200S) und Science Lab Anorganische Chemie AC (207 211S)
Weitere Informationen zu unseren lehrplankonformen Themen und Schülerversuchen sowie die dazugehörigen Schübe finden Sie auf den nachfolgenden Seiten.
LC1.1 GRUNDVERFAHREN/TRENNVERFAHREN
LC1.1.1 Eigenschaften von Stoffen
LC1.1.1.1
LC1.1.1.2
LC1.1.1.2C
LC1.1.1.3
Dichte, Löslichkeit, Magnetisierbarkeit und Farbe
Siedetemperatur
Siedetemperatur (mit Mobile-CASSY 2 WLAN)
Sublimieren
LC1.1.2 Stoffgemische
LC1.1.2.1
LC1.1.2.2
LC1.1.2.3
LC1.1.2.4
Heterogene Gemische Homogene Gemische Vergleich verschiedener Lösungsmittel Lösungen, Kolloide und Suspensionen
LC1.1.3 Stofftrennung
LC1.1.3.1
LC1.1.3.2
LC1.1.3.3
LC1.1.3.4
LC1.1.3.5
LC1.1.3.6
LC1.1.3.7
LC1.1.3.8 Verdampfen Schlämmen und Dekantieren Ausschmelzen und Magnetscheidung Aufbereitung von Steinsalz zu Siedesalz Trennung nicht mischbarer Flüssigkeiten Extraktion
Stofftrennung durch Ausschütteln Chromatografie
LC1.2 WASSER
LC1.2.1 Wasser als Lösungsmittel
LC1.2.1.1
LC1.2.1.2
LC1.2.1.3
LC1.2.1.4C
LC1.2.1.5
Nachweis gelöster fester Stoffe in verschiedenen Wasserproben Nachweis gelöster Gase in Trinkwasser Gesamthärte des Wassers Gesättigte Lösungen (mit Mobile-CASSY 2 WLAN)
Beeinflussung des Lösungsvorgangs
LC1.2.2 Analyse, Synthese und Nachweis von Wasser
LC1.2.2.1
LC1.2.2.2 Wasserzerlegung und Wassersynthese Der chemische Wassernachweis
LC1.2.3 Wasseraufbereitung
LC1.2.3.1
LC1.2.3.2C Die Filtration mit Kies- und Aktivkohlefiltern
Der Sauerstoffgehalt von Wasser (mit Mobile-CASSY 2 WLAN)
LC1.3 LUFT, GASE UND IHRE EIGENSCHAFTEN
LC1.3.2 Gase - Herstellung, Nachweis und Eigenschaften
LC1.3.2.1
LC1.3.2.2
LC1.3.2.3
LC1.3.2.4
Sauerstoff - Darstellung, Nachweis und Eigenschaften Kohlenstoffdioxid - Darstellung, Nachweis und Eigenschaften
Der Kohlenstoffdioxid-Feuerlöscher Wasserstoff - Darstellung und Eigenschaften
LC1.3.3 Luft und Verbrennung
LC1.3.3.1
LC1.3.3.2
LC1.3.3.3
LC1.3.3.4
Die Funktionsweise des Brenners Bedeutung der Luft für die Verbrennungsvorgänge
Der Sauerstoffgehalt der Luft Herstellung von Holzkohle
LC1.4 SÄUREN UND LAUGEN
LC1.4.1 Sauer und Basisch
LC1.4.1.1
LC1.4.1.2
LC1.4.1.3
LC1.4.1.4
LC1.4.1.4C
LC1.4.1.5C
LC1.4.1.6
LC1.4.1.6C
Herstellung eines Indikators aus Rotkohl Wirkung von Säuren auf Indikatoren Wirkung von Laugen auf Indikatoren
Die pH-Skala
Die pH-Skala (mit Mobile-CASSY 2 WLAN)
pH-Papier versus pH-Elektrode (mit Mobile-CASSY 2 WLAN)
Der pH-Wert von Alltagschemikalien
Der pH-Wert von Alltagschemikalien (mit Mobile-CASSY 2 WLAN)
LC1.4.2 Säuren
LC1.4.2.1C
LC1.4.2.2
LC1.4.2.2C
Leitfähigkeit von starken und schwachen Säuren Schwefelsäure und ihre Eigenschaften Schwefelsäure und ihre Eigenschaften (mit Mobile-CASSY 2 WLAN)
LC1.4.3 Laugen
LC1.4.3.1
LC1.4.3.2
LC1.4.3.2C
LC1.4.3.3
LC1.4.3.4
LC1.4.3.5
Verwendung von Laugen im Alltag Die Reaktion von Hydroxiden mit Wasser Die Reaktion von Hydroxiden mit Wasser (mit Mobile-CASSY 2 WLAN) Die Reaktion von Alkali- und Erdalkalimetallen mit Wasser Die Reaktion von Metalloxiden mit Wasser Ammoniak als Lauge
LC1.4.4 Protolysegleichgewicht
LC1.4.4.1C
LC1.4.4.2
LC1.4.4.2C
LC1.4.4.3C
Die mehrstufige Protolyse der Phosphorsäure (mit Mobile-CASSY 2 WLAN)
Pufferlösungen
Pufferlösungen (mit Mobile-CASSY 2 WLAN)
Vom pH-Wert zum pKs-Wert (mit Mobile-CASSY 2 WLAN)
LC1.4.5 Titrationen
LC1.4.5.1
LC1.4.5.2
LC1.4.5.3
LC1.4.5.3C
LC1.4.5.4
LC1.4.5.4C
LC1.4.5.5C
LC1.4.5.6C Titration von Salzsäure mit Natronlauge Bestimmung des Gehalts an Essigsäure in Haushaltsessig Aufnahme einer Titrationskurve Aufnahme einer Titrationskurve (mit Mobile-CASSY 2 WLAN) Indikatorauswahl für eine Titration Indikatorauswahl für eine Titration (mit Mobile-CASSY 2 WLAN) Aminosäuren als Zwitterionen (mit Mobile-CASSY 2 WLAN) Die Leitfähigkeitstitration (mit Mobile-CASSY 2 WLAN)
LC1.4.6 Neutralisation und Salzbildung
LC1.4.6.1
LC1.4.6.2
LC1.4.6.3 Die Neutralisation Reaktion von Metallen mit Säuren Reaktion von Metalloxiden mit Säuren
LC1.5 SALZE
LC1.5.2 Ionennachweise
LC1.5.2.1
LC1.5.2.2
LC1.5.2.3
LC1.5.2.4
LC1.5.2.5
Nachweis von Carbonat-Ionen
Nachweis von Chlorid-Ionen
Nachweis von Sulfat-Ionen
Nachweis von Eisen-Ionen
Nachweis von Kupfer-Ionen
LC1.5.3 Verwendung von Salzen
LC1.5.3.1
LC1.5.3.1C
LC1.5.3.2
LC1.5.3.2C
Kristallzüchtung
Kristallzüchtung (mit Mobile-CASSY 2 WLAN) Kälte- und Wärmemischungen Kälte- und Wärmemischungen (mit Mobile-CASSY 2 WLAN)
LC1.6 METALLE
LC1.6.1 Eigenschaften von Metallen
LC1.6.1.1
LC1.6.1.2
LC1.6.1.3
LC1.6.1.4
LC1.6.1.5
Erhitzen von Metallen Der Kupferbrief-Versuch Verbrennung von Metallen Der Rostvorgang Die Flammenfärbung
LC1.6.2 Verwendung von Metallen
LC1.6.2.1
LC1.6.2.2
LC1.6.2.3
Rostschutz durch Verzinnen und Verzinken Wärmebehandlung von Stahl Der Silberspiegel
LC1.6.3 Komplexchemie
LC1.6.3.1 Ligandenaustausch bei Kupferkomplexen
LC1.7 REDOXREAKTIONEN
LC1.7.1 Oxidation
LC1.7.1.1
LC1.7.1.2
LC1.7.1.3
Die Reaktion von Metallen an der Luft
Die Ursache einer Oxidation Verbrennung von Metallen
LC1.7.2 Redoxtitration
LC1.7.2.1 Die Redoxtitration
LC1.8 CHEMISCHE REAKTIONEN
LC1.8.1 Kennzeichen einer chemischen Reaktion
LC1.8.1.1
LC1.8.1.2 Physikalischer Vorgang oder chemische Reaktion? Die Reaktion von Kupfer und Eisen mit Schwefel
LC1.8.2 Chemische Gesetze
LC1.8.2.1
LC1.8.2.2
Das Gesetz der Erhaltung der Masse Das Gesetz der konstanten Massenverhältnisse
LC1.9 NEUE FELDER DER CHEMIE
LC1.9.1 Nanochemie
LC1.9.1.1
LC1.9.1.2 Lösungen, Kolloide und Suspensionen Nanochemie des Kohlenstoffs
93 VERSUCHE

Erhitzen von Metallen



Literatur
Kat.-Nr. Bezeichnung
207 200S Science Lab Basis Chemie CB (Satz)
207 211S Science Lab Anorganische Chemie AC (Satz)
Eine Auswahl der Literaturpakete finden Sie auf den nachfolgenden Seiten.


Schülerexperimentiersatz des Schülerversuche-Systems Science Lab im Bereich Chemie. Aufbaumaterial für eine Arbeitsgruppe in gerätegeformter Aufbewahrung. Mit dem Gerätesatz AC können, zusammen mit dem Science Lab Chemie Basis CB (207 200S), mehr als 90 Versuche in der S I und S II durchgeführt werden. Das Science Lab Anorganische Chemie AC enthält zwei Schübe. Die Einzelgeräte sind so zugeordnet, dass die Schülerinnen und Schüler für die Versuche jeweils maximal 2 Schübe auf dem Platz stehen haben.
Inhaltlich beschäftigen sich die Schülerinnen und Schüler mit den Bereichen Allgemeine und Anorganische Chemie. Beim Bearbeiten der lehrplangeforderten Themen werden sie auch in den Kompetenzen Kommunikation und Bewertung geschult. In Verbindung mit dem Mobile-CASSY 2 WLAN (524 005W2) ergeben sich weitere Auswertemöglichkeiten, die digitales Lernen ermöglichen.
Lieferumfang:
Menge Kat.-Nr.
Bezeichnung
1 510 50 Stabmagnet
8 602 022 Becherglas Boro 3.3, 100 ml, nF
2 647 002 Geräteschub, hoch
1 662 093 Objektträger 76 mm x 26 mm x 1 mm, Satz 50 Stück
1 664 003 Schmelztiegel Porzellan 20 ml
16 664 0421 Reagenzglas Fiolax 16 mm x 160 mm
1 664 048 Reagenzglas Supremax 20 mm x 180 mm
2 664 131 Becherglas Boro 3.3, 400 ml, nF
1 664 1941 Pneumatische Wanne, Kunststoff
1 664 243 Erlenmeyerkolben 250 ml, eH, SB 29
1 664 441 Abdampfschale 60 mm Ø
2 665 009 Trichter PP, 75 mm Ø
1 665 073 Tropftrichter Glas, 75 ml, SB 29
1 665 230 Gaseinleitungsrohr, abgewinkelt, 8 mm Ø
1 665 232 Winkelrohr 90°, 50/50 mm, 8 mm Ø
1 665 235 Winkelrohr 90°, 300/50 mm, 8 mm Ø
1 665 238 Glasdüse 90°, 80 mm x 80 mm, 8 mm Ø
1 665 816 Büretteneinfülltrichter Kunststoff, 35 mm Ø
1 665 843 Bürette Klarglas, 10 ml, seitlicher Hahn
1 666 573 Stativring mit Stiel 100 mm Ø
1 666 685 Wärmeschutznetz 160 mm x 160 mm
1 666 688 Drahtdreieck mit Tonröhren 60 mm
1 667 091 Pistill 88 mm
1 667 092 Mörser Porzellan 70 mm Ø
1 667 180 Gummischlauch 7 mm Ø, 1 m
14 667 253 Gummistopfen voll, 14...18 mm Ø
1 667 260 Gummistopfen voll, 25...31 mm Ø
1 667 262 Gummistopfen 2 Löcher 7 mm, 25...31 mm Ø
1 667 286 Silikonstopfen 1 Loch 7 mm, 16...21 mm Ø
1 LDS00001 Handstoppuhr, digital
207 211S Science Lab Anorganische Chemie AC (Satz)
Zusätzlich erforderlich:
Menge Kat.-Nr. Bezeichnung
1 207 200S Science Lab Chemie Basis CB (Satz)
1 520 72 LIT-digital: LC Science Lab Chemie
1 607 020 Sicherheitsgasschlauch mit Endmuffe 0,5 m
2 610 010 Laborschutzbrille Focomax
1 661 243 Spritzflasche PE 500 ml
1 656 7031 Teclubrenner, Propan
1 667 609 Schutzhandschuhe, Nitrilkautschuk, Größe 8
1 675 3410 Wasser, rein, 5 l
1 679 210 Chemikalien Science Lab Anorganische Chemie
1 ADACB501 Kompaktwaage 500 g : 0,1 g
1 MA91201 Teststäbchen Gesamthärte
Zusätzlich empfohlen:
Menge Kat.-Nr. Bezeichnung
1 520 7211DE LIT-print: LC1 Allgemeine und Anorganische Chemie
1 524 005W2 Mobile-CASSY 2 WLAN
1 524 0671 Leitfähigkeits-Adapter S
1 524 0672 pH-Adapter S
1 529 670 Leitfähigkeits-Sensor
1 529 672 pH-Elektrode, BNC-Stecker
1 607 105 Magnetrührer Mini
2 647 003 Deckel zu Geräteschub
1 666 194 Schutzrohre für Temperaturfühler, Satz 5
1 666 851 Magnetrührstäbchen 25 mm x 6 mm Ø, zylindrisch
1 667 416 Redox-Einstabmesskette BNC
1 674 4630 Pufferlösung pH 10,00, 250 ml
1 674 4640 Pufferlösung pH 4,00, 250 ml
1 674 4670 Pufferlösung pH 7,00, 250 ml
1 ADAHCB123 Kompaktwaage 120 g: 0,001 g

n 2 Geräteschübe plus Basis-Schub für 93 Experimente
n modular aufbauend auf die Basisgeräte in Chemie Basis CB - von den insgesamt 3 Schüben werden pro Versuch nur 2 Schübe benötigt
n bei vorhandenem Laborspüler empfehlen wir unsere blockweise Aufbewahrung, da die gereinigten Glaswaren schneller gepackt werden können
n Chemikaliensatz für mindestens 10-malige Durchführung aller Versuche
n Abdeckung aller Anforderungsstufen
n leichter Einstieg in digitales Messen und Auswerten
SCHÜLERMESSGERÄT DIGITALER UNTERRICHT

SENSOREN

SENSOREN
Mobile-CASSY 2 WLAN
Das universelle Schülermessgerät mit WLAN für alle Messaufgaben in der Physik, Chemie und Biologie.
524 005W2 Mobile-CASSY 2 WLAN
Detaillierte Informationen zum Mobile-CASSY 2 WLAN finden Sie im Internet unter www.leybold-shop.de/524005W2
Temperaturfühler NiCr-Ni, schnell, Typ K
Bereits im Lieferumfang des Mobile-CASSY 2 WLAN (524 005W2) enthalten.


IM LIEFERUMFANG ENTHALTEN
Detaillierte Informationen zu diesem und anderen Sensoren finden Sie im Internet unter www.leybold-shop.de.
Leitfähigkeits-Sensor
EMPFOHLENE SENSOREN
Sensor in Vierleitertechnik mit integriertem Pt-Temperatursensor; zur Verwendung mit der Chemie-Box (524 067) oder dem Leitfähigkeits-Adaper S (524 0671) zusammen mit CASSY (524 013, 524 006, 524 005W2, 524 018) oder dem Universellen Messinstrument Chemie (531 836). Offener Aufbau für schnelle Reaktion auf Leitfähigkeitsänderungen. Bei Messungen ist ein Mindestabstand von der Behälterwand von 1 cm, sowie eine Mindesteintauchtiefe von 2 cm einzuhalten.
529 670 Leitfähigkeits-Sensor
Leitfähigkeits-Adapter S
Ermöglicht zusammen mit dem Leitfähigkeits-Sensor (529 670) die Messung der Leitfähigkeit und der Temperatur mit CASSY (524 013, 524 006, 524 005W2, 524 018) oder dem Universellen Messinstrument Chemie (531 836).
524 0671
Leitfähigkeits-Adapter S
Detaillierte Informationen zu diesen und anderen Sensoren finden Sie im Internet unter www.leybold-shop.de.


EMPFOHLENE SENSOREN
Ermöglicht den Anschluss einer pH-Elektrode an CASSY (524 013, 524 006, 524 005W2, 524 018) oder das Universelle Messinstrument Chemie (531 836). Zudem kann die Spannung an der BNC-Buchse sehr hochohmig gemessen werden, z.B. zur Messung elektrochemischer Potenziale.
pH-Kunststoffelektrode mit Kunststoffschaft und BNC-Stecker. Zur Verwendung mit der Chemie-Box (524 067) oder pH-Adapter S (524 0672) an CASSY (524 013, 524 006, 524 005W2, 524 018) oder dem Universellen Messinstrument Chemie (531 836). Wartungsarme pH-Elektrode mit Festelektrolyt aus einem leitenden gelartigen Polymer.
529 672
pH-Elektrode, BNC-Stecker Zur Lagerung wird 3 M KCl empfohlen (672 5250).
Detaillierte Informationen zu diesen und anderen Sensoren finden Sie im Internet unter www.leybold-shop.de.
Hier finden Sie eine Übersicht über unsere Literaturpakete. Detaillierte Informationen zu unserer Literatur finden Sie im Internet unter www.leybold-shop.de.
LIT-print: LC1 Allgemeine und Anorganische Chemie

UNTERRICHTSFACH

Ausführliche Versuchsanleitungen zum Science Lab Schub AC (207 211S) und Science Lab Chemie Basis CB (207 200S). Beschreibt 93 Versuche aus dem Fachgebiet Allgemeine und Anorganische Chemie.
Versuchsthemen: Grundverfahren/Trennverfahren; Wasser; Luft, Gase und ihre Eigenschaften; Säuren und Laugen; Salze; Metalle; Redoxreaktionen; Chemische Reaktion
520 7211DE LIT-print: LC1 Allgemeine und Anorganische Chemie
LIT-digital: LC Science Lab Chemie
Ausführliche Versuchsanleitungen zum Unterrichtsfach Chemie im Science Lab. Beschreibt mehr als 270 Versuche zu den Fachgebieten Anorganische Chemie, Organische Chemie, Physikalische Chemie, Technische Chemie und Biochemie und Brennstoffzelle. Enthält alle interaktiven Versuchsanleitungen (Lab Docs) als html-Datei.
520 72 LIT-digital: LC Science Lab Chemie
Technische Daten der digitalen Version:
• Lieferung als Produktschlüssel (Aktivierung & Auswahl der Literatursprache über https://register.leylab.de notwendig)
• Systemvoraussetzungen:
Document Center:
PC mit Windows 7 oder höher; Internetzugang während der Installation; lokales Netzwerk zur Verteilung an die Schüler
Leylab:
- PC, Tablet oder Smartphone mit gängigem Browser; Internetzugang






Chemikalien Science Lab Anorganische Chemie
Chemikalien zur Durchführung der Schülerversuche im Science Lab Anorganische Chemie. Der Chemikaliensatz enthält 87 verschiedene Chemikalien, mit denen man jeden Versuch mindestens 10 mal durchführen kann.
679 210
Chemikalien Science Lab Anorganische Chemie
Die einzelnen Chemikalien aus diesem Satz finden Sie im Internet unter www.leybold-shop.de. Dort erfahren Sie ebenfalls mehr über die entsprechenden Gefahrensymbole und -klassen, den sicheren Umgang mit Chemikalien sowie die Gefahren- und Sicherheitshinweise.
Zusätzlich erforderlich pro Schülerin oder Schüler
Zusätzlich erforderlich pro Klasse
675 3410 Wasser, rein, 5 l
679 210 Chemikaliensatz Anorganische Chemie
ADAHCB123 Kompaktwaage, 120 g : 0,001 g
MA91201 Teststäbchen Gesamthärte
Zusätzlich erforderlich pro Gruppe Kat.-Nr.
207 200S Science Lab Chemie Basis CB (Satz)
607 020 Sicherheitsgasschlauch mit Endmuffe, 0,5 m
661 243 Spritzflasche PE, 500 ml
656 7031 Teclubrenner, Propan
667 609 Schutzhandschuhe, Nitrilkautschuk, Größe 8
ADACB501 Kompaktwaage, 500 g : 0,1 g
Zusätzlich empfohlen pro Gruppe
524 005W2 Mobile-CASSY 2 WLAN
524 0671 Leitfähigkeits-Adapter S
524 0672 pH-Adapter S
529 670 Leitfähigkeits-Sensor
529 672 pH-Elektrode, BNC-Stecker
607 105 Magnetrührer Mini
647 003 Deckel zu Geräteschub
666 194 Schutzrohre für Temperaturfühler, Satz 5
666 851 Magnetrührstäbchen, 25 mm x 6 mm Ø, zylindrisch
667 416 Redox-Einstabmesskette, BNC
674 4630 Pufferlösung pH 10,00, 250 ml
674 4640 Pufferlösung pH 4,00, 250 ml
674 4670 Pufferlösung pH 7,00, 250 ml
Der Schub Science Lab Organische Chemie ist die optimale Gerätezusammenstellung zur experimentellen Vermittlung aller relevanten Themen der Organischen Chemie.
Profitieren Sie dabei von einem intelligenten Aufbausystem: Statt mit Schliffgeräten realisieren Ihre Schülerinnen und Schüler selbst aufwändige Aufbauten einfach mittels GL-Verschraubungen. So lässt sich erfolgreich auch in nur einer Schulstunde experimentieren. Die Bandbreite reicht dabei von Einstiegsversuchen zu den Eigenschaften organischer Stoffe bis hin zu Themen der Petrochemie.

LC2.1.2.1 Nachweis von Wasserstoff und Kohlenstoff
In diesem Versuch erbringen die Schülerinnen und Schüler den Nachweis, dass organische Stoffe aus Kohlenstoff und Wasserstoff bestehen. Dazu wird Harnstoff als Beispiel einer organischen Substanz mit Kupferoxid zusammen erhitzt. Dabei reagiert das Kupferoxid zu Kupfer. Die austretenden Gase werden in Calciumhydroxid-Lösung als CO2 nachgewiesen. Für diesen Versuch benötigen Sie die Schübe Science Lab Chemie Basis CB (207 200S) und Science Lab Organische Chemie OC (207 221S).
ORGANISCHE STOFFE
LC2.2 KOHLENWASSERSTOFFE
LC2.3 ALKOHOLE, ALDEHYDE UND KETONE
LC2.4 CARBONSÄUREN UND ESTER
LC2.5 REAKTIONEN DER ORGANISCHEN CHEMIE
LC2.6 METHODEN DER ORGANISCHEN CHEMIE



LC2.3.1.3C
Die Destillation ist ein klassisches Verfahren in der Chemie. In diesem Versuch wird aus Wein durch Destillation reinerer Alkohol isoliert. Für diesen Versuch benötigen Sie die Schübe Science Lab Chemie Basis CB (207 200S) und Science Lab Organische Chemie OC (207 221S).
Weitere Informationen zu unseren lehrplankonformen Themen und Schülerversuchen sowie die dazugehörigen Schübe finden Sie auf den nachfolgenden Seiten.
LC2.1 ORGANISCHE STOFFE
LC2.1.1 Kennzeichen von organischen Stoffen
LC2.1.1.1
LC2.1.1.2 Kennzeichen von organischen Stoffen
Das Verbrennungsgas organischer Stoffe
LC2.1.2 Elemente in organischen Stoffen
LC2.1.2.1
LC2.1.2.2 Nachweis von Wasserstoff und Kohlenstoff Nachweis von Sauerstoff
LC2.2 KOHLENWASSERSTOFFE
LC2.2.1 Gesättigte Kohlenwasserstoffe
LC2.2.1.1
LC2.2.1.2
LC2.2.1.3
LC2.2.1.4
Trockene Destillation der Kohle Eigenschaften von Propan Die Eigenschaften einiger Alkane Die Schmelztemperatur von Paraffin
LC2.2.2 Ungesättigte Kohlenwasserstoffe
LC2.2.2.1
LC2.2.2.2 Nachweis von Mehrfachbindungen Die Eigenschaften von Ethin
LC2.2.3 Erdölchemie
LC2.2.3.1
LC2.2.3.2
LC2.2.3.3
LC2.2.3.4
LC2.2.3.5
LC2.2.3.5C
LC2.3
Eigenschaften einzelner Erdölfraktionen Benzin als Lösemittel Katalytisches Cracken Untersuchung der Crackprodukte Herstellung von Biodiesel Herstellung von Biodiesel (mit Mobile-CASSY 2 WLAN)
LC2.3.1 Herstellung von Alkohlen
LC2.3.1.1
LC2.3.1.2
LC2.3.1.3
LC2.3.1.3C
Herstellung von „Holzgeist“ Die alkoholische Gärung Destillation von Wein Destillation von Wein (mit Mobile-CASSY 2 WLAN)
LC2.3.2 Alkoholnachweise
LC2.3.2.1
LC2.3.2.2
LC2.3.2.3
Unterscheidung von Methanol und Ethanol Die Iodoformprobe Nachweis von mehrwertigen Alkanolen
LC2.3.3 Eigenschaften und Verwendung von Alkoholen
LC2.3.3.1
LC2.3.3.2
LC2.3.3.3
LC2.3.3.4
LC2.3.3.4C
LC2.3.3.5 Ethanol als Lösemittel Entzündbarkeit eines Ethanol-Wasser-Gemisches Die Wasserlöslichkeit verschiedener Alkanole Isomere Alkanole und ihre Siedepunkte Isomere Alkanole und ihre Siedepunkte (mit Mobile-CASSY 2 WLAN) Die Oxidation von Alkoholen
LC2.3.4 Aldehyde
LC2.3.4.1
LC2.3.4.2 Die Tollensprobe Darstellung und Nachweis von Ethanal
LC2.3.5 Ketone
LC2.3.5.1
LC2.3.5.2 Darstellung von Alkanonen Eigenschaften und Verwendung von Aceton
LC2.4 CARBONSÄUREN UND ESTER
LC2.4.1 Herstellung von Carbonsäuren
LC2.4.1.1
LC2.4.1.2 Darstellung von Essigsäure durch Oxidation Darstellung von Weinessig
LC2.4.2 Eigenschaften & Verwendung von Carbonsäuren
LC2.4.2.1
LC2.4.2.2
LC2.4.2.3
Ameisensäure als Konservierungsmittel Eigenschaften von Ameisensäure und Essigsäure Eigenschaften und Verwendung der Weinsäure
LC2.4.3 Herstellung und Eigenschaften von Estern
LC2.4.3.1
LC2.4.3.2
LC2.4.3.3
LC2.4.3.4
LC2.4.3.5
LC2.4.3.5C
Ester der Essigsäure
Ester der Propansäure Ester der Benzoesäure Estersynthese als Gleichgewichtsreaktion
Alkalische Esterhydrolyse Alkalische Esterhydrolyse (mit Mobile-CASSY 2 WLAN)
LC2.5 REAKTIONEN DER ORGANISCHEN CHEMIE
LC2.5.1 Additionsreaktionen
LC2.5.1.1
LC2.5.1.2 Elektrophile Additionsreaktion
Nucleophile Addition an die Carbonylgruppe
LC2.5.2 Substitutionsreaktionen
LC2.5.2.1
LC2.5.2.2
LC2.5.2.2C
Nucleophile Substitutionreaktion
Radikalische Substitionsreaktion
Radikalische Substitionsreaktion (mit Mobile-CASSY 2 WLAN)
LC2.6 METHODEN DER ORGANISCHEN CHEMIE
LC2.6.1 Destillationen
LC2.6.1.1
LC2.6.1.1C
LC2.6.1.2
LC2.6.1.2C
Destillation von Cola
Destillation von Cola (mit Mobile-CASSY 2 WLAN)
Wasserdampfdestillation zur Gewinnung von Duftstoffen
Wasserdampfdestillation zur Gewinnung von Duftstoffen (mit Mobile-CASSY 2 WLAN)



Kat.-Nr. Bezeichnung
207 200S Science Lab Basis Chemie CB (Satz)
207 221S Science Lab Organische Chemie OC (Satz)
Eine Auswahl der Literaturpakete finden Sie auf den nachfolgenden Seiten.



Schülerexperimentiersatz des Schülerversuche-Systems Science Lab im Bereich Chemie. Aufbaumaterial für eine Arbeitsgruppe in gerätegeformter Aufbewahrung. Mit dem Gerätesatz OC können, zusammen mit dem Science Lab Chemie Basis CB (207 200S), mehr als 50 Versuche in der S I und S II durchgeführt werden.
Inhaltlich beschäftigen sich die Schülerinnen und Schüler mit dem Bereich Organische Chemie. Beim Bearbeiten der lehrplangeforderten Themen werden sie auch in den Kompetenzen Kommunikation und Bewertung geschult. In Verbindung mit dem Mobile-CASSY 2 WLAN (524 005W2) ergeben sich weitere Auswertemöglichkeiten, die digitales Lernen ermöglichen.
Lieferumfang:
Menge Kat.-Nr. Bezeichnung
2 602 022 Becherglas Boro 3.3, 100 ml, nF
1 603 021 Dosierspritze 50 ml
1 aus 603 032 Luer Kombistopfen rot, Satz 5
1 610 9522 Zweihals-Rundkolben Boro 3.3, 100 ml, GL 18
1 610 9640 Kühlmantel
1 647 002 Geräteschub, hoch
6 664 0421 Reagenzglas Fiolax 16 mm x 160 mm
1 664 048 Reagenzglas Supremax 20 mm x 180 mm
1 664 058 Reagenzglas mit seitl. Ansatz, Boro 3.3, 20 x 180 mm
1 664 079 Kupfer-Drahtnetzrolle 80 x 7,5 mm Ø
2 664 131 Becherglas Boro 3.3, 400 ml, nF
1 664 183 Petrischale, Glas, Ø 100 mm, Höhe 20 mm
1 664 243 Erlenmeyerkolben 250 ml, eH, SB 29
2 664 441 Abdampfschale 60 mm Ø
1 665 230 Gaseinleitungsrohr, abgewinkelt, 8 mm Ø
1 665 235 Winkelrohr 90°, 300/50 mm, 8 mm Ø
1 665 238 Glasdüse 90°, 80 mm x 80 mm, 8 mm Ø
1 665 643 Gärrohr 200 mm x 8 mm Ø
1 667 091 Pistill 88 mm
1 667 092 Mörser Porzellan 70 mm Ø
2 667 180 Gummischlauch 7 mm Ø, 1 m
5 667 253 Gummistopfen voll, 14...18 mm Ø
1 667 254 Gummistopfen 1 Loch 7 mm, 14...18 mm Ø
1 667 256 Gummistopfen 1 Loch 7 mm, 16...21 mm Ø
1 667 261 Gummistopfen 1 Loch 7 mm, 25...31 mm Ø
1 667 286 Silikonstopfen 1 Loch 7 mm, 16...21 mm Ø
1 667 304 Schraubkappe GL 18, oB 207 221S Science Lab Organische Chemie OC (Satz)
Zusätzlich erforderlich:
Menge Kat.-Nr. Bezeichnung
1 207 200S Science Lab Chemie Basis CB (Satz)
1 520 72 LIT-digital: LC Science Lab Chemie
1 607 020 Sicherheitsgasschlauch mit Endmuffe 0,5 m
2 610 010 Laborschutzbrille Focomax
1 661 243 Spritzflasche PE 500 ml
1 656 7031 Teclubrenner, Propan
1 667 609 Schutzhandschuhe, Nitrilkautschuk, Größe 8
1 674 9340 Steinkohle, Stücke, 100 g
1 675 3410 Wasser, rein, 5 l
1 679 220 Chemikalien Science Lab Organische Chemie
Zusätzlich empfohlen:
Menge Kat.-Nr. Bezeichnung
1 520 7221DE LIT-print: LC2 Organische Chemie
1 524 005W2 Mobile-CASSY 2 WLAN
1 524 0671 Leitfähigkeits-Adapter S
1 524 0672 pH-Adapter S
1 529 670 Leitfähigkeits-Sensor
1 529 672 pH-Elektrode, BNC-Stecker
1 647 003 Deckel zu Geräteschub
1 666 194 Schutzrohre für Temperaturfühler, Satz 5
1 666 839 Magnetrührer mit Heizplatte, rund
2 666 851 Magnetrührstäbchen 25 mm x 6 mm Ø, zylindrisch
1 674 4640 Pufferlösung pH 4,00, 250 ml
1 674 4670 Pufferlösung pH 7,00, 250 ml
1 ADACB501 Kompaktwaage 500 g : 0,1 g


n 1 Geräteschub plus Basis-Schub für 53 Experimente n GL-Verschraubungen statt Schliff-Verbindungen
n große Bandbreite an Versuchen: Grundlagen und Versuche für Fortgeschrittene n Chemikaliensatz für mindestens 10-malige Durchführung aller Versuche
SCHÜLERMESSGERÄT

SENSOREN

SENSOREN
DIGITALER UNTERRICHT
Das universelle Schülermessgerät mit WLAN für alle Messaufgaben in der Physik, Chemie und Biologie.
524 005W2 Mobile-CASSY 2 WLAN
Detaillierte Informationen zum Mobile-CASSY 2 WLAN finden Sie im Internet unter www.leybold-shop.de/524005W2
Temperaturfühler NiCr-Ni, schnell, Typ K
Bereits im Lieferumfang des Mobile-CASSY 2 WLAN (524 005W2) enthalten.
Detaillierte Informationen zu diesem und anderen Sensoren finden Sie im Internet unter www.leybold-shop.de.

Leitfähigkeits-Sensor
EMPFOHLENE SENSOREN
Sensor in Vierleitertechnik mit integriertem Pt-Temperatursensor; zur Verwendung mit der Chemie-Box (524 067) oder dem Leitfähigkeits-Adaper S (524 0671) zusammen mit CASSY (524 013, 524 006, 524 005W2, 524 018) oder dem Universellen Messinstrument Chemie (531 836). Offener Aufbau für schnelle Reaktion auf Leitfähigkeitsänderungen. Bei Messungen ist ein Mindestabstand von der Behälterwand von 1 cm, sowie eine Mindesteintauchtiefe von 2 cm einzuhalten.
529 670 Leitfähigkeits-Sensor

Leitfähigkeits-Adapter S
Ermöglicht zusammen mit dem Leitfähigkeits-Sensor (529 670) die Messung der Leitfähigkeit und der Temperatur mit CASSY (524 013, 524 006, 524 005W2, 524 018) oder dem Universellen Messinstrument Chemie (531 836).
524 0671 Leitfähigkeits-Adapter S
Detaillierte Informationen zu diesen und anderen Sensoren finden Sie im Internet unter www.leybold-shop.de.


EMPFOHLENE SENSOREN
Ermöglicht den Anschluss einer pH-Elektrode an CASSY (524 013, 524 006, 524 005W2, 524 018) oder das Universelle Messinstrument Chemie (531 836). Zudem kann die Spannung an der BNC-Buchse sehr hochohmig gemessen werden, z.B. zur Messung elektrochemischer Potenziale.
pH-Kunststoffelektrode mit Kunststoffschaft und BNC-Stecker. Zur Verwendung mit der Chemie-Box (524 067) oder pH-Adapter S (524 0672) an CASSY (524 013, 524 006, 524 005W2, 524 018) oder dem Universellen Messinstrument Chemie (531 836). Wartungsarme pH-Elektrode mit Festelektrolyt aus einem leitenden gelartigen Polymer.
529 672
pH-Elektrode, BNC-Stecker Zur Lagerung wird 3 M KCl empfohlen (672 5250).
Detaillierte Informationen zu diesen und anderen Sensoren finden Sie im Internet unter www.leybold-shop.de.
Hier finden Sie eine Übersicht über unsere Literaturpakete. Detaillierte Informationen zu unserer Literatur finden Sie im Internet unter www.leybold-shop.de.
LIT-print: LC2 Organische Chemie

UNTERRICHTSFACH

- PC, Tablet oder Smartphone mit gängigem Browser; Internetzugang THEMA FACHGEBIET
Gedruckte Version EINES Fachgebietes in einem Ringordner
Ausführliche Versuchsanleitungen zum Science Lab Schub OC (207 221S) und Science Lab Chemie Basis CB (207 200S). Beschreibt 53 Versuche aus dem Fachgebiet Organische Chemie.
Versuchsthemen: Organische Stoffe; Kohlenwasserstoffe; Alkohole, Aldehyde und Ketone; Carbonsäuren und Ester; Reaktionen der organischen Chemie; Methoden der organischen Chemie
520 7221DE LIT-print: LC2 Organische Chemie
LIT-digital:
Ausführliche Versuchsanleitungen zum Unterrichtsfach Chemie im Science Lab. Beschreibt mehr als 270 Versuche zu den Fachgebieten Anorganische Chemie, Organische Chemie, Physikalische Chemie, Technische Chemie und Biochemie und Brennstoffzelle. Enthält alle interaktiven Versuchsanleitungen (Lab Docs) als html-Datei.
520 72 LIT-digital: LC Science Lab Chemie
Technische Daten der digitalen Version:
• Lieferung als Produktschlüssel (Aktivierung & Auswahl der Literatursprache über https://register.leylab.de notwendig)
• Systemvoraussetzungen:
Document Center: PC mit Windows 7 oder höher; Internetzugang während der Installation; lokales Netzwerk zur Verteilung an die Schüler
Leylab:






Chemikalien Science Lab Organische Chemie
Chemikalien zur Durchführung der Schülerversuche im Science Lab Organische Chemie. Der Chemikaliensatz enthält 68 verschiedene Chemikalien, mit denen man jeden Versuch mindestens 10 mal durchführen kann.
679 220
Chemikalien Science Lab Organische Chemie
Die einzelnen Chemikalien aus diesem Satz finden Sie im Internet unter www.leybold-shop.de. Dort erfahren Sie ebenfalls mehr über die entsprechenden Gefahrensymbole und -klassen, den sicheren Umgang mit Chemikalien sowie die Gefahren- und Sicherheitshinweise.
Zusätzlich erforderlich pro Schülerin oder Schüler
Kat.-Nr.
010
Focomax
Zusätzlich erforderlich pro Klasse
679 220 Chemikaliensatz Organische Chemie
674 9340 Steinkohle, Stücke, 100 g
675 3410 Wasser, rein, 5 l
Zusätzlich erforderlich pro Gruppe
Kat.-Nr. Artikelbezeichnung
207 200S Science Lab Chemie Basis CB (Satz)
607 020 Sicherheitsgasschlauch mit Endmuffe, 0,5 m
661 243 Spritzflasche PE, 500 ml
656 7031 Teclubrenner, Propan
Zusätzlich empfohlen pro Gruppe
Kat.-Nr. Artikelbezeichnung Bemerkung
524 005W2 Mobile-CASSY 2 WLAN
524 0671 Leitfähigkeits-Adapter S
524 0672 pH-Adapter S
529 670 Leitfähigkeits-Sensor
529 672 pH-Elektrode, BNC-Stecker
647 003 Deckel zu Geräteschub
666 194 Schutzrohre für Temperaturfühler, Satz 5
666 839 Magnetrührer mit Heizplatte, rund
666 851 Magnetrührstäbchen, 25 mm x 6 mm Ø, zylindrisch
667 609 Schutzhandschuhe, Nitrilkautschuk, Größe 8
674 4640 Pufferlösung pH 4,00, 250 ml
674 4670 Pufferlösung pH 7,00, 250 ml
ADACB501 Kompaktwaage, 500 g : 0,1 g
Mit dem Science Lab Schub Physikalische Chemie begeistern Sie Ihre Schülerinnen und Schüler mit zentralen, der Chemie zugrunde liegenden Phänomenen. Sie vermitteln mit der Versuchsauswahl nicht nur eine tiefes Verständnis der Elektrochemie, sondern auch Basiskonzepte wie Reaktionsgeschwindigkeit, Energie chemischer Reaktionen oder Gleichgewichtskonzentrationen.
Dabei kommen langjährig bewährte Geräte zum Einsatz, wie etwa unser Zellblock zum Aufbau elektrochemischer Elemente, während mit dem Mobile-CASSY 2 WLAN gleichzeitig modernste Messtechnik verwendet wird.

LC3.3.1.1C Der Wasserwert eines Kalorimeters
In diesem Versuch bauen die Lernenden ein einfaches Kalorimeter und berechnen anhand einer Wassermischung die Wärmekapazität des eigenen Kalorimeters. Dies ist die Grundlage für folgende Kalorimetrie-Versuche. Für diesen Versuch benötigen Sie die Schübe Science Lab Chemie Basis CB (207 200S) und Science Lab Physikalische Chemie PC (207 231S).
Weitere Informationen zu unseren lehrplankonformen Themen und Schülerversuchen sowie die dazugehörigen Schübe finden Sie auf den nachfolgenden Seiten.
VERSUCHSTHEMEN
LC3.1 ELEKTROCHEMIE
LC3.2 PHYSIKALISCHE PROZESSE
LC3.3 ENERGIE BEI CHEMISCHEN REAKTIONEN
LC3.4 REAKTIONSGESCHWINDIGKEIT
LC3.5 DAS CHEMISCHE GLEICHGEWICHT



Bei diesem Experiment bauen die Schülerinnen und Schüler einen Zinkiodid-Akku auf und laden diesen im ersten Versuchsteil mittels Elektrolyse auf. Dieser Prozess lässt sich besonders gut beobachten, da in einer Halbzelle Iod entsteht und in der anderen Halbzelle Zink auf der Kohleelektrode abgeschieden wird. Anschließend wird das Entladen des Akkus untersucht, indem die Zellspannung und der Kurzschlussstrom mit dem Mobile-CASSY 2 WLAN gemessen werden. Für diesen Versuch benötigen Sie die Schübe Science Lab Chemie Basis CB (207 200S) und Science Lab Physikalische Chemie PC (207 231S).
LC3.1 ELEKTROCHEMIE
LC3.1.1 Elektrische Leitfähigkeit
LC3.1.1.1
LC3.1.1.2
LC3.1.1.3
Leiter und Nichtleiter
Die Leitfähigkeit von Flüssigkeiten und Lösungen
Die lonenwanderung
LC3.1.2 Elektrochemische Potentiale
LC3.1.2.1
LC3.1.2.2C
LC3.1.2.3C
LC3.1.2.4C
LC3.1.2.5C
LC3.1.2.6C
LC3.1.2.7C
LC3.1.2.8C
Die Redox-Reihe der Metalle
Erstellung einer Spannungsreihe (mit Mobile-CASSY 2 WLAN)
Erweiterung der Spannungsreihe (mit Mobile-CASSY 2 WLAN)
Die Standardpotenziale von Metallen (mit Mobile-CASSY 2 WLAN)
Die Standardpotenziale von Nichtmetallen (mit Mobile-CASSY 2 WLAN)
Die NERNST-Gleichung Teil I - Grundlagen (mit Mobile-CASSY 2 WLAN)
Die NERNST-Gleichung Teil II - Aufbau (mit Mobile-CASSY 2 WLAN)
Einflüsse auf die Spannung von Konzentrationsketten (mit Mobile-CASSY 2 WLAN)
LC3.1.3 Galvanische Elemente
LC3.1.3.1C
LC3.1.3.2C
LC3.1.3.3C
LC3.1.3.4C
LC3.1.3.5C
Das Volta-Element (mit Mobile-CASSY 2 WLAN)
Das DANIELL-Element (Aufbau) (mit Mobile-CASSY 2 WLAN)
Das DANIELL-Element (Reihenschaltung) (mit Mobile-CASSY 2 WLAN)
Der Zinkiodid-Akkumulator (mit Mobile-CASSY 2 WLAN)
Die Funktionsweise einer Brennstoffzelle (mit Mobile-CASSY 2 WLAN)
LC3.1.4 Angewandte Elektrochemie
LC3.1.4.1
LC3.1.4.2
LC3.1.4.3C
LC3.1.4.4
LC3.1.4.5
LC3.1.4.6C
LC3.1.4.7C
LC3.1.4.8C
Die Korrosion von Eisen
Der Korrosionsschutz von Eisen Galvanisieren (mit Mobile-CASSY 2 WLAN)
Elektrolytische Raffination von Kupfer Anodische Oxidation
Das Löslichkeitsprodukt (mit Mobile-CASSY 2 WLAN)
Die Dissoziationskonstante (mit Mobile-CASSY 2 WLAN)
Die Silber/Silberchlorid-Elektrode (mit Mobile-CASSY 2 WLAN)
LC3.1.5 Elektrolyse
LC3.1.5.1
LC3.1.5.2
LC3.1.5.3C
LC3.1.5.4C
LC3.1.5.5C Elektrolyse von Wasser Elektrolyse von Metallhalogenid-Lösungen
Das 1. Faradaysche Gesetz am Elektrolyseur (mit Mobile-CASSY 2 WLAN)
Das 2. Faradaysche Gesetz am Elektrolyseur (mit Mobile-CASSY 2 WLAN)
Bestimmung des Faraday-Wirkungsgrads eines Elektrolyseurs (mit Mobile-CASSY 2 WLAN)
LC3.2.1 Teilchenbewegung
LC3.2.1.1 Die Diffusion
LC3.3 ENERGIE BEI CHEMISCHEN REAKTIONEN
LC3.3.1 Kalorimetrie
LC3.3.1.1C
LC3.3.1.2C
LC3.3.1.3C
LC3.3.1.4C
Der Wasserwert eines Kalorimeters (mit Mobile-CASSY 2 WLAN)
Die Neutralisationsenthalpie (mit Mobile-CASSY 2 WLAN)
Die Lösungsenthalpie bei Salzen (mit Mobile-CASSY 2 WLAN)
Die Reaktionsenthalpie einer Redoxreaktion (mit Mobile-CASSY 2 WLAN)
LC3.3.2 Reaktionswärme
LC3.3.2.1C
LC3.3.2.2C
LC3.3.2.3C
LC3.3.2.4C
Die exotherme Reaktion (mit Mobile-CASSY 2 WLAN)
Die endotherme Reaktion (mit Mobile-CASSY 2 WLAN)
Der Satz von Hess (mit Mobile-CASSY 2 WLAN)
Eine spontan ablaufende, endotherme Reaktion (mit Mobile-CASSY 2 WLAN)
LC3.4 REAKTIONSGESCHWINDIGKEIT
LC3.4.1 Verlauf einer Reaktion
LC3.4.1.1C
LC3.4.1.2 Die Esterspaltung (mit Mobile-CASSY 2 WLAN)
Die Aktivierungsenergie
LC3.4.2 Beeinflussung der Reaktionsgeschwindigkeit
LC3.4.2.1
LC3.4.2.2
LC3.4.2.3
LC3.4.2.4
LC3.4.2.5
LC3.4.2.6
Die Temperaturabhängigkeit
Die Konzentrationsabhängigkeit Der Zerteilungsgrad Eine katalytische Reaktion
Anorganische und organische Katalysatoren Untersuchung der Enzymaktivität
LC3.5 DAS CHEMISCHE GLEICHGEWICHT
LC3.5.1 Das chemische Gleichgewicht
LC3.5.1.1
LC3.5.1.2 Das chemische Gleichgewicht Ligandenaustausch bei Kupferkomplexen
LC3.5.2 Das Prinzip von Le Chatelier
LC3.5.2.1C
LC3.5.2.2
LC3.5.2.3
Einfluss einer Temperaturänderung (mit Mobile-CASSY 2 WLAN)
Einfluss einer Konzentrationsänderung Einfluss einer Druckänderung
LC3.5.3 Das Massenwirkungsgesetz und seine Anwendungen
LC3.5.3.1
LC3.5.3.2C
LC3.5.3.3
LC3.5.3.4C Das Massenwirkungsgesetz Bestimmung der Gleichgewichtskonstante (mit Mobile-CASSY 2 WLAN) Das Löslichkeitsprodukt Die Dissoziationskonstante (mit Mobile-CASSY 2 WLAN)

Das DANIELL-Element (Aufbau)
ÜBERSICHT BENÖTIGTES MATERIAL


Kat.-Nr. Bezeichnung
207 200S Science Lab Basis Chemie CB (Satz)
207 231S Science Lab Physikalische Chemie PC (Satz)
Eine Auswahl der Literaturpakete finden Sie auf den nachfolgenden Seiten.



Schülerexperimentiersatz des Schülerversuche-Systems Science Lab im Bereich Chemie. Aufbaumaterial für eine Arbeitsgruppe in gerätegeformter Aufbewahrung. Mit dem Gerätesatz PC können, zusammen mit dem Science Lab Chemie Basis CB (207 200S), mehr als 50 Versuche in der S I und S II durchgeführt werden.
Inhaltlich beschäftigen sich die Schülerinnen und Schüler mit dem Bereich Physikalische Chemie und Elektrochemie. Beim Bearbeiten der lehrplangeforderten Themen werden sie auch in den Kompetenzen Kommunikation und Bewertung geschult. In Verbindung mit dem Mobile-CASSY 2 WLAN (524 005W2) ergeben sich weitere Auswertemöglichkeiten, die digitales Lernen ermöglichen.
Lieferumfang: Menge Kat.-Nr. Bezeichnung
2 501 45 Experimentierkabel 19 A, 50 cm, rot/blau, Paar
6 501 86 Krokodilklemme, blank
4 602 022 Becherglas Boro 3.3, 100 ml, nF
1 603 021 Dosierspritze 50 ml
1 aus 603 032 Luer Kombistopfen rot, Satz 5
4 aus 604 298 Kunststoffbecher, Satz 5
1 647 002 Geräteschub, hoch
5 664 0421 Reagenzglas Fiolax 16 mm x 160 mm
2 664 131 Becherglas Boro 3.3, 400 ml, nF
2 664 183 Petrischale, Glas, Ø 100 mm, Höhe 20 mm
1 664 3801 Kunststoffplättchen für Magnesiumelektrode
4 664 3821 Plattenelektrode Kupfer 43 x 28 mm
2 664 3831 Plattenelektrode Zink 43 x 28 mm
2 664 3851 Plattenelektrode Eisen 43 x 28 mm
3 664 3871 Plattenelektrode Kohle 43 x 28 mm
2 664 3891 Plattenelektrode Silber 43 x 28 mm
1 664 3901 Netzelektrode Platin 43 x 28 mm
1 664 391 Schmirgelstein
1 664 392 Papierdiaphragmen, 100 Stück
1 665 231 Winkelrohr 90°, 250/50 mm, 8 mm Ø
1 667 406 Verbraucher Elektrochemie
1 688 162 Zellblöcke mit Schale, Paar
1 LDS00001 Handstoppuhr, digital
207 231S Science Lab Physikalische Chemie PC (Satz)
Zusätzlich erforderlich:
Menge Kat.-Nr. Bezeichnung
1 207 200S Science Lab Chemie Basis CB (Satz)
1 520 72 LIT-digital: LC Science Lab Chemie
1 524 450 Elektrochemie-Box M
1 607 020 Sicherheitsgasschlauch mit Endmuffe 0,5 m
2 610 010 Laborschutzbrille Focomax
1 661 243 Spritzflasche PE 500 ml
1 656 7031 Teclubrenner, Propan
1 667 609 Schutzhandschuhe, Nitrilkautschuk, Größe 8
1 675 3410 Wasser, rein, 5 l
1 679 230 Chemikalien Science Lab Physikalische Chemie
1 ADACB501 Kompaktwaage 500 g : 0,1 g
Zusätzlich empfohlen:
Menge Kat.-Nr. Bezeichnung
1 520 7231DE LIT-print: LC3 Physikalische Chemie
1 521 491 AC/DC Netzgerät 0...12 V/3 A
1 524 005W2 Mobile-CASSY 2 WLAN
1 524 0671 Leitfähigkeits-Adapter S
1 524 0672 pH-Adapter S
1 529 670 Leitfähigkeits-Sensor
1 529 672 pH-Elektrode, BNC-Stecker
1 647 003 Deckel zu Geräteschub
1 666 194 Schutzrohre für Temperaturfühler, Satz 5
1 666 839 Magnetrührer mit Heizplatte, rund
1 666 851 Magnetrührstäbchen 25 mm x 6 mm Ø, zylindrisch
1 ADAHCB123 Kompaktwaage 120 g: 0,001 g


n 1 Geräteschub plus Basisschub für 55 Experimente
n Elektrochemie mit dem bewährten Zellblock: geringer Chemikalieneinsatz und gleichzeitiges Messen zwischen den einzelnen Zellen.
n digitales Messen (Temperatur, Spannung, Strom, Leifähigkeit)
n Experimentieren mit der multifunktionalen Elektrochemie-Box M, kein separates Netzgerät nötig
n quantitative Experimente für den fortgeschrittenen Chemie-Unterricht
n Chemikaliensatz für mindestens 10-malige Durchführung aller Versuche

SENSOREN

SENSOREN
Mobile-CASSY 2 WLAN
DIGITALER UNTERRICHT
Das universelle Schülermessgerät mit WLAN für alle Messaufgaben in der Physik, Chemie und Biologie.
524 005W2 Mobile-CASSY 2 WLAN
Detaillierte Informationen zum Mobile-CASSY 2 WLAN finden Sie im Internet unter www.leybold-shop.de/524005W2
Temperaturfühler NiCr-Ni, schnell, Typ K
Bereits im Lieferumfang des Mobile-CASSY 2 WLAN (524 005W2) enthalten.


IM LIEFERUMFANG ENTHALTEN
Detaillierte Informationen zu diesem und anderen Sensoren finden Sie im Internet unter www.leybold-shop.de.
Leitfähigkeits-Sensor
EMPFOHLENE SENSOREN
Sensor in Vierleitertechnik mit integriertem Pt-Temperatursensor; zur Verwendung mit der Chemie-Box (524 067) oder dem Leitfähigkeits-Adaper S (524 0671) zusammen mit CASSY (524 013, 524 006, 524 005W2, 524 018) oder dem Universellen Messinstrument Chemie (531 836). Offener Aufbau für schnelle Reaktion auf Leitfähigkeitsänderungen. Bei Messungen ist ein Mindestabstand von der Behälterwand von 1 cm, sowie eine Mindesteintauchtiefe von 2 cm einzuhalten.
529 670 Leitfähigkeits-Sensor
Leitfähigkeits-Adapter S
Ermöglicht zusammen mit dem Leitfähigkeits-Sensor (529 670) die Messung der Leitfähigkeit und der Temperatur mit CASSY (524 013, 524 006, 524 005W2, 524 018) oder dem Universellen Messinstrument Chemie (531 836).
524 0671
Leitfähigkeits-Adapter S
Detaillierte Informationen zu diesen und anderen Sensoren finden Sie im Internet unter www.leybold-shop.de.



Ermöglicht den Anschluss einer pH-Elektrode an CASSY (524 013, 524 006, 524 005W2, 524 018) oder das Universelle Messinstrument Chemie (531 836). Zudem kann die Spannung an der BNC-Buchse sehr hochohmig gemessen werden, z.B. zur Messung elektrochemischer Potenziale.
pH-Kunststoffelektrode mit Kunststoffschaft und BNC-Stecker. Zur Verwendung mit der Chemie-Box (524 067) oder pH-Adapter S (524 0672) an CASSY (524 013, 524 006, 524 005W2, 524 018) oder dem Universellen Messinstrument Chemie (531 836). Wartungsarme pH-Elektrode mit Festelektrolyt aus einem leitenden gelartigen Polymer.
529 672
pH-Elektrode, BNC-Stecker Zur Lagerung wird 3 M KCl empfohlen (672 5250).
Detaillierte Informationen zu diesen und anderen Sensoren finden Sie im Internet unter www.leybold-shop.de.
Elektrochemie-Box M
ERFORDERLICHE SENSOREN
Mobiles Stromversorgungsgerät für Experimente sowie Spannungs- und Strommessgerät in Verbindung mit dem Mobile-CASSY 2 WLAN (524 005W2). Zur Stromversorgung bis 300 mA sowie der intuitiven, parallelen Messung der elektrischen Spannung bis ±20 V und der Stromstärke bis ±2 A.
524 450 Elektrochemie-Box M
Detaillierte Informationen zu diesem und anderen Sensoren finden Sie im Internet unter www.leybold-shop.de.
Hier finden Sie eine Übersicht über unsere Literaturpakete. Detaillierte Informationen zu unserer Literatur finden Sie im Internet unter www.leybold-shop.de.
THEMA FACHGEBIET

UNTERRICHTSFACH

LIT-print: LC3 Physikalische Chemie
Gedruckte Version EINES Fachgebietes in einem Ringordner
Ausführliche Versuchsanleitungen zum Science Lab Schub PC (207 231S) und Science Lab Chemie Basis CB (207 200S). Beschreibt 55 Versuche aus dem Fachgebiet Physikalische Chemie.
Versuchsthemen:
Elektrochemie; Physikalische Prozesse; Energie bei chemischen Reaktionen; Reaktionsgeschwindigkeit; Das chemische Gleichgewicht
520 7231DE
LIT-print: LC3 Physikalische Chemie
LIT-digital: LC Science Lab
Ausführliche Versuchsanleitungen zum Unterrichtsfach Chemie im Science Lab. Beschreibt mehr als 270 Versuche zu den Fachgebieten Anorganische Chemie, Organische Chemie, Physikalische Chemie, Technische Chemie und Biochemie und Brennstoffzelle. Enthält alle interaktiven Versuchsanleitungen (Lab Docs) als html-Datei.
520 72 LIT-digital: LC Science Lab Chemie
Technische Daten der digitalen Version:
• Lieferung als Produktschlüssel (Aktivierung & Auswahl der Literatursprache über https://register.leylab.de notwendig)
• Systemvoraussetzungen:
Document Center: PC mit Windows 7 oder höher; Internetzugang während der Installation; lokales Netzwerk zur Verteilung an die Schüler
Leylab:
- PC, Tablet oder Smartphone mit gängigem Browser; Internetzugang

Chemikalien Science Lab Physikalische
Chemikalien zur Durchführung der Schülerversuche im Science Lab Physikalische und Elektrochemie. Der Chemikaliensatz enthält 57 verschiedene Chemikalien, mit denen man jeden Versuch mindestens 10 mal durchführen kann.
679 230
Chemikalien Science Lab Physikalische Chemie
Die einzelnen Chemikalien aus diesem Satz finden Sie im Internet unter www.leybold-shop.de. Dort erfahren Sie ebenfalls mehr über die entsprechenden Gefahrensymbole und -klassen, den sicheren U mgang mit Chemikalien sowie die Gefahren- und Sicherheitshinweise.
Zusätzlich erforderlich pro Schülerin oder Schüler
Kat.-Nr. Artikelbezeichnung
610 010 Laborschutzbrille Focomax
Zusätzlich erforderlich pro Klasse
Kat.-Nr. Artikelbezeichnung
679 230 Chemikaliensatz Physikalische Chemie
ADAHCB123 Kompaktwaage, 120 g : 0,001 g
675 3410 Wasser, rein, 5 l
Zusätzlich erforderlich pro Gruppe
Kat.-Nr. Artikelbezeichnung
ADACB501 Kompaktwaage, 500 g : 0,1 g
667 609 Schutzhandschuhe, Nitrilkautschuk, Größe 8
207 200S Science Lab Chemie Basis CB (Satz)
607 020 Sicherheitsgasschlauch mit Endmuffe, 0,5 m
661 243 Spritzflasche PE, 500 ml
656 7031 Teclubrenner, Propan
Zusätzlich empfohlen pro Gruppe
Kat.-Nr. Artikelbezeichnung
521 49 AC/DC-Netzgerät 0...12 V
647 003 Deckel zu Geräteschub
524 0671 Leitfähigkeits-Adapter S
529 670 Leitfähigkeits-Sensor
666 839 Magnetrührer mit Heizplatte, rund
666 851 Magnetrührstäbchen, 25 mm x 6 mm Ø, zylindrisch
524 005W2 Mobile-CASSY 2 WLAN
524 0672 pH-Adapter S
529 672 pH-Elektrode, BNC-Stecker
666 194 Schutzrohre für Temperaturfühler, Satz 5


Bemerkung
Bemerkung
Bemerkung



Mit den Versuchen des Science Lab Schubes Technische Chemie übertragen Ihre Schülerinnen und Schüler Grundlagenwissen auf ihren Alltag. So wenden sie zum Beispiel beim Thema Kalk und Gips das chemische Gleichgewicht an oder greifen beim Thema Farbstoffe auf Grundlagen der organischen Chemie zurück. Auch die Themen Metalle, Kunststoffe oder Seifen bieten einen direkten Alltagsbezug.
Die Biochemie ist als Grenzgebiet zwischen Chemie und Biologie für viele Schülerinnen und Schüler ein besonders mitreißender Fachbereich. Mit dem Science Lab Schub Technische und Biochemie werfen Sie einen Blick auf die Themen Fette, Kohlenhydrate und Proteine sowie auf deren Eigenschaften und geeignete Nachweisreaktionen. Zusätzlich können Sie Versuche zum Thema Lebensmittelchemie durchführen und so die Anwendung chemischer Kenntnisse auf Alltagsthemen üben.
Der Schub Technische und Biochemie beinhaltet Versuche zu den Themen Technische Chemie und Biochemie, die einzeln ausgewählt werden können.

Weichmacher können die Eigenschaften eines Kunststoffs ändern. In diesem Versuch werden zwei Folien aus Stärke hergestellt, wobei eine mit Glycerin als Weichmacher versetzt wird. Beide Folien werden miteinander verglichen. Für diesen Versuch benötigen Sie die Schübe Science Lab Chemie Basis CB (207 200S) und Science Lab Technische und Biochemie TBC (207 241S).
VERSUCHSTHEMEN TECHNISCHE CHEMIE
LC4.1 BAUSTOFFE
LC4.2 GLAS
LC4.3 METALLE
LC4.4 CHEMISCHE ANWENDUNGEN
LC4.5 PRODUKTE DER ORGANISCHEN INDUSTRIE
VERSUCHSTHEMEN BIOCHEMIE
LC5.1 FETTE
LC5.2 KOHLENHYDRATE
LC5.3 AMINOSÄUREN UND PROTEINE
LC5.4 LEBENSMITTEL



Fette sind immer Gemische aus mehreren Triglyceriden. Der Schmelzpunkt oder Schmelzbereich gibt Auskunft über die Zusammensetzung eines Fettes. Für diesen Versuch benötigen Sie die Schübe Science Lab Chemie Basis CB (207 200S) und Science Lab Technische und Biochemie TBC (207 241S).
Weitere Informationen zu unseren lehrplankonformen Themen und Schülerversuchen sowie die dazugehörigen Schübe finden Sie auf den nachfolgenden Seiten.
LC4.1 BAUSTOFFE
LC4.1.1 Kalk und Gips
LC4.1.1.1
LC4.1.1.2
LC4.1.1.3
LC4.1.1.4
LC4.1.1.4C
Brennen von Kalk Löschen von Kalk Abbinden von Kalk Abbinden von Gips Abbinden von Gips (mit Mobile-CASSY 2 WLAN)
LC4.2 GLAS
LC4.2.1 Glas
LC4.2.1.1 Herstellung von Kalknatronglas
LC4.3 METALLE
LC4.3.1 Gewinnung von Metallen
LC4.3.1.1 Die Verhüttung oxidischer Erze
LC4.3.2 Legierungen
LC4.3.2.1
LC4.3.2.2 Herstellung von Bronze Herstellung von Messing
LC4.4 CHEMISCHE ANWENDUNGEN
LC4.4.1 Düngemittel
LC4.4.1.1 Herstellung von Ammoniumsulfat
LC4.4.2 Fotografie
LC4.4.2.1 Die fotochemische Reaktion
LC4.5 PRODUKTE DER ORGANISCHEN INDUSTRIE
LC4.5.1 Farbstoffe
LC4.5.1.1
LC4.5.1.2
LC4.5.1.3
LC4.5.1.4
LC4.5.1.5
Molekülstruktur und Farbigkeit Synthese von Orange II Isolieren von Lebensmittelfarbstoffen
Herstellung von Indigo und die Küpenfärbung Das Phänomen der Fluoreszenz
LC4.5.2 Kunststoffe
LC4.5.2.1
LC4.5.2.2
LC4.5.2.3
LC4.5.2.4
LC4.5.2.5
Die Eigenschaften verschiedener Kunststoffe Die Polykondensation zur Kunststoffherstellung Eigenschaften von Kunststoff beeinflussen Recycling durch Pyrolyse Silikone und Carbonfasern als moderne Werkstoffe
LC4.5.3 Seifen
LC4.5.3.1
LC4.5.3.2
LC4.5.3.3
Herstellung durch Laugenverseifung Herstellung nach dem Carbonatverfahren Seife als Emulgator
LC5.1.1 Eigenschaften von Fetten
LC5.1.1.1
LC5.1.1.2
LC5.1.1.2C
LC5.1.1.3
LC5.1.1.3C
Die Löslichkeit
Der Schmelz- und Erstarrungspunkt
Der Schmelz- und Erstarrungspunkt (mit Mobile-CASSY 2 WLAN) Der Siedepunkt Der Siedepunkt (mit Mobile-CASSY 2 WLAN)
LC5.1.2 Fetthaltige Lebensmittel
LC5.1.2.1
LC5.1.2.2
LC5.1.2.2C
Ausschmelzen von tierischen Fetten Extraktion pflanzlicher Fette Extraktion pflanzlicher Fette (mit Mobile-CASSY 2 WLAN)
LC5.1.3 Untersuchung von Fetten
LC5.1.3.1
LC5.1.3.2
LC5.1.3.2C Fettnachweise Nachweis ungesättigter Fettsäuren Nachweis ungesättigter Fettsäuren (mit Mobile-CASSY 2 WLAN)
LC5.2 KOHLENHYDRATE
LC5.2.1 Eigenschaften von Kohlenhydraten
LC5.2.1.1
LC5.2.1.2
LC5.2.1.2C
Bestandteile der Kohlenhydrate Löslichkeit der Kohlenhydrate Löslichkeit der Kohlenhydrate (mit Mobile-CASSY 2 WLAN)
LC5.2.2 Gewinnung von Zuckern
LC5.2.2.1 Isolation und Nachweis von Milchzucker
LC5.2.3 Nachweis von Zuckern
LC5.2.3.1
LC5.2.3.3
LC5.2.3.4
LC5.2.3.5
Nachweis von Glucose und Fructose Die Seliwanow-Reaktion Das Blue-Bottle-Experiment Die Bausteine der Saccharose
LC5.2.4 Stärke und Zellulose
LC5.2.4.1
LC5.2.4.2
LC5.2.4.3
Die Bausteine der Stärke Der Stärkenachweis Der Cellulosenachweis
LC5.3 AMINOSÄUREN UND PROTEINE
LC5.3.1 Eigenschaften von Proteinen
LC5.3.1.1
LC5.3.1.2
LC5.3.1.3
LC5.3.1.5
Herstellung einer Eiklarlösung Eigenschaften von Proteinen Die Zusammensetzung von Proteinen Der isoelektrische Punkt von Aminosäuren
LC5.3.2 Nachweis von Proteinen
LC5.3.2.1
LC5.3.2.2 Die Biuret-Reaktion Der Nachweis mit Teststäbchen
LC5.4 LEBENSMITTEL
LC5.4.1 Konservierungsstoffe
LC5.4.1.1
LC5.4.1.2 Nachweis von Vitamin C Konservierung mit Benzoesäure und Sorbinsäure
LC5.4.2 Zusatzstoffe
LC5.4.2.1
LC5.4.2.2 Isolation von Lebensmittelfarben Die Zusammensetzung von Backpulver

Herstellung von Indigo und die Küpenfärbung
ÜBERSICHT BENÖTIGTES MATERIAL


Kat.-Nr. Bezeichnung
207 200S Science Lab Basis Chemie CB (Satz)
207 241S Science Lab Technische und Biochemie TBC (Satz)
Eine Auswahl der Literaturpakete finden Sie auf den nachfolgenden Seiten.



Schülerexperimentiersatz des Schülerversuche-Systems Science Lab im Bereich Chemie. Aufbaumaterial für eine Arbeitsgruppe in gerätegeformter Aufbewahrung. Mit dem Gerätesatz TBC können, zusammen mit dem Science Lab Chemie Basis CB (207 200S), mehr als 50 Versuche in der S I und S II durchgeführt werden.
Inhaltlich beschäftigen sich die Schülerinnen und Schüler mit den Bereichen Technische Chemie und/oder Biochemie. Beim Bearbeiten der lehrplangeforderten Themen werden sie auch in den Kompetenzen Kommunikation und Bewertung geschult. In Verbindung mit dem Mobile-CASSY 2 WLAN (524 005W2) ergeben sich weitere Auswertemöglichkeiten, die digitales Lernen ermöglichen.
Lieferumfang:
3 602 022 Becherglas Boro 3.3, 100 ml, nF
4 aus 604 298 Kunststoffbecher, Satz 5
1 647 002 Geräteschub, hoch
1 664 003 Schmelztiegel Porzellan 20 ml
6 664 0421 Reagenzglas Fiolax 16 mm x 160 mm
1 664 048 Reagenzglas Supremax 20 mm x 180 mm
2 664 131 Becherglas Boro 3.3, 400 ml, nF
2 664 183 Petrischale, Glas, Ø 100 mm, Höhe 20 mm
1 664 243 Erlenmeyerkolben 250 ml, eH, SB 29
1 664 391 Schmirgelstein
2 664 441 Abdampfschale 60 mm Ø
1 665 009 Trichter PP, 75 mm Ø
1 665 235 Winkelrohr 90°, 300/50 mm, 8 mm Ø
1 666 573 Stativring mit Stiel 100 mm Ø
1 666 685 Wärmeschutznetz 160 mm x 160 mm
1 667 091 Pistill 88 mm
1 667 092 Mörser Porzellan 70 mm Ø
4 667 253 Gummistopfen voll, 14...18 mm Ø
1 667 260 Gummistopfen voll, 25...31 mm Ø
1 667 286 Silikonstopfen 1 Loch 7 mm, 16...21 mm Ø
241S Science Lab Technische und Biochemie TBC (Satz)

Zusätzlich erforderlich:
Menge Kat.-Nr. Bezeichnung
1 207 200S Science Lab Chemie Basis CB (Satz)
1 520 72 LIT-digital: LC Science Lab Chemie
1 607 020 Sicherheitsgasschlauch mit Endmuffe 0,5 m
2 610 010 Laborschutzbrille Focomax
1 661 080 Kobaltchloridpapier 2 x 7 cm, 100 Streifen
1 656 7031 Teclubrenner, Propan
1 667 609 Schutzhandschuhe, Nitrilkautschuk, Größe 8
1 670 2230 Albustix-Teststäbchen, 50 St
1 670 9430 Blei(II)-acetat-Papier, 1 Heft
1 672 1150 Glucose-Teststreifen, 50 St.
1 675 3410 Wasser, rein, 5 l
1 679 240 Chemikalien Science Lab Technische Chemie
1 ADACB501 Kompaktwaage 500 g : 0,1 g
1 MA91314 Teststäbchen Ascorbinsäure
1 679 250* Chemikalien Science Lab Biochemie
* alternativ
Zusätzlich empfohlen:
Menge Kat.-Nr. Bezeichnung
1 520 7241DE LIT-print: LC4 Technische Chemie
1 520 7251DE LIT-print: LC5 Biochemie
1 524 005W2 Mobile-CASSY 2 WLAN
1 647 003 Deckel zu Geräteschub
1 665 6351 Analysenlampe (UV)
1 666 194 Schutzrohre für Temperaturfühler, Satz 5
1 666 839 Magnetrührer mit Heizplatte, rund
1 666 851 Magnetrührstäbchen 25 mm x 6 mm Ø, zylindrisch
1 ADAHCB123 Kompaktwaage 120 g : 0,001 g


n 1 Geräteschub plus Basisschub für 24 Experimente in der Technischen Chemie und 32 Experimente in der Biochemie
n Alltagsthematiken auch für Projekt- und Wahlunterricht geeignet
n Chemikaliensatz für mindestens 10-malige Durchführung aller Versuche
n Sie haben die Wahl: Versuche zu TC oder BC oder beiden Themen
SCHÜLERMESSGERÄT

SENSOREN

Mobile-CASSY 2 WLAN
DIGITALER UNTERRICHT
Das universelle Schülermessgerät mit WLAN für alle Messaufgaben in der Physik, Chemie und Biologie.
524 005W2 Mobile-CASSY 2 WLAN
Detaillierte Informationen zum Mobile-CASSY 2 WLAN finden Sie im Internet unter www.leybold-shop.de/524005W2
Temperaturfühler NiCr-Ni, schnell, Typ K
Bereits im Lieferumfang des Mobile-CASSY 2 WLAN (524 005W2) enthalten.
MOBILE-CASSY 2 WLAN
IM LIEFERUMFANG ENTHALTEN
Detaillierte Informationen zu diesem und anderen Sensoren finden Sie im Internet unter www.leybold-shop.de.

AUSWERTEMÖGLICHKEITEN
Mit dem Mobile-CASSY 2 WLAN kann direkt über 4-mm-Sicherheitsbuchsen Spannung (U), Stromstärke (I), Leistung (P) und Energie (E) gemessen werden.
Hier finden Sie eine Übersicht über unsere Literaturpakete.
Detaillierte Informationen zu unserer Literatur finden Sie im Internet unter www.leybold-shop.de.
LIT-print: LC4 Technische Chemie

UNTERRICHTSFACH

Gedruckte Version EINES Fachgebietes in einem Ringordner
- PC, Tablet oder Smartphone mit gängigem Browser; Internetzugang THEMA FACHGEBIET
Ausführliche Versuchsanleitungen zum Science Lab Schub TBC (207 241S) und Science Lab Chemie Basis CB (207 200S). Beschreibt 24 Versuche aus dem Fachgebiet Technische Chemie.
Versuchsthemen:
Baustoffe; Glas; Metalle; Chemische Anwendungen; Produkte der organischen Industrie
520 7241DE LIT-print: LC4 Technische Chemie
LIT-print: LC5 Biochemie
Gedruckte Version EINES Fachgebietes in einem Ringordner
Ausführliche Versuchsanleitungen zum Science Lab Schub TBC (207 241S) und Science Lab Chemie Basis CB (207 200S). Beschreibt 32 Versuche aus dem Fachgebiet Biochemie.
Versuchsthemen: Fette; Kohlenhydrate; Aminosäuren und Proteine; Lebensmittel
520 7251DE LIT-print: LC5 Biochemie
LIT-digital: LC Science Lab Chemie
Digitale Version ALLER Fachgebiete
Ausführliche Versuchsanleitungen zum Unterrichtsfach Chemie im Science Lab. Beschreibt mehr als 270 Versuche zu den Fachgebieten Anorganische Chemie, Organische Chemie, Physikalische Chemie, Technische Chemie und Biochemie und Brennstoffzelle.
Enthält alle interaktiven Versuchsanleitungen (Lab Docs) als html-Datei.
520 72 LIT-digital: LC Science Lab Chemie
Technische Daten der digitalen Version:
• Lieferung als Produktschlüssel (Aktivierung & Auswahl der Literatursprache über https://register.leylab.de notwendig)
• Systemvoraussetzungen:
Document Center: PC mit Windows 7 oder höher; Internetzugang während der Installation; lokales Netzwerk zur Verteilung an die Schüler
Leylab:






Chemikalien Science Lab Technische Chemie
Chemikalien zur Durchführung der Schülerversuche im Science Lab Technische Chemie. Der Chemikaliensatz enthält 40 verschiedene Chemikalien, mit denen man jeden Versuch mindestens 10 mal durchführen kann.
679 240
Chemikalien Science Lab Technische Chemie
Chemikalien Science Lab Biochemie
Chemikalien zur Durchführung der Schülerversuche im Science Lab Biochemie. Der Chemikaliensatz enthält 37 verschiedene Chemikalien, mit denen man jeden Versuch mindestens 10 mal durchführen kann.
679 250
Chemikalien Science Lab Biochemie
Die einzelnen Chemikalien aus diesen Sätzen finden Sie im Internet unter www.leybold-shop.de. Dort erfahren Sie ebenfalls mehr über die entsprechenden Gefahrensymbole und -klassen, den sicheren Umgang mit Chemikalien sowie die Gefahren- und Sicherheitshinweise.
Zusätzlich erforderlich pro Schülerin oder Schüler
Kat.-Nr. Artikelbzeichnung
610 010 Laborschutzbrille Focomax
Zusätzlich erforderlich pro Klasse
Kat.-Nr. Artikelbzeichnung
661 080 Kobaltchloridpapier 2 x 7 cm
665 635 Analysenlampe
670 240 Chemikaliensatz Technische Chemie
670 9430 Bleiacetat-Papier
670 2230 Protein-Teststäbchen
672 1150 Glucose-Teststreifen, 50 St.
675 3410 Wasser, rein, 5 l
679 250 Chemikaliensatz Biochemie
ADAHCB123 Kompaktwaage, 120 g : 0,001 g
MA91314 Teststäbchen Ascorbinsäure
Zusätzlich erforderlich pro Gruppe
Kat.-Nr. Artikelbzeichnung
207 200S Science Lab Chemie Basis CB (Satz)
607 020 Sicherheitsgasschlauch mit Endmuffe, 0,5 m
656 7031 Teclubrenner, Propan
666 839 Magnetrührer mit Heizplatte, rund
666 851 Magnetrührstäbchen, 25 mm x 6 mm Ø, zylindrisch
667 609 Schutzhandschuhe, Nitrilkautschuk, Größe 8
ADACB501 Kompaktwaage, 500 g : 0,1 g
Zusätzlich empfohlen pro Gruppe
Kat.-Nr. Artikelbzeichnung
647 003 Deckel zu Geräteschub
524 005W2 Mobile-CASSY 2 WLAN
Bemerkung
Technische Chemie + Biochemie
Bemerkung
Biochemie
Technische Chemie
Technische Chemie
Biochemie
Biochemie
Biochemie
Technische Chemie + Biochemie
Biochemie
Technische Chemie
Biochemie
Bemerkung
Technische Chemie + Biochemie
Technische Chemie + Biochemie
Technische Chemie + Biochemie
Technische Chemie + Biochemie
Technische Chemie + Biochemie
Technische Chemie + Biochemie
Technische Chemie + Biochemie
Bemerkung
Technische Chemie
Technische Chemie + Biochemie
666 194 Schutzrohre für Temperaturfühler, Satz 5 Technische Chemie
Das Thema erneuerbare Energien ist so aktuell wie nie zuvor. Mit unserem Schub Science Lab Brennstoffzelle beschäftigen sich die Schülerinnen und Schüler mit der Funktion und Verwendung der Brennstoffzelle. Sie setzen sich zudem mit der elektrolytischen Erzeugung von Wasserstoff und der damit verbundenen Nutzung von Solarenergie auseinander.
Durch Verwenden des Verbrauchers erfahren sie die Wirkung des erzeugten Stroms qualitativ und sehr anschaulich. Zusammen mit dem Mobile-CASSY 2 WLAN und der Elektrochemie-Box M lassen sich die Experimente zudem quantitativ auswerten, um beispielsweise Wirkungsgrade zu berechnen.
Mit dem Schub Science Lab Brennstoffzelle sind Ihre Schülerinnen und Schüler in der Lage, dem aktuellen Diskurs zur Brennstoffzellentechnologie zu folgen und Vor- und Nachteile zu diskutieren.

LC6.1.3.1C Betreiben der Brennstoffzelle
Die Schülerinnen und Schüler untersuchen in diesem Experiment die prinzipielle Funktionsweise einer reversiblen Brennstoffzelle. Diese wird zunächst als Elektrolyseur betrieben und der produzierte Wasserstoff anschließend als Treibstoff der Brennstoffzelle verwendet, um einen Propellermotor zu betreiben. Dabei wird die Spannung gemessen und der Wasserstoffverbrauch untersucht. Für diesen Versuch benötigen Sie den Schub Science Lab Chemie Brennstoffzelle BZ (207 261S)
VERSUCHSTHEMEN
LC6.1.1 DIE REVERSIBLE BRENNSTOFFZELLE 13 VERSUCHE S. 194
LC6.1.2 DER ELEKTROLYSEUR
LC6.1.3 DIE BRENNSTOFFZELLE
LC6.1.4 DAS SOLARMODUL
Brennstoffzelle BZ


Die Schülerinnen und Schüler untersuchen in diesem Experiment an einer reversiblen PEM-Brennstoffzelle den Zusammenhang zwischen abgeschiedener Menge Wasserstoff, Elektrolysezeit und Stromstärke. Daraus wird das 1. Faradaysche Gesetz abgeleitet. Für diesen Versuch benötigen Sie den Schub Science Lab Chemie Brennstoffzelle BZ (207 261S)
Weitere Informationen zu unseren lehrplankonformen Themen und Schülerversuchen sowie die dazugehörigen Schübe finden Sie auf den nachfolgenden Seiten.
Sensoren
LC6.1 BRENNSTOFFZELLE
LC6.1.1 Die reversible Brennstoffzelle
LB6.1.1.1C Handhabung der reversiblen Brennstoffzelle (mit Mobile-CASSY 2 WLAN)
LC6.1.2 Der Elektrolyseur
LB6.1.2.1C
LB6.1.2.2C
LB6.1.2.3C
LB6.1.2.4C
LB6.1.2.5C
Betreiben des Elektrolyseurs (mit Mobile-CASSY 2 WLAN)
Das 1. Faradaysche Gesetz am Elektrolyseur (mit Mobile-CASSY 2 WLAN)
Das 2. Faradaysche Gesetz am Elektrolyseur (mit Mobile-CASSY 2 WLAN)
Bestimmung des Faraday-Wirkungsgrads des Elektrolyseurs (mit Mobile-CASSY 2 WLAN)
Bestimmung des Energie-Wirkungsgrads des Elektrolyseurs (mit Mobile-CASSY 2 WLAN)
LC6.1.3 Die Brennstoffzelle
LB6.1.3.1C
LB6.1.3.2C
LB6.1.3.3C
Betreiben der Brennstoffzelle (mit Mobile-CASSY 2 WLAN)
Der Wirkungsgrad einer Brennstoffzelle (mit Mobile-CASSY 2 WLAN)
Reihen- und Parallelschaltung von zwei Brennstoffzellen (mit Mobile-CASSY 2 WLAN)
LC6.1.4 Das Solarmodul
LB6.1.4.1C
LB6.1.4.2C
LB6.1.4.3C
LB6.1.4.4C
Elektrochemie-Box M
Eigenschaften des Solarmoduls (mit Mobile-CASSY 2 WLAN)
Das Solarmodul bei verschiedenen Beleuchtungsstärken (mit Mobile-CASSY 2 WLAN)
Das Solarmodul bei verschiedenen Einstrahlwinkeln (mit Mobile-CASSY 2 WLAN)
Das Solarmodul als Diode (mit Mobile-CASSY 2 WLAN)

LC6.1.4.2C Das Solarmodul bei verschiedenen Beleuchtungsstärken
Die Schülerinnen und Schüler untersuchen in diesem Experiment an einem Solarmodul den Zusammenhang zwischen dem Kurzschlussstrom und der Beleuchtungsstärke. Für diesen Versuch benötigen Sie den Schub Science Lab Chemie Brennstoffzelle BZ (207 261S)
ÜBERSICHT BENÖTIGTES MATERIAL UM EXPERIMENTE DURCHZUFÜHREN
LC6.1 Brennstoffzelle



Detaillierte Information zu diesen und weiteren zusätzlich erforderlichen Produkten finden Sie auf den nachfolgenden Seiten.


Schülerexperimentiersatz des Schülerversuche-Systems Science Lab im Bereich Chemie. Aufbaumaterial für eine Arbeitsgruppe in gerätegeformter Aufbewahrung. Mit dem Gerätesatz BZ können Schülerversuche aus dem Bereich der Solarenergie und der Brennstoffzellentechnologie in der S II durchgeführt werden.
Inhaltlich beschäftigen sich die Schülerinnen und Schüler mit der Nutzung von Sonnenenergie zur Stromerzeugung, mit der Speicherung von Energie in Form von Wasserstoffgas und mit deren Nutzung durch eine Brennstoffzelle. Beim Bearbeiten der lehrplangeforderten Themen werden sie auch in den Kompetenzen Kommunikation und Bewertung geschult. In Verbindung mit dem Mobile-CASSY 2 WLAN (524 005W2) ergeben sich weitere Auswertemöglichkeiten, die digitales Lernen ermöglichen.
Lieferumfang:
Menge Kat.-Nr. Bezeichnung
1 456 110 Lichtquelle 12 V
1 456 210 H2+O2 Speicher
1 457 330 Solarmodul 1,5 V/420 mA
1 500 421 Experimentierkabel 19 A, 50 cm, rot
1 500 422 Experimentierkabel 19 A, 50 cm, blau
1 aus 505 08 Glühlampe 12 V/3 W, E10, Satz 10
1 562 791 Steckernetzgerät (Netzteil) 12 V AC
1 571 247 Kabel 2-mm-Stecker, 30 cm, schwarz
1 571 248 Kabel 2-mm-Stecker, 30 cm, rot
Menge Kat.-Nr. Bezeichnung
2 571 260 Adapterkabel 2-/4-mm, 30 cm, blau
2 571 262 Adapterkabel 2-/4-mm, 30 cm, rot
1 647 001 Geräteschub, niedrig
1 667 4012 Grundplatte f. Brennstoffzelle
1 667 4044 Reversible PEM-Brennstoffzelle
1 667 406 Verbraucher Elektrochemie
207 261S Science Lab Brennstoffzelle BZ (Satz)

Zusätzlich erforderlich pro Schüler:in
Menge Kat.-Nr. Artikelbezeichnung
1 610 010 Laborschutzbrille
Zusätzlich erforderlich pro Arbeitsgruppe
Bemerkung
Menge Kat.-Nr. Artikelbezeichnung Bemerkung
1 311 78 Rollbandmaß
1 500 422 Experimentierkabel 19 A, 50 cm, blau
1 524 005W2 Mobile-CASSY 2 WLAN für Experimente mit digitaler Messwerterfassung
1 524 450 Elektrochemie-Box M
Zusätzlich erforderlich pro Klasse
Menge Kat.-Nr. Artikelbezeichnung
1 520 72 LIT-digital: LC Science Lab Chemie
1 675 3410 Wasser, rein, 5 l
n Geräteschub für 13 Experimente
n mit der Elektrochemie-Box M ist keine separate Strom- und Spannungsquelle notwendig
n die reversible Brennstoffzelle kann als Brennstoffzelle und Elektrolyseur verwendet werden n der Elektrolyseur erzeugt den benötigten Wasserstoff: keine separate Wasserstoffquelle notwendig
SCHÜLERMESSGERÄT

SENSOREN

SENSOREN

Mobile-CASSY 2 WLAN
DIGITALER UNTERRICHT
Das universelle Schülermessgerät mit WLAN für alle Messaufgaben in der Physik, Chemie und Biologie.
524 005W2 Mobile-CASSY 2 WLAN
Detaillierte Informationen zum Mobile-CASSY 2 WLAN finden Sie im Internet unter www.leybold-shop.de/524005W2.
Temperaturfühler NiCr-Ni, schnell, Typ K
Bereits im Lieferumfang des Mobile-CASSY 2 WLAN (524 005W2) enthalten.
IM LIEFERUMFANG ENTHALTEN
Detaillierte Informationen zu diesem und anderen Sensoren finden Sie im Internet unter www.leybold-shop.de.
Elektrochemie-Box M
Mobile Stromquelle für Experimente sowie Spannungs- und Strommessgerät in Verbindung mit dem Mobile-CASSY 2 (524 005W2). Zur Stromversorgung bis 300 mA sowie der intuitiven, parallelen Messung der elektrischen Spannung bis ±20 V und der Stromstärke bis ±2 A.
524 450 Electrochemie-Box M
Detaillierte Informationen zu diesem und anderen Sensoren finden Sie im Internet unter www.leybold-shop.de.
Hier finden Sie eine Übersicht über unsere Literaturpakete.
Detaillierte Informationen zu unserer Literatur finden Sie im Internet unter www.leybold-shop.de.
FACHGEBIET

UNTERRICHTSFACH

LIT-print: LC6.1 Brennstoffzelle
Gedruckte Version EINES Fachgebietes in einem Ringordner
Ausführliche Versuchsanleitungen zum Science Lab Brennstoffzelle BZ (207 261S). Beschreibt 13 Versuche rund um die Themen Brennstoffzelle, Solarenergie und Elekrolyse.
Versuchsthemen: Die reversible Brennstoffzelle; Der Elektrolyseur; Die Brennstoffzelle; Das Solarmodul 520 7261DE LIT-print: LC6.1 Brennstoffzelle
LIT-digital: LB Science Lab Chemie
Ausführliche Versuchsanleitungen zum Unterrichtsfach Chemie im Science Lab. Beschreibt mehr als 270 Versuche zu den Fachgebieten Anorganische Chemie, Organische Chemie, Physikalische Chemie, Technische Chemie und Biochemie und Brennstoffzelle.
Enthält alle interaktiven Versuchsanleitungen (Lab Docs) als html-Datei.
520 72 LIT:-digital: LB Science Lab Chemie
Technische Daten der digitalen Version:
• Lieferung als Produktschlüssel (Aktivierung & Auswahl der Literatursprache über https://register.leylab.de notwendig)
• Systemvoraussetzungen: Document Center: PC mit Windows 7 oder höher; Internetzugang während der Installation; lokales Netzwerk zur Verteilung an die Schüler Leylab:
- PC, Tablet oder Smartphone mit gängigem Browser; Internetzugang






Bei der Brennstoffzelle handelt es sich um ein Gerät, welches die chemische Energie eines Brennstoffs in elektrische Energie umwandelt. Häufig meint man mit „Brennstoffzelle“ die WasserstoffSauerstoff-Brennstoffzelle, bei der Wasserstoff mit Sauerstoff zu Wasser reagiert und die frei werdende Reaktionsenergie nutzbar gemacht wird.
Dabei muss der Brennstoff der Brennstoffzelle kontinuierlich zugeführt werden, so dass es sich hier nicht um einen Energiespeicher handelt.

Das Verständnis dieser Aspekte rund um das Thema Brennstoffzelle ist aktuell wichtiger als je zuvor, um die Chancen und Grenzen der Brennstoffzellentechnologie im Energiemix der Gegenwart und Zukunft verstehen zu können. Dabei finden Brennstoffzellen heutzutage zum Beispiel bei der Hausenergieversorgung, in emissionsarmen Flurförderfahrzeugen oder in Autos und Bussen Anwendung.

In der aktuellen Diskussion um erneuerbare Energien spielt die Brennstoffzelle auch deshalb eine Rolle, weil Wasserstoff sich durch Elektrolyse aus Wasser gewinnen lässt, indem man Sonnenenergie als Energielieferant für den Prozess verwendet.
Zudem entsteht bei der Reaktion als Reaktionsprodukt lediglich Wasser und keine umweltgefährdenden Abfallprodukte, wie z. B. bei der Verbrennung fossiler Energieträger.
Eine Besonderheit unter den Brennstoffzellen ist die reversible Brennstoffzelle. Sie ist in der Lage den Prozess der Stromerzeugung umzukehren und durch Elektrolyse von Wasser den für den Verbrennungsprozess benötigten Wasser- und Sauerstoff zu erzeugen.

WAS IST EINE BLOCKWEISE AUFBEWAHUNG?
Schülerexperimentierblocks des Schülerversuche-Systems Science Lab im Bereich Chemie. Aufbaumaterial für bis zu 16 Arbeitsgruppen in nach Geräten sortierter Aufbewahrung.
Von 4 bis 16 Arbeitsgruppen verfügbar.
WIE FUNKTIONIERT UNSERE BLOCKWEISE AUFBEWAHRUNG?



Unsere Empfehlung:




2 - 3 Schülerinnen oder Schüler in einer Gruppe

BEISPIEL:
Klassenstärke: 20 Schüler
Gruppenstärke: 2 Schüler
Anzahl Gruppen: 10 10-fach



Die Klasse besteht aus 20 Schülerinnen und Schülern und möchte sich Science Lab Anorganische Chemie AC (207 211S) anschaffen. Der Science Lab Chemie Basis-Schub CB (207 200S) wird ebenfalls benötigt.



Die gleiche Klasse möchte zusätzlich Science Lab Organische Chemie OC (207 221S) und Science Lab Physikalische Chemie PC (207 231S) anschaffen. Der Science Lab Chemie Basis-Schub CB (207 200S) wird für beide benötigt.


20 : = 10

*Der Basisschub muss nicht erneut angeschafft werden, da er bereits aus dem ersten Kauf 10 x für die Gruppenstärke vorhanden ist.


Kat.-Nr. Bezeichnung
207 200xx Science Lab Chemie Basis CB
207 211xx Science Lab Anorganische Chemie AC


Kat.-Nr. Bezeichnung
207 200xx Science Lab Chemie Basis CB
207 221xx Science Lab Organische Chemie OC


Kat.-Nr. Bezeichnung
207 200xx Science Lab Chemie Basis CB
207 231xx Science Lab Physikalische Chemie PC


Kat.-Nr. Bezeichnung
207 200xx Science Lab Chemie Basis CB
207 241xx Science Lab Technische und Biochemie TBC

Hier finden Sie eine Gesamtübersicht über unsere Science Lab Schülerversuche aus dem Bereich der Biologie.







VERSUCHSTHEMEN
LB1.1 UNSERE SINNE
LB1.2 UNSERE KÖRPER
Fühlen und Tasten; Hören; Sehen; Riechen
Heiz-Kreislauf-System; Nervensystem; Verdauung; Sinnesorgane
LB1.3 GESUNDERHALTUNG DES KÖRPERS Ernährung; Hygiene; Lebensmitteltechnologie
VERSUCHSTHEMEN
LB2.0 EINFÜHRUNG IN METHODEN
LB2.1 FORM DER PFLANZEN Blatt; Blüte; Sprossachse; Wurzeln
LB2.2 FUNKTION DER PFLANZEN
Keimung und Wachstum; Wasserhaushalt; Photosynthese
LB3.0 EINFÜHRUNG IN METHODEN
LB3.1 ÖKOSYSTEME
LB3.2 UNTERSUCHUNG VON ÖKOSYSTEMEN
LB3.3 MENSCH UND UMWELT
LB3.4 EVOLUTION
Abiotische Faktoren; Biotische Faktoren; Biodiversität; Populationsökologie
Gewässeruntersuchung vor Ort; Wald- und Bodenuntersuchung
Gewässerverschmutzung; Bodenverschmutzung; Luftverschmutzung
Anpassung an die Umwelt



VERSUCHSTHEMEN
LB4.0 EINFÜHRUNG IN METHODEN Mikroskopie 19 Versuche S. 236
LB4.1 AUFBAU DER ZELLE
LB4.2 VORGÄNGE IN DER ZELLE
Einzellige Lebewesen; Mehrzellige Lebewesen
Die Zellmembran; Zellzyklus; Enzyme; Stofftransport

VERSUCHSTHEMEN
LB5.1 DNA-UNTERSUCHUNG
Die Experimentiergeräte; Gelelektrophorese von DNA; Versuchs-Kits 11 Versuche S. 244

VERSUCHSTHEMEN
LB6.1 HYGIENE
LEHRPLANTHEMEN
Einführung in mikrobiologische Methoden; Übertragungswege von Krankheitserregern; Keimzahlbestimmungen; Prävention und Desinfektion 21 Versuche S. 250
n Dieser Basis-Schub enthält die Grundgeräte für die Schülerversuche der Biologie, die immer wieder benötigt werden.
n Jedes Gerät hat seinen definierten Platz in der gerätegeformten Aufbewahrung.
n In Kombination mit den verschiedenen Themenschüben können zusammen mehr als 130 Schülerversuche in der S I und S II in der Biologie durchgeführt werden.
n Ein Basis-Schub für alle Themen in der Biologie und maximal 2 Schübe auf dem Schülerarbeitsplatz.
n In dem Basis-Schub befindet sich entsprechendes Aufbaumaterial für eine Arbeitsgruppebestehend aus 2-3 Schülern.
n Die Versuche aus dem Science Lab Biologie können dann themenabhängig mit einem weiteren Schub durchgeführt werden.
n Gleiche Geräte = immer wieder gleiche Handhabung: kein Neuerlernen für jedes Thema







Schülerexperimentiersatz des Schülerversuche-Systems Science Lab im Bereich Biologie. Grundgeräte für Versuche aus den Themen Humanbiologie, Botanik, Ökologie und Zellbiologie. Aufbaumaterial für eine Arbeitsgruppe in gerätegeformter Aufbewahrung. Die einzelnen Schübe sind stapelbar und können optional mit einem Deckel (647 003) verschlossen werden. Der Gerätesatz Science Lab Biologie Basis BB ermöglicht es, in Kombination mit mindestens einem der folgenden Science Lab-Biologie-Sätze, lehrplangeforderte Schülerversuche in der S I und S II durchzuführen:
• Gerätesatz Science Lab Humanbiologie HU2 (207 312S)
• Gerätesatz Science Lab Botanik BO (207 321S)
• Gerätesatz Science Lab Ökologie ECO (207 331S)
• Gerätesatz Science Lab Zellbiologie CE (207 341S)
Lieferumfang:
Menge Kat.-Nr. Bezeichnung
4 301 09 Doppelmuffe S
2 301 21 Stativfuß MF
3 301 271 Stativstange 40 cm, 10 mm Ø
1 309 45 Allschreibstift
1 382 21 Rührthermometer -10...+110 °C/1 K
1 604 5682 Pulverspatel Edelstahl 185 mm
1 647 002 Geräteschub, hoch
1 661 035 Rundfilter Sorte 595, 125 mm Ø, Satz 100
1 662 016 Bügelklingen, 5 Stück
1 662 092 Deckgläser, 22 mm x 22 mm, Satz 100 Stück
1 662 093 Objektträger 76 mm x 26 mm x 1 mm, Satz 50 Stück
1 664 154 Uhrglas 80 mm Ø
3 664 182 Petrischale, Glas, Ø 100 mm, Höhe 15 mm
1 665 212 Glasrührstab 200 mm x 8 mm Ø
1 665 754 Messzylinder 100 ml, Kunststofffuß
4 665 9531 Tropfpipette 150 mm x 7 mm Ø
4 665 9541 Pipettenhütchen
1 666 555 Universalklemme 0...80 mm
1 666 966 Löffelspatel, 180 mm
1 667 017 Schere 125 mm, rund
1 667 018 Labormesser
1 667 035 Tiegelzange 200 mm
1 667 057 Reagenzglasgestell Metall, 20 mm Ø
1 EUPB111 Präparierbesteck im Kunststoffbehälter, 5-teilig
Zusätzlich erforderlich:
Menge Kat.-Nr. Bezeichnung
Schülergruppe
1 207 312S Science Lab Humanbiologie HU2 (Satz)
1 207 321S* Science Lab Botanik BO (Satz)
1 207 331S* Science Lab Ökologie ECO (Satz)
1 207 341S* Science Lab Zellbiologie CE (Satz)
* alternativ
Zusätzlich empfohlen:
Menge Kat.-Nr. Bezeichnung
1 647 003 Deckel zu Geräteschub


Die Biologie des Menschen ist ein zentrales Fach im Biologieunterricht und dient neben einer Erweiterung der Kompetenzen im Bereich Biologie auch der Gesundheitserziehung. Die Sinne des Menschen können sehr eindrucksvoll anhand von Experimenten unterrichtet werden, weil die Schülerinnen und Schüler selbst Versuchsperson sein können. Auf dieser Idee basiert der Science Lab Schub Humanbiologie 1 (HU1). Ob Riechen, Sehen, Fühlen oder Hören – die meisten Experimente können direkt an sich selbst durchführt werden. Ergänzt wird die Versuchsauswahl durch anatomische Versuche, z. B. der Präparation eines Schweineauges.
Der Science Lab Schub Humanbiologie 2 (HU2) beschäftigt sich mit Körper und Gesundheit. Dabei untersuchen die Schülerinnen und Schüler in klassischen Experimenten Herz-Kreislauf- und Verdauungssystem. Ein besonderer Schwerpunkt liegt auf den Experimenten zum Thema Nervensystem: von Reaktionstests über Lernuntersuchungen können viele Experimente am eigenen Körper durchgeführt werden. Das Thema Gesundheit legt den Schwerpunkt neben Versuchen zur Verdauung auf das Thema Hygiene mit geeigneten mikrobiologischen Experimenten.

In diesem Versuch wird ein Bild mit einer 3D-Brille betrachtet. Obwohl die Vorlage flach ist, erscheint das Bild dreidimensional. Für diesen Versuch benötigen Sie den Schub Science Lab Humanbiologie HU1 (207 311S)
VERSUCHSTHEMEN
Humanbiologie HU1

LB1.2 UNSER KÖRPER
LB1.3 GESUNDERHALTUNG DES KÖRPERS



LB1.1.1.1 Berührung
Weitere Informationen zu unseren lehrplankonformen Themen und Schülerversuchen sowie die dazugehörigen Schübe finden Sie auf den nachfolgenden Seiten.
LB1.1.1 Fühlen und Tasten
LB1.1.1.1
LB1.1.1.2
LB1.1.1.3
LB1.1.1.4
LB1.1.1.5C
Berührung
Verteilung der Berührungspunkte Kaltpunkte
Abstandswahrnehmung auf der Haut Wärmeabstrom vom Körper (mit Mobile-CASSY 2 WLAN)
LB1.1.2 Hören
LB1.1.2.1
LB1.1.2.2
LB1.1.2.3
LB1.1.2.4
Hören körpereigener Geräusche Hören der Richtung Knochenleitung des Schalls und Vibrationswahrnehmung Schallabstrahlung durch das Trommelfell
LB1.1.3 Sehen
LB1.1.3.1
LB1.1.3.2
LB1.1.3.3
LB1.1.3.4
LB1.1.3.5
LB1.1.3.6
LB1.1.3.7
LB1.1.3.8
Der Blinde Fleck
Optische Täuschung durch Konvergenz Zwei Augen sind für das 3D-Sehen nötig Scheinbare Tiefe
Visueller Wettstreit und Farbumstimmung Farbige Nachbilder Farbkontrast Sehschärfe
LB1.1.4 Riechen
LB1.1.4.1
LB1.1.4.2
LB1.1.4.3
Wahrnehmung verschiedener Düfte Atemtätigkeit und Geruchsempfindung Adaptation der Riechzellen


In diesem Versuch werden Nährböden an verschiedenen Orten offen aufgestellt. Nach Bebrüten der Nährböden kann die Keimzahl durch Auszählen der Kolonien bestimmt werden.
Für diesen Versuch benötigen Sie den Schub Science Lab Humanbiologie HU2 (207 312S)
ÜBERSICHT

Kat.-Nr. Bezeichnung
207 311S Science Lab Humanbiologie HU1 (Satz)
Eine Auswahl der Literaturpakete finden Sie auf den nachfolgenden Seiten.

Literatur


Schülerexperimentiersatz des Schülerversuche-Systems Science Lab im Bereich Biologie. Aufbaumaterial für eine Arbeitsgruppe in gerätegeformter Aufbewahrung. Mit dem Gerätesatz HU1 können 20 Versuche in der S I und S II durchgeführt werden.
Inhaltlich beschäftigen sich die Schülerinnen und Schüler mit dem Bereich Sinne. Beim Bearbeiten der lehrplangeforderten Themen werden sie auch in den Kompetenzen Kommunikation und Bewertung geschult. In Verbindung mit dem Mobile-CASSY 2 WLAN (524 005W2) ergeben sich weitere Auswertemöglichkeiten, die digitales Lernen ermöglichen.
Lieferumfang:
Menge Kat.-Nr. Bezeichnung
1 311 78 Bandmaß 2 m
1 554 827 Rot-Cyan-Brille (3D)
1 647 001 Geräteschub, niedrig
1 661 043 Duftstreifenblock
1 662 421 Bildvorlagen optische Phänomene
1 662 425 Kaltsonde
1 662 426 Tastborste
1 662 427 Tastzirkel
1 662 433 Resonanzrohr
1 662 435 Gerät zum binauralen Hören
1 662 436 Stimmgabel 440Hz 4x8 mm
1 LDS00001 Handstoppuhr, digital
207 311S Science Lab Humanbiologie HU1 (Satz)
Zusätzlich erforderlich:
Menge Kat.-Nr. Bezeichnung
1 520 73 LIT-digital: LB Science Lab Biologie
1 673 0130 Lavendelöl, 10 ml
1 673 8600 Nelkenöl, 10 ml
1 674 5830 Rosenöl, künstlich, 10 ml
Zusätzlich empfohlen:
Menge Kat.-Nr. Bezeichnung
1 520 7311DE LIT-print: LB1.1 Humanbiologie - Sinne
1 524 005W2 Mobile-CASSY 2 WLAN
1 610 071 Einmal-Handschuhe, Latex, mittel, 100 Stück
1 647 003 Deckel zu Geräteschub


n 1 Geräteschub für 20 Experimente
n Schüler untersuchen die eigenen Körperfunktionen
n wenig Vorbereitungszeit durch die Lehrer nötig
n Tastborste, Kaltsonde, Gerät zum Richtungshören: Einsatz vieler Geräte, die extra für solche Experimente entwickelt wurden
SCHÜLERMESSGERÄT

SENSOREN

Mobile-CASSY 2 WLAN
DIGITALER UNTERRICHT
Das universelle Schülermessgerät mit WLAN für alle Messaufgaben in der Physik, Chemie und Biologie.
524 005W2 Mobile-CASSY 2 WLAN
Detaillierte Informationen zum Mobile-CASSY 2 WLAN finden Sie im Internet unter www.leybold-shop.de/524005W2
Temperaturfühler NiCr-Ni, schnell, Typ K
Bereits im Lieferumfang des Mobile-CASSY 2 WLAN (524 005W2) enthalten.
MOBILE-CASSY 2 WLAN
IM LIEFERUMFANG ENTHALTEN
Detaillierte Informationen zu diesem und anderen Sensoren finden Sie im Internet unter www.leybold-shop.de.

AUSWERTEMÖGLICHKEITEN
Mit dem Mobile-CASSY 2 WLAN kann direkt über 4-mm-Sicherheitsbuchsen
Spannung (U), Stromstärke (I), Leistung (P), Energie (E) sowie auch Temperatur (T) gemessen werden.
Hier finden Sie eine Übersicht über unsere Literaturpakete.
Detaillierte Informationen zu unserer Literatur finden Sie im Internet unter www.leybold-shop.de.
THEMA FACHGEBIET

UNTERRICHTSFACH

LIT-print: LB1.1 Humanbiologie - Sinne
Gedruckte Version EINES Fachgebietes in einem Ringordner
Ausführliche Versuchsanleitungen zum Science Lab Schub HU1 (207 311S). Beschreibt 20 Versuche aus dem Fachgebiet Humanbiologie - Sinne.
Versuchsthemen:
Fühlen und Tasten; Hören; Sehen; Riechen
520 7311DE LIT-print: LB1.1 Humanbiologie - Sinne
LIT-digital: LB Science Lab Biologie
Digitale Version ALLER Fachgebiete
Ausführliche Versuchsanleitungen zum Unterrichtsfach Biologie im Science Lab. Beschreibt mehra als 170 Versuche zu den Fachgebieten Humanbiologie, Botanik, Ökologie, Zellbiologie, Genetik und Hygiene.
Enthält alle interaktiven Versuchsanleitungen (Lab Docs) als html-Datei.
520 73 LIT-digital: LB Science Lab Biologie
Technische Daten der digitalen Version:
• Lieferung als Produktschlüssel (Aktivierung & Auswahl der Literatursprache über https://register.leylab.de notwendig)
• Systemvoraussetzungen:
Document Center:
PC mit Windows 7 oder höher; Internetzugang während der Installation; lokales Netzwerk zur Verteilung an die Schüler
Leylab:
- PC, Tablet oder Smartphone mit gängigem Browser; Internetzugang





Detaillierte Informationen zum ergänzenden Aufbewahrungszubehör finden Sie im Internet unter www.leybold.shop.de.
Zusätzlich empfohlen pro Klasse
Kat.-Nr. Artikelbezeichnung Bemerkung
610 071 Einmal-Handschuhe, Latex, mittel, 100 Stück
Zusätzlich empfohlen pro Gruppe
Kat.-Nr. Artikelbezeichnung Bemerkung
524 005W2 Mobile-CASSY 2 WLAN
666 1261 Temperaturfühler NiCr-Ni,

Reaktionszeit
Details ab S. 214


Hautwiderstand

Hörschwelle
LB1.2.1 Herz-Kreislauf-System
LB1.2.1.1C
LB1.2.1.2
LB1.2.1.3C
LB1.2.1.4C
Atemvolumen und Atemfrequenz (mit Mobile-CASSY 2 WLAN)
CO2-Nachweis in der Ausatemluft
Herzfrequenz und Puls (mit Mobile-CASSY 2 WLAN)
Der Blutdruck (mit Mobile-CASSY 2 WLAN)
LB1.2.2 Nervensystem
LB1.2.2.1C
LB1.2.2.2
LB1.2.2.3C
LB1.2.2.4C
LB1.2.2.5C
LB1.2.2.6C
LB1.2.2.7
LB1.2.2.8
LB1.2.2.9
Modellversuch Messung des Ruhepotenzials (mit Mobile-CASSY 2 WLAN)
Das Ostwald-Lillie‘sche Modell der Erregungsleitung
Reaktionstest Optischer Reiz (mit Mobile-CASSY 2 WLAN)
Reaktionstest Akustischer Reiz (mit Mobile-CASSY 2 WLAN)
Reaktionstest - Faktor Ablenkung (mit Mobile-CASSY 2 WLAN)
Reaktionstest - Bestimmung der Nervenleitungsgeschwindigkeit (mit Mobile-CASSY 2 WLAN)
Fingerlabyrinth - Lernen mit geschlossenen Augen
Fingerlabyrinth - Lernfortschritt
Fingerlabyrinth - Lernen mit geöffneten Augen
LB1.2.3 Verdauung
LB1.2.3.1
LB1.2.3.2
LB1.2.3.3
LB1.2.3.4C
LB1.2.3.5
Die Verdauung im Mund
Die Verdauung von Proteinen im Magen durch Pepsin
Die Verdauung von Proteinen im Magen durch Pepsin - Temperaturabhängigkeit
Verdauung von Fett durch Pankreatin (mit Mobile-CASSY 2 WLAN)
Verdauung von Stärke durch Pankreatin
LB1.2.4 Sinnesorgane
LB1.2.4.1 Präparation eines Schweineauges
LB1.3.1 Ernährung
LB1.3.1.1
LB1.3.1.2
LB1.3.1.3
LB1.3.1.4
LB1.3.1.5
Nachweis von Traubenzucker in Lebensmitteln
Nachweis von Stärke in Lebensmitteln
Nachweis von Fett in Lebensmitteln
Nachweis von Eiweiß in Lebensmitteln
Nachweis von Vitamin C in Lebensmitteln
LB1.3.2 Hygiene
LB1.3.2.1
LB1.3.2.2
LB1.3.2.3
LB1.3.2.4
LB1.3.2.5
LB1.3.2.6
LB1.3.2.7 Bereitung und Sterilisation von Nährmedien
Keimzahlbestimmung in der Luft
Bestimmung des Keimgehaltes an Geldscheinen und Geldmünzen
Vergleich des Keimgehaltes an gewaschenen und ungewaschenen Händen
Simulation einer Infektionskette mit Bäckerhefe
Bakteriostatische Wirkung von verschiedenen Substanzen
Sterilisation, Reinigung bzw. Vernichtung der Geräte und Nährböden
LB1.3.3 Lebensmitteltechnologie
LB1.3.3.1
LB1.3.3.2
Nachweis der Gärungsprodukte der Hefen Temperaturabhängigkeit des Gärungsprozesses

LB1.2.2.7 Fingerlabyrinth - Lernen mit geschlossenen Augen
ÜBERSICHT BENÖTIGTES


Kat.-Nr. Bezeichnung
207 300S Science Lab Biologie Basis BB (Satz)
207 312S Science Lab Humanbiologie HU2 (Satz)
Eine Auswahl der Literaturpakete finden Sie auf den nachfolgenden Seiten.



Schülerexperimentiersatz des Schülerversuche-Systems Science Lab im Bereich Biologie. Aufbaumaterial für eine Arbeitsgruppe in gerätegeformter Aufbewahrung. Mit dem Gerätesatz HU2 können, zusammen mit dem Schub Science Lab Biologie Basis BB (207 300S), mehr als 30 Versuche in der S I und S II durchgeführt werden.
Inhaltlich beschäftigen sich die Schülerinnen und Schüler mit den Bereichen Unser Körper und Gesundheit des menschlichen Körpers. Beim Bearbeiten der lehrplangeforderten Themen werden sie auch in den Kompetenzen Kommunikation und Bewertung geschult. In Verbindung mit dem Mobile-CASSY 2 WLAN (524 005W) ergeben sich weitere Auswertemöglichkeiten, die digitales Lernen ermöglichen.
Lieferumfang:
Menge Kat.-Nr. Bezeichnung
2 501 46 Experimentierkabel 19 A, 100 cm, rot/blau, Paar
4 501 86 Krokodilklemme, blank
4 602 022 Becherglas Boro 3.3, 100 ml, nF
1 647 002 Geräteschub, hoch
1 662 334 Drigalski-Spatel, Glas
2 662 429 Eisennagel, Satz 2
1 662 5426 Fingerlabyrinth
8 664 0421 Reagenzglas Fiolax 16 mm x 160 mm
2 664 131 Becherglas Boro 3.3, 400 ml, nF
1 664 243 Erlenmeyerkolben 250 ml, eH, SB 29
1 664 3831 Plattenelektrode Zink 43 x 28 mm
4 664 3871 Plattenelektrode Kohle 43 x 28 mm
1 664 391 Schmirgelstein
1 665 643 Gärrohr 200 mm x 8 mm Ø
3 665 997 Messpipette 10 ml
1 666 002 Pipettierhilfe 10 ml
1 666 350 Sieb, Kunststoff, Ø 7 cm
1 667 243 Gummiblasen (Luftballons), Satz 10
3 667 253 Gummistopfen voll, 14...18 mm Ø
1 667 261 Gummistopfen 1 Loch 7 mm, 25...31 mm Ø
Zusätzlich erforderlich:
Menge Kat.-Nr. Bezeichnung
1 207 300S Science Lab Biologie Basis BB (Satz)
1 520 73 LIT-digital: LB Science Lab Biologie
1 524 005W2 Mobile-CASSY 2 WLAN
2 610 010 Laborschutzbrille Focomax
1 675 3410 Wasser, rein, 5 l
1 679 312 Chemikaliensatz Science Lab Humanbiologie HU2
Zusätzlich empfohlen:
Menge Kat.-Nr. Bezeichnung
1 520 7312DE LIT-print: LB1.2+LB1.3 HumanbiologieKörper und Gesundheit
1 524 0461 Reaktionstest-Adapter S
1 524 0471 Puls-Sensor S
1 524 0501 Blutdruck-Sensor S
1 524 056 Spirometer-Box
1 607 020 Sicherheitsgasschlauch mit Endmuffe 0,5 m
1 610 290 Parafilm
1 647 003 Deckel zu Geräteschub
1 656 7031 Teclubrenner, Propan
1 661 091 Siedesteine 100 g
1 662 148 Handtaster
1 662 149 Fußtaster
1 666 8036 Trockenschrank UN30
1 666 8471 Magnetrührer mit Heizplatte, rund
1 666 851 Magnetrührstäbchen 25 mm x 6 mm Ø, zylindrisch
1 670 2230 Albustix-Teststäbchen, 50 St
1 ADACB501 Kompaktwaage 500 g : 0,1 g
1 MA91314 Teststäbchen Ascorbinsäure


n 33 Versuche mit 1 Schub plus Basis-Schub
n Schwerpunkt auf Versuchen, die am eigenen Körper durchgeführt werden
n Exkurs zum Thema Hygiene und Ernährung
n moderne Modellversuche zu Ruhepotenzial und Nervenweiterleitung
SCHÜLERMESSGERÄT




Mobile-CASSY 2 WLAN
DIGITALER UNTERRICHT
Das universelle Schülermessgerät mit WLAN für alle Messaufgaben in der Physik, Chemie und Biologie.
524 005W2 Mobile-CASSY 2 WLAN
Detaillierte Informationen zum Mobile-CASSY 2 WLAN finden Sie im Internet unter www.leybold-shop.de/524005W2
EMPFOHLENE SENSOREN
Zur Messung von Reaktionszeiten über Hand- oder Fußtaster und zur Bestimmung der Nervenleitungsgeschwindigkeit. Signalisierung wahlweise über drei farbige LEDs (Handtaster) oder ein akustisches Signal (Fußtaster) oder mit CASSY (524 013, 524 006, 524 005W2, 524 018).
524 0461
Reaktionstest-Adapter S
Puls-Sensor S
Zur Messung der Pulsfrequenz mittels Infrarot-Messzelle am Ohrläppchen oder der Fingerkuppe mit automatischer Empfindlichkeitseinstellung durch CASSY (524 013, 524 006, 524 005W2, 524 018). Die einzelnen Pulsschläge werden durch eine LED angezeigt. Der Pulsaufnehmer ist galvanisch von CASSY getrennt.
524 0471
Puls-Sensor S
Blutdruck-Sensor S
Zur Messung des Blutdrucks nach der oszillometrischen Methode mit CASSY (524 013, 524 006, 524 018) ohne Stethoskop und Mikrofon. Die durch die Pulswellen verursachten und von der Blutdruck-Manschette übertragenen Druckschwankungen werden gemessen; parallel dazu wird der abfallende Manschettendruck erfasst. Alternativ zur Verwendung mit Mobile-CASSY 2 WLAN (524 005W2) nach der auskultatorischen Methode (nach Korotkow). Die charakteristischen Geräuschphänomene werden mit einem Stethoskop abgehört (zusätzlich erforderlich). Das Universelle Messinstrument Biologie (531 837) stellt die Druckschwankungen akustisch dar.
524 0501
Blutdruck-Sensor S
Detaillierte Informationen zu diesen und anderen Sensoren finden Sie im Internet unter www.leybold-shop.de.

EMPFOHLENE SENSOREN
Zur pneumotachographischen Messung verschiedener Atemvolumina, der Fluss-Volumen-Kurve und der 1-Sekunden-Kapazität mit CASSY (524 013, 524 006, 524 005W2, 524 018).
524 056 Spirometer-Box
Detaillierte Informationen zu diesem und anderen Sensoren finden Sie im Internet unter www.leybold-shop.de.
Hier finden Sie eine Übersicht über unsere Literaturpakete.
Detaillierte Informationen zu unserer Literatur finden Sie im Internet unter www.leybold-shop.de.
THEMA FACHGEBIET

UNTERRICHTSFACH

LIT-print: LB1.2+LB1.3 HumanbiologieKörper und Gesundheit
Gedruckte Version EINES Fachgebietes in einem Ringordner
Ausführliche Versuchsanleitungen zum Science Lab Schub HU2 (207 312S). Beschreibt 33 Versuche aus dem Fachgebiet Humanbiologie - Körper und Gesundheit.
Versuchsthemen: Herz-Kreislauf-System; Nervensystem; Verdauung; Sinnesorgane; Ernährung;Hygiene
520 7312DE LIT-print: LB1.2+LB1.3 Humanbiologie - Körper und Gesundheit
LIT-digital: LB Science Lab Biologie
Digitale Version ALLER Fachgebiete
Ausführliche Versuchsanleitungen zum Unterrichtsfach Biologie im Science Lab. Beschreibt mehr als 170 Versuche zu den Fachgebieten Humanbiologie, Botanik, Ökologie, Zellbiologie, Genetik und Hygiene.
Enthält alle interaktiven Versuchsanleitungen (Lab Docs) als html-Datei.
520 73 LIT-digital: LB Science Lab Biologie
Technische Daten der digitalen Version:
• Lieferung als Produktschlüssel (Aktivierung & Auswahl der Literatursprache über https://register.leylab.de notwendig)
• Systemvoraussetzungen:
Document Center:
PC mit Windows 7 oder höher; Internetzugang während der Installation; lokales Netzwerk zur Verteilung an die Schüler
Leylab:
- PC, Tablet oder Smartphone mit gängigem Browser; Internetzugang





Detaillierte Informationen zum ergänzenden Aufbewahrungszubehör finden Sie im Internet unter www.leybold.shop.de.

Chemikalien zur Durchführung der Schülerversuche im Science Lab Humanbiologie HU2. Der Chemikaliensatz enthält 20 verschiedene Chemikalien, mit denen man jeden Versuch mindestens 10 mal durchführen kann.
679 312 Chemikalien Science Lab Humanbiologie
Die einzelnen Chemikalien aus diesem Satz finden Sie im Internet unter www.leybold-shop.de. Dort erfahren Sie ebenfalls mehr über die entsprechenden Gefahrensymbole und -klassen, den sicheren Umgang mit Chemikalien sowie die Gefahren- und Sicherheitshinweise.
Zusätzlich erforderlich pro Schülerin oder Schüler
Kat.-Nr. Artikelbezeichnung Bemerkung
610 010 Laborschutzbrille Focomax
Zusätzlich erforderlich pro Gruppe
Kat.-Nr. Artikelbezeichnung
524 005W2 Mobile-CASSY 2 WLAN
Zusätzlich empfohlen pro Klasse
Kat.-Nr.
610 290 Parafilm
661 091 Siedesteine 100 g
666 8036 Trockenschrank
670 2230 Albustix-Teststäbchen, 50 St
MA91314 Ascorbinsäure-Bestimmung, Teststreifen
Zusätzlich empfohlen pro Gruppe
Kat.-Nr. Artikelbezeichnung
524 0461 Reaktionstest-Adapter S
524 0471 Puls-Sensor S
524 0501 Blutdruck-Sensor S
524 056 Spirometer-Box
607 020 Sicherheitsgasschlauch mit Endmuffe, 0,5 m
656 7031 Teclubrenner, Propan
662 148 Handtaster
662 149 Fußtaster
666 8471 Magnetrührer mit Heizplatte, rund
666 851 Magnetrührstäbchen 25 mm x 6 mm Ø, zylindrisch
ADACB501 Kompaktwaage, 500 g : 0,1 g
Die Untersuchung der Form und Funktion von Pflanzen ist experimentell leicht zugänglich. So können mit dem Science Lab Botanik (BO) Untersuchungen an Blatt und Blüte durchgeführt werden. Ein Schwerpunkt liegt auf Experimenten zur Untersuchung von Pflanzenmechanismen, z. B. der Untersuchung des Wasserhaushalts oder der Photosynthese. Hier liegt ein besonderes Augenmerk auf Versuchen, die sich problemlos in einer Schulstunde durchführen lassen und die Effekte besonders eindrucksvoll zeigen.

LB2.2.2.2 Wasserleitung in einem Spross
Bei diesem Versuch kann der Weg des Wassers im Spross einer Pflanze wahrnehmungsaktiv nachvollzogen werden. Dazu wird der frisch angeschnittene Spross einer weißblühenden Pflanze in angefärbtes Wasser gestellt. Für diesen Versuch benötigen Sie die Schübe Science Lab Biologie Basis BB (207 300S) und Science Lab Botanik BO (207 321S)
VERSUCHSTHEMEN
LB2.0 EINFÜHRUNG IN METHODEN
LB2.1 FORM DER PFLANZEN
LB2.2 FUNKTION DER PFLANZEN



LB2.2.3.1 Lichtabhängigkeit bei der Photosynthese
Bei diesem Versuch werden aufsteigende Luftbläschen am Spross einer Wasserpflanze gezählt. Dabei wird eine Pflanze vorher belichtet, die andere dunkel gehalten. Für diesen Versuch benötigen Sie die Schübe Science Lab Biologie Basis BB (207 300S) und Science Lab Botanik BO (207 321S)
Weitere Informationen zu unseren lehrplankonformen Themen und Schülerversuchen sowie die dazugehörigen Schübe finden Sie auf den nachfolgenden Seiten.
LB2.0 EINFÜHRUNG IN METHODEN
LB2.0.0 Mikroskopie
LB2.0.0.1
LB2.0.0.2 Aufbau und Funktionsweise eines Lichtmikroskops Präparate herstellen
LB2.1 FORM DER PFLANZEN
LB2.1.1 Blatt
LB2.1.1.1
LB2.1.1.2
LB2.1.1.3
LB2.1.1.4
LB2.1.1.5
LB2.1.1.6
LB2.1.1.7
Betrachtung eines Blattes Blattstruktur eines Moosblattes
Laubblattquerschnitt mit oberer und unterer Epidermis Flächenschnitt: Spaltöffnungen unter dem Mikroskop Pflanzliche Zelle: Aufbau einer Zwiebelzelle Organe der Wasserverdunstung Viele Pflanzenteile besitzen einen Verdunstungsschutz
LB2.1.2 Blüte
LB2.1.2.1
LB2.1.2.2
Betrachtung einer Blüte Pollen und Pollenschlauch
LB2.1.3 Sprossachse
LB2.1.3.1 Querschnitt durch einen Pflanzenstängel
LB2.1.4 Wurzeln
LB2.1.4.1
LB2.1.4.2 Organe der Wasseraufnahme Wurzelhaarbildung
LB2.2 FUNKTION DER PFLANZEN
LB2.2.1 Keimung und Wachstum
LB2.2.1.1
LB2.2.1.2
LB2.2.1.3
LB2.2.1.4
LB2.2.1.5
LB2.2.1.6 Quellung Quellungsdruck
Abhängigkeit der Keimung von verschiedenen Faktoren Licht beeinflußt die Keimung von Pflanzen Zellatmung bei der Keimung Wahlvermögen der Wurzeln
LB2.2.2 Wasserhaushalt
LB2.2.2.1
LB2.2.2.2
LB2.2.2.3
LB2.2.2.4
LB2.2.2.5
LB2.2.2.6
LB2.2.2.7 Ohne Wasser können Pflanzen nicht leben Wasserleitung in einem Spross Wasser steigt in Kapillaren Bedeutung der Spaltöffnungen Abhängigkeit des Wasserbedarfs von Blattzahl und Blattgröße Wasserverbrauch von Feuchtigkeits- und Trockenpflanzen Messen der Transpiration
LB2.2.3 Photosynthese
LB2.2.3.1
LB2.2.3.2
LB2.2.3.3
LB2.2.3.4
LB2.2.3.5
Lichtabhängigkeit bei der Photosynthese Sauerstoffnachweis bei der Photosynthese Kohlenstoffdioxid und Photosynthese Nachweis von Stärke bei Photosynthese Trennung von Blattfarbstoffen durch Papierchromatographie

LB2.2.1.4 Licht beeinflusst die Keimung von Plfanzen (trocken)

LB2.2.1.4 Licht beeinflusst die Keimung von Plfanzen (feucht)
ÜBERSICHT


Kat.-Nr. Bezeichnung
207 300S Science Lab Biologie Basis BB (Satz)
207 321S Science Lab Botanik BO (Satz)
Eine Auswahl der Literaturpakete finden Sie auf den nachfolgenden Seiten.



Schülerexperimentiersatz des Schülerversuche-Systems Science Lab im Bereich Biologie. Aufbaumaterial für eine Arbeitsgruppe in gerätegeformter Aufbewahrung. Mit dem Gerätesatz BO können, zusammen mit dem Science Lab Biologie Basis BB (207 300S), mehr als 30 Versuche in der S I und S II durchgeführt werden.
Inhaltlich beschäftigen sich die Schülerinnen und Schüler mit den Bereichen Form der Pflanzen und Funktion der Pflanzen. Beim Bearbeiten der lehrplangeforderten Themen werden sie auch in den Kompetenzen Kommunikation und Bewertung geschult.
Lieferumfang:
Menge Kat.-Nr. Bezeichnung
2 301 261 Stativstange 25 cm, gelocht
1 362 36 Kapillargerät
1 451 17 Lampenfassung E27, Euro-Stecker
6 591 21 Federstecker groß
2 602 022 Becherglas Boro 3.3, 100 ml, nF
1 647 002 Geräteschub, hoch
1 662 328 LED Pflanzenlampe
3 664 0421 Reagenzglas Fiolax 16 mm x 160 mm
1 664 131 Becherglas Boro 3.3, 400 ml, nF
1 664 243 Erlenmeyerkolben 250 ml, eH, SB 29
1 665 009 Trichter PP, 75 mm Ø
3 665 240 Kunststoffrohr, 240 x 25 mm Ø
1 665 643 Gärrohr 200 mm x 8 mm Ø
1 667 091 Pistill 88 mm
1 667 092 Mörser Porzellan 70 mm Ø
1 667 127 Standlupe, 8x
1 667 253 Gummistopfen voll, 14...18 mm Ø
3 667 257 Gummistopfen voll, 19...24 mm Ø
1 667 261 Gummistopfen 1 Loch 7 mm, 25...31 mm Ø
207 321S Science Lab Botanik BO (Satz)
Zusätzlich erforderlich:
Menge Kat.-Nr. Bezeichnung
1 207 300S Science Lab Biologie Basis BB (Satz)
1 520 73 LIT-digital: LB Science Lab Biologie
2 610 010 Laborschutzbrille Focomax
1 675 3410 Wasser, rein, 5 l
1 679 320 Chemikaliensatz Science Lab Botanik
1 MIK5738860 Mikroskop EduLed FLQ
Zusätzlich empfohlen:
Menge Kat.-Nr. Bezeichnung
1 520 7321DE LIT-print: LB2 Botanik
1 607 020 Sicherheitsgasschlauch mit Endmuffe 0,5 m
1 610 290 Parafilm
1 647 003 Deckel zu Geräteschub
1 656 7031 Teclubrenner, Propan
1 661 055 Chromatografiepapier
1 661 080 Kobaltchloridpapier 2 x 7 cm, 100 Streifen
1 661 091 Siedesteine 100 g
1 661 243 Spritzflasche PE 500 ml
1 665 568 Mikrokapillaren
1 666 8471 Magnetrührer mit Heizplatte, rund
1 ADACB501 Kompaktwaage 500 g : 0,1 g


n 1 Schub und Basis-Schub für 32 Versuche
n Schülerversuchsaufbau zum parallelen Darstellen und Vergleichen mehrerer Proben (Aufbau mit Stativstab - gelocht)
n enthält Mikroskopie-Versuche und Grundlagen zum Mikroskopieren
n eindrucksvolle Versuche, z. B. der Quellungsdruck bei der Keimung, Messen der Transpiration oder Sauerstoffnachweis bei der Photosynthese
SCHÜLERMESSGERÄT


Mobile-CASSY 2 WLAN
DIGITALER UNTERRICHT
Das universelle Schülermessgerät mit WLAN für alle Messaufgaben in der Physik, Chemie und Biologie.
524 005W2 Mobile-CASSY 2 WLAN
Detaillierte Informationen zum Mobile-CASSY 2 WLAN finden Sie im Internet unter www.leybold-shop.de/524005W2
Temperaturfühler NiCr-Ni, schnell, Typ K
Bereits im Lieferumfang des Mobile-CASSY 2 WLAN (524 005W2) enthalten.
MOBILE-CASSY 2 WLAN
IM LIEFERUMFANG ENTHALTEN
Detaillierte Informationen zu diesem und anderen Sensoren finden Sie im Internet unter www.leybold-shop.de.

AUSWERTEMÖGLICHKEITEN
Mit dem Mobile-CASSY 2 WLAN kann direkt über 4-mm-Sicherheitsbuchsen Spannung (U), Stromstärke (I), Leistung (P) und Energie (E) gemessen werden.
Hier finden Sie eine Übersicht über unsere Literaturpakete.
Detaillierte Informationen zu unserer Literatur finden Sie im Internet unter www.leybold-shop.de.
THEMA FACHGEBIET

UNTERRICHTSFACH

LIT-print: LB2 Botanik
Gedruckte Version EINES Fachgebietes in einem Ringordner
Ausführliche Versuchsanleitungen zum Science Lab Schub BO (207 321S). Beschreibt 32 Versuche aus dem Fachgebiet Botanik.
Versuchsthemen:
Mikroskopie; Blatt; Blüte; Sprossachse; Wurzeln; Keimung und Wachstum; Wasserhaushalt; Photosynthese
LIT-digital: LB Science Lab Biologie
Ausführliche Versuchsanleitungen zum Unterrichtsfach Biologie im Science Lab. Beschreibt mehr als 170 Versuche zu den Fachgebieten Humanbiologie, Botanik, Ökologie, Zellbiologie, Genetik und Hygiene.
Enthält alle interaktiven Versuchsanleitungen (Lab Docs) als html-Datei.
520 73 LIT-digital: LB Science Lab Biologie
Technische Daten der digitalen Version:
• Lieferung als Produktschlüssel (Aktivierung & Auswahl der Literatursprache über https://register.leylab.de notwendig)
• Systemvoraussetzungen: Document Center:
PC mit Windows 7 oder höher; Internetzugang während der Installation; lokales Netzwerk zur Verteilung an die Schüler Leylab:
- PC, Tablet oder Smartphone mit gängigem Browser; Internetzugang


Chemikalien Science Lab Botanik
Chemikalien zur Durchführung der Schülerversuche im Science Lab Botanik. Der Chemikaliensatz enthält 15 verschiedene Chemikalien, mit denen man jeden Versuch mindestens 10 mal durchführen kann.
679 320 Chemikalien Science Lab Botanik
Die einzelnen Chemikalien aus diesem Satz finden Sie im Internet unter www.leybold-shop.de. Dort erfahren Sie ebenfalls mehr über die entsprechenden Gefahrensymbole und -klassen, den sicheren Umgang mit Chemikalien sowie die Gefahren- und Sicherheitshinweise.
Zusätzlich erforderlich pro Schülerin oder Schüler
Kat.-Nr. Artikelbezeichnung Bemerkung
610 010 Laborschutzbrille Focomax
Zusätzlich erforderlich pro Gruppe
Kat.-Nr. Artikelbezeichnung
MIK5738860 Mikroskop EduLed FLQ
Zusätzlich empfohlen pro Klasse
Kat.-Nr. Artikelbezeichnung
610 290 Parafilm
661 055 Chromatografiepapier
661 080 Kobaltchlorid-Papier
661 091 Siedesteine 100 g
665 568 Mikrokapillaren
Zusätzlich empfohlen pro Gruppe
Kat.-Nr. Artikelbezeichnung
661 243 Spritzflasche PE 500 ml
524 0461 Reaktionstest-Adapter S
607 020 Sicherheitsgasschlauch mit Endmuffe, 0,5 m
656 7031 Teclubrenner, Propan 666 8471 Magnetrührer mit Heizplatte, rund ADACB501 Kompaktwaage, 500 g : 0,1 g
Bemerkung
Bemerkung
Bemerkung



Detaillierte Informationen zum

Aufbewahrungszubehör finden Sie im

Ökologie ist mehr als der Sprachgebrauch des Wortes „Öko“ vermuten lässt. Im Science Lab Ökologie (ECO) geht es unter anderem darum, ein Ökosystem unter möglichst vielen Gesichtspunkten zu beobachten und zu beschreiben. So messen die Schülerinnen und Schüler Temperatur und Beleuchtungsstärke oder vergleichen einen Waldboden mit einem Boden vom Straßenrand. Auch das Thema Biodiversität wird experimentell erarbeitet.

LB3.1.3.4 Beobachtung von Lebewesen im Heuaufguss
Bei diesem Versuch können eukaryotische und prokaryotische Ein- und Mehrzeller beobachtet werden. Zum Beispiel können im Heuaufguss Bakterien, begeißelte Einzeller, Wimperntiere oder Rädertiere entstehen. Für diesen Versuch werden die Schübe Science Lab Biologie Basis BB (207 300S) und Science Lab Ökologie ECO (207 331S) benötigt.
LB3.1 ÖKOSYSTEME
LB3.2 UNTERSUCHUNG VON ÖKOSYSTEMEN
LB3.3 MENSCH UND UMWELT
LB3.4 EVOLUTION



LB3.2.2.3C pH-Wert von Bodenproben
Bei diesem Versuch fließt Wasser durch verschiedene Bodenproben. Die pH-Werte der Filtrate werden mit dem Mobile-CASSY 2 WLAN bestimmt. Es wird herausgearbeitet, dass Pflanzen spezifische Bodeneigenschaften bevorzugen und daher z. B. als pH-Anzeiger dienen können. Für diesen Versuch werden die Schübe Science Lab Biologie Basis BB (207 300S) und Science Lab Ökologie ECO (207 331S) benötigt.
Weitere Informationen zu unseren lehrplankonformen Themen und Schülerversuchen sowie die dazugehörigen Schübe finden Sie auf den nachfolgenden Seiten.
EINFÜHRUNG IN METHODEN
LB3.0.0 Mikroskopie
LB3.0.0.1
LB3.0.0.2
Aufbau und Funktionsweise eines Lichtmikroskops Mikropräparate herstellen
LB3.1 ÖKOSYSTEME
LB3.1.1 Abiotische Faktoren
LB3.1.1.1
LB3.1.1.2C
LB3.1.1.3C
LB3.1.1.4C
LB3.1.1.5
LB3.1.1.5C
LB3.1.1.6
Temperaturabhängigkeit von Lebensvorgängen
Bergmann-Regel (Faktor Temperatur) (mit Mobile-CASSY 2 WLAN)
Allen-Regel (Faktor Temperatur) (mit Mobile-CASSY 2 WLAN)
Gruppenbildung als Schutz vor Kälte (mit Mobile-CASSY 2 WLAN)
Isolierende Wirkung der Körperbedeckung
Isolierende Wirkung der Körperbedeckung (mit Mobile-CASSY 2 WLAN)
Laubblattquerschnitte im Vergleich: Sonnenblatt und Schattenblatt
LB3.1.2 Biotische Faktoren
LB3.1.2.1
LB3.1.2.3
Zwischenartliche Konkurrenz bei Pflanzen Symbiose
LB3.1.3 Biodiversität
LB3.1.3.2
LB3.1.3.4
Untersuchung der Bodenfauna durch Sieben (Berlese-Trichter) Beobachtung von Lebewesen im Heuaufguss
LB3.1.4 Populationsökologie
LB3.1.4.3 Nahrungskette: Destruenten
LB3.2.1 Gewässeruntersuchung vor Ort
LB3.2.1.2C
LB3.2.1.3C
LB3.2.1.4
LB3.2.1.5C
LB3.2.1.6C
pH-Wert von Gewässern (mit Mobile-CASSY 2 WLAN)
Salzgehalt von Gewässern (mit Mobile-CASSY 2 WLAN)
Chemische Wasserparameter
Gewässerprotokoll (mit Mobile-CASSY 2 WLAN)
Temperaturmessungen im Gewässer (mit Mobile-CASSY 2 WLAN)
LB3.2.2 Wald- und Bodenuntersuchung
LB3.2.2.1
LB3.2.2.2
LB3.2.2.3C
LB3.2.2.4C
LB3.2.2.5C
LB3.2.2.6C
LB3.2.2.7C
LB3.2.2.8C
LB3.3
Sedimentation von Bodenteilchen Boden und Wasser
pH-Wert von Bodenproben (mit Mobile-CASSY 2 WLAN)
Humusbildung und Humusarten (mit Mobile-CASSY 2 WLAN)
Salzgehalt des Bodens (mit Mobile-CASSY 2 WLAN) Abiotischer Faktor Beleuchtungsstärke (mit Mobile-CASSY 2 WLAN)
Temperatur in Abhängigkeit des Standortes (mit Mobile-CASSY 2 WLAN) Tagesgangmessungen an einem Standort (mit Mobile-CASSY 2 WLAN)
LB3.3.1 Gewässerverschmutzung
LB3.3.1.1
LB3.3.1.2
LB3.3.1.4
Schaum - eine erhebliche Umweltbelastung Eutrophierung der Gewässer durch Phosphate Wirkung von Kies- und Aktivkohlefiltern
LB3.3.2 Bodenverschmutzung
LB3.3.2.1
LB3.3.2.2 Toxizitätsmessung von Benzin mit Kressesamen Verunreinigung von Böden mit nicht biologischen Substanzen
LB3.3.3 Luftverschmutzung
LB3.3.3.1 Feststellung von Emissionen am Beispiel der Motorabgase
LB3.4 EVOLUTION
LB3.4.1 Anpassung an die Umwelt
LB3.4.1.1
LB3.4.1.2 Schwungfeder von Vögeln Betrachtung von Fischschuppen

LB3.1.1.5C Isolierende Wirkung der Körperbedeckung
ÜBERSICHT BENÖTIGTES MATERIAL



Kat.-Nr. Bezeichnung
207 300S Science Lab Biologie Basis BB (Satz)
207 331S Science Lab Ökologie ECO (Satz)
Eine Auswahl der Literaturpakete finden Sie auf den nachfolgenden Seiten.


Schülerexperimentiersatz des Schülerversuche-Systems Science Lab im Bereich Biologie. Aufbaumaterial für eine Arbeitsgruppe in gerätegeformter Aufbewahrung. Mit dem Gerätesatz ECO können, zusammen mit dem Science Lab Biologie Basis BB (207 300S), mehr als 30 Versuche in der S I und S II durchgeführt werden. Inhaltlich beschäftigen sich die Schülerinnen und Schüler mit den Bereichen Ökosysteme, Erkunden von Ökosystemen, Mensch und Umwelt und Evolution. Beim Bearbeiten der lehrplangeforderten Themen werden sie auch in den Kompetenzen Kommunikation und Bewertung geschult. In Verbindung mit dem Mobile-CASSY 2 WLAN (524 005W) ergeben sich weitere Auswertemöglichkeiten, die digitales Lernen ermöglichen.
Lieferumfang:
Menge Kat.-Nr.
Bezeichnung
2 301 261 Stativstange 25 cm, gelocht
1 311 78 Bandmaß 2 m
1 340 90 Gummiringe, Satz 8
6 591 21 Federstecker groß
4 602 022 Becherglas Boro 3.3, 100 ml, nF
1 647 002 Geräteschub, hoch
8 664 0421 Reagenzglas Fiolax 16 mm x 160 mm
2 664 131 Becherglas Boro 3.3, 400 ml, nF
1 665 009 Trichter PP, 75 mm Ø
3 665 2011 Glasrohr, 80 x 8 mm Durchm.
3 665 240 Kunststoffrohr, 240 x 25 mm Ø
1 666 350 Sieb, Kunststoff, Ø 7 cm
1 667 127 Standlupe, 8x
1 667 253 Gummistopfen voll, 14...18 mm Ø
3 667 257 Gummistopfen voll, 19...24 mm Ø
3 667 258 Gummistopfen 1 Loch 7 mm, 19...24 mm Ø
1 LDS00001 Handstoppuhr, digital
207 331S Science Lab Ökologie ECO (Satz)
Zusätzlich erforderlich:
Menge Kat.-Nr. Bezeichnung
1 207 300S Science Lab Biologie Basis BB (Satz)
1 520 73 LIT-digital: LB Science Lab Biologie
1 524 005W2 Mobile-CASSY 2 WLAN
2 610 010 Laborschutzbrille Focomax
1 675 3410 Wasser, rein, 5 l
1 679 330 Chemiekaliensatz Science Lab Ökologie
1 MIK5738860 Mikroskop EduLed FLQ
Zusätzlich empfohlen:
Menge Kat.-Nr. Bezeichnung
1 520 7331DE LIT-print: LB3 Ökologie
1 524 0671 Leitfähigkeits-Adapter S
1 524 0672 pH-Adapter S
1 524 0673 NiCr-Ni-Adapter S, Typ K
1 524 444 Luxsensor M
1 529 670 Leitfähigkeits-Sensor
1 529 672 pH-Elektrode, BNC-Stecker
1 607 020 Sicherheitsgasschlauch mit Endmuffe 0,5 m
1 647 003 Deckel zu Geräteschub
1 656 7031 Teclubrenner, Propan
2 666 1261 Temperaturfühler NiCr-Ni, schnell, Typ K
1 666 8036 Trockenschrank UN30
1 674 4640 Pufferlösung pH 4,00, 250 ml
1 674 4670 Pufferlösung pH 7,00, 250 ml
1 ADACB501 Kompaktwaage 500 g : 0,1 g
1 MA90204 Universalindikatorpapier pH 1...14, Rolle
MA91201 Teststäbchen Gesamthärte
1
1 MA91313 Teststäbchen Nitrat/Nitrit
1 MA91315 Teststäbchen Ammonium
1 MA91320 Teststäbchen Phosphat


n 1 Schub und Basis-Schub für 35 Experimente
n enthält Mikroskopie-Versuche und Grundlagen zum Mikroskopieren
n Schülerversuchsaufbau zum parallelen Darstellen und Vergleichen mehrerer Proben (Aufbau mit Stativstab - gelocht)
n leichter Einstieg in das digitale Messen und Auswerten
SCHÜLERMESSGERÄT

SENSOREN

SENSOREN
DIGITALER UNTERRICHT
Das universelle Schülermessgerät mit WLAN für alle Messaufgaben in der Physik, Chemie und Biologie.
524 005W2 Mobile-CASSY 2 WLAN
Detaillierte Informationen zum Mobile-CASSY 2 WLAN finden Sie im Internet unter www.leybold-shop.de/524005W2
Temperaturfühler NiCr-Ni, schnell, Typ K
Bereits im Lieferumfang des Mobile-CASSY 2 WLAN (524 005W2) enthalten.
Detaillierte Informationen zu diesem und anderen Sensoren finden Sie im Internet unter www.leybold-shop.de.

Leitfähigkeits-Sensor
EMPFOHLENE SENSOREN
Sensor in Vierleitertechnik mit integriertem Pt-Temperatursensor; zur Verwendung mit der Chemie-Box (524 067) oder dem Leitfähigkeits-Adaper S (524 0671) zusammen mit CASSY (524 013, 524 006, 524 005W2, 524 018) oder dem Universellen Messinstrument Chemie (531 836). Offener Aufbau für schnelle Reaktion auf Leitfähigkeitsänderungen. Bei Messungen ist ein Mindestabstand von der Behälterwand von 1 cm, sowie eine Mindesteintauchtiefe von 2 cm einzuhalten.
529 670 Leitfähigkeits-Sensor

Leitfähigkeits-Adapter S
Ermöglicht zusammen mit dem Leitfähigkeits-Sensor (529 670) die Messung der Leitfähigkeit und der Temperatur mit CASSY (524 013, 524 006, 524 005W2, 524 018) oder dem Universellen Messinstrument Chemie (531 836).
524 0671 Leitfähigkeits-Adapter S
Detaillierte Informationen zu diesen und anderen Sensoren finden Sie im Internet unter www.leybold-shop.de.




LITERATURPAKETE
EMPFOHLENE SENSOREN
Ermöglicht den Anschluss einer pH-Elektrode an CASSY (524 013, 524 006, 524 005W2, 524 018) oder das Universelle Messinstrument Chemie (531 836). Zudem kann die Spannung an der BNC-Buchse sehr hochohmig gemessen werden, z.B. zur Messung elektrochemischer Potenziale.
pH-Kunststoffelektrode mit Kunststoffschaft und BNC-Stecker. Zur Verwendung mit der Chemie-Box (524 067) oder pH-Adapter S (524 0672) an CASSY (524 013, 524 006, 524 005W2, 524 018) oder dem Universellen Messinstrument Chemie (531 836). Wartungsarme pH-Elektrode mit Festelektrolyt aus einem leitenden gelartigen Polymer.
529 672
pH-Elektrode, BNC-Stecker
Zur Lagerung wird 3 M KCl empfohlen (672 5250).
Luxsensor M
Zur Messung der Beleuchtungsstärke von sichtbarem Licht mit Mobile-CASSY 2 (524 005W2). Der Luxsensor ist flach ausgeführt, damit er beispielsweise direkt in den Halter für Blenden und Dias auf Stiel (459 33) eingesetzt werden kann. Mit dem Luxsensor lassen sich Versuche entlang und orthogonal zur optischen Achse durchführen. Eine aufgedruckte Millimeterskala dient dazu, den Sensor auf der optischen Achse zu positionieren und ermöglicht zudem die Aufnahme von Intensitätsverteilungen verschiedener Beugungsobjekte ohne weitere Hilfsmittel.
524 444 Luxsensor M
Ermöglicht den Anschluss von zwei NiCr-Ni (Typ K) Thermoelementen zur Temperatur- und Differenztemperaturmessung mit CASSY (524 013, 524 006, 524 005W2, 524 018) oder den Universellen Messinstrumenten (531 835, 531 836, 531 837).
524 0673 NiCr-Ni-Adapter S, Typ K
Detaillierte Informationen zu diesen und anderen Sensoren finden Sie im Internet unter www.leybold-shop.de.
Hier finden Sie eine Übersicht über unsere Literaturpakete. Detaillierte Informationen zu unserer Literatur finden Sie im Internet unter www.leybold-shop.de.
THEMA FACHGEBIET

UNTERRICHTSFACH

Gedruckte Version EINES Fachgebietes in einem Ringordner
Ausführliche Versuchsanleitungen zum Science Lab Schub ECO (207 331S). Beschreibt 35 Versuche aus dem Fachgebiet Ökologie.
Versuchsthemen: Einführung in Methoden; Ökosysteme; Untersuchung von Ökosystemen; Mensch und Umwelt; Evolution
520 7331DE LIT-print: LB3 Ökologie
Ausführliche Versuchsanleitungen zum Unterrichtsfach Biologie im Science Lab. Beschreibt mehr als 170 Versuche zu den Fachgebieten Humanbiologie, Botanik, Ökologie, Zellbiologie, Genetik und Hygiene. Enthält alle interaktiven Versuchsanleitungen (Lab Docs) als html-Datei.
520 73 LIT-digital: LB Science Lab Biologie
Technische Daten der digitalen Version:
• Lieferung als Produktschlüssel (Aktivierung & Auswahl der Literatursprache über https://register.leylab.de notwendig)
• Systemvoraussetzungen:
Document Center: PC mit Windows 7 oder höher; Internetzugang während der Installation; lokales Netzwerk zur Verteilung an die Schüler
Leylab: PC, Tablet oder Smartphone mit gängigem Browser; Internetzugang

Chemikalien zur Durchführung der Schülerversuche im Science Lab Ökologie. Der Chemikaliensatz enthält 11 verschiedene Chemikalien, mit denen man jeden Versuch mindestens 10 mal durchführen kann.
679 330 Chemikalien Science Lab Ökologie
Die einzelnen Chemikalien aus diesem Satz finden Sie im Internet unter www.leybold-shop.de. Dort erfahren Sie ebenfalls mehr über die entsprechenden Gefahrensymbole und -klassen, den sicheren Umgang mit Chemikalien sowie die Gefahren- und Sicherheitshinweise.
Zusätzlich erforderlich pro Schülerin oder Schüler
Kat.-Nr. Artikelbezeichnung Bemerkung
610 010 Laborschutzbrille Focomax
Zusätzlich erforderlich pro Gruppe
Kat.-Nr. Artikelbezeichnung
524005W2 Mobile-CASSY 2 WLAN
5240673 NiCr-Ni-Adapter S, Typ K
MIK5738860 Mikroskop EduLed FLQ
Zusätzlich empfohlen pro Klasse
Kat.-Nr. Artikelbezeichnung
666 8036 Trockenschrank
MA90204 Universalindikatorpapier pH 1...14, Rolle
MA91201 Teststäbchen Gesamthärte
MA91313 Teststäbchen Nitrat/Nitrit
MA91315 Teststäbchen Ammonium
MA91320 Teststäbchen Phosphat
Zusätzlich empfohlen pro Gruppe
Kat.-Nr. Artikelbezeichnung Bemerkung
524 0671 Leitfähigkeits-Adapter S
524 0672 pH-Adapter S
524 444 Luxsensor M
529 670 Leitfähigkeits-Sensor
529 672 pH-Elektrode, BNC-Stecker
607 020 Sicherheitsgasschlauch mit Endmuffe, 0,5 m
656 7031 Teclubrenner, Propan
661 243 Spritzflasche PE 500 ml
666 1261 Temperaturfühler NiCr-Ni, schnell, Typ K
674 4640 Pufferlösung pH 4,00, 250 ml
674 4670 Pufferlösung pH 7,00, 250 ml
ADACB501 Kompaktwaage, 500 g : 0,1 g
Alle Lebewesen sind aus Zellen aufgebaut. Die Versuche zum Science Lab Schub Zellbiologie (CE) beginnen daher mit dem Aufbau von Einzellern und Mehrzellern.
Darüber hinaus ist auch das Innere der Zelle im Schulunterricht interessant.
Schülerinnen und Schüler können die Funktionen von Zellmembran und Enzymen untersuchen.

LB4.1.2.3 Vergleich zwischen einer tierischen und einer pflanzlichen Zelle
Anhand von qualitativ hochwertigen Mikropräparaten können die Unterschiede und Gemeinsamkeiten zwischen einer tierischen und einer pflanzlichen Zelle untersucht werden. Für diesen Versuch benötigen Sie die Schübe Science Lab Biologie Basis BB (207 300S) und Science Lab Zellbiologie CE (207 341S)
Weitere Informationen zu unseren lehrplankonformen Themen und Schülerversuchen sowie die dazugehörigen Schübe finden Sie auf den nachfolgenden Seiten.
VERSUCHSTHEMEN
LB4.1 AUFBAU DER ZELLE
LB4.2 VÖRGÄNGE IN DER ZELLE



LB4.2.3.3 Temperaturabhängige Enzymwirkung am Beispiel Katalase
In diesem Versuch wird die Temperaturabhängigkeit des Enzyms Katalase untersucht. Dafür wird die Spaltung von Wasserstoffperoxid durch Katalase bei verschiedenen Temperaturen durchgeführt. Es kann eine temperaturabhängige Gasentwicklung beobachtet werden. Für diesen Versuch benötigen Sie die Schübe Science Lab Biologie Basis BB (207 300S) und Science Lab Zellbiologie CE (207 341S)
LB4.0.0 Mikroskopie
LB4.0.0.1
LB4.0.0.2 Aufbau und Funktionsweise eines Lichtmikroskops Mikropräparate herstellen
LB4.1.1 Einzellige Lebewesen
LB4.1.1.1
LB4.1.1.2
LB4.1.1.3
Mikroskopieren von Hefezellen Mikroskopieren von Schimmelpilzen Lebend-Tot-Färbung von Hefezellen
LB4.1.2 Mehrzellige Lebewesen
LB4.1.2.1
LB4.1.2.2
LB4.1.2.3
LB4.1.2.4
Pflanzliche Zelle: Aufbau einer Zwiebelzelle Tierische Zelle: Zellen der Mundschleimhaut, ungefärbt Vergleich zwischen einer tierischen und einer pflanzlichen Zelle Färbung eines Zwiebelhäutchens
LB4.2 VORGÄNGE IN DER ZELLE
LB4.2.1 Die Zellmembran
LB4.2.1.1
LB4.2.1.2 Plasmolyse und Deplasmolyse Diffusion und Osmose
LB4.2.2 Zellzyklus
LB4.2.2.1 Mitosestadien von einer Zwiebelwurzel präparieren
LB4.2.3 Enzyme
LB4.2.3.1
LB4.2.3.2C
LB4.2.3.3
LB4.2.3.3C
LB4.2.3.4C
LB4.2.3.5 Wirkung des Enzyms Katalase aus Hefe Harnstoffspaltung durch Urease und Inhibierung (mit Mobile-CASSY 2 WLAN) Temperaturabhängige Enzymwirkung am Beispiel Katalase Enzymwirkung und Temperatur am Beispiel Katalase (mit Mobile-CASSY 2 WLAN) Temperaturabhängige Harnstoffspaltung durch Urease (mit Mobile-CASSY 2 WLAN) Enzymaktivität in Abhängigkeit vom pH-Wert
LB4.2.4 Stofftransport
LB4.2.4.1 Plasmaströmungen in der Wasserpest

ÜBERSICHT


Kat.-Nr. Bezeichnung
207 300S Science Lab Biologie Basis BB (Satz)
207 341S Science Lab Zellbiologie CE (Satz)
Eine Auswahl der Literaturpakete finden Sie auf den nachfolgenden Seiten.



Schülerexperimentiersatz des Schülerversuche-Systems Science Lab im Bereich Biologie. Aufbaumaterial für eine Arbeitsgruppe in gerätegeformter Aufbewahrung. Mit dem Gerätesatz CE können, zusammen mit dem Science Lab Biologie Basis BB (207 300S), mehr als 15 Versuche in der S I und S II durchgeführt werden.
Inhaltlich beschäftigen sich die Schülerinnen und Schüler mit den Bereichen Aufbau der Zelle und Vorgänge in der Zelle. Beim Bearbeiten der lehrplangeforderten Themen werden sie auch in den Kompetenzen Kommunikation und Bewertung geschult. In Verbindung mit dem Mobile-CASSY 2 WLAN (524 005W2) ergeben sich weitere Auswertemöglichkeiten, die digitales Lernen ermöglichen.
Lieferumfang:
Menge Kat.-Nr. Bezeichnung
3 602 022 Becherglas Boro 3.3, 100 ml, nF
1 647 002 Geräteschub, hoch
6 664 0421 Reagenzglas Fiolax 16 mm x 160 mm
1 664 131 Becherglas Boro 3.3, 400 ml, nF
1 665 009 Trichter PP, 75 mm Ø
2 665 997 Messpipette 10 ml
1 666 002 Pipettierhilfe 10 ml
1 667 091 Pistill 88 mm
1 667 092 Mörser Porzellan 70 mm Ø
6 667 253 Gummistopfen voll, 14...18 mm Ø
1 EU662100 Mikropräparate Set
207 341S Science Lab Zellbiologie CE (Satz)
Zusätzlich erforderlich:
Menge Kat.-Nr. Bezeichnung
1 207 300S Science Lab Biologie Basis BB (Satz)
1 520 73 LIT-digital: LB Science Lab Biologie
1 524 005W2 Mobile-CASSY 2 WLAN
1 675 3410 Wasser, rein, 5 l
1 679 360 Chemikalien Science Lab Zellbiologie
1 MIK5738860 Mikroskop EduLed FLQ
Zusätzlich empfohlen:
Menge Kat.-Nr. Bezeichnung
1 520 7341DE LIT-print: LB4 Zellbiologie
1 524 0671 Leitfähigkeits-Adapter S
1 529 670 Leitfähigkeits-Sensor
1 607 020 Sicherheitsgasschlauch mit Endmuffe 0,5 m
1 647 003 Deckel zu Geräteschub
1 656 7031 Teclubrenner, Propan
1 666 8471 Magnetrührer mit Heizplatte, rund
4 666 851 Magnetrührstäbchen 25 mm x 6 mm Ø, zylindrisch
1 MA90204 Universalindikatorpapier pH 1...14, Rolle


n 1 Schub und Basis-Schub für 19 Experimente
n enthält Mikroskopie-Versuche und Grundlagen zum Mikroskopieren
n Schwerpunkt auf Versuchen zur Enzymatik
n Einstieg in das digitale Messen und Auswerten möglich
SCHÜLERMESSGERÄT DIGITALER UNTERRICHT


Mobile-CASSY 2 WLAN
Das universelle Schülermessgerät mit WLAN für alle Messaufgaben in der Physik, Chemie und Biologie.
524 005W2 Mobile-CASSY 2 WLAN
Detaillierte Informationen zum Mobile-CASSY 2 WLAN finden Sie im Internet unter www.leybold-shop.de/524005W2
Temperaturfühler NiCr-Ni, schnell, Typ K
Bereits im Lieferumfang des Mobile-CASSY 2 WLAN (524 005W2) enthalten.
Detaillierte Informationen zu diesem und anderen Sensoren finden Sie im Internet unter www.leybold-shop.de.

Leitfähigkeits-Sensor
EMPFOHLENE SENSOREN
Sensor in Vierleitertechnik mit integriertem Pt-Temperatursensor; zur Verwendung mit der Chemie-Box (524 067) oder dem Leitfähigkeits-Adaper S (524 0671) zusammen mit CASSY (524 013, 524 006, 524 005W2, 524 018) oder dem Universellen Messinstrument Chemie (531 836). Offener Aufbau für schnelle Reaktion auf Leitfähigkeitsänderungen. Bei Messungen ist ein Mindestabstand von der Behälterwand von 1 cm, sowie eine Mindesteintauchtiefe von 2 cm einzuhalten.
529 670 Leitfähigkeits-Sensor

Leitfähigkeits-Adapter S
Ermöglicht zusammen mit dem Leitfähigkeits-Sensor (529 670) die Messung der Leitfähigkeit und der Temperatur mit CASSY (524 013, 524 006, 524 005W2, 524 018) oder dem Universellen Messinstrument Chemie (531 836).
524 0671
Leitfähigkeits-Adapter S
Detaillierte Informationen zu diesen und anderen Sensoren finden Sie im Internet unter www.leybold-shop.de.


pH-Adapter S
Ermöglicht den Anschluss einer pH-Elektrode an CASSY (524 013, 524 006, 524 005W2, 524 018) oder das Universelle Messinstrument Chemie (531 836). Zudem kann die Spannung an der BNC-Buchse sehr hochohmig gemessen werden, z.B. zur Messung elektrochemischer Potenziale.
524 0672 pH-Adapter S
pH-Elektrode, BNC-Stecker
pH-Kunststoffelektrode mit Kunststoffschaft und BNC-Stecker. Zur Verwendung mit der Chemie-Box (524 067) oder pH-Adapter S (524 0672) an CASSY (524 013, 524 006, 524 005W2, 524 018) oder dem Universellen Messinstrument Chemie (531 836). Wartungsarme pH-Elektrode mit Festelektrolyt aus einem leitenden gelartigen Polymer.
529 672
pH-Elektrode, BNC-Stecker
Zur Lagerung wird 3 M KCl empfohlen (672 5250).
Detaillierte Informationen zu diesen und anderen Sensoren finden Sie im Internet unter www.leybold-shop.de.
Hier finden Sie eine Übersicht über unsere Literaturpakete. Detaillierte Informationen zu unserer Literatur finden Sie im Internet unter www.leybold-shop.de.
THEMA FACHGEBIET

UNTERRICHTSFACH

LIT-print: LB4 Zellbiologie
Ausführliche Versuchsanleitungen zum Science Lab Schub CE (207 341S). Beschreibt 19 Versuche aus dem Fachgebiet der Zellbiologie.
Versuchsthemen:
Mikroskopie; Einzelllige Lebewesen; Mehrzellige Lebewesen; Die Zellmembran; Zellzyklus; Enzyme; Stofftransport
520 7341DE LIT-print: LB4 Zellbiologie
LIT-digital: LB Science Lab Biologie
Ausführliche Versuchsanleitungen zum Unterrichtsfach Biologie im Science Lab. Beschreibt mehr als 170 Versuche zu den Fachgebieten Humanbiologie, Botanik, Ökologie, Zellbiologie, Genetik und Hygiene. Enthält alle interaktiven Versuchsanleitungen (Lab Docs) als html-Datei.
520 73 LIT-digital: LB Science Lab Biologie
Technische Daten der digitalen Version:
• Lieferung als Produktschlüssel (Aktivierung & Auswahl der Literatursprache über https://register.leylab.de notwendig)
• Systemvoraussetzungen:
Document Center: PC mit Windows 7 oder höher; Internetzugang während der Installation; lokales Netzwerk zur Verteilung an die Schüler
Leylab:
- PC, Tablet oder Smartphone mit gängigem Browser; Internetzugang

Chemikalien Science Lab Zellbiologie
Chemikalien zur Durchführung der Schülerversuche im Science Lab Zellbiologie. Der Chemikaliensatz enthält 15 verschiedene Chemikalien, mit denen man jeden Versuch mindestens 10 mal durchführen kann.
679 360 Chemikalien Science Lab Zellbiologie
Die einzelnen Chemikalien aus diesem Satz finden Sie im Internet unter www.leybold-shop.de. Dort erfahren Sie ebenfalls mehr über die entsprechenden Gefahrensymbole und -klassen, den sicheren Umgang mit Chemikalien sowie die Gefahren- und Sicherheitshinweise.
Zusätzlich erforderlich pro Schülerin oder Schüler
Kat.-Nr. Artikelbezeichnung Bemerkung
610 010 Laborschutzbrille Focomax
Zusätzlich erforderlich pro Gruppe
Kat.-Nr. Artikelbezeichnung Bemerkung
524 005W2 Mobile-CASSY 2 WLAN
MIK5738860 Mikroskop EduLed FLQ
Zusätzlich empfohlen pro Klasse
Kat.-Nr. Artikelbezeichnung Bemerkung
MA90204 Universalindikatorpapier pH 1...14, Rolle
Zusätzlich empfohlen pro Gruppe
Kat.-Nr. Artikelbezeichnung Bemerkung
524 0671 Leitfähigkeits-Adapter S
529 670 Leitfähigkeits-Sensor
607 020 Sicherheitsgasschlauch mit Endmuffe, 0,5 m
656 7031 Teclubrenner, Propan
666 8471 Magnetrührer mit Heizplatte, rund
666 851 Magnetrührstäbchen 25 mm x 6 mm Ø, zylindrisch





Genetik und gentechnologische Methoden sind seit den1970er-Jahren in fast jedem biologischen Labor anzutreffen. Daher ist der Themenbereich auch für die Schule von großer Bedeutung. Die Versuche zum Science Lab Schub Genetik (GE) vermitteln Grundlagen zur Genetik und gentechnologischen Methoden. Neben der Methodik, vom Gießen eines DNA-Agarose-Gels bis zur Durchführung der Elektrophorese, können die Schülerinnen und Schüler verschiedene Anwendungen, z. B. genetischer Fingerabdruck oder Vaterschaftsanalyse kennenlernen.

In diesem Versuch wird ein Agarose-Gel mit Bromthymolblau angefärbt. Für diesen Versuch benötigen Sie den Schub Science Lab Biologie Genetik GE (207 351S)
DIE EXPERIMENTIERGERÄTE
LB5.1.1 GELELEKTROPHORESE VON DNA
LB5.1.2 VERSUCHS-KITS


LB5.1.1.2 Elektrophorese der DNA-Proben
In diesem Versuch werden DNA-Proben in einem Agarose-Gel aufgetrennt. Für diesen Versuch benötigen Sie den Schub Science Lab Biologie Genetik GE (207 351S)
Weitere Informationen zu unseren lehrplankonformen Themen und Schülerversuchen sowie die dazugehörigen Schübe finden Sie auf den nachfolgenden Seiten.
LB5.1.0 Die Experimentiergeräte
LB5.1.0.1
LB5.1.0.2
LB5.1.0.3
Die Elektrophoresekammer Das Netzgerät Die Mikroliterpipetten
LB5.1.1 Gelelektrophorese von DNA
LB5.1.1.1
LB5.1.1.2
LB5.1.1.3
Herstellen eines Agarose-Gels zur DNA-Analyse
Elektrophorese der DNA-Proben
Anfärben und Auswerten der Elektrophorese
LB5.1.2 Versuchs-Kits
LB5.1.2.1
LB5.1.2.2
LB5.1.2.3
LB5.1.2.4
Analyse bakterieller Plasmid-DNA
Elektrophorese von Lambda-DNA
Genetischer Fingerabdruck Die Vaterschaftsanalyse
Mit dem Science Lab Genetik GE können verschiedene DNA-Untersuchungen durchgeführt werden. Die DNA-Untersuchungen werden im folgenden beschrieben:
BEDK-004: DNA-Kit Bakterielle Plasmid-DNA

Bakterielle Plasmid-DNA ist ein ringförmiges DNA-Molekül, das in Bakterienzellen vorkommt. Plasmide sind extrachromosomale genetische Elemente, die zusätzliche genetische Informationen enthalten können. In gentechnologisch veränderten Bakterien wird die genetische Veränderung, z.B. eine Antiobitika-Resistenz, häufig über Plasmid-DNA eingebracht.
Die Untersuchung der bakteriellen Plasmid-DNA ist im Labor dann nötig, wenn überprüft werden soll, ob der Bakterien-Stamm die korrekte Plasmid-DNA enthält. Dafür verwendet man die Restriktionsenzym-Analyse. Restriktionsenzyme sind Proteine, die DNA an bestimmten Erkennungssequenzen schneiden können. Durch Zugabe des geeigneten Restriktionsenzyms kann das Plasmid in spezifische Fragmente geschnitten werden. Diese Fragmente können dann mittels Gelelektrophorese getrennt und analysiert werden. Die Restriktionsenzym-Analyse ermöglicht die Bestimmung der Größe des Plasmids sowie die Identifizierung spezifischer DNA-Sequenzen.
BEDK-005: DNA-Kit Elektrophorese von Lambda-DNA

Lambda-DNA ist die DNA des Bakteriophagen Lambda. Bakteriophagen sind Viren, die Bakterien infizieren können. Der Phage Lambda infiziert Escherichia coli-Bakterien. Die Lambda-DNA besteht aus einem doppelsträngigen linearen Molekül mit einer Länge von etwa 48.502 Basenpaaren. Es enthält eine Reihe von Genen, die für die Vermehrung des Phagen und die Wechselwirkung mit der Wirtszelle erforderlich sind.
Aufgrund der Eigenschaften der Lambda-DNA und ihrer Interaktion mit dem Wirtsbakterium hat sie sich zu einem wichtigen Modellsystem für die genetische Forschung entwickelt. Lambda-DNA wird häufig in Laboren verwendet, um DNA-Manipulationstechniken zu entwickeln, genetische Experimente durchzuführen oder die Regulation von Genen zu untersuchen.
LB5.1 Genetik
EXPERIMENTIERSCHUB


Detaillierte Information zu diesen und weiteren zusätzlich erforderlichen Produkten finden Sie auf den nachfolgenden Seiten.
BEDK-006: DNA-Kit Der genetische Fingerabdruck

Der genetische Fingerabdruck macht es möglich, Individuen anhand ihres genetischen Materials, insbesondere ihrer DNA, zu identifizieren und zu unterscheiden. Jeder Mensch hat eine einzigartige DNA-Sequenz, mit Ausnahme eineiiger Zwillinge. Diese Einzigartigkeit ermöglicht es, Personen anhand ihres genetischen Fingerabdrucks zu unterscheiden.
Der genetische Fingerabdruck basiert auf der Analyse spezifischer DNA-Bereiche. Die am häufigsten verwendete Methode zur Erstellung eines genetischen Fingerabdrucks ist die Polymerasekettenreaktion (PCR), mit der spezifische DNA-Abschnitte vervielfältigt werden können. Durch den Vergleich der DNAMuster an diesen Markern zwischen verschiedenen Proben, zum Beispiel einer Tatortprobe und einer Verdächtigenprobe, können Übereinstimmungen oder Unterschiede festgestellt werden. Es ist eine äußerst präzise Methode, um Individuen zu identifizieren und hat eine hohe Zuverlässigkeit in gerichtlichen Verfahren erreicht.
BEDK-007: DNA-Kit Vaterschaftsanalyse

Die Vaterschaftsanalyse ist ein Verfahren zur Bestimmung der biologischen Vaterschaft eines Kindes. Das Hauptziel der Vaterschaftsanalyse besteht darin, festzustellen, ob der getestete Mann das biologische Elternteil des Kindes ist oder nicht.
Die DNA-Muster des Kindes werden mit den DNA-Mustern der Mutter und des vermuteten Vaters verglichen. Wenn der vermutete Vater tatsächlich der biologische Vater ist, sollten bestimmte DNA-Marker im Kind vorhanden sein, die von beiden Elternteilen stammen.


Schülerexperimentiersatz des Schülerversuche-Systems Science Lab im Bereich Biologie. Aufbaumaterial für eine Arbeitsgruppe in gerätegeformter Aufbewahrung. Mit dem Gerätesatz GE können mehr als 10 Schülerversuche aus dem Bereich der Genetik aus der S II durchgeführt werden.
Inhaltlich beschäftigen sich die Schülerinnen und Schüler mit den Bereichen Genetik und Analysen der forensischen und medizinischen Diagnostik. Beim Bearbeiten der lehrplangeforderten Themen werden sie auch in den Kompetenzen Kommunikation und Bewertung geschult.
Der Gerätesatz GE dient dabei als Basis. Zusammen mit zusätzlichen DNA-Kits können die verschiedene Themen behandelt werden.
Lieferumfang:
Menge Kat.-Nr. Bezeichnung
1 604 5682 Pulverspatel Edelstahl 185 mm
1 647 002 Geräteschub, hoch
1 664 250 Erlenmeyerkolben Boro 3.3, 250 ml, eH
1 665 754 Messzylinder 100 ml, Kunststofffuß
1 666 0151 Färbeschale
Menge Kat.-Nr. Bezeichnung
1 666 019 Mikroliterpipette 2-20 µl
1 666 020 Mikroliterpipette 20-200 µl
1 666 022 Pipettenspitzen 20-200 µl, 96 Stück im Rack
1 BEEK-001 Elektrophoresekammer
207 351S Science Lab Genetik GE (Satz)

Zusätzlich erforderlich pro Schüler:in
Menge Kat.-Nr. Artikelbezeichnung
1 610 010 Laborschutzbrille
1 610 077 Nitril-Handschuhe, Größe M
Zusätzlich erforderlich pro Arbeitsgruppe
Menge Kat.-Nr. Artikelbezeichnung
1 ADACB501 Kompaktwaage 500 g : 0,1 g
1 BEDK-004 DNA-Kit Bakterielle Plasmid-DNA
1 BEDK-005 DNA-Kit Elektrophorese von Lambda-DNA
1 BEDK-006 DNA-Kit Genetischer Fingerabdruck
1 BEDK-007 DNA-Kit Vaterschaftsanalyse
1 BEPS-002 Netzgerät 300 V, 400 mA
Zusätzlich erforderlich pro Klasse
Menge Kat.-Nr. Artikelbezeichnung
1 520 73 LIT-digital: LB Science Lab Biologie
1 675 3410 Wasser, rein, 5 l
Bemerkung
Bemerkung
Bemerkung
n 1 Schub für 11 Experimente
n Experimente der modernen Biologie im Schülerversuch durchführen
n Methoden und Gerätekenntnis: Arbeit mit Geräten, die auch in biologischen Laboren stehen
n Anwendungsbezug durch die Verwendung von Versuchszusammenstellung zu Vaterschaftsanalysen und dem genetischen Fingerabdruck
n wenig Vorbereitungszeit durch die Lehrkraft nötig
LITERATURPAKETE
Hier finden Sie eine Übersicht über unsere Literaturpakete. Detaillierte Informationen zu unserer Literatur finden Sie im Internet unter www.leybold-shop.de.
LIT-print: LB5 Genetik

UNTERRICHTSFACH

Version EINES Fachgebietes in einem Ringordner
Ausführliche Versuchsanleitungen zum Science Lab Schub GE (207 351S). Beschreibt ausführlich die Arbeitsmethoden aus dem Fachgebiet Genetik - DNA-Untersuchungen. Es werden dabei DNA-Kits verwendet, die mit einer eigenen Versuchsanleitung ausgestattet sind.
Versuchsthemen:
Herstellen eines Agarose-Gels; Elektrophorese von DNA-Proben; Anfärben und Auswerten von DNA-Gelen; Arbeiten mit DNA-Kits (Anleitungen bei den Kits integriert)
520 7351DE LIT-print: LB5 Genetik
Ausführliche Versuchsanleitungen zum Unterrichtsfach Biologie im Science Lab. Beschreibt mehr als 170 Versuche zu den Fachgebieten Humanbiologie, Botanik, Ökologie, Zellbiologie, Genetik und Hygiene.
Enthält alle interaktiven Versuchsanleitungen (Lab Docs) als html-Datei.
520 73 LIT-digital: LB Science Lab Biologie
Technische Daten der digitalen Version:
• Lieferung als Produktschlüssel (Aktivierung & Auswahl der Literatursprache über https://register.leylab.de notwendig)
• Systemvoraussetzungen:
Document Center:
PC mit Windows 7 oder höher; Internetzugang während der Installation; lokales Netzwerk zur Verteilung an die Schüler
Leylab:
PC, Tablet oder Smartphone mit gängigem Browser; Internetzugang





Die Versuche zum Science Lab Schub Hygiene (HY) beschäftigen sich mit mikrobiologischen Arbeitsmethoden sowie mit Experimenten aus den Themen Verbreitung von Mikroorganismen und Prävention.
Hygiene ist wichtig, um die Verbreitung von Bakterien und anderen Mikroorganismen zu vermeiden. Unsere Schülerversuche zeigen, wie sich Krankheitserreger ausbreiten, wie man die Kontamination und Ausbreitung nachweist und wie man durch Desinfektion und Prävention eine Ausbreitung verhindern kann.

LB6.1.3.1
In diesem Experiment bestimmen die Schülerinnen und Schüler die Keimzahl in der Luft. Dafür verwenden sie sterile Agar-Platten und lernen dabei, dass die Keimzahl abhängig vom Untersuchungsort ist. Für diesen Versuch benötigen Sie den Schub Science Lab Biologie Hygiene HY (207 361S)
VERSUCHSTHEMEN
LB6.1.1 EINFÜHRUNG IN MIKROBIOLOGISCHE METHODEN
LB6.1.2 ÜBERTRAGUNGSWEGE VON KRANKHEITSERREGERN
LB6.1.3 KEIMZAHLBESTIMMUNGEN
LB6.1.4 PRÄVENTION UND DESINFEKTION

LB6.1.2.3 Simulation einer Infektionskette mit Bäckerhefe
In diesem Experiment simulieren die Schülerinnen und Schüler den Verlauf einer Infektionskette als Voraussetzung für die Ausbreitung jeder Infektionskrankheit. Dafür wird als Modell-Organismus Bäckerhefe verwendet. Für diesen Versuch benötigen Sie den Schub Science Lab Biologie Hygiene HY (207 361S)
Weitere Informationen zu unseren lehrplankonformen Themen und Schülerversuchen sowie die dazugehörigen Schübe finden Sie auf den nachfolgenden Seiten.
LB6.1.1 Einführung in mikrobiologische Methoden
LB6.1.1.1
LB6.1.1.2
LB6.1.1.3
Bereitung und Sterilisation von Nährmedien
Sterilisation und Reinigung von Geräten und Nährböden
Keimzahlbestimmmung durch Erstellung einer Verdünnungsreihe
LB6.1.2 Übertragungswege von Krankheitserregern
LB6.1.2.1
LB6.1.2.2
LB6.1.2.3
LB6.1.2.4
LB6.1.2.5
LB6.1.2.6
Bestimmung des Keimgehaltes an Geldscheinen und Geldmünzen Vergleich des Keimgehaltes an gewaschenen und ungewaschenen Händen
Simulation einer Infektionskette mit Bäckerhefe
Übertragungsweg beim Händeschütteln mit UV-Licht
Simulation der Verbreitung von Krankheitserregern Nachweis von Mikroorganismen an verschiedenen Objekten
LB6.1.3 Keimzahlbestimmungen
LB6.1.3.1
LB6.1.3.2
LB6.1.3.3
LB6.1.3.4
Keimzahlbestimmung in der Luft Bestimmung der Keimzahl im Boden Keimzahlbestimmung in der Milch Bestimmung der Keimzahl im Wasser
LB6.1.4 Prävention und Desinfektion
LB6.1.4.1
LB6.1.4.2
LB6.1.4.3
LB6.1.4.4
LB6.1.4.5
LB6.1.4.6
LB6.1.4.7
LB6.1.4.8
Bakteriostatische Wirkung von verschiedenen Hausmitteln Bakteriostatische Wirkung von Lysozym Nachweis der Wirkung von UV-Strahlen UV-Inaktivierung und Photoreaktivierung bei Bakterien Herstellung von Desinfektionsmittel Simulation gründlicher Handhygiene mit UV-Strahlung Abhängigkeit des Desinfektionsgrades von der Ethanolkonzentration Antibakterielle Seife oder normale Seife

Die Schülerinnen und Schüler stellen verschiedene Desinfektionsmittel in kleinem Maßstab her. Sie lernen die typische Zusammensetzung eines Desinfektionsmittels kennen und Möglichkeiten, ein solches auch mit einfachen Hausmitteln herzustellen. Für diesen Versuch benötigen Sie den Schub Science Lab Biologie Hygiene HY (207 361S)
ÜBERSICHT BENÖTIGTES MATERIAL UM EXPERIMENTE DURCHZUFÜHREN
LB6.1 Hygiene





Schülerexperimentiersatz des Schülerversuche-Systems Science Lab Biologie im Bereich Hygiene und Mikroorganismen. Aufbaumaterial für eine Arbeitsgruppe in gerätegeformter Aufbewahrung. Mit dem Gerätesatz HY können etwa 20 Schülerversuche in der S I und S II durchgeführt werden.
Inhaltlich beschäftigen sich die Schülerinnen und Schüler mit mikrobiologischen Arbeitsmethoden sowie mit Experimenten aus den Themen Verbreitung von Mikroorganismen und Prävention. Beim Bearbeiten der kontextorientierten Themen werden sie auch in den Kompetenzen Kommunikation und Bewertung geschult.
Lieferumfang:
Menge Kat.-Nr. Bezeichnung
1 309 45 Allschreibstift
1 602 022 Becherglas Boro 3.3, 100 ml, nF
1 604 5682 Pulverspatel Edelstahl 185 mm
1 647 002 Geräteschub, hoch
1 661 035 Rundfilter Sorte 595, 125 mm Ø, Satz 100
1 662 334 Drigalski-Spatel, Glas
6 664 0421 Reagenzglas Fiolax 16 mm x 160 mm
1 664 154 Uhrglas 80 mm Ø
3 664 183 Petrischale, Glas, Ø 100 mm, Höhe 20 mm
1 665 212 Glasrührstab 200 mm x 8 mm Ø
1 665 6353 UV-Handlampe
Menge Kat.-Nr. Bezeichnung
3 665 9531 Tropfpipette 150 mm x 7 mm Ø
3 665 9541 Pipettenhütchen
1 665 994 Messpipette 1 ml
1 665 997 Messpipette 10 ml
1 666 003 Pipettierball (Peleusball)
1 666 966 Löffelspatel, 180 mm
1 667 018 Labormesser
1 667 027 Pinzette, vernickelt, stumpf, 130 mm
1 667 057 Reagenzglasgestell Metall, 20 mm Ø
Hygiene HY (Satz)

n 1 Schub für 21 Experimente
n Chemikaliensatz für mindestens 10-malige Durchführung aller Versuche
n zur Vertiefung der Thematik auch für Projekt- oder Wahlunterricht geeignet

Zusätzlich erforderlich pro Schüler:In
Menge Kat.-Nr. Artikelbezeichnung
1 610 010 Laborschutzbrille
Zusätzlich erforderlich pro Arbeitsgruppe
Menge Kat.-Nr. Artikelbezeichnung
1 607 020 Sicherheitsgasschlauch, 0,5 m
1 656 017 Teclubrenner, Allgas
1 662 1131 Desinfektions-Spray
1 662 460 Ätherische Öle Set
4 685 44 Batterie 1,5 V (Mignon)
1 ADACB501 Kompaktwaage 500 g : 0,1 g
Zusätzlich erforderlich pro Klasse
Bemerkung
Bemerkung
Menge Kat.-Nr. Artikelbezeichnung Bemerkung
1 520 73 LIT-digital: LB Science Lab Biologie
1 679 361 Chemikalien Science Lab Hygiene

Chemikalien Science Lab Hygiene
Chemikalien zur Durchführung der Schülerversuche im Science Lab Hygiene. Der Chemikaliensatz enthält 16 verschiedene Chemikalien, mit denen man jeden Versuch mindestens 10 mal durchführen kann.
679 361 Chemikalien Science Lab Hygiene
Die einzelnen Chemikalien aus diesem Satz finden Sie im Internet unter www.leybold-shop.de.
Dort erfahren Sie ebenfalls mehr über die entsprechenden Gefahrensymbole und -klassen, den sicheren Umgang mit Chemikalien sowie die Gefahren- und Sicherheitshinweise.
Hier finden Sie eine Übersicht über unsere Literaturpakete. Detaillierte Informationen zu unserer Literatur finden Sie im Internet unter www.leybold-shop.de.
Gedruckte Version EINES Fachgebietes in einem Ringordner

UNTERRICHTSFACH

LIT-print: LB6.1 Science Lab Hygiene
Ausführliche Versuchsanleitungen zum Science Lab Schub Hygiene HY (207 361S). Beschreibt etwa 20 Versuche aus dem Fachgebiet Hygiene und Mikroorganismen.
Versuchsthemen:
Einführung in die Methoden; Übertragungswege; Keimzahlbestimmungen; Einfluss auf das Wachstum von Mikroorganismen; Desinfektion
520 7361DE LIT-print: LB Science Lab Hygiene
LIT-digital: LB Science Lab Biologie
Ausführliche Versuchsanleitungen zum Unterrichtsfach Biologie im Science Lab. Beschreibt ca. 170 Versuche zu den Fachgebieten Humanbiologie, Botanik, Ökologie, Zellbiologie, Genetik und Hygiene.
Enthält alle interaktiven Versuchsanleitungen (Lab Docs) als html-Datei.
520 73 LIT:-digital: LB Science Lab Biologie
Technische Daten der digitalen Version:
• Lieferung als Produktschlüssel (Aktivierung & Auswahl der Literatursprache über https://register.leylab.de notwendig)
• Systemvoraussetzungen: Document Center: PC mit Windows 7 oder höher; Internetzugang während der Installation; lokales Netzwerk zur Verteilung an die Schüler Leylab: PC, Tablet oder Smartphone mit gängigem Browser; Internetzugang





Wie können wir die Ausbreitung von Bakterien eindämmen?


Hygiene ist ein wichtiges Thema im Alltag, insbesondere in Schulen. Bakterien und andere Mikroorganismen können sich schnell verbreiten und Infektionen verursachen.
Deshalb sollten Schülerinnen und Schüler regelmäßig über Hygienepraktiken informiert werden und diese auch in der Schule üben.
Ein einfacher Schülerversuch kann zeigen, wie schnell sich Bakterien auf Oberflächen ausbreiten können. Dazu öffnet man eine Petrischale mit Nährmedium und legt sie für einige Sekunden auf eine Oberfläche wie z.B. ein Türgriff oder einen Schulranzen. Nach ein paar Tagen kann man beobachten, wie sich Bakterien auf der Petrischale vermehrt haben.

Geldscheine und Münzen können mit Bakterien und anderen Mikroorganismen kontaminiert sein, da sie oft von vielen verschiedenen Menschen berührt werden. Studien haben gezeigt, dass auf Geldscheinen und Münzen eine Vielzahl von Bakterien, Viren und anderen Mikroorganismen gefunden werden können.
Um die Sichtbarkeit der Bakterien auf Geldscheinen und Münzen zu erhöhen, kann man eine Schwarzlichtlampe verwenden. Die meisten Bakterien fluoreszieren unter UV-Licht und werden somit sichtbar. Wenn man eine Schwarzlichtlampe auf Geldscheine und Münzen richtet, kann man die Stellen erkennen, an denen sich besonders viele Bakterien befinden.

Um die Verbreitung von Bakterien und anderen Mikroorganismen zu vermeiden, ist es wichtig, regelmäßig die Hände zu waschen und gegebenenfalls Desinfektionsmittel zu verwenden. Auch das Reinigen von Oberflächen und Gegenständen kann dazu beitragen, die Ausbreitung von Bakterien zu reduzieren.
Insgesamt ist die Prävention von Infektionen durch Hygienepraktiken eine wichtige Maßnahme, um unsere Gesundheit effektiv zu schützen.

WAS IST EINE BLOCKWEISE AUFBEWAHUNG?
Schülerexperimentierblocks des Schülerversuche-Systems Science Lab im Bereich Biologie. Aufbaumaterial für bis zu 16 Arbeitsgruppen in nach Geräten sortierter Aufbewahrung. Von 4 bis 16 Arbeitsgruppen verfügbar.
WIE FUNKTIONIERT UNSERE BLOCKWEISE AUFBEWAHRUNG?



Unsere Empfehlung:




2 - 3 Schülerinnen oder Schüler in einer Gruppe
Beispielsituation 1

BEISPIEL:
Klassenstärke: 20 Schüler
Gruppenstärke: 2 Schüler
Anzahl Gruppen: 10 10-fach



Die Klasse besteht aus 20 Schülerinnen und Schülern und möchte sich Science Lab Botanik BO (207 321S) anschaffen. Der Science Lab Chemie Basis-Schub BB (207 300S) wird ebenfalls benötigt.


20 : = 10

Kat.-Nr.
Die gleiche Klasse möchte zusätzlich Science Lab Ökologie ECO (207 331S) und Science Lab Zellbiologie CE (207 341S) anschaffen. Der Science Lab Chemie Basis-Schub CB (207 300S) wird für beide benötigt.


20 : = 10

Kat.-Nr.
*Der Basisschub muss nicht erneut angeschafft werden, da er bereits aus dem ersten Kauf 10 x für die Gruppenstärke vorhanden ist.
Detaillierte Informationen zu unserer satz- und blockweisen Aufbewahrung finden Sie auf den S. 8 + 9.



Kat.-Nr.
207 300xx Science Lab Biologie Basis BB
207 311xx Science Lab Humanbiologie HU1
207 312xx Science Lab Humanbiologie HU2


Kat.-Nr. Bezeichnung
207
207 321xx Science Lab Botanik BO


207 300xx Science Lab Biologie Basis BB
207 331xx Science Lab Ökologie ECO


Kat.-Nr. Bezeichnung
207 300xx Science Lab Biologie Basis BB
207 341xx Science Lab Zellbiologie CE
Die folgende Übersicht zeigt, welche Chemikalien für die einzelnen Themengebiete benötigt werden. Die H-Sätze und P-Sätze sowie die GHSPiktogramme werden am Ende der Tabellen erläutert.

1200 1-Pentanol, 100 ml
674 4310 1-Propanol, 250 ml
674 4320 1-Propanol, 1 l
671 1210 2-Butanol, 1 l x
673 4510 2-Naphthol, 100 g
673 9390 2-Nitrobenzaldehyd, 5 g
674 4410 2-Propanol, 1 l
0400 Aceton, 250 ml
670 1600 Agar-Agar, 50 g x








670 2010 Aktivkohle, gekörnt, 250 g x -
670 2020 Aktivkohle, gekörnt, 500 g x
670 2390 Aluminium, Blech, 50 g x x
670 2500 Aluminium, Grieß, 100 g x
670 3110 Ameisensäure, 98%-100%, 250 ml x
670 3600 Ammoniaklösung, 25 %, 250 ml x x













670 3650 Ammoniaklösung, verd., 2 mol/l, 500 ml x x x x GHS05
670 4900 Ammoniumsulfat, 250 g x -
670 5200 Ammoniumthiocyanat, 50 g x GHS07

670 7200 Bariumchlorid, 100 g x GHS06

670 7300 Bariumchloridlösung, 10 %, 100 ml x GHS07
670 7410 Bariumhydroxid-Octahydrat, 250 g x




670 8200 Benzin, 90...110 °C, 250 ml x GHS02
670 8210 Benzin, 100...140 °C, 500 ml x x x




670 8300 Benzoesäure, 50 g x GHS07
671 0350 Bromid-/Bromatlösung, 500 ml x x -
671 0800 Bromthymolblau-Lösung, 0,1%, 50 ml x -


671 1300 tert.-Butanol, 100 ml x GHS02 GHS05
671 2000 Calcium, 25 g x GHS02

671 2310 Calciumcarbonat, gefällt, 500 g x x x -
671 2400 Calciumchlorid, gekörnt, 100 g x GHS07
671 2900 Calciumhydroxid, 50 g x x x




671 2950 Calciumhydroxidlösung, gesättigt, 250 ml x GHS05
671 2960 Calciumhydroxidlösung, gesättigt, 1 l x GHS05

671 3200 Calciumoxid, Pulver, 100 g x GHS05
671 4910 Chlorzinkiodlösung, 50 ml
671 5600 Citronensäure-1-hydrat, 100 g x x
671 5700 Cyclohexan, 250 ml x







671 5910 Cyclohexen, 100 ml x GHS02
671 6620 2,6-Dichlorphenolindephenol, Natriumsalz, 1 g x
671 8250 Eisen Pulver, grob, 250 g x
671 8300 Eisen Pulver, reduziert, 50 g x
671 8410 Eisen, Wolle, 200 g x x
671 8700 Eisen(III)-chlorid-6-hydrat, 50 g x x
671 9000 Eisen(III)-oxid, 100 g x




671 9100 Eisen(II)-sulfat-7-hydrat, 100 g x x x GHS07
671 9500 Essigsäure, 99%-100%, 250 ml x x GHS02










Achtung
Achtung





671 9550 Essigsäure, verd (ca. 2 mol/l), 500 ml x x x x x
671 9570 Essigsäure, 0,1 mol/l, 1 l x
671 9590 Essigsäure, 1 mol/l, 1 l x
671 9630 Essigsäureethylester, 250 ml x
671 9640 Essigsäureethylester, 500 ml x
671 9720 Ethanol, Lösungsmittel, 1 l x x x
671 9740 Ethanol, Lösungsmittel, 250 ml x
671 9800 Ethylenglykol, 250 ml x
671 9900 Fehlingsche Lösung I, 100 ml x x
672 0000 Fehlingsche Lösung II, 100 ml








672 0700 D(-)-Fructose, 50 g x -
672 0970 Gips gebrannt, rein, 500 g x
672 0980 Gips gebrannt, rein, 1 kg x
672 1000 Glaswolle, 10 g x
672 1010 Glaswolle, 100 g x -
672 1100 D(+)-Glucose, 100 g x x x
672 1110 D(+)-Glucose, 250 g x -
672 1120 D(+)-Glucose, 1 kg x
672 1190 Glyzerin, 99 %, 50 ml x -
672 1200 Glycerin, 99 %, 100 ml x x x x x
672 1300 Glycin (Glykokoll), 50 g x
672 1700 Harnstoff, 100 g x x
672 1740 Heizöl, 250 ml x
672 1800 n-Heptan, 50 ml x
672 2490 Holzkohle, kleine Stücke, 500 g x
672 2520 Holzstäbchen, 100 St. x x x x x

672 3400 Indigokarmin, 10 g x -
672 3700 Iod, 25 g x x
672 3911 Iod-Kaliumiodidlösung nach Lugol, 1 l x
672 3920 Iod-Kaliumiodidlösung nach Lugol, 50 ml x x










672 3900 Iod-Kaliumiodidlösung nach Lugol, 100 ml x GHS08
672 4900 Kaliumbromid, 50 g x GHS07

672 4930 Kaliumbromidlösung, 1 M, 250 ml x -
672 5000 Kaliumcarbonat, 100 g x GHS07

672 5200 Kaliumchlorid, 100 g x x -
672 5520 Kaliumcitrat-Monohydrat, 100 g x
672 6000 Kaliumhexacyanoferrat(II), 50 g x -
672 6100 Kaliumhexacyanoferrat(III), 50 g x -
672 6200 Kaliumhydrogenphosphat, 50 g x
672 6320 Kaliumhydrogentartrat, 250 g x -


672 6400 Kaliumhydroxid, 250 g x GHS05 GHS07
672 6600 Kaliumiodid, 25 g x
672 6630 Kaliumiodid, 250 g x -
672 6670 Kaliumiodidlösung, 1 M, 250 ml x
672 6710 Kaliumnatriumtartrat, 250 g x -
672 6810 Kaliumnitrat, 250 g x GHS03

672 6850 Kaliumnitratlösung, ca. 1 mol/l, 250 ml x -


672 7000 Kaliumpermanganat, 100 g x x x x GHS03 GHS07
672 7400 Kaliumthiocyanat, 100 g x GHS07

672 7660 Karminessigsäure, 50 ml x GHS07
672 8600 Kupfer, Blech, 50 g





H225 H319 EUH066 H336
H225 H319 EUH066 H336
H225
672 8620 Kupfer, Blech, 250 g x -
672 8800 Kupfer, Pulver, 50 g x x
672 9100 Kupfer(II)-chlorid, 50 g x
672 9500 Kupfer(II)-oxid, Pulver, 50 g x x
672 9510 Kupfer(II)-oxid, Pulver, 100 g x
672 9600 Kupfer(II)-sulfat-5-hydrat, 100 g x x
672 9630 Kupfer(II)-sulfat-5-hydrat, 500 g x
672 9650 Kupfersulfatlösung 1 %, 50 ml x
672 9660 Kupfersulfatlösung, ca. 1 mol/l (= 15 %), 500 ml x x
673 0830 Lysozym, 2,5 g x







673 0840 Magnesiastäbchen, 25 Stück x x x -
673 1000 Magnesium, Band, 25 g x x
673 1100 Magnesium, Pulver, 50 g x
673 1150 Magnesium, Späne, 50 g x x









673 1230 Magnesiumchlorid-Lösung, ca. 1 M, 250 ml x -
673 1500 Magnesiumoxid, 50 g x -
673 1600 Magnesiumsulfat-7-hydrat, 100 g x
673 2200 Mangan(IV)-oxid, (Braunstein), 100 g x
673 2210 Mangan(IV)-oxid, (Braunstein), 500 g x
673 2500 Marmor, Stücke, 250 g x
673 2720 Methanol, 1 l x
673 2920 Methylenblaulösung nach Löffler, 100 ml x x x




673 3050 Methylorangelösung, 100 ml x x -
673 5000 Natriumacetat-3-hydrat, 50 g x -
673 5600 Natriumcarbonat, wasserfrei, 100 g x





673 5610 Natriumcarbonat, wasserfrei, 250 g x x GHS07

673 5700 Natriumchlorid, 250 g x x x x -
673 5720 Natriumchlorid, 1 kg x x -
673 5740 Natriumchloridlösung, ca. 1 M, 500 ml x
673 6300 Natriumdithionit, 25 g x



673 6600 Natriumhydrogencarbonat, 250 g x -
673 6610 Natriumhydrogencarbonat, 500 g x -

673 6310 Natriumdithionit, 250 g x GHS02 GHS07
673 6780 Natriumhydrogensulfitlösung 40%, 250 ml x GHS07

673 6800 Natriumhydroxid, Plätzchen, 100 g x x GHS05

673 6810 Natriumhydroxid, Plätzchen, 250 g x GHS05

673 6830 Natriumhydroxid, Plätzchen, 500 g x GHS05



673 7100 Natriumnitrit, 50 g x GHS03 GHS06
673 7410 tri-Natriumphosphat-12-hydrat, 250 g x GHS07

673 7600 Natriumsulfat-10-hydrat, 100 g x -
673 7800 Natriumsulfit, 100 g x x
673 8000 Natriumthiosulfat-5-hydrat, 100 g x x -
673 8010 Natriumthiosulfat-5-h., 250 g x x -
673 8400 Natronlauge, verd., ca. 2M, 500 ml x x x GHS05

673 8410 Natronlauge, 0,1 mol/l, 500 ml x GHS05

673 8411 Natronlauge, 0,1 mol/l, 1 l x x GHS05

673 8420 Natronlauge, 1 mol/l, 500 ml x x x x x GHS05

673 8421 Natronlauge, 1 mol/l, 1 l x x GHS05

674 0000 Ölsäure, 50 ml x -

674 0700 Paraffin, fest, 100 g x x -

674 0620 Pankreatin, 25 g x GHS07 GHS08
P273 P391 P501 Achtung
H302 H410 P273 Achtung
H302 H410
H302 H410
H302 H319 H315 H410
P260 P273 Achtung
P260 P273 Achtung
P273 P302+P352 P305+P351+P338 Achtung
H302 H319 H315 H410 P273 P302+P352 P305+P351+P338 Achtung
H315 H304
P301+P310 P331 O280 P302+P352 Gefahr H319 H315 H410 P273 P305+P351+P338 P302+P352 Achtung
P370+P378 Achtung
H260 H250 P210 P370+P378 P402+P404 Gefahr
H228 H261 H252 P210 P402+P404 Gefahr

GHS08 H225 H301 H311 H331 H370 P210 P233 P280 P302+P352 P309+P310 Gefahr H226 H319
P280 P305+P351+P338 P337+P313 Achtung
P305+P351+P338
P305+P351+P338 Achtung
H314 H290 P280 P301+P330+P331 P309+P310 P305+P351+P338 Gefahr
H314 H290
P280 P301+P330+P331 P309+P310 P305+P351+P338 Gefahr H314 H290
P280 P301+P330+P331 P309+P310 P305+P351+P338 Gefahr

GHS09 H272 H301 H400
P273 P309+P310 Gefahr H319 H315
P302+P352 P305+P351+P338 Achtung
H314 H290
P280 P303+P361+P353 P305+P351+P338 P310 P301+P330+P331 Gefahr H290
H290
H314 H290
H314 H290
H315 H319 H335 H317 H334
P234 P390 Achtung
P234 P390 Achtung
P280 P301+P330+P331 P305+P351+P338 P309+P310 Gefahr
P280 P301+P330+P331 P305+P351+P338 P309+P310 Gefahr
P280 P302+P352 P304+P341 P342+P311 P305+P351+P338 Gefahr
674 0800 Paraffin, dickflüssig, 100 ml x
674 1420 Pepsin für die Bioch., 25 g x
674 2000 Perlkatalysator, 500 g x
674 2200 Petroleumbenzin, 40...70 °C, 250 ml x
674 2500 Phenolphthaleinlösung, 1%, 100 ml
674 3440 Phosphorsäure, 10 %, 100 ml x
674 4050 Plate-Count-Agar, für 1 l (=25g) x
674 4450 Propanal, 100 ml x
674 4510 Propionsäure, 250 ml x
674 4950 Quarzsand, 100 g x
674 5700 Resorcin, 50 g
674 5840 Rohöl, künstlich, 1 l x
674 6050 D(+)-Saccharose, 100 g x x







674 6060 D(+)-Saccharose, 250 g x x -
674 6650 Salpetersäure verd., ca. 2 mol/l, 500 ml x x
674 6750 Salzsäure konz., 25 %, 250 ml
674 6800 Salzsäure, 10 %, 500 ml x
674 6810 Salzsäure, 10 %, 1 l x













674 6900 Salzsäure, 1 mol/l, 500 ml x x x x GHS05
674 6910 Salzsäure, 1 mol/l, 1 l x x

674 6920 Salzsäure, ca. 2 mol/l, 500ml x x GHS05

674 6960 Salzsäure, 0,1 mol/l, 1 l x x GHS05

674 7350 Schiffs Reagenz, 250 ml x GHS05

674 7610 Schwefel, sublimiert, 500 g x x GHS07

674 7850 Schwefelsäure, 95-98 %, 250 ml x GHS05

674 7891 Schwefelsäure, 35 %, 1 l x GHS05

674 7900 Schwefelsäure, 5 mol/l, 100 ml x GHS05

674 7920 Schwefelsäure, verd., ca. 2 N, 500 ml x x x x GHS05

674 7950 Schwefelsäure, 0,5 mol/l, 1l x x GHS05

674 8200 Seesand, gereinigt, 250 g x x -
674 8210 Seesand, gereinigt, 1 kg x -
674 8211 Seesand, gereinigt, 500 g x -
674 8710 Silbernitratlösung, 5 %, 100 ml x x
674 8800 Silbernitratlösung, 0,1 mol/l, 250 ml x
674 8810 Silbernitratlösung, 0,1 mol/l, 1 l x
674 9040 Silikon-Hochvakuumfett, 75 g x
674 9050 Silikonöl, 100 ml x
674 9100 Sorbinsäure, 25 g x
674 9200 Stärke, löslich, 100 g x
674 9210 Stärke, löslich, 250 g x
674 9220 Stärke, löslich, 50 g x x
674 9520 Styropor P (BASF), 100 g x
674 9680 Sudanschwarz, 1 g x x








674 9710 Sulfanilsäure, 50 g x GHS07
675 1650 Tillmans Reagenz, 50 ml x
675 2530 L(-)-Tyrosin, 25 g x


675 1600 Thymolphthaleinlösung, 0,1 %, 50 ml x GHS02 GHS07

675 2800 Urease (1 U/mg), 1 g
675 3100 Vaseline, 50 g
675 3270 Vitamin C, 50 g

675 2570 Universalindikator, flüssig, 100 ml x GHS02 GHS07
H-SÄTZE
H315 H319 H335 H334

P302+P352 P304+P341 P305+P351+P338 P342+P311 Gefahr

P210 P240 P273 P301+P310 P331 P403+P235 Gefahr
GHS07 GHS09 H225 H304 H315 H336 H411 EUH066
H225 H350 H341
H315 H319
H225 H315 H319 H335
P210 P233 P281 P308+P313 Gefahr
P280 P302+P352 P305+P351+P338 P313 Achtung
P210 P233 P302+P352 P304+P340 P305+P351+P338 Gefahr H314 P280 P301+P330+P331 P305+P351+P338 P309+P310 Gefahr
H302 H315 H319 H400
P273 P302+P352 P305+P351+P338 Achtung
H314 H290
H314 H335 H290
H315 H319 H335 H290
H315 H319 H335 H290
P280 P305+P351+P338 P309+P310 P301+P330+P331 Gefahr
P280 P301+P330+P331 P309+P310 P305+P351+P338 Gefahr
P280 P261 P304+P340 P305+P351+P338 P312 P403+P233 Achtung
P280 P261 P304+P340 P305+P351+P338 P312 P403+P233 Achtung
H290 P390 Achtung
H290 P390 Achtung
H290 P390 Achtung
H290 P390 Achtung
H290 P234 P262 Achtung H315 P302+P352 Achtung
H314 H290
H290 H314
H290 H314
H290 H315 H319
P280 P301+P330+P331 P309 P310 P305+P351+P338 Gefahr
P260 P280 P301+P330+P331 P305+P351+P338 P310 Gefahr
P280 P301+P330+P331 P309 P310 P305+P351+P338 Gefahr
P280 P305+P351+P338 P337+P313 P302+P352 Achtung H290 - Achtung
H314 H410
H315 H319 H410
H315 H319 H410
H315 H319 H335
P280 P273 P302+P352 P305+P351+P338 P332+P313 P337+P313 Gefahr
P280 P273 P302+P352 P305+P351+P338 P332+P313 P337+P313 Achtung
P280 P273 P302+P352 P305+P351+P338 P332+P313 P337+P313 Achtung
P302+P352 P305+P351+P338 Achtung
H315 H319 H317
H226 H319
H225 H319
P280 P302+P352 P305+P351+P338 Achtung
P210 P280 P305+P351+P338 P337+P313 Achtung
P210 P280 P305+P351+P338 P337+P313 Gefahr

675 3500 Wasserstoffperoxid, 30 %, 250 ml x x x x GHS05


675 3520 Wasserstoffperoxid, 5 %, 50 ml x GHS07
675 3550 Watte, 200 g x x x x x x -
675 4800 Zink, gekörnt, 100 g x x -
675 4900 Zink, Pulver, 100 g x x

675 5000 Zink, Stäbchen, 100 g x -
675 5110 Zinkchlorid, trocken, 250 g x



675 5220 Zinkiodid-Lösung, 50 %, 50 g x GHS07
675 5300 Zinkoxid, 50 g x GHS09
675 5410 Zinksulfat-7-hydrat, 250 g x

675 5510 Zinksulfatlösung, 1 mol/l, 500 ml x GHS07

675 5700 Zinn, Folie, 100 x 0,10 mm, 50 g x x -

SICHERHEITSHINWEISE
Die Gefahrenhinweise werden gemäß der Zuordnung nach Anhang I, Teil 2, 3 und 4 der CLP-Verordnung angewendet. Gefahrenhinweise in allen EG-Sprachen sind Anhang III, Teil 1 der CLP-Verordnung zu entnehmen.
H-SÄTZE ERKLÄRUNG
GEFAHRENHINWEISE FÜR PHYSIKALISCH-CHEMISCHE GEFAHREN
H200 Instabil, explosiv.
H201 Explosiv, Gefahr der Massenexplosion.
H202 Explosiv; große Gefahr durch Splitter, Spreng- und Wurfstücke.
H203 Explosiv; Gefahr durch Feuer, Luftdruck oder Splitter, Spreng- und Wurfstücke.
H204 Gefahr durch Feuer oder Splitter, Spreng- und Wurfstücke.
H205 Gefahr der Massenexplosion bei Feuer.
H220 Extrem entzündbares Gas.
H221 Entzündbares Gas.
H222 Extrem entzündbares Aerosol.
H223 Entzündbares Aerosol.
H224 Flüssigkeit und Dampf extrem entzündbar.
H225 Flüssigkeit und Dampf leicht entzündbar.
H226 Flüssigkeit und Dampf entzündbar.
H228 Entzündbarer Feststoff.
H229 Behälter steht unter Druck: kann bei Erwärmung bersten.
H230 Kann auch in Abwesenheit von Luft explosionsartig reagieren.
H231 Kann auch in Abwesenheit von Luft bei erhöhtem Druck und/oder erhöhter Temperatur explosionsartig reagieren.
H240 Erwärmung kann Explosion verursachen.
H241 Erwärmung kann Brand oder Explosion verursachen.
H242 Erwärmung kann Brand verursachen.
H250 Entzündet sich in Berührung mit Luft von selbst.
H251 Selbsterhitzungsfähig; kann in Brand geraten.
H252 In großen Mengen selbsterhitzungsfähig; kann in Brand geraten.
H260 In Berührung mit Wasser entstehen entzündbare Gase, die sich spontan entzünden können.
H261 In Berührung mit Wasser entstehen entzündbare Gase.
H270 Kann Brand verursachen oder verstärken; Oxidationsmittel.
H271 Kann Brand oder Explosion verursachen; starkes Oxidationsmittel.
H272 Kann Brand verstärken; Oxidationsmittel.
H280 Enthält Gas unter Druck; kann bei Erwärmung explodieren.
H281 Enthält tiefkaltes Gas; kann Kälteverbrennungen oder -verletzungen verursachen.
H290 Kann gegenüber Metallen korrosiv sein.
GEFAHRENHINWEISE FÜR GESUNDHEITSGEFAHREN
H300 Lebensgefahr bei Verschlucken.
H301 Giftig bei Verschlucken.
H302 Gesundheitsschädlich bei Verschlucken.
H304 Kann bei Verschlucken und Eindringen in die Atemwege tödlich sein.
H310 Lebensgefahr bei Hautkontakt.
H311 Giftig bei Hautkontakt.
H312 Gesundheitsschädlich bei Hautkontakt.
H314 Verursacht schwere Verätzungen der Haut und schwere Augenschäden.
H315 Verursacht Hautreizungen.
H317 Kann allergische Hautreaktionen verursachen.
H318 Verursacht schwere Augenschäden (entfällt, wenn auch H314).
H319 Verursacht schwere Augenreizung.
H330 Lebensgefahr bei Einatmen.
H331 Giftig bei Einatmen.
H332 Gesundheitsschädlich bei Einatmen.
H334 Kann bei Einatmen Allergie, asthmaartige Symptome oder Atembeschwerden verursachen.
H335 Kann die Atemwege reizen.
H-SÄTZE ERKLÄRUNG
H336 Kann Schläfrigkeit und Benommenheit verursachen.
H340 Kann genetische Defekte verursachen (Expositionsweg angeben, sofern schlüssig belegt ist, dass diese Gefahr bei keinem anderen Expositionsweg besteht).
H341 Kann vermutlich genetische Defekte verursachen (Expositionsweg angeben, sofern schlüssig belegt ist, dass diese Gefahr bei keinem anderen Expositionsweg besteht).
H350 Kann Krebs erzeugen (Expositionsweg angeben, sofern schlüssig belegt ist, dass diese Gefahr bei keinem anderen Expositionsweg besteht).
H351 Kann vermutlich Krebs erzeugen (Expositionsweg angeben, sofern schlüssig belegt ist, dass diese Gefahr bei keinem anderen Expositionsweg besteht).
H360 Kann die Fruchtbarkeit beeinträchtigen oder das Kind im Mutterleib schädigen (sofern bekannt, konkrete Wirkung angeben). (Expositionsweg angeben, sofern schlüssig belegt ist, dass die Gefährdung bei keinem anderen Expositionsweg besteht).
H361 Kann vermutlich die Fruchtbarkeit beeinträchtigen oder das Kind im Mutterleib schädigen (sofern bekannt, konkrete Wirkung angeben). (Expositionsweg angeben, sofern schlüssig belegt ist, dass die Gefährdung bei keinem anderen Expositionsweg besteht).
H362 Kann Säuglinge über die Muttermilch schädigen.
H370 Schädigt die Organe (oder alle betroffenen Organe nennen, sofern bekannt). (Expositionsweg angeben, sofern schlüssig belegt ist, dass diese Gefahr bei keinem anderen Expositionsweg besteht).
H371 Kann die Organe schädigen (oder alle betroffenen Organe nennen, sofern bekannt). (Expositionsweg angeben, sofern schlüssig belegt ist, dass diese Gefahr bei keinem anderen Expositionsweg besteht).
H372 Schädigt die Organe (alle betroffenen Organe nennen) bei längerer oder wiederholter Exposition. (Expositionsweg angeben, wenn schlüssig belegt ist, dass diese Gefahr bei keinem anderen Expositionsweg besteht).
H373 Kann die Organe schädigen (alle betroffenen Organe nennen, sofern bekannt) bei längerer oder wiederholter Exposition. (Expositionsweg angeben, wenn schlüssig belegt ist, dass diese Gefahr bei keinem anderen Expositionsweg besteht).
H300+H310 Lebensgefahr bei Verschlucken oder Hautkontakt.
H300+H330 Lebensgefahr bei Verschlucken oder Einatmen.
H301+H330 Lebensgefahr bei Hautkontakt oder Einatmen.
H300+H310+H330 Lebensgefahr bei Verschlucken, Hautkontakt oder Einatmen.
H301+H311 Giftig bei Verschlucken oder Hautkontakt.
H301+H331 Giftig bei Verschlucken oder Einatmen.
H311+H331 Giftig bei Hautkontakt oder Einatmen.
H301+H311+H331 Giftig bei Verschlucken, Hautkontakt oder Einatmen.
H302+H312 Gesundheitsschädlich bei Verschlucken oder Hautkontakt.
H302+H332 Gesundheitsschädlich bei Verschlucken oder Einatmen.
H312+H332 Gesundheitsschädlich bei Hautkontakt oder Einatmen.
H302+H312+H332 Gesundheitsschädlich bei Verschlucken, Hautkontakt oder Einatmen.
ZU BEACHTEN BEI DEN CODES:
F/D Grossbuchstaben = kann
f/d Kleinbuchstaben = kann vermutlich
H350i Kann beim Einatmen Krebs erzeugen.
H360F Kann die Fruchtbarkeit beeinträchtigen.
H360D Kann das Kind im Mutterleib schädigen.
H361f Kann vermutlich die Fruchtbarkeit beeinträchtigen.
H361d Kann vermutlich das Kind im Mutterleib schädigen.
H360FD Kann die Fruchtbarkeit beeinträchtigen. Kann das Kind im Mutterleib schädigen.
H361fd Kann vermutlich die Fruchtbarkeit beeinträchtigen. Kann vermutlich das Kind im Mutterleib schädigen.
H360Fd Kann die Fruchtbarkeit beeinträchtigen. Kann vermutlich das Kind im Mutterleib schädigen.
H360Df Kann das Kind im Mutterleib schädigen. Kann vermutlich die Fruchtbarkeit beeinträchtigen.
GEFAHRENHINWEISE FÜR UMWELTGEFAHREN
H400 Sehr giftig für Wasserorganismen (entfällt, wenn auch H410).
H410 Sehr giftig für Wasserorganismen, mit langfristiger Wirkung.
H-SÄTZE
ERKLÄRUNG
H411 Giftig für Wasserorganismen, mit langfristiger Wirkung.
H412 Schädlich für Wasserorganismen, mit langfristiger Wirkung.
H413 Kann für Wasserorganismen schädlich sein, mit langfristiger Wirkung.
H420 Schädigt die öffentliche Gesundheit und die Umwelt durch Ozonabbau in der äußeren Atmosphäre.
ERGÄNZENDE GEFAHRENMERKMALE – PHYSIKALISCH-CHEMISCHE EIGENSCHAFTEN
EUH 001 In trockenem Zustand explosiv.
EUH 014 Reagiert heftig mit Wasser.
EUH 018 Kann bei Verwendung explosionsfähige/entzündbare Dampf/Luft-Gemische bilden.
EUH 019 Kann explosionsfähige Peroxide bilden.
EUH 044 Explosionsgefahr bei Erhitzen unter Einschluss.
ERGÄNZENDE GEFAHRENMERKMALE – GESUNDHEITSGEFÄHRLICHE EIGENSCHAFTEN
EUH 029 Entwickelt bei Berührung mit Wasser giftige Gase.
EUH 031 Entwickelt bei Berührung mit Säure giftige Gase.
EUH 032 Entwickelt bei Berührung mit Säure sehr giftige Gase.
EUH 066 Wiederholter Kontakt kann zu spröder oder rissiger Haut führen.
EUH 070 Giftig bei Berührung mit den Augen.
EUH 071 Wirkt ätzend auf die Atemwege.
ERGÄNZENDE KENNZEICHNUNGSELEMENTE/INFORMATIONEN ÜBER BESTIMMTE STOFFE UND GEMISCHE
EUH 201 Enthält Blei. Nicht für den Anstrich von Gegenständen verwenden, die von Kindern gekaut oder gelutscht werden könnten.
EUH 201A Achtung! Enthält Blei.
EUH 202 Cyanacrylat. Gefahr. Klebt innerhalb von Sekunden Haut und Augenlider zusammen. Darf nicht in die Hände von Kindern gelangen.
EUH 203 Enthält Chrom (VI). Kann allergische Reaktionen hervorrufen.
EUH 204 Enthält Isocyanate. Kann allergische Reaktionen hervorrufen.
EUH 205 Enthält epoxidhaltige Verbindungen. Kann allergische Reaktionen hervorrufen.
EUH 206 Achtung! Nicht zusammen mit anderen Produkten verwenden, da gefährliche Gase (Chlor) freigesetzt werden können.
EUH 207 Achtung! Enthält Cadmium. Bei der Verwendung entstehen gefährliche Dämpfe. Hinweise des Herstellers beachten. Sicherheitsanweisungen einhalten.
EUH 208 Enthält <Name des sensibilisierenden Stoffes>. Kann allergische Reaktionen hervorrufen.
EUH 209 Kann bei Verwendung leicht entzündbar werden.
EUH 209A Kann bei Verwendung entzündbar werden.
EUH 210 Sicherheitsdatenblatt auf Anfrage erhältlich.
EUH 401 Zur Vermeidung von Risiken für Mensch und Umwelt die Gebrauchsanleitung einhalten.
Die Sicherheitshinweise sind passend zu den Gefahrenhinweisen gemäß Anhang I, Teil 2, 3 und 4 der CLP-Verordnung nach den Vorgaben gemäß Anhang IV, Teil 1 der CLP-Verordnung auszuwählen. Sicherheitshinweise in allen EG-Sprachen sind Anhang IV, Teil 2 der CLP-Verordnung zu entnehmen.
P-SÄTZE
ERKLÄRUNG
SICHERHEITSHINWEISE – ALLGEMEINES
P101 Ist ärztlicher Rat erforderlich, Verpackung oder Kennzeichnungsetikett bereithalten.
P102 Darf nicht in die Hände von Kindern gelangen.
P103 Vor Gebrauch Kennzeichnungsetikett lesen.
P-SÄTZE
ERKLÄRUNG
SICHERHEITSHINWEISE – PRÄVENTION
P201 Vor Gebrauch besondere Anweisungen einholen.
P202 Vor Gebrauch alle Sicherheitshinweise lesen und verstehen.
P210 Von Hitze, heißen Oberflächen, Funken, offenen Flammen sowie anderen Zündquellenarten fernhalten. Nicht rauchen.
P211 Nicht gegen offene Flamme oder andere Zündquelle sprühen.
P220 Von Kleidung/…/brennbaren Materialien fernhalten/entfernt aufbewahren.
P221 Mischen mit brennbaren Stoffen/… unbedingt verhindern.
P222 Keinen Kontakt mit Luft zulassen.
P223 Keinen Kontakt mit Wasser zulassen.
P230 Feucht halten mit …
P231 Unter inertem Gas handhaben.
P232 Vor Feuchtigkeit schützen.
P233 Behälter dicht verschlossen halten.
P234 Nur im Originalbehälter aufbewahren.
P235 Kühl halten.
P240 Behälter und zu befüllende Anlage erden.
P241 Explosionsgeschützte elektrische Geräte/Lüftungsanlagen/Beleuchtungsanlagen/… verwenden.
P242 Nur funkenfreies Werkzeug verwenden.
P243 Maßnahmen gegen elektrostatische Entladungen treffen.
P244 Ventile und Ausrüstungsteile öl- und fettfrei halten.
P250 Nicht schleifen/stoßen/…/reiben.
P251 Nicht durchstechen oder verbrennen, auch nicht nach Gebrauch.
P260 Staub/Rauch/Gas/Nebel/Dampf/Aerosol nicht einatmen.
P261 Einatmen von Staub/Rauch/Gas/Nebel/Dampf/Aerosol vermeiden.
P262 Nicht in die Augen, auf die Haut oder auf die Kleidung gelangen lassen.
P263 Kontakt während der Schwangerschaft/der Stillzeit vermeiden.
P264 Nach Handhabung… gründlich waschen.
P270 Bei Gebrauch nicht essen, trinken oder rauchen.
P271 Nur im Freien oder in gut belüfteten Räumen verwenden.
P272 Kontaminierte Arbeitskleidung nicht außerhalb des Arbeitsplatzes tragen.
P273 Freisetzung in die Umwelt vermeiden.
P280 Schutzhandschuhe/Schutzkleidung/Augenschutz/Gesichtsschutz tragen.
P282 Schutzhandschuhe/Gesichtsschild/Augenschutz mit Kälteisolierung tragen.
P283 Schwer entflammbare/flammhemmende Kleidung tragen.
P284 (Bei unzureichender Lüftung) Atemschutz tragen.
P231+P232 Unter inertem Gas handhaben. Vor Feuchtigkeit schützen.
P235+P410 Kühl halten. Vor Sonnenbestrahlung schützen.
SICHERHEITSHINWEISE – REAKTION
P301 BEI VERSCHLUCKEN:
P302 BEI BERÜHRUNG MIT DER HAUT:
P303 BEI BERÜHRUNG MIT DER HAUT (oder dem Haar):
P304 BEI EINATMEN:
P305 BEI KONTAKT MIT DEN AUGEN:
P306 BEI KONTAKT MIT DER KLEIDUNG:
P308 BEI Exposition oder falls betroffen:
P310 Sofort GIFTINFORMATIONSZENTRUM/Arzt/… anrufen.
P311 GIFTINFORMATIONSZENTRUM/Arzt/… anrufen.
P312 Bei Unwohlsein GIFTINFORMATIONSZENTRUM/Arzt/… anrufen.
P313 Ärztlichen Rat einholen/ärztliche Hilfe hinzuziehen.
P314 Bei Unwohlsein ärztlichen Rat einholen/ärztliche Hilfe hinzuziehen.
P315 Sofort ärztlichen Rat einholen/ärztliche Hilfe hinzuziehen.
P-SÄTZE ERKLÄRUNG
P320 Besondere Behandlung dringend erforderlich (siehe … auf diesem Kennzeichnungsetikett).
P321 Besondere Behandlung (siehe … auf diesem Kennzeichnungsetikett).
P330 Mund ausspülen.
P331 KEIN Erbrechen herbeiführen.
P332 Bei Hautreizung:
P333 Bei Hautreizung oder -ausschlag:
P334 In kaltes Wasser tauchen/nassen Verband anlegen.
P335 Lose Partikel von der Haut abbürsten.
P336 Vereiste Bereiche mit lauwarmem Wasser auftauen. Betroffenen Bereich nicht reiben.
P337 Bei anhaltender Augenreizung:
P338 Eventuell vorhandene Kontaktlinsen nach Möglichkeit entfernen. Weiter ausspülen.
P340 Die betroffene Person an die frische Luft bringen und für ungehinderte Atmung sorgen.
P342 Bei Symptomen der Atemwege:
P351 Einige Minuten lang behutsam mit Wasser ausspülen.
P352 Mit viel Wasser/… waschen.
P353 Haut mit Wasser abwaschen/duschen.
P360 Kontaminierte Kleidung und Haut sofort mit viel Wasser abwaschen und danach Kleidung ausziehen.
P361 Alle kontaminierten Kleidungsstücke sofort ausziehen.
P362 Kontaminierte Kleidung ausziehen und vor erneutem Tragen waschen.
P363 Kontaminierte Kleidung vor erneutem Tragen waschen.
P364 Und vor erneutem Tragen waschen.
P370 Bei Brand:
P371 Bei Großbrand und großen Mengen:
P372 Explosionsgefahr bei Brand.
P373 KEINE Brandbekämpfung, wenn das Feuer explosive Stoffe/Gemisch/Erzeugnisse erreicht.
P374 Brandbekämpfung mit üblichen Vorsichtsmaßnahmen aus angemessener Entfernung.
P375 Wegen Explosionsgefahr Brand aus der Entfernung bekämpfen.
P376 Undichtigkeit beseitigen, wenn gefahrlos möglich.
P377 Brand von ausströmendem Gas: Nicht löschen, bis Undichtigkeit gefahrlos beseitigt werden kann.
P378 … zum Löschen verwenden.
P380 Umgebung räumen.
P381 Alle Zündquellen entfernen, wenn gefahrlos möglich.
P390 Verschüttete Mengen aufnehmen, um Materialschäden zu vermeiden.
P391 Verschüttete Mengen aufnehmen.
P301+P310 BEI VERSCHLUCKEN: Sofort GIFTINFORMATIONSZENTRUM/Arzt… anrufen.
P301+P312 BEI VERSCHLUCKEN: Bei Unwohlsein GIFTINFORMATIONSZENTRUM/Arzt… anrufen.
P301+P330+P331 BEI VERSCHLUCKEN: Mund ausspülen. KEIN Erbrechen herbeiführen.
P302+P334 BEI BERÜHRUNG MIT DER HAUT: In kaltes Wasser tauchen/nassen Verband anlegen.
P302+P352 BEI BERÜHRUNG MIT DER HAUT: Mit viel Wasser/... waschen.
P303+P361+P353 BEI BERÜHRUNG MIT DER HAUT (oder dem Haar): Alle kontaminierten Kleidungsstücke sofort ausziehen. Haut mit Wasser abwaschen/duschen.
P304+P340 BEI EINATMEN: Die Person an die frische Luft bringen und für ungehinderte Atmung sorgen.
P305+P351+P338 BEI KONTAKT MIT DEN AUGEN: Einige Minuten lang behutsam mit Wasser ausspülen. Eventuell vorhandene Kontaktlinsen nach Möglichkeit entfernen. Weiter spülen.
P306+P360 BEI KONTAKT MIT DER KLEIDUNG: Kontaminierte Kleidung und Haut sofort mit viel Wasser abwaschen und danach Kleidung ausziehen.
P308+P311 BEI Exposition oder falls betroffen: GIFTINFORMATIONSZENTRUM/Arzt… anrufen.
P-SÄTZE
ERKLÄRUNG
P308+P313 Bei Exposition oder falls betroffen: Ärztlichen Rat einholen/ärztliche Hilfe hinzuziehen.
P332+P313 Bei Hautreizung: Ärztlichen Rat einholen/ärztliche Hilfe hinzuziehen.
P333+P313 Bei Hautreizung oder -ausschlag: Ärztlichen Rat einholen/ärztliche Hilfe hinzuziehen.
P335+P334 Lose Partikel von der Haut abbürsten. In kaltes Wasser tauchen/nassen Verband anlegen.
P337+P313 Bei anhaltender Augenreizung: Ärztlichen Rat einholen/ärztliche Hilfe hinzuziehen.
P342+P311 Bei Symptomen der Atemwege: GIFTINFORMATIONSZENTRUM/Arzt… anrufen.
P361+P364 Alle kontaminierten Kleidungsstücke sofort ausziehen und vor erneutem Tragen waschen.
P362+P364 Kontaminierte Kleidung ausziehen und vor erneutem Tragen waschen.
P370+P376 Bei Brand: Undichtigkeit beseitigen, wenn gefahrlos möglich.
P370+P378 Bei Brand: … zum Löschen verwenden.
P370+P380 Bei Brand: Umgebung räumen.
P370+P380+P375 Bei Brand: Umgebung räumen. Wegen Explosionsgefahr Brand aus der Entfernung bekämpfen.
P371+P380+P375 Bei Großbrand und großen Mengen: Umgebung räumen. Wegen Explosionsgefahr Brand aus der Entfernung bekämpfen.
SICHERHEITSHINWEISE – AUFBEWAHRUNG
P401 … aufbewahren.
P402 An einem trockenen Ort aufbewahren.
P403 An einem gut belüfteten Ort aufbewahren.
P404 In einem geschlossenen Behälter aufbewahren.
P405 Unter Verschluss aufbewahren.
P406 In korrosionsbeständigem/… Behälter mit widerstandsfähiger Innenauskleidung aufbewahren.
P407 Luftspalt zwischen Stapeln/Paletten lassen.
P410 Vor Sonnenbestrahlung schützen.
P411 Bei Temperaturen nicht über …°C/…°F aufbewahren.
P412 Nicht Temperaturen über 50 °C/122 °F aussetzen.
P413 Schüttgut in Mengen von mehr als … kg/… lbs bei Temperaturen von nicht mehr als …°C/…°F aufbewahren.
P420 Von anderen Materialien entfernt aufbewahren.
P422 Inhalt in/unter … aufbewahren.
P402+P404 An einem trockenen Ort aufbewahren. In einem geschlossenen Behälter aufbewahren.
P403+P233 An einem gut belüfteten Ort aufbewahren. Behälter dicht verschlossen halten.
P403+P235 An einem gut belüfteten Ort aufbewahren. Kühl halten.
P410+P403 Vor Sonnenbestrahlung schützen. An einem gut belüfteten Ort aufbewahren.
P410+P412 Vor Sonnenbestrahlung schützen und nicht Temperaturen über 50 °C/122 °F aussetzen.
P411+P235 Bei Temperaturen nicht über ...°C/...°F aufbewahren. Kühl halten.
SICHERHEITSHINWEISE – ENTSORGUNG
P501 Inhalt/Behälter … zuführen.
P502 Informationen zur Wiederverwendung/Wiederverwertung beim Hersteller/ Lieferanten erfragen.
Die Piktogramme sind rot umrandete auf der Spitze stehende weiße Quadrate mit einem schwarzen Symbol. Jedes Piktogramm hat eine Nummer und eine Bezeichnung für das schwarze Symbol.
NR.WW SYMBOL
GHS01 Explodierende Bombe
GHS02 Flamme
GHS03 Flamme über einem Kreis
BEZEICHNUNG PIKTOGRAMM
Gefahr Unstabil, Explositionsgefahr
Gefahr oder Achtung Entzündlich
Gefahr oder Achtung Brandfördernd
GHS04 Gasflasche
GHS05 Ätzwirkung
GHS06 Totenkopf mit gekreuzten Knochen
GHS07 Ausrufezeichen
GHS08 Gesundheitsgefahr
GHS09 Umwelt
Achtung Komprimierte Gase
Gefahr oder Achtung Ätzend etc. Kat. 1
Gefahr Giftig Kat. 1-3
Giftig Kat. 4 (Gesundheitsschädlich) Ätz- oder Reizwirkung Kat. 2 Niedrigere systemische Gesundheitsgefährdung
Gefahr oder Achtung Systemische Gesundheitsgefährdungen
Achtung (für Kat. 1) (für Kat. 2 kein Signalwort) Umweltgefährlich




Mobile-CASSY 2 WLAN
Universelles mobiles Handmessgerät für Schülerversuche und Demonstration:
• große Messwertanzeige
• automatische Erkennung der Sensoren, kompatibel mit allen CASSY-Sensoren S und Sensoren M
• 4-mm-Sicherheitsbuchsen für U, I, P und E sowie Typ-K-Buchse für Temperatur integriert
• intuitive Bedienung über Touchwheel
• schnelle Messwertaufnahme wahlweise mit Trigger und Vorlauf (auch als Oszilloskop einsetzbar)
• grafische Darstellung und Auswertung (z. B. freie Achsenbelegung, Zoom und Geradenanpassung) im Gerät
• USB-Anschluss für Präsentation und Auswertung am PC durch volle CASSY Lab 2-Unterstützung (524 220)
• USB-Stick-Anschluss zum einfachen Transport von Messdaten und Screenshots auch ohne PC
• mit praktischem Aufstellfuß
• mit integriertem WLAN
Technische Daten:
• Grafikdisplay: 9 cm (3,5“), QVGA, farbig, hell (einstellbar bis 400 cd/m²)
• Eingänge: 3 (gleichzeitig verwendbar)
• Eingang A: U oder CASSY-Sensor S oder Sensor M
• Eingang B: I oder CASSY-Sensor S oder Sensor M
• Eingang ϑ: Temperatur
• Messbereiche U: ±0,1/±0,3/±1/±3/±10/±30 V
• Messbereiche I: ±0,03/±0,1/±0,3/±1/±3 A
• Messbereiche ϑ: -200 ... +200 °C / -200 ... +1200 °C
• Sensoranschlüsse: je 2 für CASSY-Sensoren S und Sensoren M
• Abtastrate: max. 500.000 Werte/s
• Auflösung der Analogeingänge: 12 Bit
• Auflösung der Timereingänge: 20 ns
• Lautsprecher: integriert für Tastentöne und GM-Zählrohr (jeweils abschaltbar)
• Datenspeicher: integrierte Micro-SD-Karte für über tausend Messdateien und Screenshots
• WLAN: 802.11 b/g/n als Access Point oder Client (WPA/WPA2) - Clientverbindung zu einem internetfähigen Router/Hotspot ermöglicht auch die Internetverbindung der verbundenen Tablets oder Smartphones
• TCP-Server: integriert (zur Verbindung mit CASSY Lab oder der CASSY App auf einem PC oder einem Tablet)
• HTTP-Server: integriert (Ansicht der Multimeter, der Tabelle und des Diagramms in einem Browser)
• WebSocket-Server: integriert (Verteilung der aktuellen Messdaten an bis zu drei Clients)
• VNC-Server: integriert (Remotebedienung durch Übertragung des Displayinhalts an einen Client)
• USB-Ports: je 1 für Anschluss eines USB-Sticks und eines PCs
• Akkukapazität: 14 Wh (Größe AA, wechselbar)
• Akkulaufzeit: 8 h im Betrieb, mehrere Jahre im Standby
• Kensington-Lock: Anschlussmöglichkeit für Diebstahlsicherung integriert
• Abmessungen: 175 mm x 95 mm x 40 mm
Lieferumfang:
• Mobile-CASSY 2 WLAN
• Ladegerät mit Sicherheitstransformator nach DIN EN 61558-2-6
• NiCr-Ni-Temperaturfühler
• Kurzanleitung
524 005W2 Mobile-CASSY 2 WLAN
Zusätzlich empfohlen:
Menge Kat.-Nr. Bezeichnung
1 524 0034 Ladeadapter für 4 Mobile-CASSY 2
1 524 0039 Geräteschub Mobile-CASSY 2
Ladeadapter für 4 Mobile-CASSY 2
Zum gleichzeitigen Aufladen von bis zu 4 Mobile-CASSY 2 (524 005W2) mit nur einem Steckernetzgerät.
Technische Daten:
• Ladedauer: unverändert im Vergleich zum einzelnen Aufladen
• Anschluss: Hohlbuchse für Steckernetzgerät 12 VAC (im Lieferumgang jedes Mobile-CASSY 2 enthalten)
• Sicherung: 1,1 A (selbstrückstellend)
• Abmessungen: 195 mm x 17 mm x 36 mm
• Masse: 70 g
524 0034 Ladeadapter für 4 Mobile-CASSY 2
Geräteschub Mobile-CASSY 2
Zur sicheren Aufbewahrung von bis zu 8 Mobile-CASSY 2 (524 005W). Zusammen mit zwei Ladeadaptern (524 0034) können alle 8 Mobile-CASSY 2 gleichzeitig im Geräteschub geladen werden.
Technische Daten:
• Abmessungen: 27 cm x 45 cm x 16,5 cm
Lieferumfang:
• Geräteschub mit Schaumstoffeinlage
524 0039 Geräteschub Mobile-CASSY 2
Empfohlenes Zubehör: 2 Ladeadapter (524 0034)
Drucksensor S, ±70 hPa
Zur Messung sehr kleiner Druckdifferenzen mit CASSY (524 013, 524 006, 524 018, 524 005W2) oder den Universellen Messinstrumenten (531 835, 531 836, 531 837), z. B. bei Strömungsexperimenten im Windkanal (373 12) oder dem Venturiohr (aus 373 091). Anschluss ans Experiment über zwei Schlauchwellen (4 mm Ø). Lieferung einschließlich PVC-Schlauch (667 192) und zwei Verbindungsstücken mit Schlaucholive (604 520).
Technische Daten:
• Messbereiche: ±0,7/ ±2,1/ ±7/ ±21/ ±70 hPa
• Auflösung: 0,05 % des Messbereiches
• Abmessungen: 70 mm x 50 mm x 25 mm
• Masse: 75 g
524 066
Drucksensor S, ± 70 hPa
Kraftsensor M, ±50 N
Zur Messung von Kraftkomponenten bis ±50 N (z. B. Federpendel oder Fliehkraftkomponenten) mit Mobile-CASSY 2 (524 005W2). Seine steife Konstruktion ermöglicht es, Kraftkomponenten bei beliebiger Lage des Kraftsensors zu messen.
Technische Daten:
• Messbereiche: ±5/±50 N
• Auflösung: 0,1 % des Messbereichs
• Kompensation (Tara): ±50 N in jedem Messbereich
• Befestigung: mit Feststellschraube an Stativmaterial
• Länge des Verbindungskabels: 0,30 m
524 434
Kraftsensor M, ±50 N
Lichtschranke M
Kaskadierbare Lichtschranke zur Messung von Periodendauern, Fahrzeiten, Wegen und Geschwindigkeiten auf der Schülerfahrbahn oder beim freien Fall mit dem Mobile-CASSY 2 (524 005W2).
Technische Daten:
• Zeitauflösung: 100 ns
• Wegauflösung: 5 mm bei Verwendung des Speichenrades
• Kaskadierung: bis zu 5 Lichtschranken (z. B. für Fahrzeitmessungen oder bis zu 5 aufeinanderfolgende Geschwindigkeitsmessung auf einer Fahrbahn)
• Befestigung: unter Schülerfahrbahn (460 81/460 82) einrastend oder über M6-Gewinde
• Länge des Verbindungskabels: 1 m
• Anschluss: Mini-DIN
• Versorgungsspannung: 5 V DC über Mini-DIN
• Abmessungen: 120 mm x 115 mm x 30 mm
• Masse: 180 g
524 431
Lichtschranke M
Empfohlenes Zubehör:
• Speichenrad (524 4322)
Zur Befestigung an einer Lichtschranke M zur kontinuierlichen Weg- und Geschwindigkeitsmessung
• Startvorrrichtung, Wagen (524 4323)
Zur Befestigung an einer Lichtschranke M zum automatischen Start der Zeitmessung beim Start der Bewegung auf einer Fahrbahn (statt eines Haltemagneten)
• Startvorrichtung, Kugel (524 4324)
Zur Befestigung an einer Lichtschranke M zum automatischen Start der Zeitmessung beim Start des freien Falls einer Kugel (statt eines Haltemagneten)
Mikrofon M
Zur Messung von Schallpegel (dBA), Frequenz und dem Verlauf akustischer Signale mit dem Mobile-CASSY 2 (524 005W2).
Technische Daten:
• Messgrößen: Spannung, Frequenz, Schallpegel
• Frequenzbereich: 50 ... 20.000 Hz
• Schallpegelbereiche: 40 ... 100 dB, 60 ... 120 dB (auch automatisch)
• Abtastrate: max. 500.000 Werte/s
• Länge des Verbindungskabels: 1,20 m
524 442 Mikrofon M
Magnetfeldsensor M, ±100 mT
Zur Messung der tangentialen oder axialen magnetischen Flussdichte bis ±100 mT mit dem Mobile-CASSY 2 (524 005W2).
Technische Daten:
• Messbereiche: ±10/±100 mT
• Auflösung: 0,05 % des Messbereichs
• Messrichtung: zwischen axial und tangential umschaltbar
• Länge des Verbindungskabels: 1,20 m
524 436 Magnetfeldsensor M, ±100 mT









Zur Messung der Beleuchtungsstärke von sichtbarem Licht mit Mobile-CASSY 2 (524 005W2). Der Luxsensor M ist flach ausgeführt, damit er beispielsweise direkt in den Halter für Blenden und Dias auf Stiel (459 33) eingesetzt werden kann. Mit dem Luxsensor M lassen sich Versuche entlang und orthogonal zur optischen Achse durchführen. Eine aufgedruckte Millimeterskala dient dazu, den Sensor auf der optischen Achse zu positionieren und ermöglicht zudem die Aufnahme von Intensitätsverteilungen verschiedener Beugungsobjekte ohne weitere Hilfsmittel.
Technische Daten:
• Messbereiche: 0...100 lx, 0...1 klx, 0...10 klx, 0...100 klx
• Abmessungen des Sensors: 0,4 mm x 0,4 mm
• Spektrale Empfindlichkeit: 480 … 650 nm
• Abmessungen: 50 mm x 50 mm x 2,4 mm
• Länge des Verbindungskabels: 1,20 m
524 444 Luxsensor M
GM-Adapter M
Zur Messung radioaktiver Strahlung mit einem Geiger-Müller-Zählrohr (559 01 oder 559 012) mit dem Mobile-CASSY 2 (524 005W2).
Technische Daten:
• Zählrohrspannung: 200 ... 650 V (einstellbar)
• Zählrohreingang: Koaxialbuchse
• Länge des Verbindungskabels: 0,30 m
524 440 GM-Adapter M
Leitfähigkeits-Sensor
Sensor in Vierleitertechnik mit integriertem Pt-Temperatursensor; zur Verwendung mit der Chemie-Box (524 067) oder dem Leitfähigkeits-Adaper S (524 0671) zusammen mit CASSY (524 013, 524 006, 524 005W2, 524 018) oder dem Universellen Messinstrument Chemie (531 836). Offener Aufbau für schnelle Reaktion auf Leitfähigkeitsänderungen. Bei Messungen ist ein Mindestabstand von der Behälterwand von 1 cm, sowie eine Mindesteintauchtiefe von 2 cm einzuhalten.
Technische Daten:
• Zellkonstante: 0,58 cm-1
• Messbereich: 0 ... 1 S/cm
• Temperaturmessbereich: -25 ... +100 °C
• Anschlussstecker: 8-poliger DIN-Stecker
• Abmessungen: 160 mm x 16 mm Ø
• Masse: 75 g
529 670 Leitfähigkeits-Sensor
Leitfähigkeits-Adapter S
Ermöglicht zusammen mit dem Leitfähigkeits-Sensor (529 670) die Messung der Leitfähigkeit und der Temperatur mit CASSY (524 013, 524 006, 524 005W2, 524 018) oder dem Universellen Messinstrument Chemie (531 836).
Technische Daten:
• Messbereiche:
Leitfähigkeit (mit Sensor 529 670): 10/30/100/300 µS/cm, 1/3/10/30/100/300 mS/cm, 1 S/cm
• Auflösung im kleinsten Messbereich: 0,005 µS/cm
• Temperaturmessung und -kompensation: -25 ... +100 °C
• Anschluss: 8-polige DIN-Buchse für Leitfähigkeits-Sensor mit Temperaturmessung
• Abmessungen: 50 mm x 25 mm x 60 mm
• Masse: 0,1 kg
524 0671

Leitfähigkeits-Adapter S
Zusätzlich erforderlich:
Menge Kat.-Nr. Bezeichnung
1 529 670 Leitfähigkeits-Sensor
Ermöglicht den Anschluss einer pH-Elektrode an CASSY (524 013, 524 006, 524 005W2, 524 018) oder das Universelle Messinstrument Chemie (531 836). Zudem kann die Spannung an der BNC-Buchse sehr hochohmig gemessen werden, z. B. zur Messung elektrochemischer Potenziale.
Technische Daten:
• Messbereich pH: 0 ... 14 pH
• Auflösung pH: 0,01 pH
• Messbereiche Potenzial: ±1/±2 V
• Eingangswiderstand: > 1013 Ω
• Anschluss: BNC-Buchse
• Abmessungen: 50 mm x 25 mm x 60 mm
• Masse: 0,1 kg
524 0672
pH-Adapter
Zusätzlich empfohlen:
Menge Kat.-Nr. Bezeichnung
1 529 672
pH-Elektrode, BNC-Stecker
1 667 416 Redox-Einstabmesskette BNC
1 667 4172
1 667 4242
pH-Elektrode mit Kunststoffschaft, BNC
pH-Elektrode mit Glasschaft, BNC
• Messbereich: 0 ... 14 pH
• Auflösung: 0,01 pH
• geeignet für: 524 067 und 524 0672
Kat.-Nr. Bezeichnung
529 672
667 4172
667 4242
pH-Elektrode, BNC-Stecker
pH-Elektrode mit Kunststoffschaft, BNC
pH-Elektrode mit Glasschaft, BNC
Elektrochemie-Box M
Mobiles Stromversorgungsgerät für Experimente sowie Spannungs- und Strommessgerät in Verbindung mit dem Mobile-CASSY 2 WLAN (524 005W2). Zur Stromversorgung bis 300 mA sowie der intuitiven, parallelen Messung der elektrischen Spannung bis ±20 V und der Stromstärke bis ±2 A.
Technische Daten:
• 1 Ausgang: 4-mm-Sicherheitsbuchsen
• Stromstärke: 0 bis 300 mA (30 Stufen), leistungsbegrenzt auf 1,5 Watt
• 2 Eingänge (Strom- und Spannungsmessung): 4-mm-Sicherheitsbuchsen, differenziell
• Messbereich der Stromstärke: bis ± 2 A, selbstrückstellende Sicherung
• Auflösung: 0,1 mA
• Messbereich der Spannung: bis ±20 V, Eingangswiderstand 1 MΩ
• Auflösung: 1 mV
• Länge des Anschlusskabels: 1,20 m
524 450 Elektrochemie-Box
Puls-Sensor S
Zur Messung der Pulsfrequenz mittels Infrarot-Messzelle am Ohrläppchen oder der Fingerkuppe mit automatischer Empfindlichkeitseinstellung durch CASSY (524 013, 524 006, 524 005W2, 524 018). Die einzelnen Pulsschläge werden durch eine LED angezeigt. Der Pulsaufnehmer ist galvanisch von CASSY getrennt.
524 0471 Puls-Sensor S
Blutdruck-Sensor S
Zur Messung des Blutdrucks nach der oszillometrischen Methode mit CASSY 2 (524 013, 524 006, 524 005W2, 524 018) ohne Stethoskop und Mikrofon. Die durch die Pulswellen verursachten und von der Blutdruck-Manschette übertragenen Druckschwankungen werden gemessen; parallel dazu wird der abfallende Manschettendruck erfasst. Alternativ zur Verwendung mit Mobile-CASSY 2 WLAN (524 005W2) nach der auskultatorischen Methode (nach Korotkow). Die charakteristischen Geräuschphänomene werden mit einem Stethoskop abgehört (zusätzlich erforderlich). Das Universelle Messinstrument Biologie (531 837) stellt die Druckschwankungen akustisch dar.
Technische Daten:
• Druckmessbereich: 375 mmHg (500 hPa)
524 0501
Blutdruck-Sensor S
Zur pneumotachographischen Messung verschiedener Atemvolumina, der Fluss-Volumen-Kurve und der 1-Sekunden-Kapazität mit CASSY (524 013, 524 006, 524 005W2, 524 018).
Technische Daten:
• Messbereich: -14 ... +14 l/s
• Messgenauigkeit: ±2,5 %
Lieferumfang:
• 1 Spirometer-Box
• 1 Übergangsstück
• 30 Bakterienfilter
• 30 Mundstücke
524 056 Spirometer-Box







Zur Messung von Reaktionszeiten über Hand- oder Fußtaster und zur Bestimmung der Nervenleitungsgeschwindigkeit mit CASSY (524 013, 524 006, 524 005W2, 524 018). Signalisierung wahlweise über drei farbige LEDs (Handtaster) oder ein akustisches Signal (Fußtaster) oder über Software.
524 0461
Reaktionstest-Adapter S
Zusätzlich erforderlich:
Menge Kat.-Nr.
Bezeichnung
1 662 148 Handtaster
1 662 149 Fußtaster
NiCr-Ni-Adapter S, Typ K
Ermöglicht den Anschluss von zwei NiCr-Ni (Typ K) Thermoelementen zur Temperatur- und Differenztemperaturmessung mit CASSY (524 013, 524 006, 524 005W2, 524 018) oder den Universellen Messinstrumenten (531 835, 531 836, 531 837).
Technische Daten:
• Maximale Messbereiche (sensorabhängig): -200 ... +200° C / -200 ... +1200° C
• Auflösung: 0,1 K / 1 K
• Differenztemperatur Messbereiche: -20 ... +20° C / -200 ... +200° C
• Auflösung: 0,01 K / 0,1 K
• Anschlüsse: Flachstecker, Typ K
• Abmessungen: 50 mm x 25 mm x 60 mm
• Masse: 0,1 kg
524 0673
NiCr-Ni-Adapter S, Typ K
Zusätzlich empfohlen:
Menge Kat.-Nr. Bezeichnung
1 529 676
1 666 1261
1 666 1263
1 666 1264


Temperaturfühler NiCr-Ni, 1,5 mm, Typ K
Temperaturfühler NiCr-Ni, schnell, Typ K
Temperaturfühler NiCr-Ni, 3 mm, Typ K
Temperaturfühler NiCr-Ni, für Oberflächenmessung, Typ K
Temperaturfühler NiCr-Ni, schnell, Typ K
NiCr-Ni-Thermoelement mit Miniaturstecker zur sekundenschnellen Messung in Luft, Gasen und Flüssigkeiten, glasseidenisoliert, ohne Griff. Zur Verwendung an CASSY mit dem NiCr-Ni-Adapter S (524 0673) oder direkt an der Chemie-Box (524 067) und dem Mobile CASSY 2 (524 005W2).
Technische Daten:
• Messbereich: -50 ... +400 °C
• Ansprechzeit T90: 0,3 s
• Stocklänge: 1000 mm, 2,1 mm x 1,2 mm
666 1261
Temperaturfühler NiCr-Ni, schnell, Typ K
Kleinspannungsstelltrafo 2...24 V/ 5 A
Energieversorgungsgerät für Elektrik- und einfache Elektronikversuche. Ausgangsspannung in Stufen einstellbar; überlastgeschützt mit Sicherungsautomaten. Alle Ausgänge galvanisch vom Netz getrennt, erdfrei. Besonders geeignet für Schülerversuche in allen Altersstufen durch sichere Trennung gemäß BG/GUV-SI 8040 (RiSU-konform).
Technische Daten:
• Ausgangsspannungen: 2...24 V AC und DC, in Schritten von 2 V
• DC Spannung: Brückengleichrichtung
• Belastbarkeit: 5 A, in Summe
• Anschluss: zwei 4-mm-Buchsenpaare für AC und DC
• DC und AC Teil gleichzeitig verwendbar, aber nicht galvanisch getrennt
• Elektrische Trennung: Sicherheitstransformator nach DIN EN 61558-2-6 (RiSU-konform)
• Eingangsspannung: 230 V, 50/60 Hz
• Abmessungen: 203 mm x 225 mm x 117 mm
• Masse: 2,8 kg
521 353 Kleinspannungsstelltrafo 2...24 V/ 5 A
Netzgerät 0...24 V / 5 A
Energieversorgungsgerät mit hoher Belastbarkeit für stufenlos einstellbare Gleich- und Wechselspannung und digitaler Anzeige. Alle Ausgänge sind überlastgeschützt durch Sicherungsautomaten, daher besonders geeignet für Praktikumsversuche. Alle Ausgänge galvanisch vom Netz getrennt, erdfrei. Sicherheitstechnisch geeignet für Schülerversuche in allen Altersstufen durch sichere Trennung gemäß BG/GUV-SI 8040 (RiSU-konform).
Technische Daten:
• Ausgangsspannungen: 0...24 V AC und DC, stufenlos
• DC Spannung: Brückengleichrichtung, geglättet
• Belastbarkeit: 5 A, in Summe
• Anzeige: umschaltbar zwischen AC und DC
• Anschluss: zwei 4-mm-Buchsenpaare für AC und DC
• DC und AC Teil gleichzeitig verwendbar, aber nicht galvanisch getrennt
• Elektrische Trennung: Sicherheitstransformator nach DIN EN 61558-2-6 (RiSU-konform)
• Eingangsspannung: 230 V, 50/60 Hz
• Abmessungen: 256 mm x 225 mm x 117 mm
• Masse: 6 kg
521 391 AC/DC Netzgerät 0...24 V / 5 A
Kleinspannungsstelltrafo 1...12 V/ 6 A
Energieversorgungsgerät für Elektrik- und einfache Elektronikversuche. Ausgangsspannung in Stufen einstellbar; überlastgeschützt mit Sicherungautomaten. Alle Ausgänge galvanisch vom Netz getrennt, erdfrei. Besonders geeignet für Schülerversuche in allen Altersstufen durch sichere Trennung gemäß BG/GUV-SI 8040 (RiSU-konform).
Technische Daten:
• Ausgangsspannungen: 1...12 V AC und DC, in Schritten von 1 V
• DC Spannung: Brückengleichrichtung
• Belastbarkeit: 6 A, in Summe
• Anschluss: zwei 4-mm-Buchsenpaare für AC und DC
• DC und AC Teil gleichzeitig verwendbar, aber nicht galvanisch getrennt
• Elektrische Trennung: Sicherheitstransformator nach DIN EN 61558-2-6 (RiSU-konform)
• Eingangsspannung: 230 V, 50/60 Hz
• Abmessungen: 203 mm x 225 mm x 117 mm
• Masse: 2,8 kg
521 352 Kleinspannungsstelltrafo 1...12 V/ 6 A
Das Standard-Schülernetzgerät mit stufenlos einstellbarer und geregelter DC-Ausgangsspannung, in Stufen einstellbarer AC-Spannung und digitaler Anzeige; Wechsel- und Gleichspannungsausgänge galvanisch getrennt, zuverlässiger Überlastschutz und Schaltungsschutz durch elektronische Strombegrenzung (DC) und Sicherungsautomat (AC). Alle Ausgänge galvanisch vom Netz getrennt, erdfrei. Besonders geeignet für Schülerversuche in allen Altersstufen durch sichere Trennung gemäß BG/GUV-SI 8040 (RiSU-konform).
Technische Daten:
• Ausgangsspannungen: 0 ... 12 V DC, stufenlos einstellbar, stabilisiert - 2/4/6/12 V AC
• Ausgangsstrom: max. 3 A
• Restwelligkeit DC: < 100 mV
• Anzeige
• Überlastschutz: DC elektronisch, AC mit rückstellbarer Sicherung
• Anschlüsse: 4-mm-Sicherheitsbuchsen
• Anschlussspannung: 230 V, 50/60 Hz
• Elektrische Trennung: Sicherheitstransformator nach DIN EN 61558-2-6 (RiSU-konform)
• Abmessungen: 203 mm x 225 mm x 117 mm
• Masse: 3 kg
521 487
AC/DC Netzgerät PRO 0...12 V/3 A
AC/DC Netzgerät 0...12 V/3 A
Das einfache Schülernetzgerät mit stufenlos einstellbarer und geregelter DC-Ausgangsspannung und in Stufen einstellbarer AC-Spannung; Wechsel- und Gleichspannungsausgänge galvanisch getrennt, zuverlässiger Überlastschutz und Schaltungsschutz durch elektronische Strombegrenzung (DC) und Sicherungsautomat (AC). Alle Ausgänge galvanisch vom Netz getrennt, erdfrei. Besonders geeignet für Schülerversuche in allen Altersstufen durch sichere Trennung gemäß BG/GUV-SI 8040 (RiSU-konform).
Technische Daten:
• Ausgangsspannungen: 0 ... 12 V DC, stufenlos einstellbar, stabilisiert - 2/4/6/12 V AC
• Ausgangsstrom: max. 3 A
• Restwelligkeit DC: < 100 mV
• Überlastschutz: DC elektronisch, AC mit rückstellbarer Sicherung
• Anschlüsse: 4-mm-Sicherheitsbuchsen
• Anschlussspannung: 230 V, 50/60 Hz
• Elektrische Trennung: Sicherheitstransformator nach DIN EN 61558-2-6 (RiSU-konform)
• Abmessungen: 203 mm x 225 mm x 117 mm
• Masse: 3 kg 521





Zur Aufbewahrung von Geräten und Materialien, insbesondere für Schülerversuchsmaterialien. Hohe Belastbarkeit und die Möglichkeit der freien Beschriftung durch mitgelieferte Etikettenhalter. Stapelbar sowohl mit als auch ohne Deckel (647 003). Vielseitige Möglichkeit der Unterteilung durch separate Fachteiler (647 004, 647 005, 647 006).
Technische Daten:
• Material: Styrol-Butadien (SB)
• Maße: 450 mm x 270 mm x 108 mm
• stapelbar
• hohe Belastbarkeit
• vielseitige Unterteilungsmöglichkeit
647 001 Geräteschub, niedrig

Zur Aufbewahrung von Geräten und Materialien, insbesondere für Schülerversuchsmaterialien. Hohe Belastbarkeit und die Möglichkeit der freien Beschriftung durch mitgelieferte Etikettenhalter. Stapelbar sowohl mit als auch ohne Deckel (647 003). Vielseitige Möglichkeit der Unterteilung durch separate Fachteiler (647 004, 647 005, 647 006).
Technische Daten:
• Material: Styrol-Butadien (SB)
• Maße: 450 mm x 270 mm x 162 mm
• stapelbar
• hohe Belastbarkeit
• vielseitige Unterteilungsmöglichkeit
647 002 Geräteschub, hoch



Deckel zu Geräteschub
Zur Abdeckung der Geräteschübe 647 001 (niedrig) und 647 002 (hoch). Stapelbarkeit der Schübe bleibt auch mit Deckel erhalten.
Technische Daten:
• Material: Polyproylen (PP)
• Maße (außen): 455 mm x 275 mm x 18 mm
647 003 Deckel zu Geräteschub
Etikettenhalter, Satz 8 Stück
Zur Halterung der Etiketten der Geräteschübe 647 001 (niedrig) und 647 002 (hoch). Passend für das Labeling von insgesamt 4 kompletten Geräteschüben.
Technische Daten:
• Maße: 210 mm x 77 mm
• Menge: 8 Stück
647 007 Etikettenhalter, Satz 8 Stück
Fachteiler, lang, Satz 4 Stück
Zur Unterteilung der Geräteschübe 647 001 (niedrig) und 647 002 (hoch). Jeder Geräteschub kann mit einem Fachteiler längs in 2 Fächer unterteilt werden.
Technische Daten:
• Material: Styrol-Butadien (SB)
• Maße: 401 mm x 70 mm
• Menge: 4 Stück
647 004 Fachteiler, lang, Satz 4 Stück
Fachteiler, medium, Satz 4 Stück
Zur Unterteilung der Geräteschübe 647 001 (niedrig) und 647 002 (hoch). Jeder Geräteschub kann mit den Fachteilern in bis zu 5 Fächer quer unterteilt werden.
Technische Daten:
• Material: Styrol-Butadien (SB)
• Maße: 246 mm x 70mm
• Menge: 4 Stück
647 005 Fachteiler, medium, Satz 4 Stück
Fachteiler, kurz, Satz 4 Stück
Zur Unterteilung der Geräteschübe 647 001 (niedrig) und 647 002 (hoch). Jeder Geräteschub kann mit den Fachteilern in Kombination mit dem Fachteiler 647 004 (lang) in bis zu 10 Fächer längs und quer unterteilt werden.
Technische Daten:
• Material: Styrol-Butadien (SB)
• Maße: 120 mm x 70mm
• Menge: 4 Stück
647 006 Fachteiler, kurz, Satz 4 Stück
Zusätzlich erforderlich:
Menge Kat.-Nr. Bezeichnung
1 647 004 Fachteiler, lang, Satz 4 Stück


Schlagworte zu Versuchsthemen: Damit Sie ein gewünschtes Versuchsthema schnell und einfach finden, haben wir Ihnen ein Schlagwortverzeichnis zusammengestellt.
SCHLAGWORT FACHGEBIET SCHUB
Abiotische Faktoren Ökologie ECO
Additionsreaktionen Organische Chemie OC
Aggregatzustände Energie EG1
Akustik Mechanik ME4
Aldehyde Organische Chemie OC
Alkane Organische Chemie OC
Alkanole Organische Chemie OC
Alkohole Organische Chemie OC
Ameisensäure Organische Chemie OC
Aminosäuren Biochemie TBC
Äquipotentiallinien Elektrik EL1
Archimedische Prinzip Mechanik ME1
Atemvolumen / Atemfrequenz Humanbiologie HU2
Aufbau der Zelle Zellbiologie CE
Auftriebskraft Mechanik ME1
Auge Optik OP1
Backpulver Biochemie TBC
Balkenwaage Mechanik ME2
Baustoffe Technische Chemie TBC
Beleuchtungsstärke Optik OP1
Benzin Organische Chemie OC Beugung Optik OP3
Bimetallschalter Elektrik EL3
Biodiesel Organische Chemie OC
Biodiversität Ökologie ECO
Biotische Faktoren Ökologie ECO Blatt Botanik BO
Blue-Bottle-Experiment Biochemie TBC
Blutdruck Humanbiologie HU2
Blüte Botanik BO
Boden Ökologie ECO
Bodenverschmutzung Ökologie ECO
Brennstoffzelle Energie EG3
Brewstersches Gesetz Optik OP4
Bronze Technische Chemie TBC
Carbonsäuren Organische Chemie OC
Cellulose Biochemie TBC
Chemische Gesetze Allgemeine & Anorganische Chemie AC1 & AC2
Chemische Reaktionen Allgemeine & Anorganische Chemie AC1 & AC2
Chemisches Gleichgewicht Physikalische Chemie PC
Chromatografie Allgemeine & Anorganische Chemie AC1 & AC2
Dehnung Mechanik ME2
Destillationen Organische Chemie OC
Diaprojektor Optik OP1
Dichte - Bestimmung Mechanik ME1
Diffusion Physikalische Chemie PC
Dioden Elektronik EL6
Diodenschaltungen Elektronik EL6
Druck Mechanik ME1
Düngemittel Technische Chemie TBC
Dynamo Elektrik EL5
Einfache Maschinen Mechanik ME2
Einzellige Lebewesen Zellbiologie CE
Elektrische Anwendungsschaltungen Elektrik EL3
Elektrische Grundschaltungen Elektrik EL3
Elektrische Influenz Elektrik EL1
Elektrische Leitfähigkeit Physikalische Chemie PC
Elektrisches Feld Elektrik EL1
Elektrochemie - Fachgebiet Elektrik Elektrik EL3
Elektrochemische Potentiale Physikalische Chemie PC
Elektrolyse Physikalische Chemie PC
Elektrolyseur Energie EG3
Elektrolytische Raffination Physikalische Chemie PC
Elektromagnetismus Elektrik EL4
Elektromotoren Elektrik EL5
Elektronische Grundschaltungen Elektronik EL6
Elektrostatik Elektrik EL1
Elektrostatische Wechselwirkung Elektrik EL1
Enzyme Zellbiologie CE
Erdbeschleunigung Mechanik ME3
Erdölchemie Organische Chemie OC
Ernährung Humanbiologie HU2
Erneuerbare Energien Energie EG2
Erwärmung von Luft Energie EG1
Essigsäure Organische Chemie OC
Ester Organische Chemie OC Ethanol Organische Chemie OC Ethin Organische Chemie
Ökologie ECO
Extraktion Allgemeine & Anorganische Chemie AC1 & AC2 Fadenpendel Mechanik ME2
Faraday-Konstante Energie EG3
Faradaysche Gesetz Physikalische Chemie PC
Farbenlehre Optik OP2
Farbmischung Optik OP2
Feldlinienbild Elektrik EL2
Fernrohrmodelle Optik OP1
SCHLAGWORT
und Tasten
Gesetz der Erhaltung der Masse
Gesetz der konstanten Massenverhältnisse
Gesunderhaltung des Körpers
& Anorganische
und Wärmemischungen
Kohlenstoffdioxid
&
Allgemeine & Anorganische Chemie AC1 & AC2
Kondensatoren Elektronik EL6
Konkavlinse Optik OP1
Konservierungsstoffe Biochemie TBC
Kontaktelektrizität Elektrik EL1
Konvexlinse Optik OP1
Körper Humanbiologie HU2
Korrosion von Eisen Physikalische Chemie PC
Kraft - Körper in Flüssigkeiten Mechanik ME1
Kraft - Verformung, Zusammensetzung, Zerlegung Mechanik ME2
Kraft - Wirkung Elektrik EL1
Kristallzüchtung
Allgemeine & Anorganische Chemie AC1 & AC2
Kunststoffe Technische Chemie TBC
Ladungsarten Elektrik EL1
Ladungsspeicher Elektrik EL1
Längenausdehnung Energie EG1
Längenmessung Mechanik ME1
Lärmanalyse Mechanik ME4
Laugen
Allgemeine & Anorganische Chemie AC1 & AC2
Lebensmittelfarben Biochemie TBC
Lebensmitteltechnologie Humanbiologie HU2
Legierungen Technische Chemie TBC
Leistung und Arbeit - Strom Elektrik EL3
Leiter und Nichtleiter Elektrik EL3
Leiter und Nichtleiter Physikalische Chemie PC
Leitfähigkeit Allgemeine & Anorganische Chemie AC1 & AC2
Leitfähigkeit Elektrik EL3
Leuchtdioden Elektronik EL6
Lichtbrechung Optik OP1
Lineare Bewegung
Löslichkeit
Löslichkeit
Lösungen, Kolloide und Suspensionen
& Anorganische Chemie AC1 & AC2
& Anorganische
& Anorganische
SCHLAGWORT FACHGEBIET SCHUB
Luftverschmutzung Ökologie ECO
Lupe Optik OP1
Magnetfeld Elektrik EL2
Magnetische Felder Elektrik EL2
Magnetismus Elektrik EL2
Masse - Messung Mechanik ME1
Mehrzellige Lebewesen Zellbiologie CE
Mensch und Umwelt Ökologie ECO
Menschliche Auge Optik OP1
Messing Technische Chemie TBC
Messung von Länge und Zeit Mechanik ME1
Metalle - Redox-Reihe & Standardpotenziale Physikalische Chemie PC
Metalle - Eigenschaften und Verwendung
Allgemeine & Anorganische Chemie AC1 & AC2
Metalle - Gewinnung und Legierungen Technische Chemie TBC
Metalloxide
Allgemeine & Anorganische Chemie AC1 & AC2
Methanol Organische Chemie OC
Mikroskop Optik OP1
Mikroskopie - Lichtmikroskop, Mikropräparate Ökologie ECO Mikroskopie - Lichtmikroskop, Mikropräparate Zellbiologie CE Mikroskopie - Lichtmikroskop, Präparate Botanik BO
Modell einer Schmelzsicherung Elektrik EL3
Motoren Elektrik EL5
Nanochemie
Allgemeine & Anorganische Chemie AC1 & AC2
Nervensystem Humanbiologie HU2
Neutralisation Allgemeine & Anorganische Chemie AC1 & AC2
Newtonsche Gesetze Mechanik ME3
Ohmsche Widerstände Elektrik EL3
Ohmsches Gesetz Elektrik EL3
Ökosysteme Ökologie ECO Optische Aktivität Optik OP4
Optische Instrumente Optik OP1
Optische Täuschungen Optik OP1
Organische Stoffe Organische Chemie OC Oxidation
Allgemeine & Anorganische Chemie AC1 & AC2
Paraffin Organische Chemie OC
Parallelschaltung Elektrik EL3
Pendel Mechanik ME2
Pflanzliche Fette Biochemie TBC
Pflanzliche Zelle Botanik BO
Pflanzliche Zelle Zellbiologie CE Photosynthese Botanik BO
pH-Skala/ pH-Wert
Allgemeine & Anorganische Chemie AC1 & AC2
pH-Wert Bodenproben und Gewässer Ökologie ECO
Plattenkondensator Elektrik EL1
Polarimetrie Optik OP4
Polarisation Optik OP4
Populationsökologie Ökologie ECO
Potentiometer Elektrik EL3
Präparate herstellen Botanik BO
Prinzip von Le Chatelier Physikalische Chemie PC Prisma Optik OP2
Propan Organische Chemie OC
Proteine Biochemie TBC
Protolysegleichgewicht Allgemeine & Anorganische Chemie AC1 & AC2
Pufferlösungen
SCHLAGWORT
Schwingungen - Erzwungene
FACHGEBIET SCHUB
Mechanik ME2
Schwingungen - Harmonische Mechanik ME2
Schwingungen - Töne, Stimmgabel Mechanik ME4
Sehen
Seifen
Siedepunkte
Siedetemperatur
Silberspiegel
Silikone
Sinnesorgane
Solarenergie
Solarzellen - Durchlassrichtung, Kennlinien, Leerlaufspannung
Spannungsquellen
Spektralfarben
Sprossachse
Spulen
Stabmagneten
Stabpendel
Stärke
Statistik des radioaktiven Zerfalls
Stoffgemische
Stofftransport
Stofftrennung
Stoßversuche
Strahlenoptik
Strahlung Abschirmung
Stromkreis
Stromstärke
Substitutionsreaktionen
Humanbiologie HU1
Technische Chemie TBC
Organische Chemie OC
Allgemeine & Anorganische Chemie AC1 & AC2
Allgemeine & Anorganische Chemie AC1 & AC2
Technische Chemie TBC
Humanbiologie HU2
Energie EG2
Elektrik EL3
Elektrik EL3
Optik OP2
Botanik BO
Elektrik EL4
Elektrik EL2
Mechanik ME2
Biochemie TBC
Atom- und Kernphysik RA
Allgemeine & Anorganische Chemie AC1 & AC2
Zellbiologie CE
Allgemeine & Anorganische Chemie AC1 & AC2
Mechanik ME3
Optik OP1
Atom- und Kernphysik RA
Elektrik EL3
Elektrik EL3
Allgemeine & Anorganische Chemie AC1 & AC2
Quellung Botanik BO
Radioaktiver Strahlung Atom- und Kernphysik RA
Reaktionsgeschwindigkeit Physikalische Chemie PC
Reaktionstests Humanbiologie HU2
Reaktionswärme Physikalische Chemie PC
Redoxreaktionen
Allgemeine & Anorganische Chemie AC1 & AC2
Reflexion an Spiegeln Optik OP1
Reihenschaltung Elektrik EL3
Relaisschaltungen
Elektronik EL6
Resonanz Mechanik ME4
Riechen Humanbiologie HU1
Riemengetriebe Mechanik ME2
Rolle Mechanik ME2
Rostvorgang
Allgemeine & Anorganische Chemie AC1 & AC2
Saccharose Biochemie TBC
Salze
Allgemeine & Anorganische Chemie AC1 & AC2
Salzgehalt von Gewässern Ökologie ECO
Sauerstoff - Darstellung, Nachweis & Eigenschaften
Allgemeine & Anorganische Chemie AC1 & AC2
Sauerstoff Nachweis Organische Chemie OC
Sauerstoffgehalt von Wasser oder Luft
Allgemeine & Anorganische Chemie AC1 & AC2
Säuren Allgemeine & Anorganische Chemie AC1 & AC2
Schall Mechanik ME4
Schallausbreitung Mechanik ME4
Schallgeschwindigkeit Mechanik ME4
Schatten Optik OP1
Schiefe Ebene Mechanik ME2
Schimmelpilzen Zellbiologie CE
Schmelz- und Erstarrungspunkt Biochemie TBC
Schraubenfederpendel Mechanik ME2
Schwebung Mechanik ME4
Schwefelsäure
Allgemeine & Anorganische Chemie AC1 & AC2
Organische Chemie OC Teilchenbewegung
Physikalische Chemie PC
Temperaturabhängigkeit - Enzyme Zellbiologie CE
Temperaturabhängigkeit - Gärung
Humanbiologie HU2
Temperaturabhängigkeit - Lebensvorgängen Ökologie ECO
Temperaturabhängigkeit -
Reaktionsgeschwindigkeit
Physikalische Chemie PC
Temperaturverlauf Energie EG1
Thermometers
Tierische Fetten
Tierische Zelle
Titrationen
Tonentstehung
Totalreflexion
Transformatoren
Transistoren
Treibhauseffekt
Tyndall-Effekt
Umschaltung
Umweltanpassung
Umweltradioaktivität
Universalmotor
Verdampfen
Verdauung
Energie EG1
Biochemie TBC
Zellbiologie CE
Allgemeine & Anorganische Chemie AC1 & AC2
Mechanik ME4
Optik OP1
Elektrik EL4
Elektronik EL6
Energie EG2
Optik OP4
Elektrik EL3
Ökologie ECO
Atom- und Kernphysik RA
Elektrik EL5
Allgemeine & Anorganische Chemie AC1 & AC2
Humanbiologie HU2
Verformung Kraft Mechanik ME2
Verstärkerschaltungen
Vitamin C
Volumenbestimmung
Wärmeausdehnung
Wärmedämmung
Elektronik EL6
Biochemie TBC
Mechanik ME1
Energie EG1
Energie EG1
Wärmekapazitäten Energie EG1
Wärmeleitung Energie EG1
Wärmetransport Energie EG1
Wärmeverhalten
Wasser
Wasseraufbereitung
Wasserhaushalt
Wasserstoff - Eigenschaften
Wasserstoff - Nachweis
Wechselschaltung
Weißen Licht
Wellen
Wellenoptik
Widerstände
Windenergie
Wurzeln
Z-Diode
Zeitmessung
Zellatmung bei der Keimung
Zelle
Zellmembran
Zellzyklus
Zerfallsprodukte
Zerteilungsgrad
Zucker
Zusatzstoffe
β-Strahlung
Energie EG1
Allgemeine & Anorganische Chemie AC1 & AC2
Allgemeine & Anorganische Chemie AC1 & AC2
Botanik BO
Allgemeine & Anorganische Chemie AC1 & AC2
Organische Chemie OC
Elektrik EL3
Optik OP1
Mechanik ME2
Optik OP3
Elektrik EL3
Energie EG2
Botanik BO
Elektronik EL6
Mechanik ME1
Botanik BO
Zellbiologie CE
Zellbiologie CE
Zellbiologie CE
Atom- und Kernphysik RA
Physikalische Chemie PC
Biochemie TBC
Biochemie TBC
Atom- und Kernphysik RA

https://www.leybold-shop.de
Kauf auf Rechnung
mehr als 2.500 Versuche/Ausstattungen erhältlich
über 10.000 Artikel online verfügbar
Versuchsanleitungen & Gebrauchsanweisungen direkt abrufbar
24 Monate Garantie
Aktuelle Preise zum Science Lab Schülerversuche-System finden Sie hier:
Zu unseren AGBs:

DEUTSCHLAND:
LD DIDACTIC GmbH
Leyboldstr. 1
D‐50354 Hürth
Tel.: +49 2233 604 0
Fax: +49 2233 604 222
E‐Mail: info@ld‐didactic.de www.ld‐didactic.de

